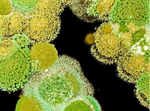

Mihirkumar Jashubhai Parmar
મે મારુ ગ્રેજ્યુએશન (B.com) બેચલર ઓફ કોમર્સ 2009માં કર્યુ છે. ત્યારબાદ સર્ટીફાઈડ ઈન્ડસ્ટ્રીયલ એકાઉન્ટન્ટ(CIA) નો કોર્ષ આઈસીએ (ICA) institute of computer accountant માંથી 2011માં કર્યો છે. મે એકાઉન્ટન્ટ તરીકે 3 વર્ષ સુધી કાર્ય કર્યુ. ત્યારબાદ 2016-17માં પત્રકારત્વ ક્ષેત્ર સાથે સંકળાયો. 2017માં (PGDJMC) પોસ્ટ ગ્રેજ્યુએશન ડિપ્લોમાં ઈન જર્નાલિઝમ એન્ડ માસ કોમ્યુનિકેશનમાં ગ્રેજ્યુએશન કર્યુ. 2018 માં ETV Bharat (Ramoji Film City, Hyderabad) માં એક કન્ટેન્ટ રાઈટર તરીકે કામ કર્યુ. ત્યારબાદ ગુજરાતી ભાષાની અલગ અલગ ચેનલો અને અખબારોમાં કામ કરવાનો અવસર મળ્યો. હાલમાં ગુજરાતી કન્ટેન્ટ રાઈટર તરીકે કૃષિ જાગરણ દિલ્હી ખાતે ફરજ બજાવુ છુ.
પ્રધાનમંત્રીએ ગુજરાતનાં ગાંધીનગરમાં આશરે રૂ. 4400 કરોડનું મૂલ્ય ધરાવતાં વિવિધ વિકાસલક્ષી પ્રોજેક્ટનો શિલાન્યાસ કર્યો અને દેશને અર્પણ કર્યા
રૂ. 2,450 કરોડથી વધારે મૂલ્યનાં વિવિધ વિકાસલક્ષી પ્રોજેક્ટનો શિલાન્યાસ કર્યો અને સમર્પણ કર્યું…
નારી સંરક્ષણ ગૃહો/કેન્દ્રો તથા ગ્રાંટેડ પ્રિવેન્ટીવ રેસ્ક્યુ સેન્ટર ખાતે આશ્રીત બહેનોના લગ્ન સહાયમાં નોંધપાત્ર વધારો: મહિલા અને બાળ વિકાસ મંત્રી શ્રી ભાનુબેન બાબરીયા
અંદાજપત્રમાં કરાયેલ જાહેરાતનો ત્વરિત અમલ કરી ભાવનગરના નારી સંરક્ષણ ગૃહની દિકરીને સહાય આપતા મંત્રીશ્રી…
નરેન્દ્ર મોદીના નેતૃત્વ હેઠળ આંતરરાષ્ટ્રીય બાજરી વર્ષ-2023ને ધ્યાનમાં રાખીને, ગૃહ મંત્રાલયે CAPF અને NDRF કર્મચારીઓના આહારમાં બાજરી (શ્રી અન્ન)નો સમાવેશ કરવાનો અભૂતપૂર્વ નિર્ણય લીધો
કેન્દ્રીય ગૃહ અને સહકારિતા મંત્રી શ્રી અમિત શાહના આહ્વાન પર તમામ દળો સાથે વિસ્તૃત ચર્ચા કર્યા બાદ કેન્દ્રીય સશસ્ત્ર પોલીસ દળોના આહારમાં 30% મિલેટ (શ્રી…
આજે મહાત્મા મંદિર ગાંધીનગર ખાતે ગુજરાત પંચાયત સેવા પંસદગી મંડળ દ્વારા ૧૭૬૦ મલ્ટીપર્પઝ હેલ્થ વર્કર તરીકે પસંદગી પામેલા ઉમેદવારોને નિમણૂંક પત્ર એનાયત કરાશે
નાણા અને ઊર્જા મંત્રી શ્રી કનુભાઈ દેસાઈના હસ્તે નિમણૂંક પત્ર એનાયત કરાશેઃ મંત્રી શ્રી ઋષિકેશભાઈ પટેલ તથા મંત્રી શ્રી બચુભાઈ ખાબડની વિશેષ ઉપસ્થિતિ…
ડૉ. મનસુખ માંડવિયાએ અંગદાન નીતિની સમીક્ષા કરી; આંતરરાષ્ટ્રીય ધોરણોમાંથી શિક્ષા લેવા નિર્દેશ આપ્યો
દૂરદર્શી માળખાકીય સુધારાઓ નજીકમાં છે સમગ્ર દેશમાં ત્રણ ગણું અંગ પ્રત્યારોપણ; 5000 (2013) થી વધીને 2022 માં 15000 થી વધુ…
ગૃહ રાજ્યમંત્રી શ્રી હર્ષ સંઘવીએ અમદાવાદ એરપોર્ટ પર સુદાનથી પરત ફરેલા ૨૩૧ જેટલા ભારતીયોને આવકાર્યા
ઓપરેશન કાવેરી અંતર્ગત ૨૦૮ જેટલા ગુજરાતીઓ સુદાનથી પરત ફર્યાં.વોર ઝોનમાં લેન્ડિંગ કરવું ક્યારેય સરળ હોતું નથી, આપણી સેનાના જાંબાઝ જવાનો આ મિશનને ખૂબ જ હિંમતપૂર્વક…
રાજયમાં સ્ટુડન્ટ પોલીસ કેડેટ SPC સાત દિવસીય સમર કેમ્પ-૨૦૨૩નું આયોજન કરાયું – પ્રવક્તા મંત્રી શ્રી ઋષિકેશ પટેલ
રાજ્યમાં ૨૧ મી એપ્રિલ થી શરૂ SPC સમર કેમ્પમાં રાજ્યના ૪૮૭ એકમમાં ૧૫૮૦૦ જેટલા વિદ્યાર્થીઓએ લાભ લીધો…
નરેન્દ્રભાઇ મોદી ‘સ્વાગત’ના ર૦ વર્ષ પૂર્ણ થવા અવસરે આગામી ર૭ એપ્રિલ-ચોથા ગુરૂવારે યોજાનારા ‘રાજ્ય સ્વાગત’માં ઓનલાઇન સહભાગી થશે- લાભાર્થીઓ સાથે સંવાદ કરશે-તંત્રવાહકોને પ્રેરણા-માર્ગદર્શન આપશે
મુખ્યમંત્રીશ્રી ભૂપેન્દ્ર પટેલની પ્રેરક ઉપસ્થિતી :- ર૦૦૩ થી દર મહિનાના ચોથા ગુરૂવારને ફરિયાદ નિવારણ દિવસ તરીકે શ્રી નરેન્દ્રભાઇ મોદીએ પ્રસ્થાપિત કર્યો છે…
ગાંધીનગરના યુવા સર્જક શ્રી જિગર સાગરની સાયન્સ ફિક્શન નવલકથા “રહસ્યમય પ્રકાશ” પુસ્તકનું વિમોચન ઈન્ડિયન ઈન્સ્ટિટ્યુટ ઓફ ટીચર્સ એજ્યુકેશનના ઓડિટોરિયમ ખાતે યોજાયુ.
તારીખ ૧૪મી એપ્રિલ ૨૦૨૩ના રોજ આદરણીય બાબા સાહેબની જન્મ જયંતિના દિવસે ગાંધીનગરમાં સચિવાલય ખાતે શાખા અધિકારી તરીકે ફરજો બજાવતા યુવા સર્જક શ્રી જિગર સાગરની સાયન્સ…
ભારતના રાષ્ટ્રપતિએ NIFના 11મા દ્વિવાર્ષિક રાષ્ટ્રીય ગ્રાસરૂટ ઇનોવેશન અને ઉત્કૃષ્ટ પરંપરાગત જ્ઞાન પુરસ્કારો રજૂ કર્યા અને ફાઇન-2023નું ઉદ્ઘાટન કર્યું
ફાઈન એ એક અનોખો પ્રયાસ છે જે વિજ્ઞાન, ટેકનોલોજી અને નવીનતાને પ્રોત્સાહન આપે છે અને નાગરિકોને ઉદ્યોગસાહસિકતા હાથ ધરવા પ્રોત્સાહિત કરે છે: રાષ્ટ્રપતિ મુર્મુ…
સુરતમાં કેન્દ્રીય વસ્ત્ર અને રેલવે રાજ્ય મંત્રી શ્રીમતી દર્શના જરદોશે સાડીની થીમ પર વિશેષ હૅન્ડલૂમ એક્સપોનું ઉદ્ઘાટન કર્યું
આ એક્સપો કારીગરો ખાસ કરીને મહિલા કારીગરોને તેમનાં ઉત્પાદનો પ્રદર્શિત કરવાની તક આપે છે, નવીનતાને પ્રોત્સાહન આપે છે, એક ભારત શ્રેષ્ઠ ભારતની ભાવના એમાં છલકાય…
ડૉ.મનસુખ માંડવિયાએ રાજ્યો સાથે કોવિડ-19 અને કોવિડ-19 રસીકરણની પ્રગતિના સંચાલન માટે જાહેર આરોગ્યની તૈયારીની સમીક્ષા કરી
"કેન્દ્ર અને રાજ્યોએ કોવિડ-19 નિવારણ અને વ્યવસ્થાપન માટે અગાઉના વધારા દરમિયાન કરવામાં આવ્યું હતું તે રીતે સહયોગી ભાવનાથી કામ કરવાનું ચાલુ રાખવાની જરૂર છે". કેન્દ્રીય…
SSC પાસ માટે નીકળી બમ્પર ભરતી, માસિક પગાર 47 હજાર સુધી
દસમુ ધોરણ પાસ ઉમેદવારો માટે બમ્પર ભરતી બહાર આવી છે. અરજી માટેની વય મર્યાદા કેટલી છે અને ફોર્મ કેવી રીતે ભરવું, તે તમામ વિગતો તમને…
વિશ્વ આરોગ્ય દિવસ નિમિત્તે, કેન્દ્રીય આરોગ્ય મંત્રાલયે નવી દિલ્હીમાં વોકાથોન ઈવેન્ટનું આયોજન કર્યું
વિશ્વ આરોગ્ય દિવસ નિમિત્તે, કેન્દ્રીય આરોગ્ય અને પરિવાર કલ્યાણ મંત્રાલયે નવી દિલ્હીમાં વોકથોન ઈવેન્ટનું આયોજન કર્યું હતું. કેન્દ્રીય સ્વાસ્થ્ય મંત્રી ડૉ.મનસુખ માંડવિયા અને ડૉ. ભારતી…
અમિત શાહના માર્ગદર્શન હેઠળ ગૃહ મંત્રાલય જેલોમાં અન્ડરટ્રાયલના મુદ્દાને ઉકેલવા માટે વિવિધ પગલાં લઈ રહ્યું છે
એ સુનિશ્ચિત કરવા માટે કે બજેટના લાભો સમાજના તમામ હેતુવાળા વર્ગો સુધી વિસ્તરે, બજેટની પ્રાથમિકતાઓમાંની એક છે, એટલે કે માર્ગદર્શક 'સપ્તરિષીઓ' છેવાડાના લોકો સુધી પહોંચે…
ઝુનઝુનવાલાના રોકાણ શેરમાં તેજી, શેર 10 ટકાની અપર સર્કિટને સ્પર્શ્યો
સિંગર ઈન્ડિયાનો શેર ગુરુવારે (6 એપ્રિલ) તેમના 10 ટકાની અપર સર્કિટને સ્પર્શ્યો હતો. આજે એટલે કે 7 એપ્રિલે ગુડ ફ્રાઈડેની રજા હોવાથી શેરબજારમાં ટ્રેડિંગ બંધ…
પેકેજ્ડ બંધ પીવાના પાણીની કંપની પર ભારતીય માનક બ્યુરોના દરોડા
ભારતીય માનક બ્યુરોના અધિકારીઓ દ્વારા બ્યુરીથ માન્ય લાયસન્સ લીધા વગર પેકેજ્ડ બંધ પીવાના પાણીનું ઉત્પાદન થતું હોવાની માહિતીના આધાર પર તા. 6 એપ્રિલ 2023ના રોજ…
પાકિસ્તાનમાં ઈંધણ સંકટ, 24 કલાક માટે ગેસ સપ્લાય બંધ
દોસ્તો તમે બધા પાકિસ્તાનની હાલત તો જાણો જ છો. છેલ્લા ઘણા સમયથી પાકિસ્તાનની જનતા મોંઘવારી સામે ઝઝુમી રહી છે. પાકિસ્તાનમાં લોકો માટે દરરોજ એક નવું…
Aadhar-PAN: જો 30 જૂન સુધી PANને આધાર સાથે લિંક નહીં કરાવો તો ભરવો પડશે દંડ, જાણો શું કહ્યું નાણામંત્રીએ?
જો 30 જૂન 2023 સુધીમાં PAN કાર્ડને આધાર સાથે લિંક નહીં કરવામાં આવે તો તે નિષ્ક્રિય થઈ જશે. ગુરુવારે એક પ્રેસ કોન્ફરન્સને સંબોધતા નાણામંત્રીએ કહ્યું…
મોરબી દુર્ઘટનાનો આરોપી જયસુખ પટેલ બન્યો માનસિક બિમારીનો શિકાર, જેલમાંથી હોસ્પિટલ ખસેડવામાં આવ્યો
મોરબીના ઝુલતા પુલ દુર્ઘટના વિશે તો બધા જાણતા જ હશો. આ દુર્ઘટનામાં 135 લોકોના મોત થયા હતા.આ માટે જવાબદાર કંપની ઓરેવા ગ્રુપના મેનેજિંગ ડિરેક્ટર જયસુખ…
સાવચેત રહો ખેડુતો! આ મશીનના ઉપયોગથી ઘઉંની કાપણીમાં થઈ શકે મુશ્કેલી, 15 એપ્રિલ સુધી ઉપયોગ પર પ્રતિબંધ!
સ્ટ્રો રીપર મશીનઃ ખેડૂતોની સુવિધા માટે કૃષિ મશીનોના ઉપયોગને પ્રોત્સાહન આપવામાં આવી રહ્યું છે, પરંતુ આ કૃષિ મશીનો મુશ્કેલી પણ ઉભી કરી શકે છે. ઘણા…
4 એપ્રિલ પછી વરસાદ સાથે જોરદાર પવન ફૂંકાશે, રાતના તાપમાનમાં થશે ઘટાડો
દેશના ઘણા વિસ્તારોમાં વેસ્ટર્ન ડિસ્ટર્બન્સના કારણે 2 એપ્રિલ સુધી વેધર પેટર્ન ડિસ્ટર્બ રહેશે. બીજી તરફ, 4 એપ્રિલે બીજી વિક્ષેપ સક્રિય થતાં જ, 8 એપ્રિલ સુધી…
MNRE G20 એનર્જી ટ્રાન્ઝિશન વર્કિંગ ગ્રૂપની સાથે-સાથે 'ગ્રીન હાઇડ્રોજન - એક્સિલરેટિંગ નેટ-ઝીરો પાથવેઝ' ઇવેન્ટનું આયોજન કરશે
નવી અને પુનઃપ્રાપ્ય ઊર્જા મંત્રાલય (MNRE) 2જી એપ્રિલ 2023ના રોજ 2જી એનર્જી ટ્રાન્ઝિશન વર્કિંગ ગ્રૂપની બેઠકની બાજુમાં એક ઇવેન્ટ ‘ગ્રીન હાઇડ્રોજન – એક્સિલરેટીંગ નેટ-ઝીરો પાથવેઝ’નું…
G20 ડીઆરઆર વર્કિંગ ગ્રૂપ મીટિંગના બીજા દિવસે ડિઝાસ્ટર રેઝિલિયન્ટ ઈન્ફ્રાસ્ટ્રક્ચર કેન્દ્રબિંદુ રહ્યું
1લી ડિઝાસ્ટર રિસ્ક રિડક્શન (DRR) વર્કિંગ ગ્રૂપ મીટિંગના બીજા દિવસે મુખ્યત્વે ડિઝાસ્ટર રિસિલિયન્ટ ઈન્ફ્રાસ્ટ્રક્ચર, ડિઝાસ્ટર રિસ્ક રિડક્શન માટે ફાઇનાન્સિંગ અને ડિઝાસ્ટર રિસ્પોન્સ, રિકવરી અને “બિલ્ડ…
01.04.2023થી અમલી સૂક્ષ્મ અને નાના ઉદ્યોગો માટે ક્રેડિટ ગેરંટી સ્કીમમાં નોંધપાત્ર સુધારા
કેન્દ્રીય બજેટ 2023-24માં, કેન્દ્રીય નાણા મંત્રી, શ્રીમતી નિર્મલા સીતારમણે 01.04.2023થી અમલી બનેલ સૂક્ષ્મ અને નાના ઉદ્યોગો માટેની ધિરાણ ગેરંટી યોજનામાં મહત્વના સુધારાની જાહેરાત કરી હતી,…
maxEEma બાયોટેક: પાકને ટકાવવા અને જંતુરહિત ખેતી સાથે નવી ટેકનોલોજી માં પણ અવ્વલ
maxEEma બાયોટેક એ ગ્રીન એગ્રીકલ્ચરલ સાયન્સ ફર્મ છે જે નવીન અને ટકાઉ પાક સંરક્ષણ તકનીકો દ્વારા ખેતી સાથે આગળ વધી રહી છે.…
ક્રાંતિકારી શહીદ ભગતસિંહનો તેમના પિતાજીને પત્ર
(અબ્રાહમ લિંકનનો પોતાના પુત્ર બાબતે તેના શિક્ષકને પત્ર, જવાહરલાલ નહેરુના જેલમાંથી પોતાની પુત્રી ઈન્દિરા ગાંધીને પત્રો, વગેરે ખૂબ પ્રખ્યાત છે. પરંતુ ભગતસિંહે પોતાના પિતાને જે…
માવઠાએ બગાડી કેરીની મજા, વરસાદી સંકટના કારણે કેરીના પાકને ભારે નુકસાન, જાણો કેટલે પહોંચ્યા ભાવ?
ગુજરાતમાં ક્લાઈમેટ ચેન્જના કારણે કેટ કેટલાય જિલ્લાઓમાં વરસાદ ખાબકી રહ્યો છે. ભારે પવન અને વીજ કડાકા સાથે તૂટી પડેલા આ વરસાદે ખેડૂતોની આશા અને મહેનત…
મધ્ય ભારતમાં ટેરો કેટરપિલરનો પ્રકોપ, શું છે ઉપાય તે જાણો
ટેરો કેટરપિલર (સ્પોડોપ્ટેરા લિટિયોરા), એશિયા અને ઓશનિયામાં ઘણા પાકની જીવાત છે. આ પ્રજાતિ સામાન્ય રીતે કુદરતી દુશ્મનો દ્વારા નિયંત્રિત થાય છે - જૈવિક નિયંત્રણ. છેલ્લા…
આ વર્ષે ઘઉંના ઉત્પાદન પર ગરમીની અસર નહીં પડે, કેન્દ્ર સરકારે આપી મોટી રાહત
દેશના મોટા ભાગમાં ઘઉંનું વાવેતર થયું છે. કેન્દ્ર સરકાર ઘઉંના ઉત્પાદન પર નજર રાખી રહી છે. આ વર્ષે ગરમીમાં વધારો થવાને કારણે ઘઉંના ઉત્પાદનને અસર…
ગુજરાત સાયન્સ સિટી ખાતે ગૂગલના સહયોગથી બે દિવસીય "વુમન વિલ" કાર્યક્રમ યોજાયો.
મહિલાઓ દરેક સંબંધોને સારી રીતે સંભાળે છે. આજે તમામ ક્ષેત્રોમાં મહિલાઓનું યોગદાન મહત્વપૂર્ણ છે. કોઈપણ દેશના વિકાસનો મુખ્ય આધાર મહિલાઓ છે. તેઓ પરિવાર, સમાજ અને…
નહેરુ યુવા કેન્દ્ર સંગઠન, નર્મદા દ્વારા યુવા ઉત્સવનું આયોજન
G20 સમિટના યજમાનપદની ઉજવણીના ભાગરૂપે આજે આઇ ટી આઇ, વાઘડીયા ખાતે આયોજિત યુવા ઉત્સવમાં યુવાઓ બહોળી સંખ્યામાં ભાગ લેશે…
પ્રધાનમંત્રી 18મી માર્ચે ગ્લોબલ મિલેટ્સ (શ્રી અન્ના) કોન્ફરન્સનું ઉદ્ઘાટન કરશે
પ્રધાનમંત્રી શ્રી નરેન્દ્ર મોદી 18મી માર્ચ, 2023ના રોજ સવારે 11 વાગ્યે સુબ્રમણ્યમ હોલ, NASC કોમ્પ્લેક્સ, IARI કેમ્પસ, PUSA નવી દિલ્હી ખાતે ગ્લોબલ મિલેટ્સ (શ્રી અન્ના)…
જાયદના પાકની યોગ્ય જાળવણી કરી કૃષિ ક્ષેત્રમાં વધુ સારું ઉત્પાદન મેળવીએ
ખેતીમાં જાળવણી, સંભાળનું પોતાનું મહત્વ છે, અથવા તેના બદલે, કૃષિ અને આ શબ્દોનો ઊંડો સંબંધ છે. જો કે જાયદ પાકની વાવણીનો સમય ગત મહિનાથી જ…
આ રીત અપનાવી શેરડીને નિંદણથી રાખો મુક્ત, ઉર્જા અને ખર્ચની થશે બચત
શેરડીના આવા કેટલાક નિંદણ જે શેરડીમાં રાત-દિવસ ચારગણા ઉગે છે. તેને અંકુશમાં લેવા માટે ગમે એટલી ખેતીની કામગીરી કરવામાં આવે તો પણ તે ઘટવાનું નામ…
આંબામાં નવીનીકરણ કરવાની પદ્ધતિ, તેની ટેકનીકો અને આર્થિક અસર
કેરીને 'બધા ફળોના રાજા' તરીકે ઓળખવામાં આવે છે. સમગ્ર વિશ્વમાં ૧૦૦૦ થી વધુ અલગ અલગ કેરીની જાતો છે. કેરીએ ઉષ્ણકટિબંધીય વિસ્તારમાં થતો પાક છે. કેરી…
અમદાવાદ સાયન્સ સિટી ખાતે આર્ટ ઓફ લિવિંગ અને ગુજરાત ટેકનોલોજિકલ યુનિવર્સિટીના ઉપક્રમે 'આઝાદી ના અમૃત મહોત્સવ'ના ભાગરૂપે 'નશામુક્ત ભારત' કાર્યક્રમનું આયોજન
નશામુકત ભારત કાર્યક્રમમાં ઉદ્યોગ મંત્રી શ્રી બલવંતસિંહ રાજપૂત તથા ગૃહ રાજ્યમંત્રી શ્રી હર્ષ સંઘવી ઉપરાંત આર્ટ ઓફ લિવિંગ સંસ્થાના સ્થાપક ગુરુદેવ શ્રી શ્રી રવિશંકરની પ્રેરક…
બાગાયતી પાક માટે ત્રણ શ્રેષ્ઠતા કેન્દ્રો મંજૂર
મિશન ફોર ઇન્ટિગ્રેટેડ ડેવલપમેન્ટ ઑફ હોર્ટિકલ્ચર (MIDH) હેઠળ વિવિધ રાજ્યોમાં સેન્ટર ઑફ એક્સલન્સ (CoE) ની સ્થાપના કરવામાં આવી રહી છે. આ COE બાગાયત ક્ષેત્રે નવી…
વાદળી રંગના ઘઉંથી ખેડૂતો થશે સમૃદ્ધ, વિદેશમાં ભારે માંગ
ઘઉંની ખેતી ખેડૂતો માટે નફાકારક સોદો સાબિત થઈ રહી છે. ઘઉંની આંતરરાષ્ટ્રીય માંગ વધી રહી છે. જેના કારણે વિદેશમાં ભારતીય ઘઉંની નિકાસ વધવા લાગી છે.…
ડાંગરની પ્રાપ્તિ 700 લાખ મેટ્રિક ટનને પાર થઈ, 96 લાખથી વધુ ખેડૂતોને ફાયદો થયો
ખરીફ માર્કેટિંગ સીઝન માટે ડાંગરની ખરીદી ખૂબ જ સરળતાથી ચાલી રહી છે, દેશમાં 20 ફેબ્રુઆરી સુધી 702 લાખ મેટ્રિક ટન કરતાં વધુ ડાંગરની ખરીદી કરવામાં…
આ રોકડીયા પાકો ખેડૂતભાઈઓને આપશે ખૂબ જ સારું વળતર
ભારતની આશરે 70 ટકા વસ્તી કૃષિ પર તેમની આજીવિકાનો આધાર ધરાવે છે. આ સંજોગોમાં દરેક ખેડૂતભાઈ ઈચ્છે છે કે તેઓ એવા પાકોની જ ખેતી કરે…
માર્ચ મહિનામાં ખાંડના નિકાસ ક્વોટામાં વધારો કરવા માટે વિચારણા કરાય તેવી શક્યતા
કેન્દ્ર સરકારે આ વર્ષના માર્ચ મહિને એટલે કે આગામી મહિને ખાંડની નિકાસને લગતા કક્વોટામાં વધારો કરવો કે નહીં તે અંગે યોગ્ય નિર્ણય લઈ શકે છે…
હીટવેવથી બચવું હોય તો કરો આટલું, આ ફળો તમને આપશે સમરમાં ભરપૂર એનર્જી
હવે ઉનાળાનો પ્રારંભ થઈ ગયો છે. ઉનાળામાં હીટવેવટના કારણે સૌથી વધુ સમસ્યાઓ ઊભી થાય છે પણ શું તમને ખબર છે કે આ હીટ વેવ શું…
ઉનાળામાં ફેવરિટ ફ્રુટ તરબૂચની ખેતી કેવી રીતે કરશો અને કેવી રીતે કરશો માવજત?
ઉનાળો શરૂ થાય કે દરેક તરત આવી જાય છે તરબૂચની યાદ જો કે હવે તો લોકો ઓફ સિઝનમાં પણ તરબૂચને એટલું જ આરોગે છે. પણ…
જો PM કિસાન યોજનાનો 13 મો હપ્તો લેવો હોય તો આટલું કરજો નહીંતર લિસ્ટમાંથી નામ થઈ જશે ગાયબ
જાન્યુઆરીના પહેલા અઠવાડિયાથી ખેડૂતો કાગડોળે પ્રધાનમંત્રી કિસાન સન્માન નિધિના 13મા હપ્તાની રાહ જોઈ રહ્યા છે. હવે ફેબ્રુઆરી મહિનાના 22 દિવસ બાદ પણ ખેડૂતોના ખાતામાં બે…
હુરુન ઈન્ડિયા દ્વારા મુંબઈમાં 'હુરુન મોસ્ટ રિસ્પેક્ટેડ એન્ટરપ્રિન્યોર્સ એવોર્ડ્સ'ની ૧૦મી આવૃત્તિનું આયોજન કરવામાં આવ્યું હતું, જેમાં ઉદ્યોગની ઘણી મોટી હસ્તીઓએ ભાગ લીધો હતો.
હુરુન ઈન્ડિયા દ્વારા મુંબઈમાં 'હુરુન મોસ્ટ રિસ્પેક્ટેડ એન્ટરપ્રિન્યોર્સ એવોર્ડ્સ'ની ૧૦મી આવૃત્તિનું આયોજન કરવામાં આવ્યું હતું, જેમાં ઉદ્યોગની ઘણી મોટી હસ્તીઓએ ભાગ લીધો હતો. કાર્યક્રમમાં એસએમએલ…
ભારતમાં પોસ્ટ-હાર્વેસ્ટ ઈન્ફ્રાસ્ટ્રક્ચરમાં નોંધપાત્ર સુધારો કરવાની જરૂર છેઃ નિષ્ણાતોએ આપ્યો મહત્વનો અભિપ્રાય
તાજેતરના સર્વે પ્રમાણે દેશની ઉપલબ્ધ સંગ્રહ ક્ષમતા એટલે કે સ્ટોરેજ કરવાની ક્ષમતા ભારતમાં ખેતીવાડી ક્ષેત્રે થતા કુલ ઉત્પાદન પૈકી ફક્ત 10% જ સંગ્રહ કરવાની ક્ષમતા…
કૃષિક્ષેત્રમાંથી આવ્યા ખુશીના સમાચાર, આ વર્ષે 32.36 મિલિયન ટન અનાજનું ઉત્પાદન થવાનો અંદાજ
કેન્દ્રીય કૃષિ મંત્રાલય દ્વારા કૃષિ વર્ષ 2022-23 માટે મુખ્ય પાકોના ઉત્પાદનના બીજા આગોતરા અંદાજો બહાર પાડવામાં આવ્યા છે. વર્ષ 2022-23 માટેના બીજા એડવાન્સ અંદાજ મુજબ,…
એક્વાપોનિક્સ: જલીયકૃષિ માં નવી તકનીક
વિશ્વ માં ઘણી ગંભીર સમસ્યાઓ છે જેમાં બેરોજગારી, ગરીબી, વસ્તી-વધારા ની સાથે સાથે જાળ-વાયુ પરિવર્તન, માટીનું ધોવાણ, પાણીની અછત, અને અન્નસુરક્ષા બધાથી મહત્વપૂર્ણ છે. તેથી,…
ફૂડ કોર્પોરેશન ઓફ ઈન્ડિયાના બીજા ઈ-ઓક્શનમાં 3.85 લાખ ટન ઘઉં 901 કરોડ રૂપિયામાં વેચાયા
ફૂડ કોર્પોરેશન ઓફ ઈન્ડિયા ઈ-ઓક્શનમાં રૂપિયા 901 કરોડમાં ઈ-બિડિંગમાં 3.85 લાખ ટન ઘઉંનું વેચાણ થયું છે. કોર્પોરેશને હરાજી દરમિયાન 15.25 LMT ઘઉંનો સ્ટોક ઓફર કર્યો…
ICL ઉત્તર પૂર્વમાં તેની છાપ છોડે છે; એક્સ્પો વન ખાતે પોષણ સોલ્યુશન્સની તેની વિશાળ શ્રેણીનું પ્રદર્શન કરે છે
150 થી વધુ ઓર્ગેનિક અને નેચરલ બ્રાન્ડ કંપનીઓએ તાજેતરમાં ગુવાહાટીમાં યોજાયેલા ઉત્તર પૂર્વ ભારતના પ્રથમ ઓર્ગેનિક મેળા, એક્સ્પો ONEમાં તેમના ઉત્પાદનોની વિશાળ શ્રેણીમાં ભાગ લીધો…
મેથીની ખેતી કેવી રીતે કરશો
મેથી એ પાંદડાવાળા ઔષધીય પાક છે. તેની ગણતરી મસાલેદાર પાકોમાં થાય છે. મેથીનો ઉપયોગ શાક, અથાણું અને લાડુ વગેરે બનાવવામાં થાય છે. ભલે તે સ્વાદમાં…
વેલેન્ટાઈન ડે પર મોંઘવારી હાવી, જાણો એક છૂટક ગુલાબ પણ બન્યું ભારે મોંઘુ
આજે વેલેન્ટાઈન ડે અને સાથો સાથ લગ્નપ્રસંગ નીમિતે ગુલાબના ભાવમાં વધારો થતા એક ગુલાબના ફુલના 20 રૂપિયાના બદલે 30 રૂપિયા થઈ ગયા છે. આજે લાલ…
શું તમે પણ બ્લડશુગરથી પીડાવ છો તો આ મસાલાઓને એડ કરો લાઈફ સ્ટાઈલમાં
બ્લડ શુગરને કંટ્રોલમાં રાખવું ખૂબ જ જરૂરી છે. બદલાતા સમયની સાથે જીવનશૈલી પણ બદલાઈ ગઈ છે. બલ્ડ શુગરમાં વધ ઘટ એ પણ અનિયમિત ખાન-પાન અને…
આજે છે વર્લ્ડ પલ્સેસ ડે, જાણો આ દિવસ પાછળનું શું ખાસ કારણ?
દાળ ભારતીય ભોજનનો એક મુખ્ય હિસ્સો છે એમ કહીએ તો પણ એમાં કંઇ ખોટુ નથી. દાળ વગર ભોજનનો સ્વાદ જાણે અધૂરો હોય એમ લાગે છે.…
બટાકાની ખેતી કેવી રીતે કરવી? અહીં શીખો
બટેટા શાકભાજીનો રાજા છે. ગરીબ હોય કે અમીર, ભાગ્યે જ કોઈનો દિવસ બટાકા ખાધા વગર પસાર થાય છે. બટાટા રવિ સિઝનના મુખ્ય પાકોમાંનો એક છે.…
બોલીવુડની સ્ક્રીન પરથી ગાયબ સ્ટાર એક્ટર્સ જુહી આજકાલ કરી રહી છે ઓર્ગેનિક ખેતી
બોલીવુડ અભિનેત્રી જુહી ચાવલા છેલ્લા ઘણા સમયથી પરદા પર જોવા મળી રહી નથી. પણ આ અભિનેત્રી એટલી જ સોશિયલ મીડિયા પર એક્ટિવ છે. જુહી ચોક્કસપણે…
વધુ દૂધ આપતી દેશી ગાયની 5 જાતિ
આપણા દેશમાં ગાયને સદીઓથી ઉછેરવામાં આવે છે. આપણી સંસ્કૃતિમાં ગાય માતા સમાન છે. પ્રાચીન સમયમાં ભારતની અર્થવ્યવસ્થામાં ગાયનું ઘણું મહત્વ હતું. આપણા દેશમાં ગાયની સેંકડો…
થાઈરોડથી તમારું વજન વધી રહ્યું છે?તો વાંચી લો આ આર્ટિકલ
ઘણી બીમારીઓનું કારણ આપણું ખરાબ ખાણી-પીણી પણ છે. ડાયાબિટીસ, થાઈરોઈડ અને આર્થરાઈટીસ જેવી બીમારીઓ હવે લોકોમાં સામાન્ય બની ગઈ છે. તમને જણાવી દઈએ કે થાઈરોઈડના…
આ વિદેશી ફ્રુટની ખેતી કરી મેળવો લાખોની આવક,જાણો કેવી રીતે કરશો ડ્રેગનફ્રુટની ખેતી
દેશના ઘણા ખેડૂતો વિદેશી પાક ઉગાડવામાં પોતાનો હાથ અજમાવી રહ્યા છે. આવો જ એક વિદેશી પાક ડ્રેગન ફ્રૂટ છે. આ એક એવો પાક છે, જે…
તમે પણ શિયાળામાં ડેન્ડ્રફની સમસ્યાથી ત્રાસી ગયા છો, તો આ છે નિવડો; આ રીતે કરો વાળની માવજત
શિયાળાની સિઝનમાં હેર ફોલ ડેન્ડ્રફ ની સમસ્યા સામાન્ય છે. મોટા ભાગના લોકોને આ ફરિયાદ રહેતી હોય છે. શિયાળાની સિઝન વાળનું મોશ્ચર ઉડી જાય છે અને…
શું તમે પણ કોબીજને કરો છો હેટ, આ આર્ટિકલ વાંચીને તમે શરૂ કરી દેશો કોબીજને લવ કરવાનું
શું તમે પણ કોબીજને હેટ કરો છો અને જમવામાં અવોઈડ કરો છો. તો આ આર્ટિકલ ખાસ આપના માટે છે.. કોબીજને ભોજનમાં શામેલ કરવાથી ઘણી બિમારીઓથી…
લાલ મૂળાની ખેતી કરો અને થઈ જાવ માલામાલ, જાણો કેવી રીતે કરાય છે લાલ મૂળાની ખેતી; ઝડપથી વાંચી લો આ ન્યૂઝ
ખેડૂતો આજ કાલ અવનવી ખેતી કરી આવકને બમણી કરવાના પ્રયાસમાં લાગી ગયા છે.એવામાં પણ શિયાળો એટલે લીલા અને રંગબેરંગી શાકભાજીની ઋતુ. આ ઋતુમાં લોકો અવનવા…
ભયંકર ખાંસી અને કફનો રામબાણ ઈલાજ, ડોક્ટર પાસે નહીં પણ બધી જ દવા મળી રહેશે કિચનમાંથી
શિયાળાની ઋતુમાં અનેક મોસમી બીમારીઓ ઘર કરી જાય છે, જેમાં શરદી-ઉધરસ અને તાવ તો સામાન્ય છે. ઘણી વખત આ શરદી ની સાથે એલર્જી ની સમસ્યા,…
શું તમે પપૈયાની ખેતી કરીને થવા માંગો છો માલામાલ તો જોઈ લો આ પદ્ધતિ, આવી રીતે થશે મબલખ ઉત્પાદન
ભારતમાં ફળપાકોના કુલ વાવેતર વિસ્તારમાં ૯૬ લાખ હેકટર વિસ્તાર સાથે પપૈયાનો હિસ્સો પ % છે, જયારે ગુજરાતમાં આ હિસ્સો ર૧.૩ % છે. ફળપાકોમાં ૫પૈયા (papaya)…
આ વર્ષે રવિ વાવેતરમાં 22 લાખ હેક્ટરનો થયો વધારો
ગયા વર્ષની સરખામણીમાં આ વર્ષે દેશમાં રવિ વિસ્તાર 22 લાખ જેટલો છે. કરતાં વધુ વધારો થયો છે ગયા વર્ષે જ્યાં 697.98 લાખ હેક્ટરમાં વાવણી થઈ…
મગફળીમાં જીવાતોનું યોગ્ય નિયંત્રણ મેળવીને મેળવો મબલખ ઉત્પાદન
મગફળી ખાદ્ય તેલિબિયાંનો પાક છે. તેનુ વાવેતર ખરીફ અને ઉનાળુ બંને ઋતુમાં થાય છે. આ પાકને વાતાવરણ સંબંધિત અને જૈવિક પરિબળોથી નુકસાન થતુ હોય છે.…
શ્રી અન્ન યોજનાથી બરછટ અનાજને પ્રોત્સાહન મળશે, ખેડૂતો માટે ઘણી ભેટ
નાણામંત્રી નિર્મલા સીતારમણે 2024ની લોકસભા ચૂંટણી પહેલા મોદી સરકારના કાર્યકાળનું છેલ્લું સંપૂર્ણ સામાન્ય બજેટ 2023-24 રજૂ કર્યું હતું. સંસદમાં સામાન્ય બજેટ રજૂ કરતા નાણામંત્રી નિર્મલા…
મધમાખી ઉછેર ક્યારે કરવામાં આવે છે? સંપૂર્ણ વિગતો જાણો
ભારતમાં મધમાખી ઉછેર એ પણ ખેતી અને બાગાયતની જેમ ખેતીનો એક ભાગ છે. મધમાખી ઉછેરનો ધંધો પણ માનવ જાતિના લાભમાં ઘણો મોટો ફાળો આપે છે.…
સિંચાઈના પાણીનો ખેતીવાડી ક્ષેત્રમાં સદઉપયોગથી ઉત્પાદનમાં વધારો કરીએ
સિંચાઈ અને ખેતી એક સાથે બીજા સાથે જોડાયેલ છે. માનવી જ્યારથી ખેતી કરતો થયો છે ત્યારથી જ તે સિંચાઈ સાથે જોડાઈ ગયો હતો. સદીઓથી ખેતીના…
દેશમાં ઘઉંનું વિક્રમી ઉત્પાદન થાય તેવી શક્યતા, વાતાવરણ આ પાકના ઉત્પાદન માટે બિલકુલ અનુકૂળ
હાલનું હવામાન ઘઉંના વિકાસ માટે ખૂબ જ સાનુકૂળ છે અને આ વર્ષે ઘઉંનું વિક્રમી ઉત્પાદન થવાની ધારણા છે. એટલે કે ઘઉંના પાક માટે વર્તમાન સમયમાં…
કૃષિ ઉત્પાદનમાં ટ્રાઇકોડર્માનું મહત્વ શું છે તે જાણો
ફૂગની ઘણી પ્રજાતિઓ (મોલ્ડ) આપણી જમીનમાં જોવા મળે છે, એક તરફ કેટલીક પ્રજાતિઓ પાકને નુકસાન પહોંચાડે છે (દુશ્મન મોલ્ડ) તો બીજી તરફ કેટલીક પ્રજાતિઓ ફાયદાકારક…
ફ્રેન્ચ બીનની ખેતી કેવી રીતે કરવી - લાખો રૂપિયાની કમાણી થશે
શિયાળાની ઋતુ ચાલી રહી છે. આ દિવસોમાં રવિ પાકની વાવણી પૂરજોશમાં ચાલી રહી છે. ખેડૂતો તેમના ખેતરોમાં રવિ પાકો જેવા કે ઘઉં, ચણા, સરસવ વગેરેની…
પાત્રમાં ભીંડાનું વાવેતર કેવી રીતે કરવું અને ભીંડાના છોડની સંભાળ કેવી રીતે રાખવી?
જો તમે પણ તાજા શાકભાજીના શોખીન છો, તો તમે ઘરે પાત્રમાં ઓર્ગેનિક શાકભાજી ઉગાડીને સ્વાદિષ્ટ ભોજનનો આનંદ માણી શકો છો. તો મિત્રો, જો તમને આ…
મકાઈની ખેતી આરોગ્ય અને આવક માટે ફાયદાકારક છે
મકાઈને એવા અનાજ કહેવામાં આવે છે, જેનું ઉત્પાદન ભારતની ધરતી પર 1600 ઈસવીસનના અંતમાં જ થવાનું શરૂ થયું હતું અને આજે ભારત વિશ્વના મુખ્ય ઉત્પાદક…
ચીકુ ઉછેરથી થશે 5 લાખ રૂપિયા સુધીની કમાણી - જાણો ખેતીની સાચી રીત
આજકાલ ખેડૂતો પરંપરાગત પાકોની સાથે બાગાયતી ફળોની ખેતી કરીને સારો નફો કમાઈ રહ્યા છે. ખેડૂતોને બાગાયતી પાકની ખેતી કરવા પ્રોત્સાહિત કરવાના હેતુથી સરકાર સમયાંતરે વિવિધ…
શાકભાજીની ખેતી કરીને કેવી રીતે કરી શકાય છે સમૃદ્ધ
આજે પણ ઘણા ખેડૂતો ખેતીકામ કરીને લાખોની કમાણી કરી રહ્યા છે. અને તમારું ઘરેલું જીવન સફળ બનાવવા માટે, જો તમે પણ ખેતીમાંથી પૈસા કમાવા માંગતા…
બંજર જમીનને કેવી રીતે ફળદ્રુપ બનાવવી
જમીન વાસણની હોય કે ખેતરની હોય, જમીનને ફળદ્રુપ બનાવવા માટે બોરોન, નાઈટ્રોજન, ફોસ્ફરસ, પોટેશિયમ, આયર્ન, જસત, તાંબુની જરૂર પડે છે, તેમજ ગાયનું છાણ, ખાતર કે…
મેથીની ખેતી ક્યારે કરવી, મેથી વાવવાનો યોગ્ય સમય કયો
મેથીની ખેતી માટે ઠંડુ વાતાવરણ સારું માનવામાં આવે છે. તેથી જ તેની ખેતી ઓક્ટોબરથી ફેબ્રુઆરી સુધી કરવામાં આવે છે. ઉનાળામાં તેની ખેતી કરી શકાતી નથી.…
રીંગણની ખેતી માટે દવા, રીંગણના છોડમાં જીવાતનું નિયંત્રણ કેવી રીતે કરવું?
રીંગણના છોડમાં જીવાત નિયંત્રણ- જો કોઈ ખેડૂત રીંગણના પાકમાં સૌથી વધુ પરેશાન હોય તો તે રીંગણની ઈયળ છે, જો કે રીંગણની ખેતીમાં અનેક પ્રકારના રોગો…
ટમેટાના તમામ ખતરનાક રોગોથી પાકને કેવી રીતે બચાવવો
ખેડૂત ભાઈઓ, જો તમે શિયાળાની ઋતુમાં ટામેટાની ખેતી કરશો તો તમારે પણ ઘણી બીમારીઓનો સામનો કરવો પડશે. શિયાળાની સરખામણીએ ઉનાળામાં થતી ટામેટાંની ખેતીમાં બહુ ઓછા…
કિસાન ક્રેડિટ કાર્ડ યોજના ૨૦૨૩
કિસાન ક્રેડિટ કાર્ડ લોનનો એક પ્રકાર છે. જે બેંકો દ્વારા ખેડૂતોને સસ્તા વ્યાજ દરે (૪%) ઉપલબ્ધ કરાવવામાં આવે છે. આ યોજના ભારત સરકાર, ભારતીય રિઝર્વ…
કૃષિ બજેટ ૨૦૨૩ : MSPની રકમ સીધી ખેડૂતોના ખાતામાં ટ્રાન્સફર કરવામાં આવશે, જમીનના રેકોર્ડને ડિજીટલ કરવામાં આવશે.
કૃષિ બજેટ ૨૦૨૩ : MSPની રકમ સીધી ખેડૂતોના ખાતામાં ટ્રાન્સફર કરવામાં આવશે, જમીનના રેકોર્ડને ડિજીટલ કરવામાં આવશે. નાણામંત્રી નિર્મલા સીતારમણે ખેડૂતોને મોટી રાહત આપી છે.…
હવે મશરૂમ કોઈપણ સિઝનમાં ઉગાડી શકાય છે
હવે મશરૂમ કોઈપણ સિઝનમાં ઉગાડી શકાય છે, આ ટેક્નિક થી નફો વધારી શકાશે. મશરૂમની ખેતી: મશરૂમ એ ઠંડી ઋતુનો પાક છે, પરંતુ વિપરીત તાપમાનમાં મશરૂમ…
Budget 2023
બજેટ ૨૦૨૩ : આવકવેરાને લઈને મધ્યમ વર્ગ માટે સારા સમાચાર, મહિલાઓ અને વરિષ્ઠ નાગરિકો માટે મોટી જાહેરાત કેન્દ્રીય નાણાં પ્રધાન નિર્મલા સીતારમણે દેશનું સામાન્ય બજેટ…
ધાણાના પાકને હિમથી કેવી રીતે બચાવશો!
શિયાળાની ઋતુમાં જ્યારે તાપમાનનો પારો શૂન્ય ડિગ્રી સેલ્સિયસથી નીચે પહોંચે છે, ત્યારે વાતાવરણમાં હાજર નાના ઝાકળના ટીપાં, જેને અંગ્રેજીમાં ડ્યૂ કહે છે, બરફ જેવા ઘન…
ભારતમાં ખેતીના પ્રકાર
ભારતમાં ખેતીના પ્રકાર આજે, ભારત વિશ્વમાં બીજા ક્રમે સૌથી વધુ પાક ઉત્પાદન ધરાવે છે. આપણા દેશની અર્થવ્યવસ્થા ખેતી પર નિર્ભર છે. અહીંના મોટાભાગના લોકો ખેતી…
ગુજરાતનું ધોલેરા બનશે ભારત દેશનું પ્રથમ સ્માર્ટ સિટી
આપ સૌએ ઉત્તરાયણ સારી રીતે ઉજવણી કરી હશે અને આપ સૌ જાણો છો કે આ વખતે પતંગોત્સવ ધોલેરા અને સ્ટેચ્યુ ઓફ યુનિટી માં થયો હતો.…
પી એમ કિશાન યોજના : ખાતામાં આવશે ૮,૦૦૦ રૂપિયા
પીએમ કિસાન સન્માન નિધિ યોજના હેઠળ, લાભાર્થી ખેડૂતોને દર ૪ મહિને ૨,૦૦૦ રૂપિયા આપવામાં આવે છે. કુલ વાર્ષિક રકમ ૬,૦૦૦ રૂપિયા છે. તે સીધા બેંક…
''ક્લિન-ગ્રીન ઊર્જાયુક્ત ગુજરાત'' વિષય આધારિત નવી દિલ્હીમાં પ્રજાસતાક દિને રજૂ થશે ગુજરાતની ઝાંખી
કચ્છ-મોઢેરાની સાંસ્કૃતિક ઝલક અને સૌર-પવનઊર્જાના વિજ્ઞાનિક-તકનીકી અભિગમનું એકીકરણ કરીને પુનઃ પ્રાપ્ય-હરિત અને શુદ્ધઊર્જાના નિર્માણ દ્વારા ઊર્જાક્ષેત્રે દેશ અને દુનિયાને નવી રાહ ચીંધવાનો ઝાંખી દ્વારા સુંદર…
દર વર્ષ ૨૬ જાન્યુઆરી એ જ કેમ મનાય છે ગણતંત્ર દિવસ ?
ભારત દર વર્ષે 26 જાન્યુઆરીએ ગણતંત્ર દિવસ ઉજવે છે. ભારતના ઈતિહાસમાં આ દિવસનું એક અલગ જ મહત્વ છે. આ વર્ષે દેશ તેનો ૭૪ ગણતંત્ર દિવસ…
લોકસભાના અધ્યક્ષ શ્રી ઓમ બિરલાએ રાજસ્થાનના કોટા ખાતે બે દિવસીય કૃષિ મહોત્સવ-પ્રદર્શન અને તાલીમ કાર્યક્રમનું ઉદ્ઘાટન કર્યું
જ્યારે આપણા ખેડૂતો નવી કૃષિ પદ્ધતિઓ, નવીનતા, મૂલ્યવર્ધન, પ્રતિ ડ્રોપ વધુ પાક વગેરેનો ઉપયોગ કરશે ત્યારે આત્મનિર્ભર ભારત બનશે: શ્રી ઓમ બિરલા…
ખેતી કરતા કરતા મશીન બગડે તો હવે ગભરાશો નહીં, સરકાર લઈને આવી છે એક પ્લાન કે તમે કરી દેશો જાતે જ મશીન ઠીક
આજનો ખેડૂત ઘણી ખરી બાબતોમાં ટેકનોલોજીના સહારે થઈ ગયો છે.એવામાં બિહાર સરકાર કૃષિ વિભાગને હાઈટેક કરવામાં લાગી ગઈ છે. જેના માટે ઘણા મહત્વના નિર્ણયો પણ…
HDFCની "બેંક ઓન વ્હીલ્સ" વાન તમિલનાડુના વિરુંધુનગર જિલ્લામાં સક્રિય
ગુજરાત, મહારાષ્ટ્ર, પશ્ચિમ બંગાળ અને પંજાબ પછી, તામિલનાડુ પાંચમું રાજ્ય છે જ્યાં આ સેવા લોકોને ઉપલબ્ધ કરાવવામાં આવે છે.…
પિયૂષ ગોયલે વ્યવસાયોને તેમની રીતોમાં પર્યાવરણલક્ષી અને સતત વિકાસનો અભિગમ અપનાવવા જણાવ્યું
જી20ની થીમ - ‘એક પૃથ્વી, એક પરિવાર, એક ભવિષ્ય’- દ્વારા ભારત દુનિયાને એકબીજાની કાળજી લેવા, સંવાદ વધારવા તથા પૃથ્વી અને આપણા બાળકોના ભવિષ્ય માટે ચિંતાઓ…
શા માટે આપણે જૈવિક ખાતરોનો ઉપયોગ કરવો જોઈએ
ઉન્નત પાક કે નફાકારક પાક એ ખેડૂતો માટે મોટો પ્રશ્ન બની રહ્યો છે, આ માટે તેઓ વિવિધ પ્રકારના રાસાયણિક ખાતર કે ખાતરનો ઉપયોગ પણ કરી…
મીઠી જુવારની કરો ખેતી, થશે અનેક ગણા લાભો
મીઠી જુવાર, જેને ગોડા જુવાર (મરાઠી), મીઠી જુવાર (બંગાળી), જોલા (કન્નડ), ચોલમ (મલયાલમ, તમિલ), જોનાલુ (તેલુગુ) તરીકે પણ ઓળખવામાં આવે છે, તે અનાજની જુવાર જેવી…
ખાંડની નિકાસ અંગે સરકાર લેશે મોટા નિર્ણય સાથે વધુ એક વસ્તું સસ્તી થવાના એંધાણ
ચીન ઉપરાંત ભારતે બાંગ્લાદેશમાં 1.47 લાખ ટન, શ્રીલંકામાં 82,462 ટનની (ઓક્ટોબર-જાન્યુઆરી) નિકાસ કરી છે તેવું ઓલ ઇન્ડિયા સુગર ટ્રેડ એસોસિએશને (AISTA) જણાવ્યું હતું. હવે ગુડ…
રવિ પાકમાં છોડ સંરક્ષણને લગતી આ માહિતી જાણવી જરૂરી છે
જંતુઓ, રોગો, નીંદણ માનવ સમાજના દેખાવના ઘણા સમય પહેલાથી જ પૃથ્વી પર હાજર હતા. પર્યાવરણ, હવામાન અને પ્રકૃતિની ચરમસીમા સામે લડતા, હંમેશા પોતાની હાજરી બતાવતા…
મીઠી જુવારની ખેતી અને તેની આ પદ્ધતિ અપનાવો
મીઠી જુવાર, જેને ગોડા જુવાર (મરાઠી), મીઠી જુવાર (બંગાળી), જોલા (કન્નડ), ચોલમ (મલયાલમ, તમિલ), જોનાલુ (તેલુગુ) તરીકે પણ ઓળખવામાં આવે છે, તે અનાજની જુવાર જેવી…
નાસપતીની ખેતી કેવી રીતે કરશો - લાખો રૂપિયાની કમાણી થશે
આપણા દેશના ખેડૂતો પરંપરાગત પાકોની સાથે વિવિધ પ્રકારના ફળોની ખેતી કરીને તેમની આવકમાં વધારો કરે છે. આ એપિસોડમાં, ખેડૂત ભાઈઓ નાશપતીનું વાવેતર કરીને સારો નફો…
લીલા ચારા માટે આદર્શ છે જુવારનો આ પાક
ખરીફમાં 80-85 ટકાની સાપેક્ષ ભેજ પાકની વૃદ્ધિ માટે યોગ્ય છે અને સરેરાશ 500-750 મીમી વરસાદ અને ખરીફમાં 33-34 °Cનું મહત્તમ તાપમાન સારી વૃદ્ધિ માટે આદર્શ…
ખેતીમાં નવીનતાએ વર્ષ 2022માં ઉત્પાદનમાં કર્યો વધારો
ગત વર્ષ 2022માં, સરકારે દેશના ખેડૂતોની આવક બમણી કરવા અને દરેક ખેડૂતના લાભ માટેની યોજનાઓનો લાભ પાયાના સ્તર સુધી પહોંચે તે સુનિશ્ચિત કરવા માટે તમામ…
પેકેજ્ડ ડ્રિકિંગ વોટરના ઉત્પાદન યુનિટ પર ભારતીય માનક બ્યુરોના દરોડા
ભારતીય માનક બ્યુરોના અધિકારીઓ દ્વારા બ્યુરો પાસેથી માન્ય લાયસન્સ લીધા વિના આઈએસઆઈ માર્ક વિનાના પેકેજ્ડ ડ્રિંકિંગ વોટરના ઉત્પાદનમાં સંડોવાયેલા હોવાની માહિતીના આધારે તા. 11.01.2023નાં રોજ…
કચરામાંથી સારું ખાતર બનાવો
છેલ્લા ચાર દાયકાથી ભારતીય કૃષિ ક્ષેત્રમાં પાક ઉત્પાદનમાં થયેલો વધારો મુખ્યત્વે અદ્યતન તકનીકોને અપનાવવા અને રાસાયણિક ખાતરો અને જંતુનાશકોના મોટા જથ્થામાં ઉપયોગને કારણે છે. તેમની…
ભારતમાં પ્રથમ વખત, FSSAI બાસમતી ચોખા માટે વ્યાપક નિયમનકારી ધોરણોને સૂચિત કરાયા; 1લી ઓગસ્ટ, 2023થી લાગુ કરવામાં આવશે
તેમાં બાસમતી ચોખાની કુદરતી સુગંધની લાક્ષણિકતા હોવી જોઈએ અને તે કૃત્રિમ રંગ, પોલિશિંગ એજન્ટો અને કૃત્રિમ સુગંધથી મુક્ત હોવી જોઈએ…
પતંગ ઉડાવો પણ સાવચેતી સાથે
પતંગ ઉડાવો પણ સાવચેતી સાથે ભારતમાાંઉત્તરાયણ ૧૪ જાન્યુઆરી એ ઉજવાય છે. આ તીલ-ગોળ અનેપતાંગ ઉડાવવાનો તહેવાર છે. આ ખુશીનો તહેવાર પણ છે. મકરસાંક્ાાંતતની ઉજવણી કરતી…
કૃષિ: જીવન માટે સજીવ ખેતી
ખાતરો, દવાઓ અને જંતુનાશકોથી ભરપૂર ઝેરી ઉત્પાદનની ઘાતક અસરો અને કેટલાક નવા વ્યવસાયની શક્યતાઓને લીધે, આજકાલ સજીવ ખેતીમાં ખૂબ જ ચર્ચા છે, પરંતુ શું આ…
ગ્રીનહાઉસમાં જમીનની તૈયારી, મલ્ચીંગ અને શુદ્ધિકરણ (સોઈલ સોલારાઈઝેશન અને ફ્યુમીગેશન)
ગ્રીનહાઉસમાં જમીન સારા નિતારશક્તિ, મહતમ કાળી અથવા ગોરાળું જમીન જરૂરી છે. ગ્રીનહાઉસમાં જમીનની તૈયારીની શરૂઆત ડિસ્કિંગ, રોટોટીલિંગ અથવા માટીને હાથથી ફેરવી અને ઠેફાં ભાંગીને જમીનની…
I&B મંત્રાલયે ટીવી ચેનલોને અવ્યવસ્થિત ફૂટેજ, દુ:ખદાયક તસવીરો પ્રસારિત કરવા સામે ચેતવણી આપી
રક્ત, મૃતદેહો, શારીરિક હુમલાની વિચલિત કરતી છબીઓ પ્રોગ્રામ કોડની વિરુદ્ધ, દુઃખદાયક છે ચેનલો દ્વારા સોશિયલ મીડિયામાંથી લેવામાં આવતા હિંસક વીડિયોનું કોઈ એડિટીંગ કરવામાં આવતું નથી…
જમીનની ફળદ્રુપતા જાળવવા માટે અળસિયાનું ખાતર જરૂરી છે
આજના સઘન ખેતીના યુગમાં જમીનની ફળદ્રુપતા જાળવવા માટે ગાયનું છાણ, ખાતર અને લીલું ખાતર મુખ્ય કુદરતી ખાતર છે. ખાતર બનાવવા માટે, પાકના અવશેષો, પશુઓના શેડનો…
શક્કરિયાની ખેતીથી ખેડૂતોની આવક વધશે, આ રીતે મેળવો લાભ
ભારતમાં લગભગ તમામ પ્રકારની ખેતી કરવામાં આવે છે. ભારતના દરેક રાજ્ય અને પ્રદેશમાં અલગ-અલગ આબોહવાને કારણે જમીનમાં તફાવત છે, જેના કારણે અલગ-અલગ સમયે અલગ-અલગ પાકની…
ખરીફ સિઝનમાં જુવારની ખેતી વિશે સંપૂર્ણ માહિતી
પરિસ્થિતિઓમાં ટકી રહેવાની ક્ષમતા સાથે, જુવાર ટકાઉ કૃષિ મોડેલમાં ખૂબ જ સારી રીતે બંધ બેસે છે અને સીમાંત ખેડૂતો માટે ઉત્તમ વિકલ્પ પૂરો પાડે છે.…
બારે મહિને મળતુ લીલુ ખાતર એટલે એઝોલા
ખાતર તરીકે વપરાતી લીલી અવિઘટીત વનસ્પતિને લીલું ખાતર કહે છે. લીલું ખાતર એ કુદરતી ખાતરોમાંનું એક છે જે બે રીતે જૈવિક ખેતીને ટેકો આપે છે:…
ODOPનું રાષ્ટ્રવ્યાપી જાગૃતિ અભિયાન શરૂ કરવામાં આવ્યું
ઈન્વેસ્ટ ઈન્ડિયાના ઉદ્યોગ વિભાગ, ગુજરાત અને ભારત સરકાર વતી સૂક્ષ્મ, નાના અને મધ્યમ ઉત્પાદકો, વિક્રેતાઓ અને મીડિયા સાથે સંવાદ યોજાયો…
"આ શો આપણા ખેડૂતો માટે વિશ્વભરમાંથી શ્રેષ્ઠ જ્ઞાન અને કુશળતા લાવશે": વિજય સરદાના
વિજય સરદાના જેઓ એક ટેકનો-કાનૂની નિષ્ણાત છે. તેમણે અને કૃષિ જાગરણે સાથે મળીને ખેડૂતો માટે એક ચેટ પ્રોગ્રામ બનાવ્યો છે જેમાં ભૂતપૂર્વ કૃષિ-નિષ્ણાતો અને મહત્વપૂર્ણ…
માણસને કેટલી જોડ કપડાં જોઈએ ?
અમદાવાદની અરવિંદ મિલના માલિક કસ્તુરભાઈ લાલભાઈ ઘસાયેલાં કપડાં પહેરતા. કરોડો લોકો માટે કપડાંનું ઉત્પાદન કરનારા અને શિક્ષણ ક્ષેત્ર માટે ક્ષણ માત્રમાં લાખો-કરોડો રૂપિયાનું દાન આપનારા…
ભોળા કબૂતરની ચરક જીવલેણ હોય છે ?, નિર્દોષ પારેવાની હગાર માણસના ફેફસાંને ખલાસ કરી શકે છે ?
હમણાં અમે એક 45 વર્ષનાં એક સ્વજન બહેન, નામે નીપાબહેન ચાવડા ગુમાવ્યાં. બે બાળકોએ માતા, એક પતિએ પ્રેમાળ પત્ની અને એક પરિવારે કુળવધૂ ગુમાવી. ઘરમાં…
ભારતના ટોચના ન્યુટ્રિશનિસ્ટ અને ફિટનેસ નિષ્ણાતો Fit Indiaના નવા ટોક શો સાથે નાગરિકોને તેમના નવા વર્ષની ફિટનેસ પ્લાન તૈયાર કરવામાં મદદ કરવા તૈયાર
આ કાર્યક્રમ 8મી જાન્યુઆરીથી 26મી ફેબ્રુઆરી, 2023 સુધી ફીટ ઇન્ડિયાના અધિકૃત ઇન્સ્ટાગ્રામ અને યુટ્યુબ હેન્ડલ્સ પર દર રવિવારે સવારે 11 વાગ્યે શરૂ થાય છે.…
દેશમાં ઘઉંનો વાવેતર વિસ્તાર 2.11 કરોડ હેક્ટરે પહોંચ્યો છે
ઘઉંનો વાવેતર વિસ્તાર 2.11 કરોડ હેક્ટરે પહોંચ્યો છે - શિયાળાની શરૂઆત સાથે દેશમાં ઘઉંની વાવણીમાં પણ તેજી આવી છે. અત્યાર સુધીમાં (2 ડિસેમ્બરના રોજ) ઘઉંનું…
બારલેરિયા: વૈવિધ્યસભર ઉપયોગ માટે પરંપરાગત ફૂલ પાક
બારલેરિયા એક આકર્ષક નાનું સદાબહાર સ્વદેશી સુશોભન છોડ છે જે એકેન્થેસી કુટુંબનું છે. તે ઉગાડવામાં સરળ લગભગ 3 ફૂટની ઊંચાઈએ વધે છે, જેનો ઉપયોગ વાડ…
ઊંટની વસ્તીમાં થઈ રહ્યો છે ભારે ઘટાડો, સંસદમાં આપવામાં આવી માહિતી
19મી પશુધન વસ્તી ગણતરી (2012)ની સરખામણીમાં, 20મી પશુધન ગણતરીમાં ઊંટની વસ્તી 4 લાખથી ઘટીને 2 લાખ 52 હજાર થઈ છે. આ ચોંકાવનારા આંકડા પશુપાલન મંત્રી…
ફુલો ને આધારિત વ્યવસાયની તકો
ફૂલો એ ભગવાનની સૌથી દિવ્ય રચના છે. ફૂલો દરેકને આકર્ષે છે અને માનવ જીવનમાં હંમેશા આકર્ષણનું કેન્દ્ર બને છે. ફૂલો શુદ્ધતા, સુંદરતા, શાંતિ, પ્રેમ અને…
દૂધની શ્રેષ્ઠ ગુણવત્તા અને સ્વચ્છતા સુનિશ્ચિત કરવા માટે દૂધ ઉત્પાદન અને સંચાલનની વૈજ્ઞાનિક પદ્ધતિ
માનવી લાંબા સમયથી દૂધ અને દૂધની બનાવટોનો ખોરાક તરીકે ઉપયોગ કરી રહ્યો છે કારણ કે તેમાં શરીરના નિર્માણ માટે જરૂરી અને સુપાચ્ય તત્વો સંતુલિત સ્વરૂપમાં…
લીલી ડુંગળીની ખેતી અને તેનું વ્યાપારી મહત્વ
લીલી ડુંગળી જેને આપણે કંદયુક્ત ફળના નામથી પણ જાણીએ છીએ. તેનો છોડ દેખાવમાં લસણ જેવો જ દેખાય છે. તેના પાંદડા સીધા અને આકારમાં પોઇન્ટેડ હોય…
ગાજર ઘાસનો ઉકેલ મળ્યો, હવે ઓર્ગેનિક ખાતર બનાવાશે
ગાજર ઘાસ (પાર્થેનિયમ હિસ્ટેરોફોરસ) પર્યાવરણ માટે ખરાબ માનવામાં આવે છે, જ્યારે પ્રાણીઓ પણ આ ઘાસ ખાવાનું પસંદ કરતા નથી. આ ઘાસના પરાગથી ખરજવું, અસ્થમા અને…
દ્રાક્ષની ખેતીથી ખેડૂતોની આવક વધી રહી છે, જાણો સંપૂર્ણ માહિતી
મહારાષ્ટ્રમાં સૌથી વધુ દ્રાક્ષની ખેતી થાય છે. અહીંના ખેડૂતો તેની ખેતીથી ખૂબ સારી કમાણી કરી રહ્યા છે. મહારાષ્ટ્રના નાસિકમાં તેની સૌથી વધુ ખેતી થાય છે.…
વડા પ્રધાન નરેન્દ્ર મોદીના માતા હીરાબેન મોદીનું શુક્રવારે ૧૦૦ વર્ષની વયે નિધન થયું હતું
વડા પ્રધાન નરેન્દ્ર મોદીના માતા હીરાબેન મોદીનું શુક્રવારે ૧૦૦ વર્ષની વયે નિધન થયું હતું - લગભગ 3.30 વાગે તેણીએ અંતિમ શ્વાસ લીધા.તેમને અમદાવાદની યુએન મહેતા…
ગુલાબના મુખ્ય જંતુઓ અને નિવારણ
એફિડ (ચંપા) - આ જંતુનો હુમલો જાન્યુઆરી-ફેબ્રુઆરીમાં થાય છે. આ નાના કાળા રંગના જંતુઓ ફૂલો અને કળીઓ પર ચોંટી જાય છે.આ જંતુના શિશુ અને પુખ્ત…
હાલની સ્થિતિમાં ગાજર અને ટામેટાના પાકની જાળવણી કેવી રીતે કરવી
ગાજર-ટામેટા શાકભાજીના પાકની જાળવણી બાબતે હાલમાં ગાજરનો પાક 40 થી 45 દિવસ જેટલો થયો છે. ખેતરમાં બીજ વધુ હોવાને કારણે જ્યાં છોડ વધુ અને ગાઢ…
કોરોનાવાયરસ સમાચાર અપડેટ
કોરોના વાયરસઃ દેશ અને સમગ્ર વિશ્વમાં કોરોના વાયરસની સ્થિતિ ઝડપથી બગડી રહી છે. જાપાનમાં અત્યારે કોરોનાની 8મી લહેર ચાલી રહી છે ત્યારે ચીનમાં દરરોજ ૪૦૦…
ભારતમાં રમતગમત દિવસની ઉજવણી
ભારતમાં રાષ્ટ્રીય રમત દિવસ ૨૯ ઓગસ્ટના રોજ ઉજવવામાં આવે છે, જે હોકીના દિગ્ગજ મેજર ધ્યાનચંદની જન્મજયંતિ છે. આ દિવસને ૨૦૧૨ માં ભારતના રાષ્ટ્રીય રમત દિવસ…
ભારત મા બાજરી નું મહત્વ, બાજરીનો ખાસ અંક
ભારત વિશ્વમાં બાજરીનું સૌથીમોટું ઉત્પાદકછે. બાજરીમાં પૌષ્ટિક તત્વભરપૂર માત્રામાંહોયછે. તેમાં એનર્જી,કેલરી, ભેજ, પ્રોટીન, મિનરલફાઇબર, કાર્બોહાઇડ્રેટ, કેલ્શિયમ, ફોસ્ફરસ અને આયર્ન વગેરે હોય છે. ગરીબોનોખોરાક - ભારતમા…
ઝિમ્બાબ્વેમાં બાજરી પાર્ક સ્થાપવાની ભારતની મોટી દરખાસ્ત
ભારત સરકારે ઝિમ્બાબ્વેની સંસદના અધ્યક્ષને ઝિમ્બાબ્વેમાં ભારતીય બાજરી (મિલેટ્સ) પાર્ક સ્થાપવા માટે પ્રસ્તાવ મૂક્યો છે. પાર્કમાં ભારતના બરછટ અનાજની વાવણી કરી શકાય છે. તેનાથી વિશ્વમાં…
ગુજરાતનો સૌથી અગત્યનો પાક બાજરી
બાજરી એ અત્યંત પરિવર્તનશીલ નાના-બીજવાળા ઘાસનો સમૂહ છે, જે સમગ્ર વિશ્વમાં ધાન્ય પાકો અથવા ચારા અને માનવ ખોરાક માટે અનાજ તરીકે વ્યાપકપણે ઉગાડવામાં આવે છે.…
વર્ષાંત સમીક્ષા - 2022: કૃષિ અને ખેડૂત કલ્યાણ મંત્રાલય
1. બજેટ ફાળવણીમાં અભૂતપૂર્વ વધારો વર્ષ 2022-23માં કૃષિ અને ખેડૂત કલ્યાણ મંત્રાલય માટે બજેટની ફાળવણી વધારીને રૂ. 1,24,000 કરોડ કરવામાં આવી છે.…
કંકોડાની ખેતી: એકવાર વાવો, 10 વર્ષ સુધી નફો મળશે - જાણો, સંપૂર્ણ માહિતી
શાકભાજીની ખેતીથી ખેડૂતોને ઘણો ફાયદો મળી શકે છે. કારણ કે શાકભાજી ઓછા સમયમાં તૈયાર થાય છે અને સારો નફો પણ આપે છે. તેમાં પણ જો…
ગુજરાત સરકારનુ 2030 સુધીમાં 1 ટ્રિલિયન ડોલરનું અર્થતંત્ર બનાવવાનું લક્ષ્ય
ગુજરાતની ભાજપ સરકારે રાજ્યની અર્થવ્યવસ્થાને $1 ટ્રિલિયન સુધી લઈ જવા માટે ઘણા મહત્વપૂર્ણ પગલાં લીધા છે. આ સિવાય સરકારે ઉદ્યોગોને પ્રોત્સાહન આપવા માટે ડબલ ટેક્સેશન…
એક છત નીચે થશે ખેડુતોના પ્રશ્નોનુ નિરાકરણ, જાણો પીએમ કિસાન સમૃદ્ધિ કેન્દ્ર વિશે
કેન્દ્ર અને રાજ્ય સરકારો ખેડુતોને આર્થીક રીતે સધ્ધર બનાવવા માટે સતત પ્રયાસો કરી રહી છે. સરકારો સમય સમય પર ખેડુતો માટે અલગ અલગ યોજનાઓ લાવે…
શીત લહેર અને હિમથી પાક રક્ષણનાં પગલાં
રવિ સિઝનમાં હિમ એ ખેડૂતોની મોટી સમસ્યા છે. આ ઋતુમાં તાપમાનમાં ઘટાડાની સાથે સાથે જ ઠંડી વધે છે અને તાપમાન ઠંડું પોઈન્ટ પર આવે છે…
આ રવિ સિઝનમાં ઘઉંના વિક્રમી વિસ્તાર અને ઉત્પાદનની અપેક્ષા છે
રવિ પાકની વાવણીની ગતિ સતત ચાલુ છે. 23 ડિસેમ્બર સુધીમાં, રવિ પાક હેઠળ વાવેતર 2021-22માં 594.62 લાખ હેક્ટરથી 4.37 ટકા વધીને 2022-23માં 620.62 લાખ હેક્ટર…
મિશ્ર ખેતીની વર્તમાન જરૂરિયાત અને કૃષિ ક્ષેત્રે નવી તકોનું કરે છે સર્જન
સદીઓથી, ભારતીય કૃષિમાં નાની રીતે મિશ્ર ખેતીનો સમાવેશ થતો હતો. ખેતરની તૈયારીથી લઈને વાવણી, લણણી, થ્રેસીંગ સુધી, લગભગ દરેક ખેડૂત પાસે બળદની જોડી, અનાજની હેરફેર…
રવિ પાકની યોગ્ય જાળવણી કરી સારું ઉત્પાદન સાથે મહત્તમ આવક મેળવીએ
ખેતીમાં મેનેજમેન્ટનું પોતાનું મહત્વ છે, વાવણી સાથે વ્યવહાર કર્યા પછી, લણણીના આ લાંબા અંતરાલમાં પાકની જાળવણી કરવી જરૂરી રહેશે. રાજ્યમાં ઘઉંના પાક હેઠળનો વિસ્તાર સૌથી…
કરચલા પાલન કરી ખેડુતો કમાઈ શકે છે અઢળક નફો, જાણો સંપુર્ણ માહિતી
કરચલા બે પ્રકારના હોય છે. એક દરિયામાં જોવા મળે છે અને બીજા મીઠા પાણીમાં જોવા મળે છે.એટલે કે નદીઓ અને તળાવોમાં. આ લેખમાં અમે તમને…
ચીન, જાપાન, હોંગકોંગ, બેંગકોક, દક્ષિણ કોરિયાથી આવતા મુસાફરો માટે આરટી-પીસીઆર ફરજિયાત બનાવીશું: ડો. મનસુખ માંડવિયા
શ્રી માંડવિયાએ ભારતીય વિજ્ઞાન શિક્ષણની સંભાવનાઓ અને સામર્થ્યો પર પ્રકાશ પાડ્યો NIPER-A દ્વારા 24 ડિસેમ્બર, 2022ના રોજ ગાંધીનગર ખાતે નવમા દીક્ષાંત સમારંભનું આયોજન…
અમિત શાહે ગુજરાતનાં મહેસાણામાં શ્રી ગોવર્ધનનાથજી મંદિરમાં દર્શન કર્યાં અને મંદિર પરિસરમાં વિવિધ કાર્યોનો શિલાન્યાસ કર્યો
શ્રી અમિત શાહે ગુજરાતનાં મહેસાણામાં આવેલી શેઠ જી સી હાઈસ્કૂલનાં 95 વર્ષ પૂર્ણ થવાનાં પ્રસંગે આયોજિત એક કાર્યક્રમને પણ સંબોધન કર્યું અને શાળાને શુભેચ્છા પાઠવી…
પ્રધાનમંત્રી ગરીબ કલ્યાણ અન્ન યોજના, જાણો કેવી રીતે લઈ શકાય છે લાભ
પ્રધાનમંત્રી ગરીબ કલ્યાણ અન્ન યોજના (PMGKAY) એ આત્મનિર્ભર ભારતના ભાગ રૂપે સ્થળાંતર કરનારા અને ગરીબ લોકોને મફત અનાજ પૂરું પાડવાની યોજના છે. પ્રધાનમંત્રી ગરીબ કલ્યાણ…
શિયાળામાં દુધાળા પશુઓને ખવડાવો આ ચારો, સ્વાસ્થ્ય માટે પણ છે ફાયદાકારક
અઝોલા પશુ આહાર ઉગાડવા માટે ખેતરોની જરૂર રહેશે નહીં. પ્રાણીના આહાર મુજબ, એઝોલાને દરરોજ પાણીની ટાંકી, ડોલ, ટબ અથવા તળાવમાં ઉગાડી શકાય છે અને પ્રાણીઓને…
ધાણાના બીજ કેવી રીતે વાવવામાં આવે છે? ધાણા રોપવાની નવી પદ્ધતિ
કોથમીર એક એવો પાક છે જેના લીલા પાંદડા શાકભાજી અને સલાડમાં વપરાય છે. અને તેમના સૂકા બીજનો ઉપયોગ ખોરાકમાં મસાલા માટે થાય છે. જો ખેડૂતો…
ઝાટકા મશીન શું છે
આજકાલ ખેડૂત ભાઈઓના પાકને જેટલું નુકસાન થાય છે તેટલું પાકને અસર કરતી જીવાતો અને રોગોને કારણે થતું નથી. રખડતા અને જંગલી જાનવરોને કારણે વધુ નુકસાન…
ટમેટાના તમામ ખતરનાક રોગોથી પાકને કેવી રીતે બચાવવો
ખેડૂત ભાઈઓ, જો તમે શિયાળાની ઋતુમાં ટામેટાની ખેતી કરશો તો તમારે પણ ઘણી બીમારીઓનો સામનો કરવો પડશે. શિયાળાની સરખામણીએ ઉનાળામાં થતી ટામેટાંની ખેતીમાં બહુ ઓછા…
મધમાખીઓમાં જંતુનાશકોનું ઝેર: નિવારણ અને જરૂરી સારવારની યોગ્ય જાણકારી
ડૉ. મુકેશ કુમાર સિંઘ1, ડૉ. રાજીવ કુમાર શ્રીવાસ્તવ2 અને ડૉ. સુદાનંદ પ્રસાદ લાલ3 1સહાયક પ્રોફેસર, કીટવિજ્ઞાન વિભાગ, પોસ્ટ ગ્રેજ્યુએટ કોલેજ, ડૉ. રાજેન્દ્ર પ્રસાદ કેન્દ્રીય કૃષિ…
હવે ઘરેથી જ ઉગાડો આ ત્રણ શાકભાજી, સ્વાદમાં પણ કરશે વધારો
આપણે અહી મોટે ભાગે શાકભાજી ખરીદતી વખતે કોથમીર, ફુદીનો, લીલા મરચાં મફતમાં મંગાવવાનો રિવાજ છે, પરંતુ કેટલીકવાર તે એટલા મોંઘા થઈ જાય છે કે તે…
કેન્દ્રીય કર્મચારીઓ અને પેન્શનરોના DA એરેયર્સનો મુદ્દો સંસદમાં, સરકારે આપ્યુ નિવેદન
કેન્દ્રીય કર્મચારીઓ અને પેન્શનરો તેમના 18 મહિનાના ડીએ એરીયર્સની રાહ જોઈ રહ્યા છે. હવે આ મામલાને સંસદમાં સતત ઉઠાવવામાં આવી રહ્યો છે.…
જો જંતુનાશક દવા વેચવાનો ધંધો હોય તો 31 ડિસેમ્બર સુધીમાં કરો આ કામ, નહીં તો દુકાન બંધ કરવી પડશે.
ઉત્તર પ્રદેશમાં જંતુનાશકોનો મોટો કારોબાર ચાલી રહયો છે. અહી ડીગ્રી કે ડીપ્લોમા વગર જ દવાના વેપારીઓ જંતુનાશકનુ વેચાણ કરી રહ્યા છે. હવે રાજ્ય સરકારે જંતુનાશક…
બાજરીના આ વિવિધ પ્રકારો વિશે જાણો
સામાન્ય રીતે, બાજરી અત્યંત પૌષ્ટિક અને પ્રોટીન, ફાઇબર અને આવશ્યક પોષક તત્વોનો સારો સ્ત્રોત માનવામાં આવે છે. તેઓ મોટાભાગે વિશ્વના એવા ભાગોમાં મુખ્ય ખોરાક તરીકે…
દેશમાં રવિ વિસ્તાર 526 લાખ હેક્ટરને વટાવી ગયો છે
9 ડિસેમ્બર સુધીમાં દેશમાં રવિ પાક હેઠળનો વિસ્તાર 526 લાખ હેક્ટરને વટાવી ગયો છે. જ્યારે ગત વર્ષે સમાન સમયગાળામાં 457.80 લાખ હેક્ટરમાં વાવણી થઈ હતી.…
શું તમને પણ છે માઈગ્રેનની સમસ્યા, તો જાણો ઘરેલુ ઉપાય
માઇગ્રેન દુનિયામાં ત્રીજો સૌથી વધુ થતો રોગ છે. આ બિમારી 18થી 44 વર્ષની વય ધરાવતી વ્યક્તિઓમાં સૌથી વધુ જોવા મળે છે. માઇગ્રેનનાં આશરે 90 ટકા…
ગુજરાતના મુખ્યમંત્રીએ અર્બન 20 લોગો અને સોશિયલ મીડિયા પ્લેટફોર્મ લોન્ચ કર્યું
અમદાવાદ ભારતના મુખ્ય શહેરી કેન્દ્ર તરીકે ઝડપથી ઉભરી આવ્યું છે અને G20ના વિશેષ વર્ટિકલ એવા અર્બન-20ના પ્રમુખ તરીકે શહેર મહત્વની ભૂમિકા ભજવે તે જ યોગ્ય…
મુંબઈના એન્જિનિયરે બનાવ્યું ઈલેક્ટ્રિક સેલ્ફ ડ્રાઈવિંગ ટ્રેક્ટર, ખેડુતોને થશે ફાયદો
મુંબઈ સ્થિત એન્જિનિયર કૌસ્તુભ ધોંડે અને તેમનું ઇલેક્ટ્રિક ટ્રેક્ટર સ્ટાર્ટઅપ AutoNxt ઓટોમેશન આર્ટિફિશિયલ ઈન્ટેલિજન્સ (AI) અને 5G ટેક્નોલોજી દ્વારા સંચાલિત સ્વાયત્ત ટ્રેક્ટર પર કામ કરી…
NBEMS દ્વારા આયોજિત સાયક્લેથોનમાં કેન્દ્રીય આરોગ્ય મંત્રી ડો.મનસુખ માંડવિયાએ ભાગ લીધો
સ્વાસ્થ્ય અને ફિટનેસને પ્રોત્સાહન આપવા માટે સાયકલનો ઉપયોગ પ્રોત્સાહિત કરે છે- તેને "ફેશન"માંથી "પેશન" બનાવવાની જરૂર છે, અને ગરીબ માણસના વાહનમાંથી ધનવાનના વાહનમાં રૂપાંતરિત કરવાની…
રસોડાના કચરામાંથી બનાવો ખાતર, જાણો કેવી રીતે બનાવી શકાય છે ખાતર બનાવો
છોડ માટે જેટલી માટી અને પાણી જરૂરી છે, એટલું જ મહત્વનું ખાતરનું પણ છે. હોમમેઇડ ઓર્ગેનિક ખાતરો સસ્તા અને વધુ અસરકારક છે.…
બહુસ્તરીય ખેતી: ખેડુતો એક કરતા વધુ પાક ઉગાડી કરો લાખો રૂપિયાનો નફો
જો તમે ઓછી જમીનમાં વધુ નફો મેળવવા માંગતા હોવ તો મલ્ટી લેયર ફાર્મિંગ તમારા માટે સારો વિકલ્પ સાબિત થઈ શકે છે.…
ખેડુતોને ખેતી કરવા માટે સરકાર કરી રહી છે મદદ, જાણો ખેડુતોને કયા કયા મળી રહ્યા છે ફાયદા
ભારત દેશ કૃષિ પ્રધાન દેશ છે. દેશની લગભગ 60% વસ્તી ખેતી પર નિર્ભર છે. ઘમીવાર આર્થિક સંકડામણના કારણે ખેડૂતોને મુશ્કેલીનો સામનો કરવો પડે છે. આ…
પંચગવ્યના આરોગ્ય અને ઔષધીય ફાયદા
પંચગવ્ય ગાયમાંથી મેળવેલા દૂધ, પેશાબ, છાણ, ઘી અને દહીંનું પ્રતિનિધિત્વ કરે છે અને આયુર્વેદ અને પરંપરાગત ભારતીય તબીબી પદ્ધતિઓમાં બદલી ન શકાય તેવું ઔષધીય મૂલ્ય…
વિવિધ પાકો માટે ખેડૂતોને ઉપયોગી સલાહ
જો સ્પોટેડ પોડ બોરરનાં નિયંત્રણ માટે પ્રોફેનોફોસ 50 ઇ.સી. (2 ml/l) અથવા Deca 6 P (2 g/l.) પાણીમાં દ્રાવણ બનાવી સ્પ્રે કરો. જૂનથી વાવેલા વટાણાની…
શું તમે પણ તમારા ઓર્ગેનિક ઉત્પાદનો વેચવાને લઈને માર્કેટમાં જવાની ઝંઝટથી થઈ ગયા છો પરેશાન.. તો જોઈ લ્યો આ છે તમારા માટે સારા સમાચાર
ખેડૂતોને આશા હોય છે કે તેમને તેમના વિવિધ ઉત્પાદનો પર સારા ભાવ મળે, પણ ખેડૂતો માટે સૌથી મોટો અને અઘરો પ્રશ્ન તો એને માર્કેટમાં જઈને…
માટી રહિત ઉગાડવાના માધ્યમો: છોડ ઉગાડવા માટે 5 વૈકલ્પિક માધ્યમો
શું તમે ક્યારેય માટી વિના છોડ ઉગાડવા વિશે વિચાર્યું છે? જો કે મોટાભાગના લોકો બાગકામ માટે માટીનો ઉપયોગ કરે છે, તે છોડ ઉગાડવાનું એકમાત્ર માધ્યમ…
વર્મીકમ્પોસ્ટિંગ: સોલિડ વેસ્ટને ઓર્ગેનિક ખાતરમાં રિસાયકલ કરવું
રાસાયણિક ખાતરનો વ્યાપક ઉપયોગ અશ્મિભૂત ઇંધણ, CO2 ઉત્પાદનમાં વધારો અને પાણીના પુરવઠાને દૂષિત કરીને પર્યાવરણીય અધોગતિમાં નોંધપાત્ર રીતે ફાળો આપે છે. વૈશ્વિક કાર્બન સાંદ્રતા અને…
CCPAએ ભારતમાં એસિડના ઓનલાઈન વેચાણ સામે નોટિસ જારી કરી
CCPAએ ઇ-કોમર્સ એન્ટિટીને કોરોસિવ એસિડની સરળ સુલભતા માટે કારણ દર્શાવવા નિર્દેશ કર્યો…
આદુની ખેતીથી કેવી રીતે લાખોની કમાણી થાય છે, જાણો સંપૂર્ણ વિગતો
ખેડૂતો આદુની ખેતી કરીને લાખો રૂપિયાની કમાણી કરી શકે છે. શિયાળામાં બજારમાં આદુની ખૂબ માંગ હોય છે. આદુનો ઉપયોગ ચા અને શાકભાજી બનાવવામાં પણ થાય…
NDDB એ યુએસ કંપની સાથે કર્યા MOU, ડેરી ઉદ્યોગને થશે ફાયદો
NDDB એ અમેરિકન કંપની સાથે એમઓયુ પર હસ્તાક્ષર કર્યા છે, જેના હેઠળ ભારતને એવી ટેક્નોલોજી મળશે, જે માત્ર દૂધ ઉત્પાદનમાં જ વધારો નહીં કરે, પરંતુ…
ઘરેથી ઉગાડો સ્ટ્રોબેરીનો છોડ અને મેળવો અઢળક ઉત્પાદન, જાણો સંપુર્ણ માહિતી
સ્ટ્રોબેરી શીત કટિબંધનો પાક છે જયાં ઉનાળામાં સ્ટ્રોબેરી મોટા પાયે ઉગાડવામાં આવે છે ત્યાં ઉનાળો પણ ઘણો ઠંડો હોય છે. તેથી જમીનને ઠંડી પડતી રોકવા…
આંતરરાષ્ટ્રીય સ્તરે રેકોર્ડ ઊંચા ભાવ હોવા છતાં પેટ્રોલ અને ડીઝલના ભાવમાં વધારો કરવામાં આવ્યો નથી: શ્રી હરદીપ એસ.પુરી
આંતરરાષ્ટ્રીય સ્તરે રેકોર્ડ ઊંચા ભાવ હોવા છતાં 6ઠ્ઠી એપ્રિલ 2022થી પબ્લિક સેક્ટર ઓએમસી દ્વારા પેટ્રોલ અને ડીઝલના ભાવમાં વધારો કરવામાં આવ્યો નથી,: શ્રી હરદીપ એસ.…
આત્મા યોજના: મહિલાઓ માટે વરદાનરૂપ છે આ યોજના, જાણો સંપુર્ણ માહિતી
એગ્રીકલ્ચરલ ટેકનોલોજી મેનેજમેન્ટ એજન્સી(આત્મા) એ જીલ્લા કક્ષાએ કાર્યરત રજીસ્ટર્ડ સોસાયટી છે જે જીલ્લાના ટકાઉ કૃષિવિકાસ માટે જીલ્લાની તમામ કૃષિ સંલગ્ન સંસ્થાઓની સાથે રહીને ખુડૂતોના સર્વાંગી…
વર્ટિકલ ફાર્મિંગ: વધુ ઉપજ માટે ટામેટાં ઊભી રીતે ઉગાડો
ટામેટા ઊભી ખેતી એ ટામેટાં ઉગાડવાની એક ક્રાંતિકારી પદ્ધતિ છે જે પરંપરાગત આડી ખેતીની તકનીકોને બદલે ઊભી જગ્યાનો ઉપયોગ કરે છે. આ પદ્ધતિ ઉચ્ચ ઉપજ…
લેન્ડસ્કેપિંગ ગાર્ડનિંગ માં વિવિધ પામો નું મહત્વ
પામ સૌથી જાણીતા અને સૌથી વધુ વ્યાપક રીતે ઉગાડવામાં આવતા છોડ પરિવારોમાંનો એક છે. તેઓ સમગ્ર ઇતિહાસમાં મનુષ્યો માટે મહત્વપૂર્ણ રહ્યા છે. ઘણા સામાન્ય ઉત્પાદનો…
કૃષિ ક્ષેત્ર ઉપર આબોહવા પરિવર્તનની અસર
સમયાંતરે કોઈ ચોક્કસ પ્રદેશના પરંપરાગત વાતાવરણમાં થતા ફેરફારને આબોહવા પરિવર્તન કહેવામાં આવે છે. આબોહવા પરિવર્તનની અસરો મર્યાદિત વિસ્તારમાં અનુભવી શકાય છે અને સમગ્ર વિશ્વમાં અનુભવી…
બકરી ઉછેરની સમસ્યાઓ અને અવરોધો
ગ્રામીણ ભારતના લાખો ગરીબ ખેડૂતો અને ભૂમિહીન મજૂરોને પૂરક આવક અને આજીવિકા પૂરી પાડવામાં બકરી મહત્વપૂર્ણ ભૂમિકા ભજવે છે. દુકાળ અને દુષ્કાળ જેવી તકલીફોની પરિસ્થિતિઓમાં…
ખાલી પ્લોટ્સ પર વૃક્ષારોપણ
પર્યાવરણ, વન અને આબોહવા પરિવર્તન મંત્રાલયના રાજ્ય મંત્રી શ્રી અશ્વિની કુમાર ચૌબેએ લોકસભામાં ડૉ. (પ્રો.) કિરીટ પ્રેમજીભાઈ સોલંકીના અતારાંકિત પ્રશ્ન નંબર 912નો જવાબ આપ્યો…
ઊર્જા મંત્રાલય "ઊર્જા સંરક્ષણ દિવસ 2022" ઉજવશે
રાષ્ટ્રપતિ રાષ્ટ્રીય ઉર્જા સંરક્ષણ પુરસ્કારો, રાષ્ટ્રીય ઉર્જા કાર્યક્ષમતા ઇનોવેશન પુરસ્કારો, રાષ્ટ્રીય પેઇન્ટિંગ સ્પર્ધા પુરસ્કારોના વિજેતાઓને સન્માનિત કરશે…
કારેલાની ખેતી કેવી રીતે કરવી - જાણો કારેલાની ખેતી કરવાની સાચી રીત
ખેડૂતોની આવક વધારવા માટે સરકાર તેમને રવિ અને ખરીફના મુખ્ય પાકો ઉપરાંત શાકભાજી અને ફળોની ખેતી પર ભાર આપી રહી છે. આ માટે સરકાર દ્વારા…
ઓર્ગેનિક ખેતીનું એક પોર્ટલ, જેમા જૈવિક ખેતી વિશેની તમામ માહિતી ઉપલબ્ધ
કેન્દ્ર સરકારના ઓર્ગેનિક ફાર્મિંગ પોર્ટલ પર ખેડૂતોને માત્ર ઓર્ગેનિક ખેતી સાથે જોડાવાનો મોકો જ નથી મળતો, પરંતુ તેમને ઉત્પાદનની યોગ્ય કિંમત અને યોગ્ય સમયે ઓનલાઈન…
ગ્રેજ્યુએશનના તમામ પુસ્તકો આ ભાષાઓમાં થશે ઉપલબ્ધ
આપણા દેશમાં અલગ અલગ રાજ્યોમાં અલગ અલગ ભાષાઓ બોલાતી હોય છે અને ઉચ્ચ અભ્યાસમાં પણ અમુક જ ભાષાઓનો સમાવેશ કરવામાં આવે છે. પરંતુ હવે ચિંતા…
આજે વારાણસી ખાતે યુનિવર્સલ હેલ્થ કવરેજ (UHC) દિવસ 2022ની ઉજવણી
યુપીના માનનીય રાજ્યપાલ શ્રીમતી આનંદીબેન પટેલ બે દિવસીય સ્વાસ્થ્ય મંત્રીઓના કોન્ક્લેવનું ઉદ્ઘાટન કરશે જેની થીમ "આપણે જોઈએ છીએ તે વિશ્વનું નિર્માણ કરો: બધા માટે તંદુરસ્ત…
કુદરતી ઔષધિઓના ઉપયોગ થકી પશુ રોગની સારવાર
ભારતએ ઋષિ અને કૃષિનો દેશ છે. ગ્રામીણ ભારત પાસે પ્રાચીન ઔષધિઓનો અખૂટ ભંડાર પડેલો છે. પરંતુ યોગ્ય પધ્ધતિ અને માહિતી વિના તેનો યથાયોગ્ય ઉપયોગ થઇ…
આ ફૂડ્સનુ કરો સેવન, કબજિયાતની સમસ્યા માટે છે રામબાણ ઈલાજ
શિયાળાની ઋતુમાં કબજિયાતની સમસ્યા સામાન્ય સમસ્યા છે. દરરોજ દર 4માંથી બે લોકોને આનો ભોગ બનવું પડે છે. વાસ્તવમાં, પાચનની સમસ્યા ઘણા કારણોસર હોઈ શકે છે.…
જાણો ગુજરાત સરકારમાં કોને કોને મળી શકે છે કેબિનેટમાં સ્થાન
ગુજરાત વિધાનસભાની ચૂંટણીના પરિણામો ગુરુવારે (8 ડિસેમ્બર) ના રોજ જાહેર કરવામાં આવ્યા હતા. જેમાં ભાજપે 182માંથી 156 સીટો મેળવી પુર્ણ બહુમત મેળવી જીત હાંસલ કરી…
ભારત બનશે વિશ્વમાં બાજરીનુ મોટુ બજાર
બાજરીના ઉત્પાદનમાં ભારત વિશ્વમાં નંબર વન છે. વિશ્વમાં તેનો 40 ટકા હિસ્સો છે. ભારત ઘણા દેશોમાં બાજરીની નિકાસ કરે છે. બાજરી પોષક તત્વોથી ભરપૂર હોય…
ઘઉંના બમ્પર પાક માટે કૃષિ વૈજ્ઞાનિકોની ભલામણો
ઘઉંના બમ્પર પાક માટે કૃષિ વૈજ્ઞાનિકોની ભલામણો - બીજનો દર અને વાવણીની પદ્ધતિ - બીજનો દર અનાજના કદ, અંકુરણની ટકાવારી, વાવણીનો સમય, વાવણીની પદ્ધતિ અને…
કોબીની મુખ્ય જીવાતો અને તેનું અસરકારક નિવારણ
કોબી સિઝનમાં હોય છે, તે એક લોકપ્રિય શાકભાજી છે. આપણા બધા ખેડૂત ભાઈઓ અને બહેનોએ કોબીની ખેતીની તૈયારીમાં સતત વ્યસ્ત રહે છે, કારણ કે આપણે…
કૃષિ ઉડાન યોજના 2.0 હેઠળ ગુજરાતના 3 સહિત 58 એરપોર્ટ આવરી લેવાયા
આ યોજનાનો ઉદ્દેશ્ય ખાસ કરીને દેશના ઉત્તર-પૂર્વ, ડુંગરાળ અને આદિવાસી વિસ્તારોમાંથી ઉદ્ભવતી તમામ કૃષિ પેદાશો માટે સીમલેસ, કોસ્ટ-ઈફેક્ટિવ, સમયસર, હવાઈ પરિવહન અને સંલગ્ન લોજિસ્ટિક્સ સુનિશ્ચિત…
National Mission on Edible Oils: તેલીબિયાંના પાકની કરો ખેતી, થશે બમ્પર ઉત્પાદન, સરકાર આપી રહી છે સબસિડી
દેશમાં ખાદ્યતેલનું ઉત્પાદન વધારવા માટે પામની ખેતીને પણ ઘણું પ્રોત્સાહન મળી રહ્યું છે. આ પાક ઉગાડીને તમે દર મહિને 30,000 સુધીની કમાણી કરી શકો છો…
કેળાં ના પાકમાં કરવામાં આવતી જરૂરી કૃષિ પદ્ધતિઑ
કેળાં નો પાક ઉષ્ણકટિબંધ વિસ્તાર માં ૧૩૦ દેશ માં સૌથી વધુ ઉગાડવામાં આવતો પાક છે. કેળાં માં વિવિધ પ્રજાતિઑ છે જેમાં ઓસ્ટ્રેલિમુસા અને યુમુસા શ્રેણી…
ખેડુત મહિલાઓ આ કૃષિ યંત્રોનો કરો ઉપયોગ અને બનાવો તમારી ખેતીને સરળ
મહિલાઓ ખેતરની સાથે ઘરની પણ સંભાળ રાખે છે. આ 3 કૃષિ મશીનો આ બધી જવાબદારીઓનો બોજ હળવો કરવામાં અને ખેતીને સરળ બનાવવામાં મદદરૂપ સાબિત થશે.…
ખેડુતો માટે સારા સમાચાર, ખેડૂતોની આવકમાં થશે વધારો, જાણો આરબીઆઈની નવી નીતિમાં શું છે ખાસ
આરબીઆઈના ગવર્નર શક્તિકાંત દાસે ભારતના કૃષિ ક્ષેત્રને સ્થિતિસ્થાપક (લચીલુ) ગણાવ્યું છે. ખરીફ સિઝનમાં થયેલા નુકસાન પછી તાજા રવી પાકની વાવણીને સારી શરૂઆત માનવામાં આવી રહી…
ઘરે બનાવો શાહી લૌકીનુ શાક, સ્વાદમાં પણ છે ભરપુર, જાણો બનાવવાની સંપુર્ણ માહિતી
શાહી લૌકીનું શાક પૌષ્ટિક હોવાની સાથે સાથે સ્વાદથી પણ ભરપૂર છે. શાહી લૌકી લંચ અથવા ડિનર માટે તૈયાર કરી શકાય છે. ઘણા લોકોને સાદી લૌકી…
મીની રાઈસ મિલ મશીન ખરીદી શરૂ કરો પોતાનો વ્યવસાય, સરકાર આપી રહી છે સબસિડી
કેન્દ્ર અને રાજ્ય સરકારો ખેડુતોના આર્થિક વિકાસ માટે અનાર નવાર નવી નવી યોજનાઓ બહાર પાડતી રહે છે, આવી જ એક યોજના છે મીની રાઈસ મિલ…
સોઈલ હેલ્થ કાર્ડની મદદથી ખેતી કરવી બનશે સરળ, જાણો સંપુર્ણ માહિતી
તમે જાણો જ છો કે ખેતી સંપૂર્ણપણે જમીન પર આધારિત હોય છે. દરેક પાકની ખેતી અલગ-અલગ જમીનમાં કરવામાં આવે છે અને જમીનની પોતાની વિશેષતા હોય…
ઇટાલીના રોમમાં એફએઓ મુખ્યાલયમાં આંતરરાષ્ટ્રીય બાજરી વર્ષના ઉદ્ઘાટન સમારોહ દરમિયાન પ્રધાનમંત્રીનો સંદેશ
આંતરરાષ્ટ્રીય બાજરી વર્ષ 2023 શરૂ કરવા બદલ સંયુક્ત રાષ્ટ્ર અને ખાદ્ય અને કૃષિ સંગઠનને અભિનંદન પાઠવ્યા "સદીમાં એક વખત આવતી મહામારી અને ત્યારબાદ સંઘર્ષની પરિસ્થિતિએ…
સંસદના શિયાળુ સત્રની શરૂઆત પહેલા પ્રધાનમંત્રીની ટિપ્પણીનો મૂળપાઠ
આજે શિયાળુ સત્રનો પ્રથમ દિવસ છે. આ સત્ર મહત્વપૂર્ણ છે કારણ કે આપણે 15મી ઓગસ્ટ પહેલા મળ્યા હતા. 15 ઓગસ્ટે આઝાદીના 75 વર્ષ પૂર્ણ થયા…
શિયાળા ઋતુમાં દુધાળા પશુઓની માવજત
ડેરી ફાર્મિંગ એ ભારતના મોટા ભાગના ગ્રામીણ લોકોને આજીવિકા અને પોષણ પ્રદાન કરવાના સૌથી મહત્વપૂર્ણ માધ્યમોમાંનું એક છે. ડેરીમાંથી નફો મેળવવા માટે કાર્યક્ષમ સંચાલન અત્યંત…
ભારતે બાજરીની વૈશ્વિક મૂડી બનવા માટે પ્રયત્ન કરવો જોઈએઃ શ્રી પીયૂષ ગોયલ
મંત્રીએ કુપોષણ અને ખાદ્ય સુરક્ષા સામેના પડકારોનો સામનો કરવા માટે બાજરીને પ્રોત્સાહન આપવાના વડાપ્રધાન શ્રી નરેન્દ્ર મોદીના પ્રયાસની પ્રશંસા કરી…
સરસવના તેલનુ કરો સેવન અને વધારો તમારી રોગપ્રતિકારક શક્તિ, જાણો તેના ફાયદા
સરસવના તેલ વિશે તો તમે બધા જાણતા જ હશો. ભાગ્યે જ કોઇ ઘરમા સરસવના તેલ નો ઉપયોગ નહિ થતો હોઇ. હવે તો સરસવના તેલનો ઉપયોગ…
કરી પત્તા કરી શકે છે તમારા વાળની મોટી સમસ્યાઓને દૂર, અહીં જાણો તેના ફાયદા અને ઉપયોગની રીત
કરી પત્તા: તમે અવારનવાર ભોજનમાં કરી પત્તા નાખ્યા હશે, હવે તેને તમારા વાળમાં પણ લગાવવાનો પ્રયાસ કરો. તેના ફાયદાઓ તમને પણ આશ્ચર્યચકિત કરી દેશે.…
શિયાળુ ખેત પેદાશનુ મહત્વ
હેલો મિત્રો, આપ સૌને ખબર જ છે ભારત એક ખેતી પ્રધાન દેશ છે અને આપણા દેશ ના બધા રાજ્યો માં અલગ અલગ ખેત પેદાશ થાય…
સફેદ ચંદનની ખેતી કેવી રીતે કરવી: સફેદ ચંદનની ખેતી કરીને ખેડૂતો સમૃદ્ધ બનશે
જો ખેડૂત પોતાની આવક વધારવા માટે પરંપરાગત પાકોની સાથે અન્ય ફાયદાકારક વૃક્ષોનું વાવેતર કરે તો તે લાખો રૂપિયાની કમાણી કરી શકે છે. ઘણા છોડનું લાકડું…
સરસવની ખેતીમાં આ બાબતોનું ધ્યાન રાખો, નુકસાન નહીં થાય
હાલ રવિ પાકની સિઝન ચાલી રહી છે. ખેડૂતો તેમના ખેતરોમાં રવિ પાકની વાવણીમાં વ્યસ્ત છે. ઘણા ખેડૂતો ઘઉં અને સરસવની વાવણી કરી રહ્યા છે. જ્યારે…
Lemon Pickle Recipe: લીંબુનું અથાણું હોય છે આરોગ્યથી ભરપૂર, અહીં જાણો બનાવવાની રીત
તમે બધા જાણો જ છો કે આપણા દેશમાં જાત જાતના અથાણા ખવાતા હોય છે. આજે આપણે વાત કરી રહ્યા છે લીંબુના અથાણાની, એક સમય હતો…
Subsidy Scheme: આ પાકની કરો આધુનિક ખેતી, સરકાર આપી રહી છે સબસિડી
દેશમાં પાનના ઘણા ચાહકો મળી જશે. દેશમાં તેમજ વિદેશમાં પણ પાનની ઘણી વપરાશ થાય છે, તેથી રાજ્ય સરકારે પાનની આધુનિક ખેતી માટે 35% સબસિડી એટલે…
ડિસેમ્બર મહિનામાં કરો આ શાકભાજીની ખેતી, મળશે બમ્પર ઉપજ
શાકભાજીની ખેતી માટે ડિસેમ્બર મહિનો સૌથી વધુ અનુકૂળ છે. મૂળા, પાલક, ટામેટા, રીંગણ, કોબીજ જમીનની ભેજ અને ઠંડા વાતાવરણ વચ્ચે સારું ઉત્પાદન મેળવી શકે છે.…
આ 5 આધુનિક કૃષિ સાધનોનો ઉપયોગ કરી બનાવો તમારી ખેતીને સરળ
આ એજ કૃષિ મશીનો છે, જે થોડા જ કલાકોમાં કેટલાય દિવસોનું કામ પૂરું કરી દે છે. સરકાર આ સાધનોની ખરીદી પર સબસિડી પણ આપી રહી…
Hop Shoots Vegetable: આ શાકની કિંમત જાણી લાગશે તમને નવાઈ, જાણો કેમ છે ખાસ
તમને સાંભળીને નવાઈ લાગશે કે આ શાકભાજીની કિંમત એક કિલોના લગભગ 85 હજાર રૂપિયા છે. ધ ગાર્ડિયનના એક અહેવાલ મુજબ, હોપ શૂટના છોડમાંથી મેળવેલી શાકભાજી…
દ્રાક્ષની ખેતી કેવી રીતે કરવી: દ્રાક્ષની જાતો અને ખેતીની સાચી પદ્ધતિ
બાગાયતી પાકોમાં દ્રાક્ષની ખેતી પણ આગવું સ્થાન ધરાવે છે. ભારતમાં, તે મુખ્યત્વે પંજાબ, હરિયાણા, રાજસ્થાન, દિલ્હી અને પશ્ચિમ ઉત્તર પ્રદેશમાં ઉગાડવામાં આવે છે. અહીં ખેડૂતો…
ભારતના રાષ્ટ્રપતિએ આંતરરાષ્ટ્રીય ગીતા સેમિનારમાં હાજરી આપી
આરોગ્ય, માર્ગ પરિવહન અને શિક્ષણ સંબંધિત હરિયાણા સરકારના વિવિધ પ્રોજેક્ટ્સનું ઉદ્ઘાટન/શિલારોપણ કર્યું…
બ્રોકોલીની ખેતી- નર્સરીમાં રોપાઓ તૈયાર કરવાની રીત, સમય અને પદ્ધતિ શીખો
શાકભાજીમાં બ્રોકોલીની ખેતી ખેડૂતો માટે ખૂબ જ ફાયદાકારક સાબિત થઈ રહી છે. અનેક પ્રકારના પોષક તત્વો સાથેના આ શાકભાજીની બજારમાં ઘણી માંગ છે. તે મોટા…
ચણાની ખેતી કરતી વખતે ધ્યાનમાં રાખવાની ખાસ વાત
ચણાની ખેતીમાં કેટલીક બાબતોનું ધ્યાન રાખવામાં આવે તો સારું ઉત્પાદન મેળવી શકાય છે. અમે નીચે જણાવી રહ્યા છીએ ચણાની ખેતીમાં જે ખાસ બાબતોનું ધ્યાન રાખવું…
ચણાની અગ્રણી જાતો: ફાયદા અને વિશેષતા વિશે જાણો
રવિ પાકની વાવણીની સિઝન ચાલી રહી છે. આવી સ્થિતિમાં ખેડૂતોને સારી ગુણવત્તાના બિયારણની જરૂર છે જેથી કરીને તેઓ સારી ઉપજ મેળવી શકે. રવિ પાકની ઘણી…
શિયાળામાં કરો આ શાકભાજીનુ સેવન, રોગપ્રતિકારક શક્તિમાં થશે વધારો
દેશમાં શિયાળાની શરુઆત થઈ ચુકી છે. તેવામાં સીઝનલ ફ્લૂ, વાયરલ ઈન્ફેક્શનની પણ શરુઆત થઈ ચુકી છે. આવી સ્થિતિમાં જો શરીરની રોગપ્રતિકારક શક્તિ મજબૂત હોય તો…
ટીવી ચેનલો પર દરરોજ 30 મિનિટ માટે થશે રાષ્ટ્રહિત કન્ટેન્ટનુ પ્રસારણ, 1 જાન્યુઆરીથી લાગુ થશે નિયમો
આવતા વર્ષથી, ભારતીય ટેલિવિઝન ચેનલો માટે દરરોજ 30 મિનિટ માટે 'દેશહિત'ના કન્ટેન્ટ પ્રસારિત કરવા જરૂરી બનશે. એવી સંભાવના છે કે 1 જાન્યુઆરી, 2023 થી, સેટેલાઇટ…
Ration Card Update:રેશન કાર્ડ કેટલા પ્રકારના હોય છે? જાણો સંપુર્ણ માહિતી
રેશન કાર્ડ દ્વારા કેન્દ્ર અને રાજ્ય સરકારો દ્વારા ગરીબોને તેમની રોજિંદી આવશ્યક ચીજવસ્તુઓ સબસિડીવાળા દરે ખરીદવામાં મદદ પૂરી પાડવામાં આવે છે. આનાથી તમને વિવિધ સરકારી…
રવિ પાકની વાવણી કરતા પહેલા જાણી લો આ મહત્વની બાબતો, મળશે બમ્પર ઉપજ
આજે અમે અમારા ખેડૂત ભાઈઓને રવિ પાકની ઉપજ વધારવા માટે વાવણીની પદ્ધતિ, માટી અને ખાતર વ્યવસ્થાપન તકનીકો વિશે માહિતગાર કરીશું, જે તમારા પાક પાછળના ખર્ચમાં…
ગુણોથી ભરપુર છે આ વિદેશી શાકભાજી, સેવનથી થશે શરીરને અઢળક ફાયદા
બ્રોકોલી એક વિદેશી શાકભાજી છે, જે હમણાં જ ભારતમાં આવી છે. વિશ્વના ઘણા દેશોમાં બ્રોકલીની ખુબ માંગ છે. સમગ્ર વિશ્વમાં છવાયેલી આ શાકભાજી સ્વાદ અને…
એનર્જી બૂસ્ટર શિંગાડાના સેવનથી થશે અનેક ફાયદા, ચાલો જાણીએ તેનાથી સંબંધિત રસપ્રદ વાતો
શિંગાડા એક ઓલરાઉન્ડર ફળ ભારતમાં હવે શિયાળાનુ આગમન થઈ ગયુ છે. આ દરમિયાન શાકમાર્કેટ અને બજારોમાં શિંગાડા દેખાવા લાગ્યા છે. ઘેરા લીલા અને ન રંગેલું…
કેન્દ્રીય કૃષિ રાજ્ય મંત્રી કૈલાશ ચૌધરીએ રાષ્ટ્રીય અધ્યક્ષ જેપી નડ્ડા સાથે ગુજરાતમાં કર્યો હતો ચૂંટણી જનસંપર્ક
કેન્દ્રીય કૃષિ રાજ્ય મંત્રી કૈલાશ ચૌધરીએ ગુજરાતમાં ચૂંટણી રોકાણ દરમિયાન સાબરકાંઠા જિલ્લાની વિધાનસભા મતવિસ્તારમાં ભાજપના ઉમેદવારોના સમર્થનમાં જનસંપર્ક કર્યો…
અમૂલે દૂધના ભાવમાં આપી મોટી રાહત, દિલ્હીથી ગુજરાત સુધીના સામાન્ય લોકોને થશે ફાયદો
દૂધના વધતા જતા ભાવથી દરેક વ્યક્તિ ચિંતિત છે. આ વર્ષે દિલ્હીમાં દૂધના ભાવમાં 3 થી 4 વખત વધારો કરવામાં આવ્યો છે. આ દરમિયાન અમૂલની એક…
Solar rooftop scheme 2022: ઘર-ઘર સુધી વીજળી પહોંચાડવાની સરકારની મોટી પહેલ, આ યોજના દ્વારા 25 વર્ષ સુધી મફતમાં મેળવો લાભ
કેન્દ્ર અને રાજ્ય સરકારો સમય સમય પર ખેડુતો માટે નવી નવી યોજનાઓ લાવતી રહે છે જેથી ખેડુતોને આર્થીક રીતે મજબુત બનાવી શકાય. સરકાર જનતાના હિતમાં…
પ્રધાનમંત્રીએ બંધારણ દિવસની ઉજવણી નિમિત્તે ભારતની સર્વોચ્ચ અદાલતમાં યોજાયેલા કાર્યક્રમમાં સંબંધોન આપ્યું
ઇ-કોર્ટ પ્રોજેક્ટ હેઠળ વિવિધ નવી પહેલો શરૂ કરી 26/11 આતંકવાદી હુમલાનો ભોગ બનનારાઓને શ્રદ્ધાંજલિ અર્પણ કરી “ભારત તાકાત સાથે આગળ વધી રહ્યું છે અને તેની…
રવિ પાકની સારી ઉપજ માટે - ખાતર કેવી રીતે આપવું તે જાણો
દેશમાં ખરીફ પાકની લણણી લગભગ પૂર્ણ થઈ ગઈ છે. ખેડૂતોએ હવે રવિ સિઝનના પાકની વાવણી પણ શરૂ કરી દીધી છે અને ઘણા વિસ્તારોમાં રવિ પાકની…
ગાંઠ દાર (લમ્પી) ત્વચા રોગની પશુઓના સ્વાસ્થ પર થતી આડઅસરો અને તેનું નિવારણ
ભારત લમ્પી સ્કિન રોગના પ્રકોપનો સામનો કરી રહ્યું છે, જેણે 1 લાખથી વધુ પશુઓના જીવ લીધા છે. લમ્પી સ્કિન અથવા ગઠ્ઠો ચામડીનો રોગ, અથવા એલએસડી,…
Goat farming : બકરીની આ જાતિઓ આપશે સારો નફો, આ જાતિઓને મળી રાષ્ટ્રીય સ્તરે ઓળખ
ખેડુતો ખેતીવાડીની સાથે સાથે પશુપાલનલા વ્યવસાય તરફ પણ આગળ વધી રહ્યા છે. ગ્રામીણ વિસ્તારોમાં લોકો બકરી ઉછેર કરીને સારી કમાણી કરી રહ્યા છે. બકરી પાલનનો…
કેન્દ્રીય કર્મચારીઓના પગારમાં થશે 49420 રૂ. નો વધારો, સરકાર લેશે આ નિર્ણય
નવું વર્ષ શરૂ થવામાં લગભગ એક મહિનો બાકી છે. વર્ષ 2023ની શરૂઆત સાથે જ કેન્દ્રીય કર્મચારીઓ માટે સારા સમાચાર મળી રહ્યા છે. લાખો કર્મચારીઓની વર્ષો…
આર્ટિફિશિયલ ઇન્ટેલિજન્સ (AI) શું છે?
આર્ટિફિશિયલ ઇન્ટેલિજન્સનો અર્થ છે - કૃત્રિમ (કૃત્રિમ) રીતે વિકસિત બૌદ્ધિક ક્ષમતા.…
ટાટા હવે વેચશે બિસલેરી વોટર, ટૂંક સમયમાં ખરીદશે આ વિશાળ કંપની
બિસલેરીની વેબસાઈટ અનુસાર, કંપની બોટલ્ડ વોટર બિઝનેસમાં 60 ટકા હિસ્સો ધરાવે છે. હાલમાં, બિસલેરી પાસે 122 થી વધુ ઓપરેશનલ પ્લાન્ટ છે. ટાટા ગ્રુપ ટૂંક સમયમાં…
સરકાર આપી રહી છે ડ્રોન પર 50 ટકા સબસિડી, ડ્રોનના ઉપયોગથી ખેતી કરવી બનશે સરળ
ખેડુત તેની ખેતીમાં અવનવી તક્નીકોનો ઉપયોગ કરી પોતાની ખેતીને સફળ બનાવવાના પ્રયાસ કરી રહ્યો છે. સરકારનો ઉદ્દેશ્ય એ છે કે વિકસિત દેશોની જેમ ભારતમાં પણ…
આ 2 શાકભાજીનુ સેવન કરી તમે ઘટાડી શકો છો તમારુ વજન, નહી જવુ પડે જીમ
વધુ વજન વ્યક્તિના રોજિંદા જીવનને અસર કરતુ હોય છે. વજન ઘટાડવા માટે લોકો ઘણા પ્રયત્નો કરતા હોય છે, પરંતુ કોઈના માટે પણ વજન ઘટાડવુ એ…
"ઈસી (EC) ભરતી પ્રક્રિયા 24 કલાકમાં પૂર્ણ કરવાના સરકારના જવાબથી SC અસંતુષ્ટ
મુખ્ય ચૂંટણી કમિશનર અને ચૂંટણી કમિશનરોની નિમણૂકનો મુદ્દો સમગ્ર દેશમાં હાલ ચર્ચાનો વિષય બની ગયો છે. હાલ તે બાબતે સુપ્રીમ કોર્ટમાં ચર્ચા ચાલી રહી છે.…
અમેરિકામાં ભણતા ભારતીય વિદ્યાર્થીઓને કેવી થશે મંદીની અસર?
અમેરિકાની અર્થવ્યવસ્થામાં મંદીના સંકેતો દેખાવા લાગ્યા છે. આવી સ્થિતિમાં વિદેશમાં અભ્યાસ કરતા વિદ્યાર્થીઓ સામે અનિશ્ચિતતાનું વાતાવરણ છે.…
નવેમ્બર મહિનામાં આ પાકની ખેતી કરો, બમ્પર ઉપજ મળશે
દેશમાં મુખ્ય ખરીફ પાક ડાંગરની કાપણી તેના અંતિમ તબક્કામાં છે. ખરીફ પાકની કાપણી પૂર્ણ થયા બાદ ખેડૂતોએ રવિ પાકની વાવણીની તૈયારીઓ શરૂ કરી દીધી છે.…
બિઝનેસ આઈડિયા: ફ્રોઝન વટાણાનો બિઝનેસ 10 ગણો વધુ નફો આપશે
આજે મોટાભાગના લોકો પોતાનો વ્યવસાય શરૂ કરવા માંગે છે. પરંતુ યોગ્ય બિઝનેસ આઈડિયા ન હોવાને કારણે તેઓ તેને શરૂ કરવામાં ડરે છે. આજે ભારત આત્મનિર્ભરતા…
શિયાળામાં આમળાના મુરબ્બાનુ કરો સેવન, રોગપ્રતિકારક શક્તિમાં થશે વધારો, જાણો બનાવવાની રીત
આમળા સ્વાસ્થ્ય માટે ખૂબ જ ફાયદાકારક છે. આ જ કારણ છે કે લોકોને શિયાળાની ઋતુમાં આમળાનો મુરબ્બો ખૂબ જ પસંદ આવે છે. ગુણોથી ભરપૂર આમળાનો…
મતદાર જાગૃતિ મલ્ટીમીડિયા પ્રદર્શનનું આત્મીય યુનિવર્સિટી ખાતે થયું ઉદ્ઘાટન
ભારત સરકારના માહિતી અને પ્રસારણ મંત્રાલયના કેન્દ્રીય સંચાર બ્યુરો દ્વારા લોકશાહીનો અવસર ગુજરાત વિધાનસભા ચૂંટણી 2022ના ઉપક્રમે મતદાર જાગૃતિ અભિયાનનું વિભિન્ન કાર્યક્રમ દ્વારા આયોજન કરવામાં…
હવે મિનિટોમાં ચાર્જ થશે તમારું ગેજેટ, IIT ગાંધીનગરના સંશોધકોએ નવી એનોડ સામગ્રી શોધી
શું તમારો મોબાઈલ, લેપટોપ અને કારની બેટરી જેને ચાર્જ થવામાં કલાકો લાગી જાય છે, તે મિનિટોમાં થઈ જાય તો? તમે કહેશો કે આ તો ચમત્કાર…
Fertilizer in India: રવિ સિઝનના વાવેતર માટે ખેડૂતોને ખાતરની નહી પડે ખોટ, ખેતી માટે મોટા પ્રમાણમાં ખાતરનો સ્ટોક
સમગ્ર દેશમાં રવિ પાકની વાવણી લગભગ પૂર્ણ થઈ ગઈ છે. આ પછી હવે ખેડૂત ભાઈઓ પાકમાંથી સારું ઉત્પાદન મેળવવા માટે પાકમાં પોષણ વ્યવસ્થાપનની કામગીરીમાં વ્યસ્ત…
દમણ ખાતે વિશ્વ માછીમારી દિવસની ઉજવણી કરવામાં આવી
સાગર પરિક્રમા ગીતના ગુજરાતી સંસ્કરણનું લોન્ચિંગ એ સોમવારે વિશ્વ માછીમારી દિવસ નિમિત્તે દમણમાં એક રંગારંગ સમારંભમાં ઉજવણીની વિશેષતા હતી. નેશનલ ફિશરીઝ ડેવલપમેન્ટ બોર્ડ સાથે ભારત…
મૂળાની ખેતી કેવી રીતે કરવી: મૂળાની આ અદ્યતન જાતો ઘણો નફો આપશે
મૂળાનો પાક ઓછા સમયમાં સૌથી વધુ નફાકારક પાક છે. જો કે તે ઠંડા વાતાવરણનો પાક ગણાય છે, પરંતુ તેની ખેતી મુખ્યત્વે રવિ સિઝનમાં થાય છે.…
ખેડૂતોએ આ 5 વૃક્ષો ખેતરમાં વાવો, લાખોની કમાણી થશે,જાણો તેમની વિશેષતા અને ફાયદા
ખેડૂતોની આવક વધારવા માટે સરકાર અનેક યોજનાઓ લાવી રહી છે. આ યોજનાઓનો લાભ ખેડૂતોને મળી રહ્યો છે. સરકારી પ્રયાસોની સાથે ખેડૂતોએ પણ પોતાની આવક વધારવા…
ચણાની ખેતી અને ઉચ્ચ ઉપજ આપતી મુખ્ય જાતો વિશેની સંપૂર્ણ માહિતી જાણો
ચણાની ખેતી અને વધુ ઉત્પાદન આપતી જાતો વિશે સંપૂર્ણ માહિતી જાણો. ચણાને સૌથી મહત્વપૂર્ણ કઠોળ પાકોમાં ગણવામાં આવે છે. ચણાની ખેતી શુષ્ક અને ઠંડી વાતાવરણમાં…
એરંડાની ખેતીથી ખેડૂતો થશે સમૃદ્ધ, જાણો સંપૂર્ણ માહિતી
આપણા દેશના ખેડૂતો પરંપરાગત ખેતીની સાથે તેમની આવક વધારવા માટે વ્યાપારી ખેતી તરફ વળ્યા છે. આ એપિસોડમાં, ખેડૂત ભાઈઓ એરંડાની ખેતી કરીને સારો નફો કમાઈ…
તરબૂચની ખેતી કેવી રીતે કરવી: તરબૂચની અદ્યતન ખેતીની પદ્ધતિ જાણો
સમગ્ર દેશમાં રવિ પાકની લણણી ચાલી રહી છે. માર્ચ સુધીમાં કાપણી પૂર્ણ થઈ જશે અને ત્યાર બાદ ખેતરો ખાલી થઈ જશે. આવી સ્થિતિમાં ખેડૂતો તરબૂચની…
Kisan Credit Card :ઘરે બેઠા કિસાન ક્રેડિટ કાર્ડ (KCC) રિન્યૂ કરો, જાણો શુ છે પ્રક્રિયા
ડેબિટ અને ક્રેડિટ કાર્ડની જેમ, કિસાન ક્રેડિટ કાર્ડની પણ એક્સપાયરી ડેટ હોય છે અને તેને સમય સમય પર રિન્યૂ કરાવવાની હોય છે. જો તમારું KCC…
ગરમ આબોહવામાં વધુ પ્રતિક્રિયા આપે છે છોડ, બંધ કરી દે છે ફળનું ઉત્પાદન
છોડના નવા અભ્યાસમાં જાણવા મળ્યું છે કે હવામાનમાં ફેરફારને કારણે થોડી વધેલી ગરમી પણ ફળો અને બીજનું ઉત્પાદન ઘટાડવાનું કામ કરે છે. અભ્યાસમાં એવું જોવામાં…
Zomato Layoffs: Zomato માં મંદીના આસાર, કંપની કરશે 4 ટકા કર્મચારીઓની છટણી
ફૂડ એગ્રીગેટર ઝોમેટોમાં છટણી વિશે જાણતા લોકોએ જણાવ્યું છે કે હાલ કંપનીમાંથી ઓછામાં ઓછા 100 કર્મચારીઓની છટણી કરવામાં આવી છે. તેમાં પ્રોડક્ટ, ટેક, કેટલોગ અને…
ઊંડુ ખેડાણ કરવાથી કયા-કય ફાયદા થાય છે તે જાણો
ખેડાણનો વૈજ્ઞાનિક અર્થ એ છે કે જમીનને કાંપીને તેને એવી રીતે ઉથલાવવી કે જમીનની ઉપરની સપાટીની માટી નીચે જાય અને નીચેની જમીન ઉપર આવે. તેથી…
મસાલા પાકોનું ઉત્પાદન વધારવાની ખેત પદ્ધતિઓ
મસાલાવાળા પાકો જે સુકા બીજ ધરાવે છે અને જેનો ઉપયોગ મસાલા તરીકે થાય છે તે પાકોનું ધનિષ્ઠ રીતે સુકા અને અર્ધસુકા વસ્તારમાં શિયાળુ ઋતુમા વાવેતર…
2050 સુધીમાં ભારત બનશે વિશ્વની બીજી સૌથી મોટી અર્થવ્યવસ્થા, ગૌતમ અદાણીની આગાહી
એશિયાના સૌથી ધનિક વ્યક્તિ ગૌતમ અદાણીએ શનિવારે કહ્યું કે ભારત 2050 સુધીમાં વિશ્વની બીજી સૌથી મોટી અર્થવ્યવસ્થા બની જશે. તેમણે કહ્યું કે દેશને $1000 બિલિયનની…
બિનજરૂરી ખર્ચ કરતા પહેલા ચેતી જજો, વિશ્વ આર્થિક મંદી તરફ આગળ વધી રહ્યુ છે, જેફ બેઝોસની ચેતવણી
વિશ્વના બિજા સૌથી ધનિક વ્યક્તિ અને એમેઝોનના સ્થાપક જેફ બેઝોસે પોતાના એક નિવેદનમાં જણાવ્યુ છે કે ટૂંક સમયમાં જ વિશ્વ મંદીની ઝપેટમાં આવવાનું છે. તેમણે…
ભારતીય તટરક્ષક દળે ગુજરાતમાં 20મી રાષ્ટ્રીય મેરિટાઇમ સર્ચ અને રેસ્ક્યૂ બોર્ડ બેઠકનું આયોજન કર્યું
ભારતીય તટરક્ષક દળ (ICG) દ્વારા ગુજરાતમાં કેવડિયા ખાતે શુક્રવાર, 18 નવેમ્બર 2022ના રોજ વાર્ષિક મેરિટાઇમ સર્ચ અને રેસ્ક્યૂ (M-SAR) બેઠકની શ્રેણીના ભાગરૂપે 20મી રાષ્ટ્રીય મેરિટાઇમ…
ICAR-IARI, નવી દિલ્હી ખાતે આરોગ્ય જાગૃતિ દિવસ
PG સ્કૂલ ICAR-IARI, નવી દિલ્હીએ પુસા ઇન્સ્ટિટ્યૂટ લેડીઝ એસોસિએશન (PILA) ના સહયોગથી આજે (18મી નવેમ્બર 2022)ના રોજ સ્વાસ્થ્ય જાગૃતિ દિવસનું આયોજન કર્યું.…
અખરોટની ખેતી કેવી રીતે કરવી: જાણો, અખરોટની જાતો અને ખેતી પદ્ધતિ
ડ્રાયફ્રુટ્સની ખેતી કરીને ખેડૂતો સારો નફો મેળવી શકે છે. આમાં અખરોટની ખેતી ખેડૂતો માટે ખૂબ જ ફાયદાકારક સાબિત થઈ શકે છે. બજારમાં અખરોટની માંગ પણ…
રવિ સિઝનની જરૂરિયાતોને પહોંચી વળવા દેશમાં યુરિયા, DAP, MOP, NPKS અને SSP ખાતરોની પૂરતી ઉપલબ્ધતા
ત્રિચી, તમિલનાડુ અને રાજસ્થાનમાં ખાતરની અછત હોવાનો દાવો કરતા કેટલાક મીડિયા અહેવાલો આવ્યા છે. આવા અહેવાલો તથ્યોથી પર છે. એવી સ્પષ્ટતા કરવામાં આવી છે કે…
ભારતની અગ્રણી કૃષિ લુબ્રિકન્ટ ઉત્પાદક, ગાંધારની દુનિયાની એક ઝલક
ખેતીમાં, સારા ઉત્પાદન માટે ટ્રેક્ટર, ટિલર, પંપ સેટ, બેઈલર, ટ્રક, એર કોમ્પ્રેસર અને વેક્યુમ પંપ જેવા સાધનો અનિવાર્ય છે, તેથી જટિલ સમયગાળા દરમિયાન આ મશીનોની…
ઝડપી વિકાસ કામો અને મજબૂત કાયદો અને વ્યવસ્થાના કારણે ગુજરાતમાં ફરી એકવાર ભાજપ સરકાર: કૈલાશ ચૌધરી
કેન્દ્રીય કૃષિ રાજ્ય મંત્રી કૈલાશ ચૌધરીએ સાબરકાંઠા જિલ્લાના હિંમતનગર વિધાનસભા મત વિસ્તારના ભાજપના ઉમેદવાર વિનેન્દ્રસિંહ ઝાલાની નોમિનેશન બેઠકમાં હાજરી આપી અને સાથે સાથે ગુજરાતની જનતાને…
કેન્દ્રીય પર્યાવરણ, વન અને આબોહવા પરિવર્તન મંત્રીએ COP 27 ખાતે “સ્મોલ આઇલેન્ડ ડેવલપિંગ સ્ટેટ્સ (SIDS)માં પ્રતિરોધક ઇન્ફ્રાસ્ટ્રક્ચરને વેગ આપવો” વિષય પર આયોજિત સત્રમાં ભાગ લીધો
મુખ્ય અંશો: • ‘પ્રતિરોધક આઇલેન્ડ સ્ટેટ્સ માટે ઇન્ફ્રાસ્ટ્રક્ચર’ (IRIS)ની દૂરંદેશી રજૂ કરવામાં આવી. • IRIS હેઠળની પરિયોજનાઓના અમલીકરણ માટે પ્રથમ ‘પ્રસ્તાવના આહ્વાન’ની જાહેરાત કરવામાં આવી.…
પ્રધાનમંત્રી 19મી નવેમ્બરના રોજ અરૂણાચલ પ્રદેશ અને ઉત્તર પ્રદેશની મુલાકાત લેશે
પૂર્વોત્તરમાં કનેક્ટિવિટીને પ્રોત્સાહન આપવા માટેનાં મહત્ત્વપૂર્ણ પગલાં સ્વરૂપે પ્રધાનમંત્રી અરૂણાચલ પ્રદેશમાં પ્રથમ ગ્રીનફિલ્ડ એરપોર્ટ –'ડોની પોલો એરપોર્ટ, ઇટાનગર'નું ઉદઘાટન કરશે…
દેશની આ 10 મોટી યુનિવર્સિટીમાંથી તમે ઘરે બેઠા કરી શકો છો અભ્યાસ, મેળવી શકો છો મનચાહી ડિગ્રી
દેશમાં ડિસ્ટેન્સ લર્નિંગ પ્રદાન કરતી ઘણી સંસ્થાઓ છે. આ સંસ્થાઓમાંથી વિદ્યાર્થીઓ તેમના મનપસંદ કોર્સ ઘરે બેસીને સરળતાથી કરી શકે છે.…
ઘરેથી શરૂ કરો આ બિઝનેસ, સરકાર આપશે બેંક લોન પર સબસિડી
જો તમે નવો બિઝનેસ શોધી રહ્યા છો અને તમને તેના માટે કોઈ આઈડિયા નથી મળી રહ્યો, તો અમે લાવ્યા છીએ એક એવો બિઝનેસ આઈડિયા જેની…
LPG ઉપભોક્તાઓ માટે સારા સમાચાર, સરકાર બનાવી રહી છે સિલિન્ડરનું 'આધાર કાર્ડ'
એલપીજી સિલિન્ડરનો ઉપયોગ કરતા ગ્રાહકો માટે સારા સમાચાર છે. ઇન્ડિયન ઓઇલે સિલિન્ડરમાં ઓછો ગેસ ભરવા અને તેની હેરાફેરી જેવી ઘટનાઓને રોકવા માટે એક મોટી યોજના…
પરાલી એક ગંભીર સમસ્યા બની રહી છે પરાલી એક ગંભીર સ્વરૂપ ધારણ કરી રહેલી સમસ્યા
પરાલી સળગાવવાની સમસ્યાનો ઉકેલ: પુસા ડી-કંપોઝર - પુસા ડી-કંપોઝર કેપ્સ્યુલ એ ભારતીય કૃષિ સંશોધન સંસ્થા દ્વારા વિકસાવવામાં આવેલ એક એવો ઉકેલ છે. જેના કારણે પાકના…
ગાયના દૂધ અને છોડ આધારિત દૂધની આ કેટલીક હકીકત જાણો
ભારતમાં ઓપરેશન ફ્લડની સફળતા પછી, ડેરી અને પશુપાલન ક્ષેત્ર લગભગ 100 મિલિયન ગ્રામીણ પરિવારો માટે આવકના પ્રાથમિક સ્ત્રોત તરીકે ઉભરી આવ્યું - જેમાં જમીનવિહોણા, નાના…
લોકશાહીના મહાપર્વમાં અચૂક નૈતિક મતદાન સંદર્ભે મહા સિગ્નેચર અભિયાન
અમદાવાદના સરકારી, ખાનગી અને જાહેર સ્થળોએ યોજાયું મતદાર જાગૃતિ મહા સિગ્નેચર અભિયાન…
રબરની ખેતી કરી ખેડૂતો કમાઈ શકે છે જંગી નફો, જાણો રબરની ખેતીની પદ્ધતિ
ભારત એક કૃષિપ્રધાન દેશ છે. ભારતની લગભગ 60 ટકાથી વધુ વસ્તી આડકતરી રીતે કૃષિ ક્ષેત્ર પર નિર્ભર છે. ભારતના ખેડૂતો હવે પરંપરાગત ખેતી સાથે તેમની…
બારેમાસ મળતું લીલુંખાતર : એઝોલા
ખાતર તરીકે વપરાતી લીલી અવિઘટિત વનસ્પતિ ને લીલું ખાતર કહેવાય છે. લીલું ખાતર એ કુદરતી ખાતરોમાનું એક છે જે સજીવ ખેતી માટે હિમાયત કરે છે…
કૃષિ અર્થતંત્રમાં દેશને સંકટમાંથી બહાર કાઢવાની શક્તિ છેઃ શ્રી તોમર
કૃષિ અર્થવ્યવસ્થામાં દેશને કટોકટીમાંથી બહાર કાઢવાની શક્તિઃ શ્રી તોમર - કેન્દ્રીય કૃષિ મંત્રી શ્રી નરેન્દ્ર સિંહ તોમરે જણાવ્યું હતું કે આ કૃષિ મેળો અદ્યતન કૃષિના…
ખેડૂતોને પરલીમાંથી પ્રતિ એકર મળી રહ્યા છે 11000 રૂપિયા, ખેડૂતો ટ્રોલીઓ ભરી ભરીને જઈ રહ્યા છે વેચવા
ખેડૂતોને પરાલીમાંથી પ્રતિ એકર 11000 રૂપિયા મળી રહ્યા છે, ખેડૂતો ટ્રોલી ભરી ભરીને પરાલી વેચવા જઈ રહ્યા છે.…
Petrol Diesel Prices : બ્રેન્ટ ક્રૂડના ભાવમાં નજીવો વધારો, શું પેટ્રોલ અને ડીઝલના ભાવમાં પણ થયો ફેરફાર
છેલ્લા 24 કલાક દરમિયાન વૈશ્વિક બજારમાં કાચા તેલની કિંમતોમાં થોડો ઉછાળો આવ્યો છે, પરંતુ તેની અસર સ્થાનિક બજારમાં પેટ્રોલ અને ડીઝલની છૂટક કિંમતો પર થઈ…
પશુઓના જૈવિક કચરાનું વ્યવસ્થાપન
ભારતમાં કૃષિ અને પશુપાલનએ એકબીજાના પુરક વ્યવસાય છે અને તેના ઉપર ૭૫ % થી વધુ ગ્રામ્ય વસ્તી આવકની દ્રષ્ટીએ નિર્ભર છે. કૃષિ અને પશુપાલન થકી…
સર્વ વિદ્યાલય કેળવણી મંડળ કડી-ગાંધીનગર દ્વારા આયોજિત કાયરોકપ્રેકટર કેમ્પમાં 2000થી વધુ લોકોએ સારવાર લીધી
સર્વ વિદ્યાલય કેળવણી મંડળ કડી-ગાંધીનગર દ્વારા આયોજિત ત્રિ-દિવસીય કાયરોપ્રેકટર કેમ્પ સંપન્ન…
PM Kisan Yojana: PM મોદીની ખેડૂતોને ભેટ, ખાતામાં આવશે પૂરા 15 લાખ રૂપિયા, આ રીતે કરો અરજી
કેન્દ્ર અને રાજ્ય સરકારો ખેડુતોના આર્થીક વિકાસને ધ્યાનમાં રાખીને અવાર નવાર નવી નવી યોજનાઓ બહાર પાડતી હોય છે તેવી જ એક યોજના છે પીએમ કિસાન…
પેટ્રોલ અને ડીઝલ GSTના દાયરામાં! કેન્દ્ર સરકાર થઈ તૈયાર
પેટ્રોલિયમ અને કુદરતી ગેસ મંત્રી હરદીપ સિંહ પુરીએ સોમવારે જણાવ્યું હતું કે કેન્દ્ર સરકાર પેટ્રોલ અને ડીઝલને ગુડ્સ એન્ડ સર્વિસ ટેક્સ (GST)ના દાયરામાં લાવવા માટે…
કેન્દ્ર સરકારની પેન્શન અને પેન્શનર્સ કલ્યાણ વિભાગની ટીમે અમદાવાદમાં ડિજિટલ જીવન પ્રમાણપત્ર અંગે જાગૃતિ અભિયાનનું આયોજન કર્યું
પેન્શન અને પેન્શનર્સ કલ્યાણ વિભાગ, કર્મચારી, જાહેર ફરિયાદ અને પેન્શન મંત્રાલય, ભારત સરકાર દ્વારા કેન્દ્ર સરકારના પેન્શનરો માટે ડિજિટલ જીવન પ્રમાણપત્રને પ્રોત્સાહન આપવા માટે દેશવ્યાપી…
ગ્લોબલ વોર્મિંગઃ ઘઉં, ડાંગર અને મકાઈની ઉપજમાં ઘટાડો થવાની શક્યતા
ગ્લોબલ વોર્મિંગ ભારત માટે તેમજ સમગ્ર વિશ્વ માટે જોખમી છે. દિન-પ્રતિદિન થઈ રહેલા હવામાન પરિવર્તનની સાથે તેની વધતી અસર કૃષિ ક્ષેત્ર પર પણ જોવા મળી…
ગાય, ભેંસનો સમતોલ આહાર નિર્ધારણ કરીને દૂધના પ્રમાણમાં કરો અનેક ગણો વધારો
ભારતમાં પ્રાચીન સમયથી પશુપાલન પ્રચલિત છે. જેમાં મુખ્યત્વે ગાય, ભેંસ જેવા દુધાળા પશુઓને દૂધ ઉત્પાદન માટે ઉછેરવામાં આવે છે. મોટાભાગના પશુપાલકો ફરિયાદ કરે છે કે…
ભારતે તેની લાંબા ગાળાની ઓછાં ઉત્સર્જન વિકાસની વ્યૂહરચના યુએનએફસીસીસીને સુપરત કરી
ભારતે આજે 27મી કૉન્ફરન્સ ઑફ પાર્ટીઝ (સીઓપી27) દરમિયાન યુનાઈટેડ નેશન્સ ફ્રેમવર્ક કન્વેન્શન ઓન ક્લાઇમેટ ચેન્જ (યુએનએફસીસીસી)ને તેની લાંબા ગાળાની ઓછાં ઉત્સર્જન વિકાસ વ્યૂહરચના સુપરત કરી…
DA Hike: સરકારી કર્મચારીઓને ભેટ, મળશે 42% મોંઘવારી ભથ્થું! સરકાર આ દિવસે કરશે જાહેરાત
કેન્દ્રીય કર્મચારીઓને સરકાર તરફથી સતત મોટી ભેટો મળી રહી છે. જ્યાં એક તરફ સરકાર કર્મચારીઓના ફિટમેન્ટ ફેક્ટરમાં વધારો કરવાની યોજના બનાવી રહી છે તો બીજી…
G-20 સમિટમાં ભાગ લેવા પીએમ ઇન્ડોનેશિયા રવાના, 15-16 નવેમ્બરના રોજ જી-20 સમિટ યોજાશે.
G-20 અથવા 20 દેશોનું જૂથ એ વિશ્વની મુખ્ય વિકસિત અને વિકાસશીલ અર્થવ્યવસ્થાઓનું આંતર-સરકારી મંચ છે.…
મતદાર જાગૃતિ મલ્ટીમીડિયા પ્રદર્શનનું ગુજરાત યુનિવર્સિટી ગ્રંથાલય ખાતે જિલ્લા કલેકટરશ્રી ડૉ.ધવલ પટેલના હસ્તે થયું ઉદ્ઘાટન
કેન્દ્રીય સંચાર બ્યુરો અને ગુજરાત યુનિવર્સિટીના સંયુક્ત આયોજન દ્વારા મતદાર જાગૃતિ અભિયાનનો થયો પ્રારંભ સિગ્નેચર કેમ્પેઈન, રેલી, સંવાદ, શેરી નાટક, શપથ, વિભિન્ન સ્પર્ધાઓ સાથે બહુવિધ…
સામાન્ય ગ્રાહકને મોંઘવારીમાંથી રાહત! જથ્થાબંધ ફુગાવો 8 મહિનામાં પ્રથમ વખત 10% થી નીચે
જથ્થાબંધ મોંઘવારી દર (WPI) ઘટીને 8.39 ટકા પર આવી ગયો છે. માસિક ધોરણે જથ્થાબંધ મોંઘવારી દર 10.70 ટકાથી ઘટીને અહીં આવી ગયો છે. લગભગ 19…
ગેસના ભાવને લઈને મોટો નિર્ણય, હવે ખિસ્સા પર વધશે બોજ
ગેસના ભાવને લઈને એક નવું અપડેટ આવ્યું છે અને તમે આ જાણીને ચોંકી જશો. જાણો તમારા ખિસ્સા પર કેટલો બોજ વધશે.…
માલામાલ બનાવી દેશે તમને આ ચમત્કારી વૃક્ષનું મૂળ
શાસ્ત્રો અનુસાર, કેટલાક છોડ એવા હોય છે જેને આપણે શ્રદ્ધા અને વિશ્વાસથી પોતાની સાથે રાખીએ છીએ, તો તે આપણું નસીબ ખૂબ પ્રબળ બનાવે છે અને…
છોડો હવે દીકરીના લગ્નની ચિંતા, 7 વર્ષમાં આ રીતે જમા કરાવો 50 લાખ રૂપિયા
ભારતમાં, લોકો ઘણીવાર દીકરીના જન્મની સાથે જ તેમના લગ્નની ચિંતા કરે છે. પરંતુ હવે ધીમે ધીમે લોકોની વિચારસરણી બદલાવા લાગી છે. હવે પુત્ર અને પુત્રી…
ઇફ્કોનું કોનાત્સુ: એક પાક-મૈત્રીપૂર્ણ બ્રોડ-સ્પેક્ટ્રમ જંતુનાશક
કૃષિ વિશ્વમાં, જંતુઓ ઘણીવાર પાકને ખાઈને અથવા મહત્વપૂર્ણ પોષક તત્વોને દૂર કરીને નુકસાન પહોંચાડે છે. ખેડૂતો નુકસાનને રોકવા માટે જીવાતોના ઉપદ્રવને ઘટાડવા અથવા દૂર કરવા…
નેશનલ ફિશરીઝ ડેવલપમેન્ટ બોર્ડ દ્વારા "ઇન્ડિયા એગ્રીબિઝનેસ એવોર્ડ 2022" એનાયત
ડૉ. સંજીવ કે બાલ્યાન, MoS MoFAHD અને ડૉ. રમેશ ચંદ, સભ્ય, નીતિ આયોગે NFDBને “ઇન્ડિયા એગ્રીબિઝનેસ એવોર્ડ્સ 2022 અર્પણ કર્યા…
સુક્ષમતત્વોની ઉણપ દુર કરવાના ઉપાયો અને વધુ પડતા ઉપયોગથી સર્જાતી પ્રતિકૂળ અસરો
પોષક તત્વોની ઉણપ સહેલાઈથી વર્તાય તેવા દર્શક પાકો કેટલાક પાકો અમુક તત્વોની ઉણપની અસર ઝડપથી બનાવતા હોય છે. પોષકતત્વોની અછત પ્રત્યેની સહન ક્ષમતા જુદા જુદા…
રજનીગંધાની ખેતીઃ આ ફુલની કરો કમાણી થશે બમ્પર કમાણી
સુગંધિત ફૂલોમાં પણ રજનીગંધા એક અલગ મહત્વનું સ્થાન ધરાવે છે. રજનીગંધાના ફૂલો લાંબા સમય સુધી સુગંધિત અને તાજા રહે છે. તેથી, બજારમાં તેમની માંગ ઘણી…
Union Budget 2023: નાણાપ્રધાન નિર્મલા સીતારમણની અધ્યક્ષતામાં 21 નવેમ્બરથી શરૂ થશે પ્રી-બજેટ બેઠકોનો રાઉન્ડ!
Budget 2023-24: દર વર્ષે બજેટ તૈયાર કરતા પહેલા નાણામંત્રીની સ્ટેકહોલ્ડર્સ સાથે પ્રી-બજેટ મીટિંગ હોય છે. જેમાં ભાગ લેનાર પ્રતિનિધિઓ તેમના વતી બજેટ અંગે સૂચનો આપે…
ભારી ઉદ્યોગ મંત્રાલય દ્વારા ઇન્ડસ્ટ્રી 4.0 નેશનલ કોન્ફરન્સ યોજાઈ
માનનીય પ્રધાનમંત્રી શ્રી નરેન્દ્ર મોદીના દૂરંદેશી નેતૃત્વ હેઠળ ભારત વૈશ્વિક ઉત્પાદન હબ તરીકે ઉભરી રહ્યું છે: ડૉ. મહેન્દ્રનાથ પાંડે…
IRMA ખાતે 18 જિલ્લા સહકારી દૂધ ઉત્પાદક સંઘો અને 18 જિલ્લા મધ્યસ્થ સહકારી બેંકો માટે 1-દિવસીય ખરીદનાર અને વિક્રેતા તાલીમ કાર્યક્રમનું આયોજન કરવામાં આવ્યું
18 જિલ્લા સહકારી દૂધ ઉત્પાદક સંઘો અને 18 જિલ્લા મધ્યસ્થ સહકારી બેંકો માટે 1-દિવસીય ખરીદનાર અને વિક્રેતા તાલીમ કાર્યક્રમનું આયોજન AMUL, નેશનલ કોઓપરેટિવ યુનિયન ઓફ…
ડિપાર્ટમેન્ટ ફોર પ્રમોશન ઓફ ઈન્ડસ્ટ્રી એન્ડ ઈન્ટરનલ ટ્રેડ (DPIIT) એ સ્ટાર્ટઅપ્સ (CGSS) માટે ક્રેડિટ ગેરંટી સ્કીમની સ્થાપનાની સૂચના આપી
ધિરાણ આપતી સંસ્થાઓ માટે ચાવીરૂપ સક્ષમ અને જોખમ ઘટાડવાના માપદંડ તરીકે કાર્ય કરવા માટેની યોજના, સ્ટાર્ટઅપ્સને કોલેટરલ ફ્રી ફંડિંગને સક્ષમ બનાવે છે…
કોઠીંબાની ખેતી અને તેનું મૂલ્ય વર્ધન
કોઠીંબા એ કાકડી પ્રજાતિનું વેલામાં થતું શાકભાજી છે. જે ભારતમાં પ્રચલિત છે તેમજ ગુજરાતમાં સામાન્ય રીતે એ કોઠીંબા તરીકે ઓળખાય છે. કોઠીંબાનો વેલો, ચોતરફ ફેલાયેલો,…
PM Kisan Tractor Yojana:ટ્રેક્ટરની ખરીદી પર મળશે 50% સબસિડી, કેન્દ્ર સરકાર લાવી છે આ ખાસ યોજના
મોદી સરકાર ખેડૂતોની આવક વધારવા અને તેમને આર્થિક મદદ કરવા માટે ઘણી યોજનાઓ લાવી રહી છે. પીએમ કિસાન હેઠળ ખેડૂતોના ખાતામાં વાર્ષિક 6000 રૂપિયા જમા…
અર્ધ શિયાળુ બાજરી – એક નવીન અભિગમ
ભારતવર્ષમાં કૃષિ એક અગ્રીમ ક્ષેત્ર છે. ભારતમાં લોકો મુખ્યત્વે સીધી અથવા આડકતરી રીતે ખેતી પર નભે છે. હાલનાં બદલાતા જળવાયું પરિવર્તનના યુગમાં કૃષિપાકો સામે અનેક…
PM Awas Yojana: PM આવાસ યોજનાની નવી યાદી જાહેર, તમારું નામ આ રીતે તપાસો
પ્રધાનમંત્રી આવાસ યોજનાની નવી યાદી બહાર પાડવામાં આવી છે. સરકાર લોકોને ઘર બનાવવા માટે લોન પર સબસિડીની સુવિધા આપે છે.…
12 નવેમ્બર 2022ના રોજ દેશભરમાં રાષ્ટ્રીય લોક અદાલત યોજાશે
ગ્રાહક બાબતોનો વિભાગ ગ્રાહકોના પડતર કેસોને પતાવટ દ્વારા નિકાલ માટે રાષ્ટ્રીય લોક અદાલતમાં રિફર કરશે…
ભારત સરકારના રક્ષા અને પ્રવાસન રાજ્યમંત્રી શ્રી અજય ભટ્ટે વડોદરામાં ડિફેન્સ કચેરીની મુલાકાત લીધી
ભારત સરકારના રક્ષા અને પ્રવાસન રાજ્યમંત્રી અજય ભટ્ટ આજે વડોદરાની મુલાકાતે આવ્યા હતા.વડોદરાની મુલાકાત દરમિયાન તેમણે વડોદરામાં આવેલ ડિફેન્સ કચેરીની મુલાકાત લીધી હતી તેમજ એનસીસીની…
બાલોતરામાં કેન્દ્રીય મંત્રી કૈલાશ ચૌધરી દ્વારા લોકસભા કક્ષાની "સાંસદ ગરબા સ્પર્ધા"નું આયોજન
કેન્દ્રીય કૃષિ રાજ્ય મંત્રી કૈલાશ ચૌધરી સાંજે 5:00 વાગ્યે બાલોતરામાં લોકસભા મતવિસ્તાર-સ્તરની સાંસદ ગરબા સ્પર્ધાનું આયોજન કરશે, જેમાં બાડમેર, જેસલમેર અને બાલોતરાના કાર્યકરો અને સામાન્ય…
પ્રોડક્ટ પર નથી બનાવવા વાળા દેશનું નામ, તો ઈ-કોમર્સ પોર્ટલ જવાબદાર રહેશે, થઈ શકે છે દંડ
જો ઈ-કોમર્સ પોર્ટલ પર વેચાતી પ્રોડક્ટ પર જો બનાવવા વાળા દેશના નામનો ઉલ્લેખ નથી, તો પોર્ટલ પોતે આ પ્રોડક્ટ માટે જવાબદાર રહેશે. હૈદરાબાદના ડિસ્ટ્રિક્ટ કન્ઝ્યુમર…
કૃષિ ઉન્નતિ સંમેલન 2022: ઓડિશાનું સૌથી મોટું કૃષિ પ્રદર્શન આવી રહ્યું છે આ 17મીએ
કૃષિ ઉન્નતિ સંમેલન 2022 એ કૃષિ ઉદ્યોગોને તેમની નવીનતમ તકનીકી નવીનતાઓ પ્રતિભાગીઓને પ્રદર્શિત કરવા માટે એક પ્લેટફોર્મ પૂરું પાડશે.…
Vande Bharat Express: મુંબઈ-ગાંધીનગર વચ્ચે દોડતી વંદે ભારત એક્સપ્રેસનો થયો અકસ્માત, ભેંસોના ટોળા સાથે અથડાઈ
વટવા સ્ટેશનથી મણિનગર વચ્ચેની રેલ્વે લાઇન પર ભેંસોનું ટોળું આવવાના કારણે સવારે 11.15 વાગ્યે આ અકસ્માત થયો હતો. ટ્રેનના એન્જિનના આગળના ભાગને નુકસાન થયું હતું.…
ખેડુતોને આ રીતે લિસ્ટમાં ચેક કરી શકો છો પોતાનુ નામ, જાણો પીએમ કિસાન યોજનાનો 12મો હપ્તો ક્યારે આવી શકે છે?
ખેડુતો માટે કેન્દ્ર અને રાજ્ય સરકારો અવાર નવાર નવી નવી યોજનાઓ બહાર પાડતી હોય છે. આપણા દેશમાં આવી ઘણી યોજનાઓ ચાલે છે, જેનો હેતુ ગરીબ…
લીંબુ અને તેની સાથે જોડાયેલા હાનિકારક જંતુઓના રોગો તથા તેને લગતી દવા
ખેતી અને ખેતી વિશેની આ માહિતીમાં, આજે આપણે લીંબુના રોગો વિશે વાત કરવા જઈ રહ્યા છીએ. જો તમારે લીંબુની ખેતી કરવી હોય તો તેના માટે…
કોબીની ખેતી કેવી રીતે કરવી તે વિશે A to Z માહિતી જાણો
આજે આપણે કોબીની ખેતી કેવી રીતે કરવી અને કઈ બાબતની કાળજી રાખવી તે અંગે વિશેષ વાત કરશું. ખાસ કરીને આ ખેતીમાં તાજુ ગાયનું છાણ ખૂબ…
MSP ગેરંટી પર ખેડૂતો કરશે શક્તિ પ્રદર્શન, દિલ્હીમાં 200 ખેડૂત સંગઠનો ભેગા થશે - જાણો શું છે તૈયારી
આ દરમિયાન દેશભરના વિવિધ સંગઠનોને એક મંચ પર લાવવાનો ખેડૂતોનો પ્રયાસ રહેશે. તેને ખેડૂતોની શક્તિનું પ્રદર્શન માનવામાં આવી રહ્યું છે.…
ભારત સમગ્ર વિશ્વમાં ખાંડના સૌથી મોટા ઉત્પાદક અને ઉપભોક્તા તરીકે તેમજ દુનિયામાં બીજા ક્રમના સૌથી મોટા ખાંડના નિકાસકાર તરીકે ઉભરી આવ્યું
ખાંડની સિઝન 2021-22માં 5000 LMT શેરડીનું વિક્રમી ઉત્પાદન થયું હોવાનું નોંધાયું; સિઝનમાં 35 LMT ખાંડનો ઉપયોગ ઇથેનોલ ઉત્પાદન માટે થયો અને 359 LMT ખાંડનું ઉત્પાદન…
જંતુનાશક દવાઓનાં ઉપયોગમાં સાવચેતી
કૃષિ ક્ષેત્રે જંતુનાશક, ફૂગનાશક અને નિંદામણનાશક દવાઓનો ઉપયોગ કૃષિ ઉત્પાદનનો એક મહત્વપૂર્ણ ભાગ બની ગયેલ છે. ખેતીપાકો, શાકભાજી, બાગાયત વગેરે માંથી કયું એવું ક્ષેત્ર છે…
પાંદડાવાળા શાકભાજીમાં સંકલિત જીવાત વ્યવસ્થાપન
પુખ્ત રાખોડી રંગનું લાંબી ચાંચવાળું હોય છે. તે કુમળા પાન અને થડને નુકશાન કરે છે. ઇંડા આછા પીળા રંગના ગોળ હોય છે અને એકલ દોકલ…
સનાયા: બહુમુખી અને પ્રતિભાશાળી ઔષધીય વનસ્પતિ
એક બહુમુખી ઔષધીય વનસ્પતિ - વ્યાપારી દૃષ્ટિકોણથી વિવિધ પ્રજાતિઓનો ઉપયોગ દવા તરીકે થાય છે, સનાયા (સેના) એક મહત્વપૂર્ણ ઔષધીય વનસ્પતિ છે જેનો ઉપયોગ યુનાની અને…
પ્રાકૃતિક ખેતી, આધુનિક રસાયણિક જહરયુક્ત ખેતી
એક પ્રશ્ન ઉકેલ છે. આ રીતે ખેતીમાં રસાયણોનો ઉપયોગ કર્યા વિના અને સફળ સતત ઉપાયોથી ખેડૂતો જહર મુક્ત ખેતી કરી શકાય છે. આ રીતે ખેતીમાં…
વટાણાની ખેતી ક્યારે અને કેવી રીતે કરવી, જાણો વાવણીનો યોગ્ય સમય
વટાણાની ખેતી (માતરની ખેતી) સામાન્ય રીતે શિયાળુ પાક છે. વટાણાની ખેતી માત્ર સારો નફો જ આપે છે, પરંતુ તે ખેતરની ફળદ્રુપતા પણ વધારે છે. તેમાં…
આર્થિક કટોકટી પછી બ્લેકઆઉટ, નેશનલ પાવર ગ્રીડ નિષ્ફળ, સમગ્ર બાંગ્લાદેશ અંધકારમાં
બાંગ્લાદેશમાં મંગળવારે દેશભરમાં અંધારપટ છવાયો હતો. નેશનલ પાવર ગ્રીડની નિષ્ફળતાને કારણે આવું બન્યું છે. અધિકારીઓએ આ માહિતી આપી હતી. બાંગ્લાદેશ પાવર ડેવલપમેન્ટ બોર્ડના અધિકારીઓએ જણાવ્યું…
ભારત ટેકમાં વિશ્વનું નેતૃત્વ કરશે: રાજ્યમંત્રી શ્રી રાજીવ ચંદ્રશેખર
પીએમ મોદી અંતર્ગત, તકોનું લોકશાહીકરણ અને મૂડીનું લોકશાહીકરણ છે: રાજ્યમંત્રી રાજીવ ચંદ્રશેખર ધોલેરા સેમીકોન હબ બનશે, ગુજરાતના ટેકડેની શરૂઆત કરશે…
શાકભાજી પાકો માં સંકલિત જીવાત વ્યવસ્થાપન
પાક ઉત્પાદન વધારે મેળવવા માટે પાક સંરક્ષણ અંગેની સાચી સમજ હોવી ખુબ જ જરૂરી છે. કીટનાશક માટે જુદી જુદી પધ્ધતિઓ અપનાવવામાં આવે છે. તેમાંની સૌથી…
ભારતમાં હવે મફત રાશન યોજના માટે અનાજનો બસ આટલો બચ્યો છે જથ્થો
કોરોનાના સમયથી, સરકાર ગરીબોને ખાવા-પીવાની ચિંતાથી દૂર રાખવા માટે મફત રાશન યોજના ચલાવી રહી છે. આ અઠવાડિયે, કેન્દ્રીય કેબિનેટે આ યોજનાને વધુ 3 મહિના સુધી…
ચાલો પરાગનયન માટે ઉપયોગી એવી મધમાખીને બચાવીએ
પાક ઉત્પાદનને અસર કરતા વિવિધ જૈવિક પરિબળોમાં પરાગનયનની ક્રિયા મહત્વનો ભાગ ભજવે છે. એકદમ સાદી ભાષામાં એમ કહી શકાય કે ફૂલમાના પુંકેસર પરથી સ્ત્રીકેસર પર…
ભારતના રાષ્ટ્રપતિએ 'herSTART' લોંચ કર્યું - મહિલા ઉદ્યોગ સાહસિકો માટે ગુજરાત યુનિવર્સિટીનું એક સ્ટાર્ટ-અપ પ્લેટફોર્મ અને ગુજરાત સરકારના શિક્ષણ અને આદિજાતિ વિકાસને લગતા વિવિધ પ્રોજેક્ટ્સનું ઉદ્ઘાટન/શિલાન્યાસ કર્યો
ભારતના રાષ્ટ્રપતિ શ્રીમતી દ્રૌપદી મુર્મુએ આજે (4 ઓક્ટોબર, 2022) અમદાવાદમાં ગુજરાત યુનિવર્સિટીનું સ્ટાર્ટ-અપ પ્લેટફોર્મ 'herSTART' લોન્ચ કર્યું. તેમણે શિક્ષણ અને આદિજાતિ વિકાસને લગતી ગુજરાત સરકારની…
પાક ઉત્પાદનમાં ઉપયોગમાં લેવાતા રસાયણોની માનવ સ્વાસ્થ ઉપર અસર
પાક ઉત્પાદનમાં થતા રસાયણોનો વપરાશ ખેડૂતોએ ઘટાડવો જ પડશે. આપણા દેશમાં 1960 એટલે કે હરિયાળી કાંતિ પછીના સમયમાં વધુ ઉત્પાદન આપતી જાતો દાખલ કરી અને…
ખાદ્યતેલ, બટેટા અને ડુંગળી સહિત આ 11 વસ્તુઓના ભાવમાં ઘટાડો, સરકારે આપી મોટી માહિતી
સામાન્ય જનતા માટે એક સારા સમાચાર છે. દેશભરમાં ખાદ્યપદાર્થોની કિંમતોમાં મોટો ઘટાડો જોવા મળ્યો છે. સરકારે સોમવારે કહ્યું કે એક મહિનામાં 11 આવશ્યક ખાદ્ય ચીજોના…
પ્રધાનમંત્રી 5 ઓક્ટોબરે હિમાચલ પ્રદેશની મુલાકાત લેશે
પ્રધાનમંત્રી રૂ. 3650 કરોડથી વધુના પ્રોજેક્ટનું ઉદ્ઘાટન અને શિલાન્યાસ કરશે પીએમ બિલાસપુર એઈમ્સનું ઉદ્ઘાટન કરશે, જેનો શિલાન્યાસ પણ પીએમ દ્વારા કરવામાં આવ્યો હતો પ્રધાનમંત્રી રૂ.1690…
5Gના લોન્ચિંગ સાથે રાજ્યના IT મંત્રીઓની ડિજિટલ ઈન્ડિયા કોન્ફરન્સ યોજાઈ
12 રાજ્યો અને કેન્દ્રશાસિત પ્રદેશોના IT મંત્રીઓએ કોન્ફરન્સમાં હાજરી આપી, 5G ના રાષ્ટ્રીય રોલઆઉટનું સ્વાગત કર્યું, ડિજિટલ ઈન્ડિયા પહેલની નવીનતમ પ્રગતિ અને પ્રતિકૃતિ માટેની શ્રેષ્ઠ…
ભારતનાં રાષ્ટ્રપતિએ ગુજરાતના કંડલાનાં દીનદયાળ બંદર ખાતે રૂ.280 કરોડથી વધારેની બહુવિધ યોજનાઓનો શિલાન્યાસ કર્યો
ભારતનાં રાષ્ટ્રપતિ શ્રીમતી દ્રોપદી મુર્મુએ ગુજરાતમાં દીનદયાળ પોર્ટ ઑથોરિટી, કંડલાની રૂ.280 કરોડથી વધારે કિંમતની ચાર મહત્ત્વપૂર્ણ પરિયોજનાઓનો શિલાન્યાસ કર્યો હતો. આ પ્રોજેક્ટ્સ પોર્ટ ઇન્ફ્રાસ્ટ્રક્ચરમાં વધારો…
મંત્રાલયે ટેલિવિઝન અને ડિજિટલ મીડિયા પર હજુ પણ દેખાતી સટ્ટાબાજીની જાહેરાતો સામે એડવાઇઝરી જારી કરી
સમાચારનો સરોગેટ પ્રોડક્ટ તરીકે ઉપયોગ કરીને વિદેશી સટ્ટાબાજી પ્લેટફોર્મ્સ, સમાચારની આડમાં સટ્ટાબાજીને પ્રોત્સાહન આપે છે…
પ્રધાનમંત્રી છઠ્ઠી ઈન્ડિયા મોબાઈલ કોંગ્રેસ 2022માં ભારતમાં 5G સેવાઓ શરૂ કરશે
પ્રધાનમંત્રી શ્રી નરેન્દ્ર મોદી 01 ઓક્ટોબર, 2022ના રોજ ભારતમાં 5G સેવાઓ શરૂ કરશે અને 1-4 ઓક્ટોબર, 2022 દરમિયાન પ્રગતિ મેદાન, ન્યૂ દિલ્હી ખાતે યોજાનારી ઈન્ડિયા…
કૃષિ પાકોમાં નુકસાન કરતી ઉધઈનું સંકલિત વ્યવસ્થાપન
કીટક જગતમાં ઉધઈ કૃષિ અને બાગાયતી પાકોમાં નુકસાન કરવા ઉપરાંત લાકડામાંથી બનાવેલ ચીજવસ્તુઓ તેમજ કપડાં, પુસ્તકો વગેરેમાં નુકસાન પહોંચાડે છે. ઉધઈનો વ્યાપ ઉષ્ણ અને સમશીતોષ્ણમાં…
પ્રધાનમંત્રીએ ગુજરાતના ગાંધીનગર સ્ટેશન પર ગાંધીનગર અને મુંબઈ વચ્ચે નવી વંદે ભારત એક્સપ્રેસને લીલી ઝંડી બતાવી
પ્રધાનમંત્રી નરેન્દ્ર મોદીએ આજે ગાંધીનગર સ્ટેશનથી ગાંધીનગર-મુંબઈ વંદે ભારત એક્સપ્રેસને લીલી ઝંડી બતાવી અને ત્યાંથી કાલુપુર રેલવે સ્ટેશન સુધી ટ્રેનમાં મુસાફરી કરી.…
FD પર મળશે વધુ વળતર, RBIના આ પગલા બાદ બેંકો વ્યાજદર વધારશે
આશા છે કે ટૂંક સમયમાં FD પર વ્યાજ દર 8 ટકાની નજીક પહોંચી જશે. વ્યાજદર વધારવામાં નાની બેંકો આગળ રહેશે.…
પ્રધાનમંત્રીએ અમદાવાદમાં 36મી નેશનલ ગેમ્સ ખુલ્લી મૂકાયાંની જાહેરાત કરી
પ્રધાનમંત્રીએ ડેસરમાં વિશ્વ કક્ષાની 'સ્વર્ણિમ ગુજરાત સ્પોર્ટ્સ યુનિવર્સિટી'નું ઉદઘાટન કર્યું "જ્યારે ઈવેન્ટ આટલી અદ્ભુત અને અનન્ય હોય, ત્યારે તેની ઊર્જા એને અસાધારણ બનાવે જ" "…
અનુરાગ સિંહ ઠાકુરે 1લીથી 31મી ઓક્ટોબર સુધી એક મહિનાના દેશવ્યાપી સ્વચ્છ ભારત 2.0ની જાહેરાત કરી
“સ્વચ્છ ભારત 2.0” 1લી ઑક્ટોબરે પ્રયાગરાજથી શરૂ કરવામાં આવશે, જેનો ઉદ્દેશ્ય જાગૃતિ લાવવા, લોકોને એકત્ર કરવા અને ભારતને સ્વચ્છ બનાવવામાં તેમની ભાગીદારી સુનિશ્ચિત કરવા માટે…
PM કિસાન યોજનાના નિયમો બદલાયા, ખેડૂતોએ કરવું પડશે હવે આ કામ
પીએમ કિસાન સન્માન નિધિ યોજના યોજનાના 12મા હપ્તાની રકમ જાહેર કરતા પહેલા સરકારે નિયમોમાં મોટો ફેરફાર કર્યો છે. આ અપડેટને કારણે દેશભરમાં 12 કરોડથી વધુ…
મશરૂમનું વ્યાપારી બીજ ઉત્પાદનની પધ્ધતિ
વર્ષ ૧૬૫૨મા કલ્પેપરએ સ્પાનને મશરૂમનું માયસેલિયમ છે એવુ વર્ણવેલ.ત્યાર્ પછી વર્ષ ૧૬૫૨ થી ૧૮૯૪ સુધી સ્પાનને બનાવવાને બદલે જંગલીમાંથી એકત્રિત કરવામાં આવતા હતા. અનાજના દાણ…
કલ્પતરુ – કેળાની ખેતીથી આવકમાં વધારો
કેળા એ ભારતના પ્રાચીન ફળોમાં એક મહત્વપૂર્ણ ફળ છે. તેના વિવિધ ઉપયોગ અને મહત્વને ધ્યાનમાં રાખીને, આ ફળને ભારતીય સંસ્કૃતિમાં કલ્પતરુ તરીકે સંબોધવામાં આવે છે.…
પાકિસ્તાનમાં હજારો ખેડૂતો ઉતરી આવ્યા રસ્તા પર
પાકિસ્તાનમાં સરકાર વિરુદ્ધ હજારો ખેડૂતો રસ્તા પર ઉતરી આવ્યા છે. કિસાન ઇત્તેહાદ સંગઠનના બેનર હેઠળ આ ખેડૂતો બીજા દિવસે પણ ઇસ્લામાબાદના રેડ ઝોનમાં સ્થિર રહ્યા…
ઓગસ્ટમાં આધાર દ્વારા 23.45 કરોડ ઈ-કેવાયસી વ્યવહારો કરવામાં આવ્યા
ઓગસ્ટમાં લગભગ 220 કરોડ આધાર ઓથેન્ટિકેશન થયા, આધારનો ઉપયોગ અને સ્વીકાર સતત વધી રહ્યા છે. UIDAIએ મહિના દરમિયાન રહેવાસીઓ તરફથી 1.46 કરોડ આધાર અપડેટ વિનંતીઓનો…
ગુજરાતના અમદાવાદ ખાતે SC-ST ઉદ્યોગ સાહસિકોમાં જાગૃતિ માટે રાષ્ટ્રીય SC-ST હબ કોન્ક્લેવ
સૂક્ષ્મ, લઘુ અને મધ્યમ ઉદ્યોગ મંત્રાલયે રાષ્ટ્રીય SC-ST હબ (NSSH) યોજના અને મંત્રાલયની અન્ય યોજનાઓ વિશે જાગૃતિ ફેલાવવા માટે 28મી સપ્ટેમ્બર 2022ના રોજ અમદાવાદ, ગુજરાત…
Gujarat Mukhyamantri Yuva Swavalamban Yojana: ગુજરાત મુખ્યમંત્રી યુવા સ્વાવલંબન યોજના, આ રીતે કરો આવેદન
ગુજરાત સરકારે ગરીબ બાળકોને સારું શિક્ષણ આપવા માટે મુખ્યમંત્રી યુવા સ્વાવલંબન યોજના શરૂ કરી છે. આમાં સરકાર તેમને શિષ્યવૃત્તિના રૂપમાં 1 લાખ રૂપિયા સુધીની સહાય…
જીરૂની વૈજ્ઞાનિક ખેતી
જીરૂ એ શિયાળામાં ઉગાડવામાં આવતો અગત્યનો મસાલા પાક છે. દુનિયામાં ભારત ઉત્પાદન અને જીરૂના વપરાશમાં મોખરે છે. ગુજરાતમાં ૬૦% વિસ્તારમાં જીરાનું ઉત્પાદન કરવામાં આવે છે.…
પ્રધાનમંત્રીએ સુરત ખાતે શિલાન્યાસ કર્યો અને ₹3400 કરોડથી વધુના મૂલ્યના વિવિધ પ્રોજેક્ટનું સમર્પણ કર્યું
પ્રધાનમંત્રી શ્રી નરેન્દ્ર મોદીએ આજે સુરતમાં ₹3400 કરોડથી વધુના મૂલ્યના વિવિધ પ્રોજેક્ટનો શિલાન્યાસ કર્યો અને સમર્પિત કર્યો. પ્રધાનમંત્રીએ રોડ ઈન્ફ્રાસ્ટ્રક્ચર કામોના તબક્કા-1 અને ડાયમંડ રિસર્ચ…
FPO - એકમેકનો સાથ ખેડુતોનો વિકાસ
ઉત્પાદક સંગઠન એ ખેડુતો, દુધ ઉત્પાદકો, માછીમારો,વણકર, ગ્રામિણ કારીગરો વગેરે પ્રાથમિક ઉત્પાદકો દ્વારા સર્જિત કાયદેસર એકમ છે. ખેડૂત અથવા ખેડુત સંગઠનો દ્વારા સર્જિત ઉત્પાદક સંગઠનને…
મસાલા પાકોમાં કાપણી પછીનું વ્યવસ્થાપન અને મૂલ્ય વર્ધન
ભારત દેશ પ્રાચીન કાળથી ઉચ્ચ્તમ ગુણવત્તા ધરાવતા મસાલા પાકોના વાવેતર, ઉત્પાદન અને નિકાસમાં વિશ્ર્વમાં મોખરાનું સ્થાન ધરાવતો હોવાથી ભારતને ‘મસાલાનું ઘર’ તરીકે ઓળખવામાં આવે છે.…
જમીન સ્વાસ્થ્ય પત્રક
ખેતીમાં આધુનિક સંશોધનોની સાથે સાથે ખેડૂતો પાકની વધુ ઉત્પાદન આપતી નવી જાતોનું વાવેતર કરતા થયા છે. આ જાતો જમીનમાંથી પોષક તત્વોનો વધુ પ્રમાણમાં ઉપાડ કરી…
ઘાસચારાના પાકો માં વિષયુક્ત તત્વોને જાણો અને તમારા પશુને ભય મુક્ત રાખો
કેટલાક ઘાસચારાના પાકો માં જોવા મળતા ઝેરી તત્ત્વોની આડઅસરથી જાનવરો મૃત્યુ પામે છે।. અથવા તો મોટી બિમારીને નોંતરે છે. ઘાસચારાના પાકો માં રહેલા ઝેરી તત્વોને…
સરગવો- એક અદભુત છોડ
સરગવો અથવા ડ્રમસ્ટીક્સ અથવા મોરિંગા ઓલિફેરા એક મહત્વપૂર્ણ છોડ છે. તેના દરેક ભાગ (ફૂલ, પર્ણ, શીંગ અને દાંડી) ખોરાક માટે મૂલ્યવાન માનવામાં આવે છે, તેમાં…
કેન્દ્ર સરકારે પ્રધાનમંત્રી ગરીબ કલ્યાણ અન્ન યોજનાને વધુ ત્રણ મહિના માટે લંબાવી
એનએફએસએના તમામ લાભાર્થીઓ માટે દર મહિને વ્યક્તિદીઠ 5 કિલોના દરે નિઃશુલ્ક સારું અનાજ ડિસેમ્બર, 2022 સુધી ચાલુ રાખવામાં આવશે…
ભારતીય ખાતર કંપનીઓએ કેનપોટેક્સ, કેનેડા સાથે વૈશ્વિક સ્તરે સૌથી મોટા પોટાશ સપ્લાયર્સમાંના એક સાથે MOU પર હસ્તાક્ષર કર્યા
એક મહત્વપૂર્ણ પગલું; એમઓયુ પુરવઠા અને ભાવની અસ્થિરતા બંને ઘટાડશે અને ભારતમાં પોટાસિક ખાતરનો લાંબા ગાળાનો સ્થિર પુરવઠો સુનિશ્ચિત કરશે: ડૉ. મનસુખ માંડવિયા…
Dengue Alert: ડેન્ગ્યુના કેસોમાં આવી રહ્યો છે ઉછાળો, આ રીતે કરો પોતાનો બચાવો
તાજેતરના વરસાદને કારણે દેશના ઘણા ભાગોમાં ડેન્ગ્યુના કેસમાં વધારો જોવા મળ્યો છે. જાણો શું છે તેના લક્ષણો અને સારવાર...…
ભગતસિંહના જીવન સાથે જોડાયેલી અમુક રોચક વાતો
શહીદ ક્રાંતિકારી ભગતસિંહની આજે જન્મજયંતિ છે. ભગત સિંહની જન્મજયંતિના અવસર પર જાણીએ તેમના જીવન સાથે જોડાયેલી એવી રસપ્રદ વાતો, જે દરેક દેશ પ્રેમીએ જાણવી જોઈએ.…
Peanut Benefits: મગફળી ખાવાથી શરીરને કેટલો થશે ફાયદો? તેના ગુણ અને ખામીઓ જાણો
જો તમે રોજ મગફળીનું સેવન કરો છો, તો આ માહિતી તમારા માટે ખૂબ જ મહત્વપૂર્ણ છે, જેથી કરીને તમે તમારા શરીરની તંદુરસ્તી જાળવી શકો...…
Surgical Strike Day: રાતના અંધારામાં લખાઈ હતી નવા ભારતની પટકથા, 10 દિવસની અંદર સેનાએ લીધો હતો બદલો
28 સપ્ટેમ્બર 2016ની રાત્રે જ્યારે આખો દેશ શાંતિથી સૂતો હતો ત્યારે ભારતના વડાપ્રધાન નરેન્દ્ર મોદી અને કેટલાક ટોચના નેતાઓ નવા ભારતની પટકથા લખી રહ્યા હતા.…
PFI પર સરકારની મોટી કાર્યવાહી, 5 વર્ષનો પ્રતિબંધ
સરકારે PFI પર મોટી કાર્યવાહી કરી છે. સતત દરોડા પાડ્યા બાદ હવે ગૃહ મંત્રાલયે PFI અને તેની સાથે જોડાયેલી કંપનીઓ પર પાંચ વર્ષ માટે પ્રતિબંધ…
નિંદણને કમજોર કરવાની ભૂલ ક્યારેય ન કરશો
જીવાત, રોગો, નીંદણ માનવસમાજ ઊતર્યા તે પહેલાં પૃથ્વી પર અસ્તિત્વમાં હતા. પર્યાવરણ, હવામાન, પ્રકૃતિના અતિરેક સાથે લડીને, તેની હાજરીને હંમેશા કૃષિ માટે ગંભીર પડકાર બનાવે…
અમિત શાહે આજે ગુજરાતના કલોલમાં 150 બેડની ESIC હોસ્પિટલ અને ઉમિયા માતા કે.પી.નું ઉદ્ઘાટન કર્યું હતું, એજ્યુકેશનલ ટ્રસ્ટની 750 પથારીની આદર્શ મલ્ટીસ્પેશિયાલિટી હોસ્પિટલનો શિલાન્યાસ
પ્રધાનમંત્રી શ્રી નરેન્દ્ર મોદીજીએ દેશના દરેક વ્યક્તિને, ખાસ કરીને ગરીબોને સ્વાસ્થ્યનો સંપૂર્ણ અધિકાર આપવાનું કામ કર્યું છે…
કૃષિ જાગરણની અમુલ ડેરીના એમ.ડી અમિત વ્યાસ સાથે વાર્તાલાપ
કૃષિ જાગરણના વરિષ્ઠ પત્રકાર અંજલી ત્યાગીએ ગુજરાત અમુલ ડેરીના એમ.ડી અમિત વ્યાસ સાથે મુલાકાત કરી અને તેમની સાથે ઓર્ગેનિક ખેતી તેમજ અમુલના ઉત્પાદનો વિશે ચર્ચા…
પ્રધાનમંત્રી 29-30 સપ્ટેમ્બરે ગુજરાતની મુલાકાતે આવશે
પ્રધાનમંત્રી સુરત, ભાવનગર, અમદાવાદ અને અંબાજીના કાર્યક્રમોમાં આશરે રૂ. 29,000 કરોડની વિવિધ વિકાસ યોજનાઓનું ઉદ્ઘાટન અને શિલાન્યાસ કરશે…
શું ભારતમાં બટાટાના બીજની નિકાસ વધશે?
ભારતીય શાકભાજીમાં બટેટા એક એવું શાક છે, જેને કોઈપણ શાકભાજી સાથે મિક્સ કરીને બનાવી શકાય છે. તેથી તેનું ઉત્પાદન પણ ઘણું સારું છે, પરંતુ અફસોસની…
Ration Card: રેશનકાર્ડ ધારકોને લાગી લોટરી, ઓક્ટોબરથી મોદી સરકાર આપશે આ ખાસ સુવિધા!
જો તમારી પાસે રેશન કાર્ડ છે અને તમે પ્રધાનમંત્રી ગરીબ કલ્યાણ અન્ન યોજના (PMGKAY) હેઠળ મફત રાશન લઈ રહ્યા છો, તો આ સમાચાર તમારા કામના…
કેપ્સીકમને જીવાતો અને રોગથી બચાવો
આપણા દેશમાં ઉગાડવામાં આવતી શાકભાજીની વિવિધતાઓમાં, મરચાં અને કેપ્સિકમનો પાક અગ્રણી સ્થાન ધરાવે છે. પરંતુ મરચાં અને કેપ્સીકમની ઉત્પાદકતાનું સ્તર ઘણું ઓછું છે. તેમના ઉત્પાદનમાં…
દેશના છેવાડાના નાગરિકને સરકારી સેવાઓ પહોંચાડવા માટે ડિજિટલ પ્લેટફોર્મ વિકસાવવા જોઈએઃ દેવુસિંહ ચૌહાણ
મંત્રીએ કોમન વેલ્થ ટેલિકોમ ઓર્ગેનાઈઝેશન (CTO)ના પ્રતિનિધિઓને ડિજિટલ ભેદભાવને દૂર કરવા માટે ભારતની સર્વશ્રેષ્ઠ ડિજિટલ કુશળતાઓને વૈશ્વિક હિત અર્થે અપનાવવા આમંત્રિત કર્યા…
અમિત શાહે ગઈ કાલે ગુજરાતના અમદાવાદમાં કિસાન સંમેલનનુ સંબોધન કર્યું
પ્રધાનમંત્રી નરેન્દ્ર મોદીએ દાયકાઓથી પડતર નર્મદા યોજનાને પૂર્ણ કરી ગુજરાતમાં કચ્છ સુધી નર્મદાનું પાણી પહોંચાડવાનું ભગીરથ કાર્ય કર્યું છે…
JALDOOT એપનું રાષ્ટ્રીય લોન્ચ
ગ્રામીણ વિકાસ મંત્રાલયે ગામડામાં પસંદ કરેલા કૂવાના પાણીના સ્તરને કેપ્ચર કરવા માટે સમગ્ર દેશમાં ઉપયોગમાં લેવા માટે "જલદૂત એપ્લિકેશન" વિકસાવી છે…
અમિત શાહે આજે ગુજરાતના સાણંદમાં 350 પથારીવાળી ESIC હોસ્પિટલનું ભૂમિપૂજન કર્યું હતું
અમિત શાહે સાયન્સ સિટી નજીક અમદાવાદ અર્બન ડેવલપમેન્ટ ઓથોરિટી દ્વારા બનાવવામાં આવેલ ભાડજ ઓવરબ્રિજ અને વિરોચનનગર પ્રાથમિક આરોગ્ય કેન્દ્ર અને AUDA દ્વારા બનાવવામાં આવેલ મિલન…
264 વર્ષ પહેલા પ્લાસીના યુદ્ધ પછી શરૂ થઈ હતી બંગાળમાં પ્રથમ દુર્ગા પૂજા
બંગાળમાં 260 વર્ષ પહેલાં દેશભરમાં નવરાત્રિના દિવસોમાં મંડપ અને પંડાલોમાં ભવ્ય રીતે દુર્ગા પૂજાની ઉજવણી શરૂ થઈ હતી. તેના પોતાના કારણો હતા, પરંતુ સ્વતંત્રતા સંગ્રામના…
Business Idea: આ શાકભાજીની કિંમત છે 1200-1300 રૂપિયા પ્રતિ કિલો, ઘરે બેઠા બની જશો કરોડપતિ, આ રીતે કરો શરૂઆત
જો તમે ઓછા પૈસાનું રોકાણ કરીને મોટી કમાણી કરવા માંગો છો તો આજે અમે તમને એવો બિઝનેસ શરૂ કરવાનો આઈડિયા આપવા જઈ રહ્યા છીએ જેનાથી…
ચોળીની વૈજ્ઞાનિક ખેતી પધ્ધતિ
દેશની કૃષિમાં ધાન્ય પાકો પછીના ક્રમે કઠોળ પાકો અત્યંત મહત્વનું સ્થાન ધરાવે છે. કઠોળ આપણા દૈનિક ખોરાકનો ખૂબજ મહત્વનો ભાગ છે. ચોળી એ અગત્યનો કઠોળ…
Gopal Ratna Award 2022: પશુપાલન કરનારા ખેડૂતો જીતી શકે છે 5 લાખ સુધીનું ઈનામ, જાણો કેવી રીતે
પશુપાલનના વ્યવસાયમાં આવનાર ખેડૂતોને કેન્દ્ર સરકાર દ્વારા દર વર્ષે ગોપાલ રત્ન એવોર્ડ આપવામાં આવે છે. તેનો હેતુ વધુમાં વધુ ખેડૂતોને પશુપાલન તરફ આકર્ષવાનો છે.…
આ ફળોના બીજ 'ઝેર' કરતાં પણ વધુ ખતરનાક છે, તેને ભૂલથી પણ ખાશો નહીં
આપણે જે ફળો ખાઈએ છીએ તેના બીજ ઝેર સાથે કામ કરતા નથી. આજે આપણે જાણીએ કે કયા ફળોના બીજ ઝેર સાથે કામ કરતા નથી. જેનું…
કુનો નેશનલ પાર્કમાં લોકો ચિત્તાને ક્યારે જોઈ શકશે? પીએમ મોદીએ જણાવ્યું
વડાપ્રધાન નરેન્દ્ર મોદીના 'મન કી બાત'નો 93મો એપિસોડ ખાસ હતો. તેમણે રવિવારે કહ્યું કે જો તમે ચિત્તા સંબંધિત સ્પર્ધા જીતી જાઓ છો, તો કદાચ તમને…
PFI પર મોદી સરકાર ટૂંક સમયમાં મૂકશે પ્રતિબંધ! NIAને મળ્યા મજબૂત પુરાવા
PFI વિરુદ્ધ NIA અને ED દ્વારા તાજેતરમાં પાડવામાં આવેલા દરોડામાં ઘણા ખુલાસા થયા છે. એવું કહેવામાં આવી રહ્યું છે કે ગૃહ મંત્રાલય ટૂંક સમયમાં PFI…
ચંદીગઢ એરપોર્ટનું નામ હવે શહીદ ભગત સિંહના નામ પર રાખવામાં આવશેઃ પીએમ
વડાપ્રધાન મોદીએ આજે જાહેરાત કરી છે કે ચંદીગઢ એરપોર્ટનું નામ હવે ભગતસિંહના નામ પર રાખવામાં આવશે. તેમણે 'મન કી બાત' કાર્યક્રમમાં આની જાહેરાત કરી હતી.…
Mustard Cultivation: સરસવની ખેતીમાં વધુ ઉત્પાદન મેળવવાની કેટલીક સરળ રીતો
રવી સિઝન થોડા દિવસોમાં શરૂ થવાની છે અને સરસવ એ રવિ સિઝનના મુખ્ય પાકોમાંનો એક છે. તેથી, આજના કૃષિ જાગરણના આ લેખમાં, અમે સરસવની ખેતી…
રણ તીડનું જીવન ચક્ર અને તેની ઓળખ
માદા રેતાળ / રણ પ્રદેશની જમીનમાં ૫ થી ૧૨ સેન્ટિમીટર નીચે ૨ થી ૪ વખત ૬૦ થી ૨૦૦ ઈંડા મૂકે છે. ઈંડામાંથી ૧૦ - ૧૨…
તલ: સ્વાસ્થ્ય અને મુલ્યવર્ધન માટેનો ઉત્તમ પાક
તલ વિશ્વમાં એક મહત્વપૂર્ણ અને સૌથી જૂના ઉગાડવામાં આવતા તેલીબિયાં પાકોમાંથી એક છે અને તેને ‘તેલીબિયાં પાકોની રાણી’ તરીકે ઓળખવામાં આવે છે. દુનિયામાં તલના કુલ…
એમેઝોન ભારતમાં 3 સોલાર ફાર્મ અને 23 સોલાર રૂફટોપ પ્રોજેક્ટ સ્થાપશે
એમેઝોન ભારતમાં નવા સોલાર ફાર્મ અને રૂફટોપ સ્થાપશે જે વાર્ષિક 1.07 મિલિયન મેગાવોટ કલાક (1,076,000 મેગાવોટ) રિન્યુએબલ એનર્જી પેદા કરી શકે છે.…
ચોખા-ઘઉં-લોટના ભાવમાં 20%નો વધારો, હવે ઈંડા, દૂધ અને માંસના ભાવ પહોંચશે આસમાને
લોકો પર વધતા રાશનનો બોજ ઘટાડવા માટે સરકારે એક મહત્વપૂર્ણ પગલું ભર્યું છે. જે અંતર્ગત રાશનની વસ્તુઓની વધતી કિંમતોને નિયંત્રિત કરી શકાશે.…
તુલસીની ખેતી, તુલસીની ખેતીથી કમાઓ લાખો રૂપિયા, જાણો કેવી રીતે ખેતી કરી શકાય છે
તુલસીની ખેતી ખેડૂતોમાં ચર્ચાનો વિષય છે. તુલસીની ખેતી કેવી રીતે કરવી? તેની ખેતી માટે કયા પ્રકારનું વાતાવરણ જોઈએ, જમીન અને તાપમાન જરૂરી છે. આ વિશે…
1 ઓક્ટોબરથી શરૂ થશે દેશમાં 5G સેવાઓ, PM મોદી ઈન્ડિયા મોબાઈલ કોંગ્રેસમાં કરશે લોન્ચ
દેશમાં 5જી સેવાઓ 1 ઓક્ટોબરથી શરૂ થવા જઈ રહી છે. વડાપ્રધાન નરેન્દ્ર મોદી 1 ઓક્ટોબરે ઈન્ડિયા મોબાઈલ કોંગ્રેસમાં 5G સેવાઓ લોન્ચ કરશે. લોન્ચ થયા બાદ…
બેંકિંગ અને તમારાથી સંબંધિત આ નિયમો 1 ઓક્ટોબરથી બદલાશે, જરૂરી કામકાજ કરી લો નહીંતર થઈ શકે છે નુકસાન
સપ્ટેમ્બર મહિનો પૂરો થવામાં હવે એક સપ્તાહ કરતાં પણ ઓછો સમય બાકી છે. આ સાથે, આવતા મહિને 1 ઓક્ટોબરથી, બેંક સાથે સંબંધિત ઘણા નિયમો દિવસેને…
ડૉ.મનસુખ માંડવિયા આયુષ્માન ભારત-PMJAYના 4 વર્ષ અને આયુષ્માન ભારત ડિજિટલ મિશનના 1 વર્ષ નિમિત્તે આરોગ્ય મંથન 2022નું ઉદ્ઘાટન કરશે
આયુષ્માન ભારત પ્રધાન મંત્રી – જન આરોગ્ય યોજના (AB PM-JAY) ના અમલીકરણના ચાર વર્ષની ઉજવણી અને આયુષ્માન ભારત ડિજિટલ મિશન (ABDM)ના અમલીકરણના એક વર્ષની ઉજવણી…
Changes on 500 RS Note: 500 રૂપિયાની નોટમાં થશે ફેરફાર! આ કારણે RBI લઈ શકે છે મોટો નિર્ણય
નવી દિલ્હી: 500 RSની નોટમાં ફેરફાર મોદી સરકારના પ્રથમ કાર્યકાળ દરમિયાન નોટબંધીએ ભલભલા લોકોને બેંકની સામે લાઈનમાં ઉભા કરી દીધા હતા. ત્યારપછી સોશિયલ મીડિયા પર…
Rain Alert: દિલ્હીમાં યલો એલર્ટ જારી, ક્યાંક પડી રહ્યા છે પહાડો તો ક્યાંક વરસાદે તોડી નાખ્યા તમામ રેકોર્ડ
વરસાદને કારણે દેશમાં કેટલીક જગ્યાએ પર જળબંબાકારની સ્થિતિ સર્જાઈ રહી છે, જ્યારે કેટલીક જગ્યાએ ભૂસ્ખલનને કારણે રસ્તાઓ પરની અવરજવર બંધ થઈ ગઈ છે. જાણો આજની…
પાકની વૃદ્ધિ અને ઉપજ પર આર્બસ્ક્યુલર માયકોરિઝા ફૂગની અસર
માયકોરિઝાલ ફૂગ છોડની મૂળ પ્રણાલીને વસાહત બનાવે છે અને "માયકોરિઝા" તરીકે ઓળખાતા સહજીવનનો વિકાસ કરે છે. તેઓ સૂક્ષ્મ તંતુઓનું નેટવર્ક બનાવે છે જે છોડના મૂળ…
ગાજરની વૈજ્ઞાનિક પદ્ધતિથી ખેતી કરો અને મેળવો વિપુલ આવક
ગુજરાતમાં ઉગાડવામાં આવતા વિવિધ શાકભાજી પાકોમાં મૂળ વર્ગના શાકભાજી પાકોમા ગાજર, મૂળા અને બીટ આગવું સ્થાન ધરાવે છે. ગુજરાત રાજ્યમાં ગાજરનું વાવેતર વિશેષ કરીને પાટણ…
નીંદણ વ્યવસ્થાપનની વિવિધ પધતિઓ
ખેતી ની શરૂઆત થઈ ત્યારથી ખેડૂતોને મુઝવતો નીંદણનો પ્રશ્ન માત્ર ખેડૂતોનોજ પ્રશ્ન ન રહેતા માનવ સમાજનો પ્રશ્ન બની ગયેલ છે. જેવા કે માનવ જાતની તંદુરસ્તી…
આંબળાની ખેતી, ખેડૂતો માટે ખોલશે સમૃદ્ધિના દ્વાર
આમળાની ખેતી એગ્રો ફોરેસ્ટ્રીના સ્વરૂપમાં કરવામાં આવી રહી છે, આમળાના ફળનું અથાણું, જેલી, મુરબ્બો અને આયુર્વેદિક દવાઓમાં વિશેષ મહત્વ ધરાવે છે. તાજેતરના સંશોધનમાં સામે આવ્યું…
વૈજ્ઞાનિક પદ્ધતિથી પશુપાલનનો વ્યવસાય કરીને ચોખ્ખી આવકમાં વધારો મેળવો
આધુનિક વૈજ્ઞાનિક પધ્ધતિથી પશુપાલનના પૂરક ઉધોગને વિકસાવી રાષ્ટ્રમાં શ્વેતક્રાંતિ લાવવા હજુ ઘણું બધું કરવાનું બાકી છે.…
કપાસના બિયારણનું સંકટ હવે ખતમ થઈ જશે, ભારતમાં પ્રથમ વખત ઓર્ગેનિક કપાસની વૈવિદ્યતા તૈયાર કરાઈ
ભારતમાં સૌ પ્રથમ વખત ઓર્ગેનિક કપાસની વૈવિદ્યતને તૈયાર કરવામાં આવી છે. તેને લીધે કપાસ માટે જૈવિક બિયારણ મળવું હવે સરળ બની જશે.…
આ વર્ષે ચોખાના ઉત્પાદનમાં ઘટાડો થવાની સંભાવના
કૃષિ મંત્રાલય દ્વારા વર્ષ 2022-23 માટે મુખ્ય ખરીફ પાકોના ઉત્પાદનના પ્રથમ આગોતરો અંદાજો જાહેર કરવામાં આવ્યા છે. વર્ષ 2022-23 દરમિયાન ખરીફ ચોખાનું કુલ ઉત્પાદન 104.99…
કારેલાની ખેતીથી ખેડૂતોને મળશે સારો નફો, જાણો અહીંની પદ્ધતિ?
ભારતમાં કારેલાની ખેતી શાકભાજી તરીકે થાય છે. કારેલાની ખેતી ભારતના લગભગ તમામ રાજ્યોના ખેડૂતો કરે છે. ભારતીય ખેડૂતો વર્ષમાં બે વાર કારેલાનો પાક લે છે.…
OBC ક્વોટા મુદ્દે ગુજરાત વિધાનસભામાં કોંગ્રેસના ધારાસભ્યોએ મચાવ્યો હંગામો, સસ્પેન્ડ; પ્લેકાર્ડ પ્રદર્શિત કરીને સૂત્રોચ્ચાર
સ્પીકર નીમાબેન આચાર્યએ ઠાકોરની માંગ ન સ્વીકારતા જીગ્નેશ મેવાણી સ્પીકર પોડિયમ તરફ દોડ્યા હતા. કોંગ્રેસના અન્ય નવ ધારાસભ્યોને એક દિવસ માટે ગૃહમાંથી સસ્પેન્ડ કરવામાં આવ્યા…
Gujarat Election 2022: ભારે વિરોધ બાદ ગુજરાત સરકારે પાછું ખેંચ્યું પશુ નિયંત્રણ બિલ
આ બિલમાં શહેરી વિસ્તારોમાં લાયસન્સ આપવા, શહેરી વિસ્તારોમાં ખરીદી, વેચાણ પર પ્રતિબંધ વગેરેનો પ્રસ્તાવ હતો. માર્ચમાં બજેટ સત્રના છેલ્લા દિવસે છ કલાકની મેરેથોન ચર્ચા બાદ…
ફળો, શાકભાજી, ઔષધીય છોડ અને જડીબુટ્ટીઓની સરળ અને સસ્તી ઍક્સેસ પ્રદાન કરવા માટે પોષણ વાટિકસ અથવા પોષક બગીચાઓ દેશભરમાં સ્થાપિત કરવામાં આવી રહ્યા છે
ચાલી રહેલ પોષણ માહ 2022 હેઠળ, પોષણ-બગીચા અથવા રેટ્રો-ફિટિંગ પોષણ વાટિકાઓની સ્થાપના માટેની પ્રવૃત્તિઓ દેશભરમાં મોટા પાયે હાથ ધરવામાં આવી રહી છે…
દિવાળી પહેલા ખેડૂતોને મળી મોટી ભેટ, ખેતી કરવા માટે સરકાર આપશે 35,250 રૂપિયા
Diwali Subsidy on Magahi Betel Cultivation: હવે થોડા જ દિવસોમાં દિવાળીનો તહેવાર આવવાનો છે, જેના કારણે સરકારે ખેડૂતોને ભેટ આપવાની તૈયારીઓ શરૂ કરી દીધી છે.…
ડીએપી (DAP)અને યુરિયા ખાતરનો ઉપયોગ કરવાની નવી રીત, ખેતરોમાં લહેરાવા લાગશે પાક
કૃષિ જાગરણના આ લેખમાં, ખેડૂતોને ડીએપી અને યુરિયા ખાતરનો યોગ્ય રીતે ઉપયોગ કરવા માટે માહિતી આપવામાં આવી છે, જેથી તમે પાકની વધુ ઉપજ મેળવી શકો.…
વેગન ફૂડ કેટેગરી હેઠળ પ્લાન્ટ આધારિત માંસ ઉત્પાદનોનો પ્રથમ માલ ગુજરાતમાંથી યુએસએમાં નિકાસ કરવામાં આવ્યો
કેન્દ્ર ઓસ્ટ્રેલિયા, ઇઝરાયેલ અને ન્યુઝીલેન્ડમાં વેગન ફૂડ ઉત્પાદનોની નિકાસને વેગ આપવાની યોજના ધરાવે છે…
PM Kisan Scheme:રાહ જોવાના દિવસો પુરા થવા આવ્યા, આ દિવસે 12મા હપ્તાના પૈસા આવી શકે છે
જો તમારું નામ પણ પીએમ કિસાન સન્માન નિધિના લાભાર્થીઓની યાદીમાં છે, તો આ સમાચાર તમારા માટે છે.…
પ્રધાનમંત્રીના પસંદગીના ભાષણોના સંગ્રહ - "સબકા સાથ સબકા વિકાસ સબકા વિશ્વાસ" નું વિમોચન
"સબકા સાથ સબકા વિકાસ સબકા વિશ્વાસ - પ્રધાનમંત્રી નરેન્દ્ર મોદી બોલે છે (મે 2019 - મે 2020)", ભારતના પ્રધાનમંત્રી શ્રી નરેન્દ્ર મોદીના પસંદગીના ભાષણોના સંગ્રહનું…
ખેતીવાડીનું સફળ ભવિષ્ય : એગ્રી–કલીનીક
એગ્રી–કલીનીક એવા કેન્દ્ર છે જયાં કૃષિ સલાહકાર દ્વારા ખેડૂતોને જૈવિક ખેતી સંબંધિત માહિતી અને સલાહ દેવામાં આવે છે તેમજ, કૃષિ ને લગતી સમસ્યાઓના સમાધાન કરવામાં…
બાજરીની ખેતી: આ ટકાઉ પાક કેવી રીતે ઉગાડવો
બાજરી એ અત્યંત અંડરરેટેડ છતાં પણ સરળતાથી ઉગાડવામાં આવતો ટકાઉ પાક છે જે કોઈપણ શુષ્ક જમીન માટે યોગ્ય છે. તેઓ અત્યંત નાના-બીજવાળા ઘાસનો સમૂહ છે…
શોધતી આંખો, થોડું આશ્ચર્ય, થોડા અસ્વસ્થ… પિંજરામાંથી બહાર નીકળ્યા પછી ચિત્તાનાં એ પ્રથમ પગલાં
પ્રાણીઓની પણ પોતાની અલગ દુનિયા હોય છે. તેમની દુનિયા તેમનું જંગલ છે. લોકોએ કોંક્રિટના જંગલો બનાવ્યા અને તેમની દુનિયા બરબાદ થવા લાગી. જ્યારે તેમને સંતાવા…
રાષ્ટ્રપતિ દૌપદી મુર્મુ જશે બ્રિટન, રાણીના અંતિમ સંસ્કારમાં આપશે હાજરી
બ્રિટનની મહારાણી એલિઝાબેથ દ્વિતીયના નિધન બાદ દેશ-વિદેશના અનેક ટોચના નેતાઓ તેમના અંતિમ સંસ્કારમાં હાજરી આપે તેવી શક્યતા છે.…
800 કરોડનું ડેરી કૌભાંડ: ગુજરાતના પૂર્વ ગૃહમંત્રી વિપુલ ચૌધરીને 7 દિવસની પોલીસ કસ્ટડીમાં મોકલવામાં આવ્યો
ચૌધરીની સાથે કોર્ટે તેના ચાર્ટર્ડ એકાઉન્ટન્ટ શૈલેષ પરીખને પણ એક સપ્તાહ માટે એસીબીની કસ્ટડીમાં મોકલી આપ્યો હતો. ચૌધરી ગુજરાત કોઓપરેટિવ મિલ્ક માર્કેટિંગ ફેડરેશન (GCMMF) ના…
નામિબિયાથી લાવવામાં આવેલા ચિત્તાઓ માટે કુનો પાર્ક જ શા માટે પસંદ કરવામાં આવ્યો? જાણો તેની વિશેષતા
નામિબિયાથી આઠ ચિત્તાઓને લઈને એક વિશેષ વિમાન ગ્વાલિયર પહોંચ્યું છે. ત્યાંથી તેમને મધ્યપ્રદેશ કુનો પાલપુર નેશનલ પાર્કમાં લઈ જવામાં આવશે, જે 748 ચોરસ કિલોમીટરમાં ફેલાયેલો…
KRITAGYA 3.0- ICAR દ્વારા પાક સુધારણા પર રાષ્ટ્રીય સ્તરની હેકાથોન
ભારતીય કૃષિ અનુસંધાન પરિષદ તેના રાષ્ટ્રીય કૃષિ ઉચ્ચ શિક્ષણ પ્રોજેક્ટ અને પાક વિજ્ઞાન વિભાગ સાથે 'પાક સુધારણા માટે ઝડપ સંવર્ધન'ને પ્રોત્સાહન આપવા માટે હેકાથોન 3.0…
અળસીયું એટલે ખેડૂતનું કુદરતી હળ
ચોમાસાની ઋતુ શરૂ થઇ ગઇ છે ત્યારે આજે આપણે વાત કરવી છે ખુબ જ અગત્યના વિષય એવા અળસીયા પર. ચારેકોર પ્રાકૃતિક ખેતિ, રસાયણમુક્ત ખેતી,ઝેરમુક્ત ખેતિની…
વર્ષ 2047 સુધીમાં ભારતને વિકસિત રાષ્ટ્ર બનાવવામાં બૅન્કિંગ ક્ષેત્રએ મોટું યોગદાન આપવું પડશે: ઈન્ડિયન બૅન્ક્સ એસોસિએશનની 75મી એજીએમમાં કેન્દ્રીય નાણાં મંત્રી શ્રીમતી નિર્મલા સીતારમણ
કેન્દ્રીય નાણાં મંત્રીએ બૅન્કોને આગામી 25 વર્ષ માટે ડિજિટલ, આધુનિક ટેકનોલોજીઝ અને એકબીજા સાથે વાત કરતી અવિરત સિસ્ટમ્સ અપનાવવા માટે યોજના બનાવવા પ્રોત્સાહિત કરી…
KJ Chaupal માં આજે વિદેશી સેલિબ્રિટીઓએ હાજરી આપી, ડેરી ઉદ્યોગનું જણાવ્યું મહત્વ
KJ ચૌપાલનું ફરી એકવાર કૃષિ જાગરણ મીડિયા ઓફિસ ખાતે આયોજન કરવામાં આવ્યું હતું, જેમાં ઇન્ટરનેશનલ ડેરી કન્સોર્ટિયમ (યુએસએ)ના કોમ્યુનિકેશન મેનેજર સેબેસ્ટિયન ડેટ અને માસ્ટર ન્યુટ્રિશનિસ્ટ…
IFAJ પ્રમુખ લેના જોન્સન કેજે ચૌપાલનો ભાગ બની
આજનો દિવસ કૃષિ જાગરણ માટે એક સ્વપ્ન સાકાર થવા જેવો હતો. જ્યારે AJAY ની અધિકૃત વેબસાઈટનું ઉદ્ઘાટન IFAJ પ્રમુખ લેના જ્હોન્સન દ્વારા લોન્ચ ઈવેન્ટમાં ઓનલાઈન…
પશુઓમાં સંતુલિત આહાર અને તેની જરૂરિયાત શું છે તે જાણો
પ્રાચીન કાળથી એક કહેવત પ્રચલિત છે કે શરીર અને મન એટલે કે આપણા શરીરની વૃદ્ધિ અને ઘડતરમાં ખોરાકનું વિશેષ મહત્વ છે. આ સિદ્ધાંત પ્રાણીઓને પણ…
કચરામુક્ત શહેરોને સમર્થન આપવા માટે ભારતીય સ્વચ્છતા લીગમાં લાખો યુવાનો સાથે જાણીતી હસ્તીઓ જોડાશે
શંકર મહાદેવન, વેંકટેશ ઐયર, બી પ્રાક, જીવ મિલ્ખા સિંઘ, કિરણ ખેર દરિયાકિનારા, ટેકરીઓ અને પ્રવાસન સ્થળોને સાફ કરવા માટે ભારતની પ્રથમ યુવા આગેવાની હેઠળની આંતર-શહેર…
DEFEXPO-2022 માટે પૂરજોશમાં તૈયારીઓ
ભારતનું મુખ્ય સંરક્ષણ પ્રદર્શન ગાંધીનગર, ગુજરાત ખાતે 18 થી 22 ઓક્ટોબર 2022 દરમિયાન યોજાશે…
માટી પરીક્ષણ શા માટે જરૂરી છે, જાણો માટીના નમૂના લેતી વખતે શું ધ્યાનમાં રાખવું
આપણા દેશની સતત વધતી જતી વસ્તી જોતા એવું લાગે છે કે અનાજની માંગ પૂરી કરવી એ એક મોટો પડકાર બની રહ્યો છે.ઉત્પાદનનું પ્રમાણ વધારવા માટે…
મગમાં આવતી જીવાતો અને તેનું સંકલિત રીતે નિયંત્રણ કરવું
આપણો દેશ એક કૃષિ પ્રધાન દેશ છે અને રાજ્યના મોટાભાગના લોકો શાકાહારી છે. તેમના દૈનિક ખોરાકમાં મુખ્યત્વે શર્કરાયુક્ત પદાર્થો હોય છે જેથી ખોરાકમાં પ્રોટીનની ઉણપને…
અમિત શાહની અધ્યક્ષતામાં ગઈ કાલે નવી દિલ્હીમાં ભારત સરકાર, આસામ સરકાર અને આઠ આદિવાસી જૂથોના પ્રતિનિધિઓ વચ્ચે ઐતિહાસિક સમજૂતી પર હસ્તાક્ષર કરવામાં આવ્યા
આસામમાં આદિવાસીઓ અને ચાના બગીચાના કામદારોની દાયકાઓ જૂની કટોકટીનો અંત લાવવા માટે આ કરાર પર હસ્તાક્ષર કરવામાં આવ્યા…
દેશના બીજા સૌથી મોટા ડેમમાં પાણી સંપૂર્ણ જળસ્તરને સ્પર્શી ગયું, ભરાયું138.6 મીટર
ભારતનો બીજો સૌથી મોટો ડેમ 'સરદાર સરોવર ડેમ' હવે સંપૂર્ણ રીતે ભરાઈ ગયો છે. ડેમની જળ સપાટી તેની પૂર્ણ સપાટી (138.68 મીટર) પર પહોંચી ગઈ…
ભારતને તેલ વેચનારા દેશોમાં સાઉદી અરેબિયા નીકળ્યું રશિયાથી આગળ
ભારતે રશિયા પાસેથી તેલની આયાત વધારી હતી, પરંતુ ત્રણ મહિના પછી સાઉદી અરેબિયાએ ફરી એકવાર રશિયાને પાછળ છોડી દીધું છે. હવે ભારત ઈરાક પછી સૌથી…
સ્વરાજ એવોર્ડ્સની ચોથી આવૃત્તિમાં સ્વરાજ ટ્રેક્ટર્સે ભારતીય કૃષિના હીરોની કરી ઉજવણી
મહિન્દ્રા ગ્રૂપનો ભાગ અને અગ્રણી ભારતીય ટ્રેક્ટર બ્રાન્ડ સ્વરાજ ટ્રેક્ટર્સે ગઈ કાલે નવી દિલ્હીમાં આયોજિત એગ્રીકલ્ચર કોન્ક્લેવમાં સ્વરાજ એવોર્ડ 2022ની ચોથી આવૃત્તિનું આયોજન કર્યું હતું.…
કારેલા માં રોગ જીવાત નિયંત્રણ
કારેલાનો પાક ભારતમાં વિસ્તૃત રીતે થાય છે. ગુજરાતમાં પણ ઘણા ખેડૂતોએ મહંદઅંશે આ પાક અપનાવેલ છે. કારેલા ખાસ કરીને ઉનાળામાં તેમજ ચોમાસામાં એમ બંને ઋતુમાં…
અમિત શાહે ગઈ કાલે ગુજરાતના સુરત ખાતે કૃષક ભારતી કોઓપરેટિવ લિમિટેડના બાયો-ઇથેનોલ પ્રોજેક્ટ- કૃભકો હજીરાનું શિલારોપણ કર્યું અને સહકારિતા સંમેલનને સંબોધન કર્યું
કૃભકોનો બાયો-ઇથેનોલ પ્રોજેક્ટ સહકારી ક્ષેત્ર, પર્યાવરણીય સુધારા, ખેડૂતોની આવક બમણી કરવા, ભારતનાં વિદેશી વિનિમય ભંડારને વધારવા અને ગ્લોબલ વોર્મિંગના પડકારને પહોંચી વળવા પ્રધાનમંત્રી શ્રી નરેન્દ્ર…
PM Kisan Yojana : ખેડૂતોની રાહ પૂરી થઈ, આ તારીખ સુધીમાં મેળવી શકશો 12મા હપ્તાના પૈસા, જાણો કેવી રીતે કરશો ચેક
પ્રધાનમંત્રી કિસાન નિધિ યોજના દેશના ખેડૂતોને ફાયદો પહોંચાડવા માટે સરકારની સૌથી મહત્વકાંક્ષી યોજના છે. પીએમ મોદી ટૂંક સમયમાં આ યોજના હેઠળ 12મો હપ્તો જાહેર કરશે.…
ખાદીને પ્રોત્સાહન આપવા પ્રતિબદ્ધ KVIC અધ્યક્ષે ગુજરાતમાં ખાદી સંસ્થાઓની મુલાકાત લીધી
ખાદી અને ગ્રામોદ્યોગ કમિશનના અધ્યક્ષ શ્રી મનોજ કુમારે 11મી સપ્ટેમ્બર 2022ના રોજ કોચરબ આશ્રમ, ગુજરાત, અમદાવાદ ખાતે ખાદી સંસ્થાઓ અને તેમના કારીગરો માટે વિકાસલક્ષી ભાવિ…
મધમાખીપાલન-રોજગારી માટે ઉજળી છે તક
ખેતી સાથે સંકળાયેલા યુવાન અથવા લઘુ ઉદ્યોગ દ્વારા રોજગારી મેળવવા માટે મધુપાલન ખુબજ સારો વ્યવસાય છે. જેમાં ઓછા ખર્ચે વધુ ઉત્પાદન મેળવી શકાય છે.જેમાં મધ…
પાકની વૃદ્ધિ અને ઉપજ પર આર્બસ્ક્યુલર માયકોરિઝા ફૂગની અસર
માયકોરિઝાલ ફૂગ છોડની મૂળ પ્રણાલીને વસાહત બનાવે છે અને "માયકોરિઝા" તરીકે ઓળખાતા સહજીવનનો વિકાસ કરે છે. તેઓ સૂક્ષ્મ તંતુઓનું નેટવર્ક બનાવે છે જે છોડના મૂળ…
વર્ટિકલ ફાર્મિંગ: 21મી સદી માટે નવો કૃષિ અભિગમ
2050 સુધીમાં વિશ્વની વસ્તી અંદાજિત 9 અબજ સુધી પહોંચવાની આગાહી છે અને શહેરો કુલ વસ્તીના લગભગ 80 ટકા હોસ્ટ કરશે. વર્ટિકલ ફાર્મિં એ ઊભી સ્ટૅક્ડ…
સૂર્યશક્તિનો ઉપયોગ કરો અને આત્મ નિર્ભરતા તરફ એક ડગલું આગળ વધો, સોલપ પંપથી શરૂઆત કરો
આપણો દેશ કૃષિપ્રધાન દેશ છે, આપણા દેશમાં સૂર્યશક્તિ પૂરતા પ્રમાણમાં ઉપલબ્ધ છે તો આપણે તેનો લાભ લેવો જોઈએ, સોલાર શક્તિ માંથી પુનઃપ્રાપ્ય ઉર્જા ઉત્પન્ન કરી…
પંચાયતી રાજ મંત્રાલય અને ગ્રામીણ વ્યવસ્થાપન સંસ્થા આણંદ (IRMA), ગુજરાત આજે આણંદ ખાતે એમઓયુ પર હસ્તાક્ષર કરશે
એમઓયુનો હેતુ સમગ્ર દેશમાં પંચાયતી રાજ સંસ્થાઓ (PRIs)ની ક્ષમતા નિર્માણને મજબૂત કરવાનો છે.IRMA ટકાઉ વિકાસ લક્ષ્યોના સ્થાનિકીકરણ અને PRI સંબંધિત અન્ય બાબતોમાં નીતિગત હસ્તક્ષેપ માટે…
World Dairy Summit: PM મોદીએ વર્લ્ડ ડેરી કોન્ફરન્સનું કર્યું ઉદ્ઘાટન, કહ્યું- 70 લાખ ખેડૂતોને થશે ફાયદો
વડા પ્રધાન નરેન્દ્ર મોદીએ ૧૨ સપ્ટેમ્બરના રોજ દિલ્હીને અડીને આવેલા ગ્રેટર નોઈડામાં વર્લ્ડ ડેરી કોન્ફરન્સનું ઉદ્ઘાટન કર્યું હતું અને ગ્રામીણ અર્થતંત્ર - લોકોની આજીવિકાના સંબંધમાં…
અમિત શાહે ગઈ કાલે ગુજરાતના મુખ્યમંત્રી ભૂપેન્દ્ર પટેલના કાર્યકાળનાં એક વર્ષ સફળતાપૂર્વક પૂર્ણ થવાંનાં ઉપલક્ષ્યમાં વીડિયો કોન્ફરન્સિંગ દ્વારા વિવિધ વિકાસલક્ષી યોજનાઓનું ઉદ્ઘાટન અને શિલાન્યાસ કર્યો
વિશ્વાસ સે વિકાસ કાર્યક્રમ પ્રસંગે આશરે 1180 કરોડનાં 519 કામોનું ઉદઘાટન અને લોકાર્પણ થયું છે જે ગુજરાતના વિકાસની કદી ન અટકનારી યાત્રાનો એક મહત્વપૂર્ણ પડાવ…
મુખ્યમંત્રી યુવા સ્વાવલંબન યોજના: ગુજરાત સરકારના કારણે યુવાનોનું સુધરી રહ્યું છે ભાવિ
ગાંધીનગરઃ ગુજરાત સરકાર યુવાનો માટે અનેક કલ્યાણકારી અને શિષ્યવૃત્તિ યોજનાઓ ચલાવી રહી છે. તેનો હેતુ એ છે કે જો આર્થિક રીતે નબળા માતા-પિતાના બાળકો સારું…
અનિલ અગ્રવાલની કંપની વેદાંતા ગુજરાતમાં 1,54,000 કરોડનું રોકાણ કરશે, લાખો લોકોને મળશે નોકરી
વેદાંતા લિમિટેડ અને ઇલેક્ટ્રોનિક્સ મેન્યુફેક્ચરિંગ જાયન્ટ ફોક્સકોને ગુજરાતમાં સેમિકન્ડક્ટર પ્રોજેક્ટ અને ડિસ્પ્લે FAB મેન્યુફેક્ચરિંગ યુનિટ સ્થાપવા માટે ગુજરાત સરકાર સાથે સમજૂતી કરાર (એમઓયુ) પર હસ્તાક્ષર…
યુરિયાની કાર્યક્ષમતા વધારે: નીમ લીપીત યુરિયા
અનાજની જરૂરિયાતને પહોંચી વળવા ઉત્પાદન અનેક ગણું વધારવાની જરૂર છે. સેંદ્રીય ખાતરો ઉપરાંત જમીનની પ્રત, પાક, પિયત વ્યવસ્થા તથા જમીન અને પાણી પૃથ્થકરણના તારણો આધારિત…
કેન્દ્ર દ્વારા રાજ્ય સરકારોને ફોર્ટિફાઇડ ચોખાના ફાયદાઓ વિશે જાગૃતિ વર્કશોપનું આયોજન કરવા નિર્દેશ
ગુજરાત સરકારે ચોખાના ફોર્ટિફિકેશનની સકારાત્મક અસર અને યોજનાઓ અને દેશની પોષણ સુરક્ષા વ્યૂહરચનામાં તેના નોંધપાત્ર યોગદાન પર વર્કશોપનું આયોજન કર્યું હતું…
ગુજરાતના રાજ્યપાલે કેન્દ્રીય મંત્રી ડૉ. જિતેન્દ્ર સિંહ સાથે તેમની એગ્રીટેકની નવીનતાઓ શેર કરી
ડૉ. જિતેન્દ્ર સિંહે ભારતમાં એગ્રી-ટેક સ્ટાર્ટ-અપ્સને મોટા પાયે પ્રોત્સાહન આપવાની રીતો પર ચર્ચા કરી, જે ભારતના ભાવિ અર્થતંત્ર માટે નિર્ણાયક છે…
ખાદી ઈન્ડિયા દ્વારા NIFT (નેશનલ ઈન્સ્ટિટ્યૂટ ઓફ ફેશન ટેકનોલોજી) ગાંધીનગર ખાતે એક પ્રદર્શન અને ફેશન શો 'અહેલી ખાદી'નું આયોજન કરવામાં આવ્યું
ખાદી અને ગ્રામોદ્યોગ આયોગનો મુખ્ય ઉદ્દેશ્ય પ્રધાનમંત્રી શ્રી નરેન્દ્ર મોદીના ખાદીને ફેશન ફેબ્રિક તરીકે સ્થાપિત કરવાના આહ્વાનને સાકાર કરવાનો છે.…
કેન્દ્ર સરકારના શિપીંગ-પોર્ટસ-વોટર વેઝ મંત્રાલય-ગુજરાત મેરિટાઇમ બોર્ડ-ફિક્કી દ્વારા સહઆયોજિત ઇન્ટરનેશનલ સેમિનાર ઓન શિપ રિસાયક્લિંગ એન્ડ વ્હીકલ સ્ક્રેપ પોલિસીનો ગાંધીનગરમાં પ્રારંભ
પ્રધાનમંત્રી શ્રી નરેન્દ્ર મોદીના વિઝનરી નેતૃત્વ અને માર્ગદર્શન હેઠળ ભારતે વિશ્વમાં આગવી ઓળખ ઉભી કરી છે ત્યારે આપણે સૌ દેશવાસીઓ ટીમ ઈન્ડીયા બનીને સહિયારા પ્રયાસો…
ખેડૂત ઉત્પાદક સંગઠન (FPO) – એક ઉભરતી તક
પ્રોડ્યુસર ઓર્ગેનાઈઝેશન (PO) એ પ્રાથમિક ઉત્પાદકો દ્વારા રચાયેલી કાનૂની સંસ્થા છે, જેમ કે. ખેડૂતો, દૂધ ઉત્પાદકો, માછીમારો, વણકર, ગ્રામીણ કારીગરો, કારીગરો. PO એ ઉત્પાદક કંપની,…
વધતા ભાવો પર આવશે અંકુશ, સરકાર બફર સ્ટોકથી 50 હજાર ટન ડુંગળી બજારમાં ઉતારશે
કેન્દ્ર સરકારે ડુંગળીના વધતા ભાવને રોકવા માટે બફર સ્ટોકનો અમુક હિસ્સો બજારમાં લાવવાનો નિર્ણય કર્યો છે. ઘણા મોટા શહેરોમાં ડુંગળીના ભાવ ધીમે ધીમે વધી રહ્યા…
સેલવાસ ખાતે પ્રેસ ઇન્ફોર્મેશન બ્યુરો દ્વારા ‘વાર્તાલાપ’- રૂરલ મીડિયા વર્કશૉપ યોજાયો
કેન્દ્ર સરકારના માહિતી અને પ્રસારણ મંત્રાલયના પીઆઇબી-પ્રેસ ઇન્ફોર્મેશન બ્યૂરો, અમદાવાદ દ્વારા કેન્દ્ર શાસિત પ્રદેશ સેલવાસ ખાતે રૂરલ મીડિયા વર્કશૉપ-વાર્તાલાપનું આયોજન કરવામાં આવ્યું હતું, જેમાં વિષય…
કૃષિમાં જાહેર-ખાનગી ભાગીદારીને પ્રોત્સાહન આપવા માટે કેન્દ્રીય કૃષિ મંત્રાલય અને FICCI વચ્ચે PMU શરૂ કરવામાં આવ્યું
કેન્દ્રીય કૃષિ અને ખેડૂત કલ્યાણ મંત્રાલય અને ફેડરેશન ઓફ ઈન્ડિયન ચેમ્બર્સ ઓફ કોમર્સ એન્ડ ઈન્ડસ્ટ્રી (FICCI) વચ્ચે કૃષિમાં જાહેર-ખાનગી ભાગીદારીને પ્રોત્સાહન આપવા માટે સંયુક્ત પહેલ…
કપાસને કીટકોથી બચાવો અને મગફળીને રોગથી બચાવો
તે ફંગલ રોગ છે. જો કે, આ ફૂગ મુખ્યત્વે નવજાત છોડમના મૂળમાં સડો રોગ ફેલાવે છે. સ્કૉર્ચ રોગના લક્ષણો સૌપ્રથમ પાંદડા પર ભૂરા અને અનિશ્ચિત…
ગુણોનો ભંડાર : દૂધી
દૂધી એક હળવા સ્વાદવાળી, કુકરબીટાસી કુટુંબની શાકભાજી છે. દૂધી વિશ્વના ઘણા ઉષ્ણકટિબંધીય અને સમશીતોષ્ણ વિસ્તારોમાં ઊગાડવામાં આવતી એક મહત્વની શાકભાજી છે. દૂધીનુ વનસ્પતિ નામ લગેનારીયા…
Prasar Bharati Recruitment 2022: પ્રસાર ભારતીમાં સરકારી નોકરી કરવાની તક, 30 સપ્ટેમ્બર પહેલા કરો અરજી
Media Jobs: જો તમે મીડિયા સેક્ટરમાં સારી નોકરી શોધી રહ્યા છો, તો આજે અમે તમારા માટે એક સારા સમાચાર લઈને આવ્યા છીએ. ખરેખર, પ્રસાર ભારતીએ…
PM Kisan Samman Nidhi:12મા હપ્તાને લગતા નવીનતમ અપડેટ્સ જાણો, આ ખાતાઓમાં નહીં આવે પૈસા
પીએમ કિસાન સન્માન નિધિ યોજનાના લાભાર્થીઓ 12મા હપ્તાની રાહ જોઈ રહ્યા છે. ટૂંક સમયમાં કેન્દ્રની મોદી સરકાર ખેડૂતોના ખાતામાં પીએમ કિસાન યોજનાનો 12મો હપ્તો જાહેર…
પ્રધાનમંત્રી આજે નેતાજી સુભાષચંદ્ર બોઝની 28 ફૂટની પ્રતિમાનું અનાવરણ કરશે
નવી દિલ્હી ખાતે ઇન્ડિયા ગેટ નજીક 8 સપ્ટેમ્બર 2022ના રોજ પ્રધાનમંત્રી શ્રી નરેન્દ્ર મોદી દ્વારા નેતાજી સુભાષ ચંદ્ર બોઝની ભવ્ય પ્રતિમાનું અનાવરણ કરવામાં આવશે.…
દિલ્હીના રાજપથનું બદલ્યું નામ, NDMCએ કર્તવ્ય પથ પર આપી મંજુરી
હવે દિલ્હીવાસીઓ માટે વધુ એક નવી ભેટ આવી છે. હવે રાષ્ટ્રીય રાજધાની દિલ્હીમાં રાષ્ટ્રપતિ ભવનથી ઈન્ડિયા ગેટ સુધીનો રસ્તો હવે કર્તવ્ય પથ તરીકે ઓળખાશે.…
ડૉ મનસુખ માંડવિયાએ સિલ્ચરમાં CGHS વેલનેસ સેન્ટરનું ઉદ્ઘાટન કર્યું
"નવું CGHS કેન્દ્ર સિલચર અને તેની આસપાસની મોટી વસતીને ગુણવત્તાયુક્ત આરોગ્યસંભાળ પ્રદાન કરશે"…
કેન્દ્રીય ગૃહ અને સહકારિતા મંત્રી શ્રી અમિત શાહ 8 સપ્ટેમ્બર 2022ના રોજ નવી દિલ્હી ખાતે યોજનારી રાજ્યોના સહકારી મંત્રીઓની બે દિવસીય રાષ્ટ્રીય પરિષદનું ઉદ્ઘાટન કરશે
પ્રધાનમંત્રી શ્રી નરેન્દ્ર મોદી ‘સહકાર સે સમૃદ્ધિ’ની તેમની પરિકલ્પના દ્વારા સહકારિતા સાથે સંકળાયેલા લોકોના જીવનમાં સકારાત્મક પરિવર્તન લાવવા માટે પ્રતિબદ્ધ છે…
પ્રધાનમંત્રી કુસુમ યોજના
પ્રધાનમંત્રી કુસુમ યોજના એટલે કે પ્રધાનમંત્રી કિસાન ઉર્જા સુરક્ષા એવમ્ ઉત્થાન મહાભિયાન યોજનાની જાહેરાત ભારત સરકાર દ્વારા સામાન્ય બજેટ ૨૦૧૮ - ૨૦૧૯ માં કરવામાં આવી…
બાગાયતી સહાય યોજનાઓ નવા બગીચા (ફળો)ની સ્થાપના માટેની યોજના તથા સુગંધિત અને ઔષધીય પાકોની ખેતી
ગુજરાત સરકારે ખેડૂતો માટે વિવિધ બાગાયત યોજનાઓ હેઠળ વિકાસ કર્યો છે બાગાયત નિર્દેશાલય, કૃષિ ભવન, ગાંધીનગર. I – Khedut પોર્ટલે ખેડૂતોને જાગૃત કરવામાં…
બાગાયતી સહાય યોજનાઓ નવા બગીચા (ફળો)ની સ્થાપના માટેની યોજના તથા સુગંધિત અને ઔષધીય પાકોની ખેતી
ગુજરાત સરકારે ખેડૂતો માટે વિવિધ બાગાયત યોજનાઓ હેઠળ વિકાસ કર્યો છે બાગાયત નિર્દેશાલય, કૃષિ ભવન, ગાંધીનગર. I – Khedut પોર્ટલે ખેડૂતોને જાગૃત કરવામાં…
“એગ્રીવોલ્ટેઈક સીસ્ટમ: ખેડૂતોની આવક બમણી કરવાનો નવીનતમ ઉપાય”
ભારતમાં ગ્રામીણ વિસ્તારમાં મુખ્ય આવક ખેતીમાંથી થાય છે પરંતુ ગ્રામીણ લોકોના વિકાસ માટે માત્ર ખાદ્યપદાર્થોનું ઉત્પાદન જ પૂરતું નથી. ખાદ્યપદાર્થો પછી હવે પછીની જરૂરિયાત ગ્રામીણ…
પાકિસ્તાનના ખેડૂતોએ કહ્યું- દેશમાં પૂરની સ્થિતિને લીધે 50 વર્ષ પાછા પડી ગયા
પાકિસ્તાનના સિંધ પ્રાંતના ખેડૂત અશરફ અલી ભામ્બરુ કહે છે, "અમે 50 વર્ષ પાછળ ગયા છીએ. સિંધમાં 2,500 એકર કપાસ અને શેરડી તૈયાર હતી, પરંતુ પૂર…
કેળાની ખેતીમાં સારું ઉત્પાદન પ્રાપ્ત કરવા આ ઉપાયોને અપનાવો
કેળ એક એવો છોડ છે કે જે ઘણા બધા પોષક તત્વોનો ઉપયોગ કરે છે અને આ પોષક તત્વો પર સકારાત્મક અસર છોડે છે. કુલ પાક…
“કૃષિ કચરામાંથી ઉત્પન્ન કરો ઉર્જા અને મેળવો વધારાની આવક”
દેશના મોટાભાગના લોકો કૃષિ જોડે સંકળાયેલા છે. દેશમાં જુદી જુદી આબોહવાને લીધે વિવિધ પાકોનું વાવેતર થાય છે. જેના પરિણામે મોટા પ્રમાણમાં કૃષિ કચરો મળે છે…
“ બાયોચાર: જમીનની ટકાઉપણું, દૂષણ નિયંત્રણ અને કૃષિ ઉત્પાદન માટેનો કાળો હીરો”
કૃષિ કચરામાંથી બાયોચરનું ઉત્પાદન કચરાના જથ્થા અને વજનમાં નોંધપાત્ર ઘટાડો કરે છે, અને તેથી, તેને કૃષિ કચરાનું સંચાલન કરવા માટેનું એક આશાસ્પદ માધ્યમ ગણી શકાય.…
કૃષિ કચરામાંથી ઉર્જા ઉત્પાદન: ખેડૂતોની આવકમાં વધારો કરતુ નવું માધ્યમ
આપનો દેશ કૃષિ પ્રધાન દેશ છે. દેશના મોટાભાગના લોકો કૃષિ જોડે સંકળાયેલા છે. દેશમાં જુદી-જુદી આબોહવાને કારણે વિવિધ પાકોનું વાવેતર થાય છે.જેના પરિણામે મોટા પ્રમાણમાં…
"ખેડૂતો: સોલાર ડ્રાયર દ્વારા પોતાની કૃષિ પેદાશો જાતે સૂકવો અને મેળવો ડબલ આવક"
પ્રાચીન સમયથી સૂર્યને ઉર્જાનો સ્ત્રોત માનવામાં આવે છે જેનો ઉપયોગ કૃષિ પેદાશો અને ઔષધીય છોડને સૂકવવા માટે થાય છે. પરંતુ, ખુલ્લા મેદાનોમાં સુકવણી કરવાના કેટલાક…
" ખેડૂતો :ગોબર-ધન યોજના દ્વારા ઢોરના કચરા અને અન્ય કાર્બનિક કચરાનું સલામત વ્યવસ્થાપન કરી મેળવો વધુ આવક"
સ્વચ્છ ભારત મિશન (ગ્રામીણ) (SMB-G) હેઠળ ગ્રામીણ સ્વચ્છતા પર સકારાત્મક અસર કરવા અને પશુઓ અને જૈવિક કચરામાંથી સંપત્તિ અને ઊર્જા ઉત્પન્ન કરવા માટે બાયોડિગ્રેડેબલ વેસ્ટ…
આધુનિક પદ્ધતિ અપનાવીને કરો સ્ટ્રોબેરીની ખેતી;ઓછા ખર્ચ, વધુ ઉત્પાદન અને ઉંચી વેચાણ કિંમત જેવા અનેક લાભ મળશે
સ્ટ્રોબેરી એક એવું ફળ છે જેનાથી આપણે બધા સારી રીતે પરિચિત છીએ. સ્ટ્રોબેરીમાં ઘણા જરૂરી પોષક તત્વો હોય છે જે આપણા સ્વાસ્થ્ય માટે જરૂરી છે.…
ભારતના બાહ્ય ઋણ 2021-22 પર સ્ટેટસ રિપોર્ટની 28મી આવૃત્તિ બહાર પાડવામાં આવી
નાણાં મંત્રાલયના આર્થિક બાબતોના વિભાગમાં એક્સટર્નલ ડેટ મેનેજમેન્ટ યુનિટ (EDMU) એ ભારતના બાહ્ય દેવા 2021-22 પર સ્ટેટસ રિપોર્ટની 28મી આવૃત્તિ બહાર પાડી છે.…
"ખેડૂતો: સપ્ટેમ્બરમાં આ પાકો વાવો અને વધુ આવક મેળવો"
કોબીની ખેતી માટે યોગ્ય સમય સપ્ટેમ્બરથી ઓક્ટોબર છે પરંતુ નવેમ્બરમાં પણ તેની ખેતી કરી શકાય છે. સામાન્ય રીતે કોબીના પાકનો સમયગાળો 60-120 દિવસનો હોય છે.…
મોબાઇલ કવરેજ અને ગુણવત્તા તપાસવા અને સુધારવા માટે ગુજરાત LSA, DoT દ્વારા વડોદરા શહેરમાં ડ્રાઇવ ટેસ્ટ
મોબાઈલ ટેલિકોમ્યુનિકેશન સેવાઓ દેશના વિકાસના મુખ્ય સમર્થક તરીકે ઉભરી આવી છે અને તે નાગરિકોના રોજિંદા જીવનનો આંતરિક ભાગ બની ગઈ છે.…
ભારતની સૌથી મોટી એગ્રીમીડિયા કૃષિ જાગરણની 26મી વર્ષગાંઠની ઉજવણી..
ભારત એક કૃષિ પ્રધાન દેશ છે અને દેશની લગભગ 70 ટકા વસ્તી કૃષિ અને કૃષિ સંબંધિત ક્ષેત્રો પર નિર્ભર છે, કૃષિ એ ભારતની કરોડરજ્જુ છે…
મોડેલ વિલેજ: ગુજરાતના ગાંધીનગરમાં દહેગામનું લવાડ ગામ રાષ્ટ્રીય રક્ષા યુનિવર્સિટીના વિઝન હેઠળ
રાષ્ટ્રીય રક્ષા યુનિવર્સિટીના વિસ્તરણ અને ડિસ્ટન્સ લર્નિંગ નિદેશાલય દ્વારા રાષ્ટ્રીય રક્ષા યુનિવર્સિટીના વાઇસ ચાન્સેલર પ્રો. (ડૉ) બિમલ એન. પટેલના દૂરંદેશી નેતૃત્વ હેઠળ યુનિવર્સિટીની સામાજિક જવાબદારીના…
લમ્પી વાયરસ પ્રાણીઓમાં દૂધ ઉત્પાદન ઘટાડી શકે છે; લક્ષણો જાણો
લમ્પી વાયરસ સમગ્ર ભારતમાં ઝડપથી ફેલાઈ રહ્યો છે. તેની દૂધ ઉત્પાદન ઉપર માઠી અસર થઈ શકે છે.…
અમદાવાદમાં ટૂંક સમયમાં વિશ્વનું સૌથી મોટું સ્પોર્ટ્સ સિટી બનશે, ગૃહમંત્રી શ્રી અમિત શાહે 36મી નેશનલ ગેમ્સના લોકાર્પણ સમારોહમાં જાહેરાત કરી
કેન્દ્રીય ગૃહ મંત્રી શ્રી અમિત શાહે અમદાવાદના EKA એરેના, ટ્રાન્સસ્ટેડિયા ખાતે 36મી નેશનલ ગેમ્સ માટે એન્થમ અને માસ્કોટનું અનાવરણ કર્યું હતું. ગુજરાતના સીએમ શ્રી ભૂપેન્દ્ર…
લીંબડામાંથી તમારા ઘરે તૈયાર કરો જંતુનાશકો, આ માટે સરળ પદ્ધતિને જાણો
જો તમે સંપૂર્ણ માળી અથવા ખેડૂત હોવ તો પણ, તમે સમયાંતરે તમારા છોડ પર હુમલો કરતા જીવાતો અને નાના જંતુઓનો સામનો કરવો પડતો હશે. ઘણી…
સૂર્યમુખીની ખેતી: 90 દિવસમાં સૂરજમુખીની ખેતી દ્વારા મેળવો અનેક લાભ
ફૂલો મોટાભાગના લોકોને પસંદ હોય છે. તેઓ લગ્નોથી લઈને લગ્નો સુધીના વિવિધ પ્રસંગોમાં તેનો ઉપયોગ કરતા હોય છે. આ સંજોગોમાં ખેડૂતો માટે ફ્લોરીકલ્ચર ખૂબ જ…
આદુ પાવડરનો છંટકાવ, આદુ પાવડર કેવી રીતે તૈયાર કરવો તેની સમગ્ર પ્રક્રિયાને જાણો
દેશના શહેરી વિસ્તારોમાં લોકો તેમના ઘરની છત અને બાલ્કનીમાં ગાર્ડનિંગ કરે છે, જે તેમના ઘરની સુંદરતામાં વધારો કરે છે, પરંતુ તેઓ ફળો, શાકભાજી જેવા ઓર્ગેનિક…
ટાટા સન્સના ભૂતપૂર્વ ચેરમેન સાયરસ મિસ્ત્રીનું રોડ અકસ્માતમાં મોત
ટાટા સન્સના પૂર્વ ચેરમેન સાયરસ મિસ્ત્રીનું માર્ગ અકસ્માતમાં નિધન થયું છે. જણાવવામાં આવી રહ્યું છે કે આ અકસ્માત પાલઘર પાસે થયો હતો. અકસ્માત બાદ તેમને…
અમિત શાહે આજે અમદાવાદના કાંકરિયા ખાતે છઠ્ઠા અખિલ ભારતીય પ્રિઝન ડ્યૂટી સંમેલનનું ઉદ્ઘાટન કર્યું
શ્રી અમિત શાહે જણાવ્યું હતું કે, ગુજરાતમાં બીજી વખત આ સંમેલનનું આયોજન કરવામાં આવી રહ્યું છે અને આ પણ એક ખૂબ જ સંયોગની વાત છે…
પ્રસૂતિ બાદ માદા પશુની કેવી રીતે કાળજી રાખશો
ડિલિવરીના તબક્કા (1) પ્રથમ તબક્કામાં માદા પશુને 10-12 કલાક જેટલો સમય લાગે છે, આ તબક્કામાં શીશુની પ્રથમ પાણીની કોથળી કે જેને સામાન્ય ભાષામાં માતાડી કહે…
પૂરની ગંભીર સ્થિતિ વચ્ચે પાકિસ્તાન ભારતમાંથી ટામેટા અને ડુંગળીની આયાત કરી શકે છે
બજારના ડીલરોના જણાવ્યા પ્રમાણે પાકિસ્તાન ભીષણ પૂરની સ્થિતિને લીધે લાહોર અને પંજાબ પ્રાંતના અન્ય વિસ્તારોમાં ફળો અને શાકભાજીની કિંમતમાં નોંધપાત્ર વધારો થવાને કારણે પાકિસ્તાન સરકાર…
ભારતનુ એક રહસ્યમય ગામ, જ્યાં હજારો પક્ષીઓ કરવા આવે છે આત્મહત્યા
આસામના દિમા હાસો જિલ્લામાં સ્થિત જાતિંગા વૈલીમાં સપ્ટેમ્બર અને ડિસેમ્બર મહિના વચ્ચે એક ખતરનાક નજારો જોવા મળે છે. જેમાં ચારે બાજુ મૃત પક્ષીઓના શરીર પડેલા…
આ બિઝનેસ આઈડિયા સાથે ઘરે બેઠા 1 લાખ રૂપિયા કમાઈ શકો છો, વાંચો સંપૂર્ણ માહિતી
મોંઘવારીના આ સમયમાં દરેક વ્યક્તિ પોતાની આવક વધારવા માંગે છે. જે લોકો પોતાની આવક વધારવા માટે સારો બિઝનેસ શોધી રહ્યા છે, તો અમે તેમના માટે…
ઓછી ખર્ચાળ એવી પ્રાકૃતિક ખેતી શું છે તેના વિશેની સંપૂર્ણ માહિતી જાણો
ઝાડ-છોડની વૃધ્ધિ અને તેનું સારું ઉત્પાદન લેવા માટે જે જે સંશાધનોની જરૂરિયાત હોય છે. આ બધા સંસાધનો ઝાડ-છોડને ઉપલબ્ધ કરવા માટે પ્રકૃતિને મજબુર કરનાર પધ્ધતિને…
અળસીયું એટલે ખેડૂતનું કુદરતી હળ
ચોમાસાની ઋતુ શરૂ થઇ ગઇ છે ત્યારે આજે આપણે વાત કરવી છે ખુબ જ અગત્યના વિષય એવા અળસીયા પર. ચારેકોર પ્રાકૃતિક ખેતિ, રસાયણમુક્ત ખેતી,ઝેરમુક્ત ખેતિની…
ફ્રિજ વગર શાકભાજીને 15 દિવસ સુધી લીલી અને તાજી કેવી રીતે રાખવી
મોટાભાગના લોકો શાકભાજીને તાજી રાખવા માટે ફ્રીજનો ઉપયોગ કરે છે. પરંતુ તેઓ નથી જાણતા કે ફ્રિજ વગર પણ શાકભાજી તાજી રાખી શકાય છે. શાકભાજીને તાજા…
કેન્દ્રીય કૃષિ મંત્રી તોમરે ગુજરાતમાં નાળિયેર વિકાસ બોર્ડના રાજ્ય કેન્દ્રનું કર્યું ઉદ્ઘાટન
ભારતમાં વધી રહી છે નારિયેળની ખેતી,પ્રક્રિયા,બજાર અને નિકાસ - શ્રી તોમર જૂનાગઢમાં વિશ્વ નાળિયેર દિવસ સમારોહનો પ્રારંભ,નેશનલ એવોર્ડ અને એક્સપોર્ટ એક્સેલન્સ એવોર્ડની જાહેરાત…
સૂર્ય શક્તિનો ઊપયોગ કરો અને સોલાર વોટર પંપની મદદથી ખેતીવાડી કરો
આપણો દેશ કૃષિપ્રધાન દેશ છે, આપણા દેશમાં સૂર્યશક્તિ પૂરતા પ્રમાણમાં ઉપલબ્ધ છે તો આપણે તેનો લાભ લેવો જોઈએ, સોલાર શક્તિ માંથી પુનઃપ્રાપ્ય ઉર્જા ઉત્પન્ન કરી…
પાકની વૃદ્ધિ અને ઉપજ પર આર્બસ્ક્યુલર માયકોરિઝા ફૂગની અસર
માયકોરિઝાલ ફૂગ છોડની મૂળ પ્રણાલીને વસાહત બનાવે છે અને "માયકોરિઝા" તરીકે ઓળખાતા સહજીવનનો વિકાસ કરે છે. તેઓ સૂક્ષ્મ તંતુઓનું નેટવર્ક બનાવે છે જે છોડના મૂળ…
મગમાં આવતી જીવાતો અને તેનું સંકલિત વ્યવસ્થાપન
આપણો દેશ એક કૃષિ પ્રધાન દેશ છે અને રાજ્યના મોટાભાગના લોકો શાકાહારી છે. તેમના દૈનિક ખોરાકમાં મુખ્યત્વે શર્કરાયુક્ત પદાર્થો હોય છે જેથી ખોરાકમાં પ્રોટીનની ઉણપને…
કેન્દ્રીય ગૃહ અને સહકારિતા મંત્રી શ્રી અમિત શાહે આજે નવી દિલ્હી ખાતે CAPF eAwas વેબ પોર્ટલનો પ્રારંભ કર્યો
કેન્દ્રીય સશસ્ત્ર પોલીસ દળો હંમેશા દરેક પરિબળોમાં દેશની આંતરિક સુરક્ષાનો મજબૂત આધારસ્તંભ રહ્યા છે…
પાકિસ્તાનમાં 400ના ટામેટાં, શાકભાજીના ભાવ આસમાને, લોકો કરી રહ્યા છે ભારતથી મંગાવાની માંગ
પાકિસ્તાનમાં પૂરના કારણે સ્થિતિ ગંભીર છે. ઉભા પાકો નાશ પામવાને કારણે શાકભાજીથી લઈને અનાજની કટોકટી સર્જાઈ છે. અહીં વિનાશક પૂરના કારણે શાકભાજી અને ફળોના ભાવમાં…
ચોમાસા દરમિયાન આ રીતે કરો હળદરમાં નીંદણ વ્યવસ્થાપન
ચોમાસાના મહિનાઓમાં નીંદણનું જોખમ સૌથી વધુ હોય છે. તે જમીનમાં હાજર નાઈટ્રોજનનો ઉપયોગ કરે છે, જેના કારણે પાકમાં નાઈટ્રોજનની ઉણપ જોવા મળે છે.…
ગ્રાન્ટ ઇન એઇડ કર્ણાટક, ત્રિપુરા, ઉત્તર પ્રદેશ, આંધ્રપ્રદેશ અને ગુજરાતની ગ્રામીણ સ્થાનિક સંસ્થાઓને રૂ. 4,189.58 કરોડ જારી કર્યા
રૂ. 15,705.65ની કુલ ગ્રાન્ટ 2022-23માં અત્યાર સુધીમાં ગ્રામીણ સ્થાનિક સંસ્થાઓને કરોડ રૂપિયા જારી કરવામાં આવ્યા…
નરેન્દ્ર મોદી 10 સપ્ટેમ્બર 2022ના રોજ અમદાવાદમાં સાયન્સ સિટી ખાતે રાજ્ય S&T મંત્રી પરિષદનું ઉદ્ઘાટન કરશે
કેન્દ્રીય મંત્રી ડૉ. જીતેન્દ્ર સિંહે અહીં એક ઉચ્ચ-સ્તરીય સમીક્ષા બેઠકની અધ્યક્ષતા કરતા કહ્યું કે, પરિષદનો ઉદ્દેશ્ય કેન્દ્ર અને રાજ્યો વચ્ચે વધુ તાલમેલ દ્વારા રાષ્ટ્રીય વિજ્ઞાન,…
મહિલા અને બાળ વિકાસ મંત્રાલય 5મો રાષ્ટ્રીય પોષણ મહિનો 2022 ઉજવશે
"મહિલા અને આરોગ્ય" અને "બાળ અને શિક્ષણ" પર ધ્યાન કેન્દ્રીત કરીને પોષણ માહ માટે ગ્રામ પંચાયતોને સક્રિય કરવી - સશક્ત મહિલા, સાક્ષર બાળક, સ્વસ્થ ભારત…
ઓગસ્ટ 2022ના મહિનામાં ₹1,43,612 કરોડની કુલ GST આવક એકત્રિત થઈ
ઑગસ્ટ 2022 મહિનાની આવક 2021માં સમાન મહિનાની GST આવક કરતાં 28% વધુ છે. સળંગ છ મહિના માટે માસિક GSTની આવક ₹1.4 લાખ કરોડ કરતાં વધુ…
સંકલિત ખેતી મોડલ ! ખેડૂતોની આવક વધારવા મળશે મદદ
દેશના વિકાસ અને પ્રગતિમાં કૃષિ અને તેને સંલગન પ્રવૃતિઓનો નોંધપાત્ર ફાળો રહ્યો છે. અંદાજે ૫૩% લોકોને કૃષિક્ષેત્રે રોજગારી પૂરૂં પાડતું હોવાથી ગ્રામ્ય પ્રજા માટે તે…
“વન હર્બ, વન સ્ટાન્ડર્ડ” ના પ્રમોશન અને સુવિધા માટે આંતર-મંત્રાલય સહયોગ માટે PCIM&H અને IPC વચ્ચે એમઓયુ પર હસ્તાક્ષર થયા
ધોરણોનો સુમેળ "વન હર્બ, વન સ્ટાન્ડર્ડ એન્ડ વન નેશન" તરફ દોરી જશે અને ભારતમાં વ્યવસાય કરવાની સરળતામાં સુધારો કરશે…
EAC-PM એ ભારત@100 માટે સ્પર્ધાત્મકતાનો રોડમેપ જાહેર કર્યો
ઇકોનોમિક એડવાઇઝરી કાઉન્સિલ દ્વારા આજે પ્રધાનમંત્રી (EAC-PM) માટે ભારતનો સ્પર્ધાત્મકતા રોડમેપ @100 બહાર પાડવામાં આવ્યો હતો. રોડમેપ, જે ભારત સ્પર્ધાત્મકતા પહેલનો એક ભાગ છે,…
અફઘાનિસ્તાનમાં 40 હજાર મેટ્રિક ટન ઘઉં મોકલવામાં આવ્યા, ગુરુદ્વારા પરના હુમલા ચિંતાજનકઃ UNSCમાં બોલ્યુ ભારત
સંયુક્ત રાષ્ટ્ર સુરક્ષા પરિષદ (UNSC)માં ભારતના સ્થાયી પ્રતિનિધિ રૂચિરા કંબોજે દેશ દ્વારા આપવામાં આવતી મદદનો ઉલ્લેખ કર્યો. તેમણે કહ્યું કે ભારતે અત્યાર સુધીમાં લગભગ 40,000…
નેશનલ પેન્શન સ્કીમ સહિત ઘણા નિયમોમાં1 સપ્ટેમ્બરથી થશે ફેરફાર, લોકોના જીવનને કરશે અસર
1 સપ્ટેમ્બરથી આવા ઘણા નિયમોમાં ફેરફાર થવા જઈ રહ્યા છે, જેની લોકોના જીવન પર ઊંડી અસર પડશે. આની સૌથી સામાન્ય વીમા કંપની સાથે સંકળાયેલા એજન્ટ…
રેલવે ટિકિટની દલાલીના જોખમ સામે કાર્યવાહી
વેસ્ટર્ન રેલવેની RPF ટીમ રેલવે ટિકિટના ગેરકાયદે ધંધામાં સંડોવાયેલા ટાઉટ્સ પર આક્રમક કાર્યવાહી કરી રૂ. 43 લાખથી વધુની ભાવિ ટિકિટો સાથે 6 લોકોની ધરપકડ…
ગાંધીનગરના કલોલ તાલુકાના વડસર ગામમાં રૂ. 6 કરોડના ખર્ચે નવીનીકરણ થનાર તળાવના કામનું ખાતમુહૂર્ત કેન્દ્રીય ગૃહ તથા સહકારિતા મંત્રી શ્રી અમિતભાઇ શાહના હસ્તે કરાયું
આપણા પૂર્વજોએ તળાવ બનાવ્યા છે, જેની સાચવણી કરવાની જવાબદારી આપણા સૌની છેઃ કેન્દ્રીય ગૃહ મંત્રી શ્રી અમિતભાઇ શાહ…
Gujarat SET 2022: ગુજરાત રાજ્ય પાત્રતા પરીક્ષા માટે નોંધણી શરૂ, જાણો અરજી પ્રક્રિયા
રસ ધરાવતા અને લાયક ઉમેદવારો અધિકૃત વેબસાઇટ gujaratset.ac.in ની મુલાકાત લઈને ગુજરાત રાજ્ય પાત્રતા કસોટી માટે અરજી કરી શકે છે. પરીક્ષા માટે નોંધણી કરવાની છેલ્લી…
કેન્દ્રીય ગૃહ અને સહકારિતા મંત્રી શ્રી અમિત શાહે ગઈકાલે ગુજરાતના ગાંધીનગરમાં નેશનલ ફોરેન્સિક સાયન્સ યુનિવર્સિટી (એનએફએસયુ)નાં પ્રથમ પદવીદાન સમારંભને સંબોધન કર્યું હતું તેમજ એનએફએસયુ પરિસરમાં વિવિધ સુવિધાઓનું ઉદઘાટન પણ કર્યું
વિદ્યાર્થીઓ વિશ્વની પ્રથમ ફોરેન્સિક સાયન્સ યુનિવર્સિટીમાંથી ડિગ્રી લઈને સમાજમાં જઈ રહ્યા છે ત્યારે તેમનાં જીવનમાં ગઈ કાલનો એટલે કે (28 ઓગષ્ટ)નો દિવસ ખૂબ જ મહત્વનો…
Nitin Gadkari on EV: કેન્દ્રીય મંત્રી ગડકરીએ કરી આવી જાહેરાત, કાર-બાઈક સવારો થઈ ગયા ખુશ
જો તમે કાર અથવા બાઇક લેવાનું વિચારી રહ્યા છો, તો આ સમાચાર તમને રાહત આપવાના છે. કેન્દ્રીય માર્ગ પરિવહન અને રાજમાર્ગ મંત્રી નીતિન ગડકરીએ એક…
ભાવનગરના આંગણે યોજાયો 'વતનના વિસરાયેલા વીરોની વાત અંગેનો અદભૂત કાર્યક્રમ ‘વીરાંજલિ’
વીરાંજલિ એ પાળિયાને પોંખવાનો અને તેને પુનઃ પ્રસ્થાપિત કરવાનો અવસર છેઃ મત્સ્યોદ્યોગ, પશુપાલન અને ડેરી વિભાગના કેન્દ્રીય મંત્રીશ્રી પરશોત્તમભાઈ રૂપાલા…
પ્રધાનમંત્રી 27-28 ઓગસ્ટે ગુજરાતની મુલાકાતે
પ્રધાનમંત્રી ભુજમાં સ્મૃતિ વન સ્મારકનું ઉદ્ઘાટન કરશે - 2001ના વિનાશક ભૂકંપ પછી દર્શાવવામાં આવેલી લોકોની સ્થિતિસ્થાપકતાની ભાવનાની ઉજવણી કરવા માટેની એક પ્રકારની પહેલ છે…
નેશનલ ઇન્સ્ટિટ્યૂટ ઓફ ફેશન ટેક્નોલોજી (NIFT) દમણની 18મી શાખા શરૂ થઈ
નેશનલ ઇન્સ્ટિટ્યૂટ ઓફ ફેશન ટેકનોલોજી (NIFT) એ દમણ ખાતે એક શાખા શરૂ કરી છે. દેશભરમાં NIFT સંસ્થાની આ 18મી શાખા છે. NIFT દમણ દ્વારા ગયા…
કેબિનેટે ઘઉં અથવા મેસ્લિન લોટ માટે નિકાસ નીતિને મંજૂરી આપી
પ્રધાનમંત્રી શ્રી નરેન્દ્ર મોદીની અધ્યક્ષતા હેઠળની આર્થિક બાબતોની કેબિનેટ સમિતિએ ઘઉં અથવા મેસ્લિન લોટ (HS કોડ 1101) માટે નિકાસ પ્રતિબંધો/પ્રતિબંધમાંથી મુક્તિની નીતિમાં સુધારાની દરખાસ્તને મંજૂરી…
ડિજિટલ ઇન્ડિયાની પહેલે ભારતને ટેક આયાતકારમાંથી ટેક ઉત્પાદક બનાવી દીધું છેઃ કેન્દ્રીય રાજ્યમંત્રી ચંદ્રશેખર
કેન્દ્રીય ઇલેક્ટ્રોનિક્સ અને આઇટી તથા કૌશલ્ય વિકાસ અને ઉદ્યોગ સાહસિકતા રાજ્ય મંત્રી શ્રી રાજીવ ચંદ્રશેખરે આજે જણાવ્યું હતું કે, દેશમાં ઇલેક્ટ્રોનિક ક્ષેત્રએ છેલ્લાં થોડાં વર્ષોમાં…
પ્રધાનમંત્રી શ્રી 25મી ઓગસ્ટે સ્માર્ટ ઈન્ડિયા હેકાથોન 2022ના ગ્રાન્ડ ફિનાલેને સંબોધિત કરશે
સમગ્ર 75 કેન્દ્રોમાંથી 15,000થી વધુ વિદ્યાર્થીઓ ગ્રાન્ડ ફિનાલેમાં ભાગ લેશે 2900થી વધુ શાળાઓ અને 2200 ઉચ્ચ શિક્ષણ સંસ્થાઓના વિદ્યાર્થીઓ અંતિમ તબક્કામાં 53 કેન્દ્રીય મંત્રાલયોમાંથી 476…
Ambedkar Awas Yojana: ગુજરાતમાં દલિતોને મળી રહ્યું છે પોતાનું ઘર, હજારો પરિવારોનું બદલાઈ ગયું જીવન
ગાંધીનગર: પોતાનું ઘર એ દરેક વ્યક્તિનું સપનુ હોય છે. પરંતુ, પરિવારની દરેક જવાબદારી નિભાવ્યા પછી દરેક વ્યક્તિ માટે આ સપનું સાકાર કરવું શક્ય નથી હોતું.…
Business Idea: માત્ર 5,000 રૂપિયાનું રોકાણ કરીને રૂમમાં શરૂ કરો આ બિઝનેસ, 10 ગણી વધુ થશે કમાણી
દેશના વડાપ્રધાન નરેન્દ્ર મોદી હંમેશા ખેડૂતોને ખેતી માટે નવી ટેકનોલોજીનો ઉપયોગ કરવાની સલાહ આપે છે. પીએમ મોદી હંમેશા આત્મનિર્ભર બનવાની વાત કરે છે.…
આરઆરયુએ સંરક્ષણ મંત્રાલયના અધિકારીઓ માટે તાલીમ અભ્યાસક્રમ યોજ્યો
રાષ્ટ્રીય રક્ષા યુનિવર્સિટીએ ભારત સરકારનાં સંરક્ષણ મંત્રાલય અને સેવા મુખ્યાલયના 20 અધિકારીઓના બેચને પ્રથમ ડિફેન્સ એક્વિઝિશન કોર્સમાં ભાગ લેવા માટે આમંત્રિત કર્યો છે.…
TVS મોટર્સ હાઇડ્રોજન સંચાલિત સ્કૂટર બનાવશે
સમગ્ર વિશ્વમાં પ્રદૂષણના સ્તરમાં ઝડપથી વધારો થવાને કારણે ઉત્પાદકો સ્વચ્છ અને હરિયાળા પરિવહનના માર્ગો તરફ સ્વિચ કરવા પ્રેર્યા છે. અને અશ્મિભૂત ઇંધણ માટે અત્યાર સુધી…
મિત્રો હવે યુરિયા અને D.A.P. છોડો અને અપનાવો ધન જીવામૃત (પ્રાકૃતિક ખેતી)જેમાં છે દરેક વ્યક્તિ નું હિત
મિત્રો આપને સૌપ્રથમ એ જાણીએ કે આ જીવામૂર્ત શાં માટે? વરસાદ આધારિત ખેતી હોય કે સિંચાઈની વ્યવસ્થા ના હોય ( સિંચાઈ માટે પાણી મળતું ના…
PACL Chit Fund Refund: pearlsના રોકાણકારો માટે રિફંડ મેળવવાની આ છેલ્લી તક, સેબી (SEBI) એ લીધો મોટો નિર્ણય
જો તમે પણ PACL ઇન્ડિયા લિમિટેડની રોકાણ યોજના પર્લ્સ (pearls) માં રોકાણ કર્યું છે, તો તમારા માટે ખૂબ જ મહત્વપૂર્ણ સમાચાર છે. તમારા પૈસા પાછા…
Gujarat માં CM ભૂપેન્દ્ર પટેલે ડ્રોન ટેકનોલોજી દ્વારા ઈફકો નેનો યુરીયા છંટકાવ યોજનાનો રાજ્ય વ્યાપી પ્રારંભ કરાવ્યો
ગુજરાતમાં( Gujarat) કૃષિ ક્ષેત્રમાં ડ્રોન ટેકનોલોજીના ઉપયોગથી ફકત 20 મીનીટમાં 1 હેકટર જેટલા વિસ્તારમાં ૨૫ લીટર પાણી દ્વારા દવા છંટકાવ કરી શકાય છે અને ખેત…
સિલ્ક માર્કનો ઉદ્દેશ સિલ્કના સામાન્ય પ્રમોશન અને ભારતીય સિલ્કની દેશ-વિદેશમાં બ્રાન્ડ ઇક્વિટી બનાવવાનો છે, કેન્દ્રીય કપડા રાજ્યમંત્રી શ્રીમતી દર્શના જરદોશે કહ્યું
સિલ્ક માર્ક એક્સપોનું ઉદ્ઘાટન કર્યું. 22મી ઓગસ્ટ, 2022થી શરૂ થઈને 28મી ઓગસ્ટ, 2022 સુધી સિલ્ક માર્ક એક્સ્પોમાં 12 રાજ્યોના 39 પ્રદર્શકો ભાગ લેશે…
પ્રધાનમંત્રી 24 ઓગસ્ટે હરિયાણા અને પંજાબની મુલાકાત લેશે
પીએમ ફરીદાબાદમાં અમૃતા હોસ્પિટલનું ઉદ્ઘાટન કરશે. નેશનલ કેપિટલ રિજનમાં આધુનિક મેડિકલ ઈન્ફ્રાસ્ટ્રક્ચરને નવી બનેલી હોસ્પિટલ દ્વારા પ્રોત્સાહન મળશે…
પેશી સંવર્ધનમાં હાઈડ્રોપોનીક્સ અને એરોપોનીક્સનો ઉપયોગ
બાગાયતી પાકોમાં ટિશ્યૂકલ્ચર (પેશીસંવર્ધન) ટેક્નોલોજી દ્વારા વિકસાવેલ ઉચ્ચ ગુણવત્તા અને વધારે ક્ષમતા ધરાવતા રોપાઓએ એની ઉપયોગીતા સિદ્ધ કરેલ છે. આ પદ્ધતિને 'સૂક્મપ્રજનન' પદ્ધતિ પણ કહેવામાં…
રાષ્ટ્રીય પુરસ્કાર પોર્ટલ શરૂ થયું, વિવિધ પુરસ્કારો માટે નામાંકન ખુલ્યા
સરકાર દ્વારા એક સામાન્ય રાષ્ટ્રીય પુરસ્કાર પોર્ટલ (https://awards.gov.in) પારદર્શિતા સુનિશ્ચિત કરવા અને ભારત સરકારના વિવિધ મંત્રાલયો/વિભાગો/એજન્સીઓના તમામ પુરસ્કારોને એક મંચ હેઠળ એકસાથે લાવવા અને જાહેર…
Kisan Mahapanchayat: દિલ્હીની તમામ સરહદો પર કડક સુરક્ષા
Delhi Jantar Mantar Kisan Protest: જંતર-મંતર મહાપંચાયતને ધ્યાનમાં રાખીને દિલ્હી બોર્ડર પર બેરિકેડ લગાવી દેવામાં આવ્યા છે અને મોટી સંખ્યામાં સૈનિકો તૈનાત કરવામાં આવ્યા છે.…
તબેલા લોન યોજના ગુજરાત 2022
Tabela Loan Yojana Gujarat 2022 | તબેલા લોન યોજના | Cow Tabela Loan in Gujarat |આદિજાતિ નિગમ યોજના | Loan For Tabela In Gujarat |…
Ration Card: કરોડો રેશનકાર્ડ ધારકોને ઝટકો, આવતા મહિનાથી બંધ થઈ જશે મફત રાશનની સુવિધા!
જો તમે પણ સરકારની મફત રાશન યોજનાનો લાભ લઈ રહ્યા છો, તો આ સમાચાર તમારા માટે મહત્વપૂર્ણ છે. નવા અપડેટ હેઠળ હવે રેશનકાર્ડ ધારકોએ અનાજની…
પ્રોસેસિંગ માટેના બટાટાની ગુણવત્તા
હાલના સમયમાં બટાટાનું પ્રોસેસિંગ કરી તેમાથી અલગ અલગ ખાદ્યચીજવસ્તુ બનાવવામાં આવે છે જેવી કે ચિપ્સ, ફ્રેન્ચ ફ્રાઈસ, સૂકા ટુકડા અને કાતરી. આ બધી ખાદ્યચીજવસ્તુની ગુણવત્તાનો…
એકવાર ફરી ખેડૂતો આવશે દિલ્હી, રોકવા માટે પોલીસે રાજધાનીની સરહદો પર શરૂ કર્યો બંદોબસ્ત
સોમવારે જંતર-મંતર ખાતે ખેડૂતોના વિરોધના આહ્વાન પહેલા દિલ્હી પોલીસે દિલ્હી-હરિયાણાને જોડતી ટિકરી બોર્ડર પર સિમેન્ટના બેરિકેડ લગાવવાનું શરૂ કર્યું છે.…
રાજમાતા વિજયરાજે સિંધિયા કૃષિ યુનિવર્સિટી, ગ્વાલિયર ખાતે 11મી રાષ્ટ્રીય બીજ કોંગ્રેસનું ઉદ્ઘાટન
ગ્વાલિયર/નવી દિલ્હી, 21 ઓગસ્ટ 2022, કેન્દ્રીય કૃષિ અને ખેડૂત કલ્યાણ મંત્રી શ્રી નરેન્દ્ર સિંહ તોમરે કહ્યું છે કે બીજ માત્ર પાકનું જ નહી પરંતુ સંસ્કૃતિનું…
દેશના દરેક શહેરમાં આરોગ્ય અને શિક્ષણ ક્ષેત્રે ગતિ શક્તિ પ્રોજેક્ટ લાગુ કરવામાં આવે: કેન્દ્રીય મંત્રી શ્રી પિયુષ ગોયલ
શ્રી પિયુષ ગોયલે આજે ગાંધીનગરમાં ભાસ્કરાચાર્ય નેશનલ ઇન્સ્ટિટ્યૂટ ઓફ સ્પેસ યુઝ એન્ડ લેન્ડ ઇન્ફોર્મેટિક્સ (BISAG-N)ની મુલાકાત લીધી…
ધોલેરા-SIR વિશ્વનો સૌથી મોટો અને શ્રેષ્ઠ મેન્યુફેક્ચરિંગ ઝોન બનશેઃ કેન્દ્રીય વાણિજ્ય અને ઉદ્યોગ મંત્રી શ્રી પિયુષ ગોયલ
પ્રધાનમંત્રી શ્રી નરેન્દ્ર મોદીનું નેતૃત્વ સમગ્ર વિશ્વએ સ્વીકાર્યું, આગામી 25 વર્ષમાં ભારત વિકસિત દેશ બનીને રહેશેઃ શ્રી ગોયલ લોજિસ્ટિક કોસ્ટ ઘટાડીને ઉત્પાદકતા વધારી આત્મનિર્ભર ભારત…
સાયલા ખાતે શ્રી ઢાંકણીયા દૂધ ઉત્પાદન મંડળીના 'નવીન દૂધ ઘર'ના લોકાર્પણનો કાર્યક્રમ યોજાયો
દુનિયામાં ભારત સૌથી વધુ દૂધ ઉત્પાદન કરતો દેશ છેઃ કેન્દ્રીય મંત્રીશ્રી પુરુષોત્તમ રૂપાલા સુપ્રસિદ્ધ સાહિત્યકાર હેમુભાઈની પુણ્યતિથિ નિમિતે કેન્દ્રી/ મંત્રી શ્રી પરશોત્તમ રૂપાલા અને રાજ્યના…
New BPL List: આખા ગામની BPL લિસ્ટ, તમારું નામ ચેક કરો ઓનલાઇન
દેશમાં થઈ રહેલી વસ્તી ગણતરીમાં લોકોની આવક અને કુટુંબની સ્થિતિના આધારે BPL યાદી તૈયાર કરવામાં આવે છે. આ BPL લિસ્ટ કેન્દ્ર સરકાર દ્વારા ઓનલાઈન પોર્ટલ…
મકાઇ માં આંતર પાક પધ્ધતિ (Mix Farming) દ્વારા વધુ કમાણી
આંતર પાક પધ્ધતિ સામાન્ય રીતે મર્યાદિત સંસાધનો સાથે નાના ખેતરો પર કરવામાં આવે છે અને વિવિધ પાક સંયોજનોમાં વધુ સ્થિરતા સાથે ઉપજ વધારવા માટે આંતર…
"ખેતીવાડી" ભવિષ્યનો "સર્વોતમ ધંધો" હશે.
"ખેતી" એક "સંપુર્ણ" અને "સ્વનિર્ભર" વ્યવસાય છે. જગત આખાની પેટની ભુખ ઠારવાનું "કૌવત" એક માત્ર "ખેડુતના બાવડામાં" જ હોય છે.…
પ્રધાનમંત્રીએ જલ જીવન મિશન હેઠળ હરઘર જલ ઉત્સવને વીડિયો સંદેશ દ્વારા સંબોધન કર્યું
દેશના 10 કરોડ ગ્રામીણ ઘરોને પાઇપ દ્વારા સ્વચ્છ પાણીની સુવિધા સાથે જોડવામાં આવ્યા છે. ગોવા પ્રથમ હરઘર જલ પ્રમાણિત રાજ્ય બન્યું દાદરા નગર હવેલી અને…
7th Pay Commission News: રાજ્યોએ વધાર્યા પોતાના કર્મચારીઓના મોંઘવારી ભથ્થા, જાણો મોદી સરકાર ક્યારે લેશે આ નિર્ણય
DA Hike News: જન્માષ્ટમી સાથે તહેવારોની સિઝન શરૂ થઈ ગઈ છે અને સરકાર તહેવારોની સિઝનમાં ગમે ત્યારે કેન્દ્રીય કર્મચારીઓના મોંઘવારી ભથ્થામાં વધારો કરવાની જાહેરાત કરી…
Village Business Ideas: ગામમાં સૌથી વધુ ચાલી રહેલા 3 બિઝનેસ આઇડિયા, જે સરળતાથી કરી શકાશે શરૂ
ગામ હોય કે શહેર, પૈસાની જરૂર દરેક વ્યક્તિને પડતી હોય છે, તેથી જો તમારે ખૂબ પૈસા કમાવવા હોય, તો તમારે તમારું ગામ છોડીને ક્યાંય જવાની…
જમીનમાં ભેજનું શું મહત્વ રહેલું છે તે જાણો
પાકની વૃધ્ધિ અને ઉત્પાદનને સારી અને માઠી અસર કરતાં પરિબળોમાં પાણી (ભેજ) એ એક અગત્યનું પરિબળ છે . આ ઉપરાંત ઉષ્ણતામાન , પ્રકાશ , જમીનની…
“કુંવારપાઠાની વૈજ્ઞાનીક ખેતી”
કુંવારપાઠાનું વૈજ્ઞાનિક નામ એલો બાર્બેડેનસીસ મિલર છે જે લીલીએસી કુળનું છે. કુંવારપાઠું એ એક બરછટ દેખાતો, બારમાસી, છીછરા મૂળવાળો છોડ છે, જેમાં ટૂંકી દાંડી સાથે…
કિરણ હોસ્પિટલ - સુરત દ્વારા સમગ્ર દેશમાં જટીલ બીમારીથી પીડાતા 750 બાળકોને વિના મૂલ્યે સર્જરી.
જટીલ બીમારીથી પીડાતા 10 વર્ષ સુધીના બાળકોને વિના મૂલ્યે સર્જરી.- *પદ્મશ્રી માથુરભાઇ સવાણી – ચેરમેન કિરણ હોસ્પિટલ…
પાલિતાણાની સર માનસિંહજી હોસ્પિટલને AIIMS રાજકોટ સાથે જોડવાથી દર્દીઓને ત્વરિત સારવાર મળશે તથા નાણાં-સમયની બચત થશેઃ કેન્દ્રીય મંત્રી શ્રી મનસુખ માંડવિયા
ટેલીમેડીસીન સેવાઓનો પાલિતાણાની સર માનસિંહજી હોસ્પિટલ ખાતે શુભારંભ ભારત સરકારના કેન્દ્રીય મંત્રીશ્રી આરોગ્ય અને પરિવાર કલ્યાણ તથા રસાયણ અને ખાતર ડો. મનસુખભાઈ માંડવિયા દ્વારા પાલિતાણા…
ઢીંગરી મશરૂમની ઉત્પાદન પદ્ધતિ
મશરૂમ એ એક ફૂગ છે જે માંસલ ફળ આપતા શરીરને ઉત્પન્ન કરે છે, ખાસ કરીને જેમાં છત્રી કેપ સાથે દાંડીનો સમાવેશ થાય છે. મશરૂમમાં કેલરીનું…
મહિલાઓને કૃષિ ક્ષેત્રમાં વધુ સશક્ત બનાવવા માટે STIHL આપી રહ્યુ છે તેમનો સાથ
વાવણીથી લઈને વાવેતર, પાણી નિકાલ, સિંચાઈ, ખાતર, છોડ સંરક્ષણ, લણણી, નિંદણ અને સંગ્રહ સુધી દરેક સ્તરે કૃષિ બહુપક્ષીય ભૂમિકા ભજવે છે. કૃષિ અને ગ્રામીણ અર્થવ્યવસ્થામાં…
UP Rain: દિલ વાલો કે દિલ કા કરાર લુટને, “ચોમાસુ” આવ્યુ છે યુપી બિહાર લુટને
ચોમાસાએ તેની દિશા યુપી તરફ ફેરવી દીધી છે, જેના કારણે આજે આગ્રા, લખનૌ, વારાણસી, પ્રયાગરાજ સહિત ઘણા વિસ્તારોમાં વરસાદ પડી શકે છે. તેમજ બિહારના કેટલાક…
કેન્દ્રીય મંત્રીમંડળે ત્રણ લાખ રૂપિયા સુધીની ટૂંકા ગાળાની કૃષિ લોન પર વાર્ષિક 1.5%ની વ્યાજ સહાયને મંજૂરી આપી
આ યોજના હેઠળ વર્ષ 2022-23થી 2024-25ના સમયગાળા માટે રૂ. 34,856 કરોડની વધારાની અંદાજપત્રીય જોગવાઈઓ આ નિર્ણયથી કૃષિ ક્ષેત્રમાં ખેડૂતને પર્યાપ્ત ધિરાણનો પ્રવાહ સુનિશ્ચિત થશે…
નાણાકીય વર્ષ 2023માં ખાદ્યાનોની નિકાસને 23.56 અબજ ડોલર સુધી વધારવાની કેન્દ્રની યોજના
કૃષિ ઉત્પાદનો માટે વાણિજ્ય અને ઉદ્યોગ મંત્રાલયની નિકાસ પ્રમોશન સંસ્થા, APEDA એ નાણાકીય વર્ષ 2022-23 માટે 23.56 બિલિયન ડોલરની નિકાસ લક્ષ્ય નિર્ધારિત કર્યું છે. નાણાકીય…
જંતુનાશકોનો અસંતુલિત ઉપયોગ બંધ કરો
એક અભ્યાસ પ્રમાણે પાકમાં જંતુ-રોગના ઉપદ્રવથી ભારતમાં વાર્ષિક 36 બિલિયન ડોલરથી વધુનું નુકસાન થાય છે. જો કે, જીવાતો-રોગને કારણે પાકની ઉત્પાદકતામાં થયેલા ઘટાડાનું ચોક્કસ મૂલ્યાંકન…
કોબીને લગતી આ માહિતી તમારે જાણવી જરૂરી છે
કોબીજ (બ્રાસિકા ઓલેરેસી) શાકભાજીમાં મુખ્યત્વે કોબીજ, કોબી, કોબી, બ્રોકોલી અને બ્રસેલ્સ સ્પ્રાઉટ પાકોનો સમાવેશ થાય છે. આ શ્રેણીના શાકભાજીની ઉપલબ્ધતા આખા વર્ષ દરમિયાન રહે છે.…
મંત્રીમંડળે પરંપરાગત જ્ઞાન ડિજિટલ લાઇબ્રેરી (TKDL)ના ડેટાબેઝનો ઍક્સેસ પેટન્ટ ઓફિસો ઉપરાંત વપરાશકારો સુધી વિસ્તૃત કરવાની મંજૂરી આપી
પ્રધાનમંત્રી શ્રી નરેન્દ્ર મોદીની અધ્યક્ષતામાં મંત્રીમંડળે “પરંપરાગત જ્ઞાન ડિજિટલ લાઇબ્રેરી (TKDL)ના ડેટાબેઝનો ઍક્સેસ પેટન્ટ ઓફિસો ઉપરાંત, વપરાશકર્તા સુધી વિસ્તૃત કરવાની” મંજૂરી આપી છે. વપરાશકર્તાઓ માટે…
સિયાચીનમાં ભારતીય સૈનિકોએ લહેરાવ્યો તિરંગો, આનંદ મહિન્દ્રાનએ ટ્વિટ કરી આપી જુસ્સાને સલામી
ભારતના જાણીતા ઉદ્યોગપતિ આનંદ મહિન્દ્રા અવારનવાર ટ્વિટર પર દેશની સુંદરતા અને વિવિધતા સાથે સંબંધિત પોસ્ટ શેર કરે છે. આજે તેમણે એક હૃદય સ્પર્શી જાય તેવી…
14 ઓગસ્ટ 1947 ની રાતનો એક દર્દનાક કિસ્સો, 10 લાખ લોકોએ ગુમાવ્યો હતો પોતાનો જીવ
15 ઓગસ્ટ 1947ના રોજ ભારત દેશ આઝાદ થયો હતો. આના એક દિવસ પહેલાની રાત્રે, 14મી ઓગસ્ટની મધ્યરાત્રિએ, હિન્દુસ્તાનમાં જે બન્યું તેનાથી દેશનો ઈતિહાસ અને ભૂગોળ…
Gujarat Police Salary Hike:15 ઓગસ્ટે પોલીસકર્મીઓને ભેટ, પગાર વધારવા માટે આ સરકારે આપ્યુ 550 કરોડનું પેકેજ
આઝાદીના 75 વર્ષ નિમિત્તે ગુજરાત સરકારે રાજ્યના પોલીસકર્મીઓને મોટી ભેટ આપી છે. પોલીસકર્મીઓના પગાર વધારાના મુદ્દા પર વિરોધ બાદ ગુજરાતની ભૂપેન્દ્ર પટેલ સરકારે રૂ. 550…
EVની ખરીદી પર ક્યાં કેટલી મળી રહી છે સબસિડી, રોડ ટેક્સ રજિસ્ટ્રેશનમાં શું છે છૂટ
ઇલેક્ટ્રિક વ્હીકલ (EV) ને પ્રોત્સાહન આપવા માટે, ઘણી રાજ્ય સરકારો આવા વાહનોની ખરીદી પર સબસિડી આપી રહી છે.…
ભ્રષ્ટાચાર, પરિવારવાદ, દેશના લૂંટારાઓ, પંચ પ્રણ.. PM મોદીની 67 વાતો પર 67 વાર તાળીઓ
સ્વતંત્રતાનો અમૃત ઉત્સવ. એટલે કે આઝાદીના 75 વર્ષ પૂર્ણ થયા છે. વડાપ્રધાન નરેન્દ્ર મોદીએ 76માં સ્વતંત્રતા દિવસ પર 2047ની બ્લૂ પ્રિન્ટ તૈયાર કરી. જ્યારે તેઓ…
PM kisan yojana: PM કિસાનના લાભાર્થીઓને સરકારે આપી મોટી રાહત, આવા ખેડૂતોને મળશે 4 હજાર
PM કિસાન સન્માન નિધિના 10 કરોડથી વધુ ખેડૂતોને સરકારે ફરી એકવાર મોટી રાહત આપી છે. જો તમે સરકાર દ્વારા e-KYCની છેલ્લી તારીખ બે વખત લંબાવવા…
બિગ બુલ રાકેશ ઝુનઝુનવાલાની ફોર્મ્યુલા જેના આધારે તેમણે બનાવ્યું પોતાનું સામ્રાજ્ય
સ્વર્ગસ્થ રાકેશ ઝુનઝુનવાલા, ભારતીય શેરબજારોમાં બિગ બુલ તરીકે જાણીતા હતા, તેઓ વારંવાર ગાણિતિક સૂત્રને અનુસરતા હતા.…
વિભાજન વિભીષિકા સ્મૃતિ દિવસ નિમિત્તે કેન્દ્રીય સંચાર રાજ્યમંત્રી દેવુસિંહ ચૌહાણે, નડિયાદ ખાતે પ્રદર્શન ખુલ્લું મૂક્યું
ખેડા જિલ્લાના વડા મથક નડિયાદના ઈપ્કોવાલા હોલ ખાતે નડિયાદ નગરપાલિકા દ્વારા આયોજીત, ૧૪ ઓગસ્ટના વિભાજન વિભીષિકા સ્મૃતિ દિવસ નિમિત્તે પ્રદર્શન ખુલ્લુ મુકાયું.…
આદિવાસીઓની આજીવિકા પુરુ પાડતું મહત્વપૂર્ણ વૃક્ષ: કડાયો
શું તમે જાણો છો કે જંગલમાં રહેતા આદિવાસીઓ પોતાનું જીવન કેવી રીતે ગુજારે છે?, આદિવાસીઓ તેમની જીવન જરૂરિયાતોની વસ્તુઓ જંગલમાં મળતા ઘાસ, છોડ, વૃક્ષ, પ્રાણી,…
આબોહવા સ્માર્ટ કૃષિ: વાતાવરણ આધારિત કૃષિનો એક નવો અભિગમ
કૃષિ ક્ષેત્ર ખાસ કરીને આબોહવા પરિવર્તન માટે સંવેદનશીલ છે કારણ કે વિવિધ પાકો અને પ્રાણીઓ વિવિધ પરિસ્થિતિઓમાં ખીલે છે. આ કૃષિને સતત તાપમાનની શ્રેણી અને…
કારેલા માં રોગ જીવાત નિયંત્રણ
કારેલાનો પાક ભારતમાં વિસ્તૃત રીતે થાય છે. ગુજરાતમાં પણ ઘણા ખેડૂતોએ મહંદઅંશે આ પાક અપનાવેલ છે. કારેલા ખાસ કરીને ઉનાળામાં તેમજ ચોમાસામાં એમ બંને ઋતુમાં…
Rakesh Jhunjhunwala Death: ભારતના વોરેન બફેટ રાકેશ ઝુનઝુનવાલાનું નિધન, 62 વર્ષની ઉંમરે લીધા અંતિમ શ્વાસ
દિગ્ગંજ રોકાણકાર રાકેશ ઝુનઝુનવાલા હવે આ દુનિયામાં નથી રહ્યા. તેમણે આજે (રવિવારે) અંતિમ શ્વાસ લીધા હતા. મુંબઈની બ્રીચ કેન્ડી હોસ્પિટલે આજે સવારે 6:45 વાગ્યે તેમના…
નવસારીની મહિલા બે બાળકો સાથે કાર ડ્રાઈવ કરી 65 હજાર કિ.મીની યાત્રા કરશે, ભારતના ચારે છેડે તિરંગો લહેરાવશે: સામાજિક ન્યાય કેન્દ્રીય મંત્રી શ્રી રામદાસજી આઠવલે
નવસારીની ખ્યાતનામ સાહસિક મહિલા શ્રીમતી ભારૂલતા પટેલ-કાંબલે પોતાના બે બાળકો સાથે કાર ડ્રાઈવ કરી 'આઝાદીના અમૃત્ત મહોત્સવ' અંતર્ગત "મિશન ભારત" ડ્રાઈવિંગ અભિયાનનો આજ આરંભ કરવામાં…
Electric Tractor:ટૂંક સમયમાં લોન્ચ થવા જઈ રહ્યું છે ઇલેક્ટ્રિક ટ્રેક્ટર! ખેડૂતોને મળશે મોટી રાહત
OSM કંપનીના ચેરમેન ઉદય નારંગે ભારતમાં લોન્ચ થનારા ઈલેક્ટ્રિક ટ્રેક્ટર વિશે બધાને જણાવ્યું કે, 'કંપનીએ દક્ષિણ કોરિયા અને થાઈલેન્ડમાં પોતાના સંશોધન-વિકાસ કેન્દ્રો પણ બનાવ્યા છે.…
હર ઘર તિરંગા અભિયાન થકી જામનગરની 300થી વધુ મહિલાઓએ મેળવી રોજગારી
દીન દયાળ અંત્યોદય યોજના - રાષ્ટ્રીય શહેરી આજીવિકા મિશન ( DAY-NULM) થકી બહેનોએ રાષ્ટ્રધ્વજ બનાવી જનતાને તિરંગો લહેરાવવા કરી વિનંતી…
Har Ghar Tiranga:હર ઘર તિરંગા અભિયાનના ભાગરૂપે કૃષિ જાગરણમાં પણ તિરંગો ફરકાવ્યો
હર ઘર તિરંગા (Har Ghar Tiranga)અભિયાનના ભાગરૂપે કૃષિ જાગરણની સમગ્ર ટીમે ઓફિસની છત પર તિરંગો ફરકાવ્યો હતો.…
કુદરતી રેસા આપતુ વૃક્ષ સીબા પેન્ટેન્ડ્રા (કપોક, સફેદ શીમળો)
પ્રસ્તાવના: આજના સમયમાં જંગલોનું પ્રમાણ દિવસને દિવસે ઓછુ થવા લાગ્યું છે. આ ઉપરાંત માનવીની જરૂરિયાત તેમજ ઔધોગિક જરૂરિયાત માટે હવે કુદરતી જંગલો ઉપર નિર્ભર રહી…
શું છે હર ઘર તિરંગા અભિયાન, કઈ તારીખ છે ખાસ, કેવી રીતે મેળવવું પ્રમાણપત્ર, જાણો બધું
હર ઘર તિરંગા અભિયાન આજથી શરૂ થયું છે. 13 થી 15 ઓગસ્ટ સુધી ચાલનારા આ અભિયાનમાં દરેકની ભાગીદારી સુનિશ્ચિત કરવા માટે સરકારે સત્તાવાર વેબસાઇટ harghartiranga.com…
ગુજરાત અને રાજસ્થાનથી છત્તીસગઢ પહોંચ્યો લમ્પી વાયરસ, બિલાસપુરમાં પણ એલર્ટ
લમ્પી વાયરસ સમગ્ર ભારતમાં ઝડપથી ફેલાઈ રહ્યો છે. દેશના અનેક રાજ્યોમાં તે પશુધન માટે જીવલેણ સાબિત થયો છે. લમ્પી વાયરસ ત્વચા રોગનો પ્રથમ કેસ જુલાઈના…
દેશમાં અત્યાર સુધીમાં ખરીફ વાવણી 80 મિલિયન હેક્ટરને પાર કરી ગઈ
દેશમાં અત્યાર સુધીમાં 847 લાખ હેક્ટરમાં ખરીફ પાકનું વાવેતર થયું છે, જે ગયા વર્ષે આ સમયગાળામાં 838 લાખ 34 હજાર હેક્ટર હતું. વધુ વિસ્તારમાં કઠોળ,…
જામનગર મહાનગરપાલિકા અને નગર પ્રાથમિક શિક્ષણ સમિતિના સંયુક્ત ઉપક્રમે તિરંગા યાત્રા યોજાઈ
જામનગર મહાનગરપાલિકા અને નગર પ્રાથમિક શિક્ષણ સમિતિ જામનગરના સંયુક્ત ઉપક્રમે શુક્રવારે સવારે 9:00 વાગ્યે લાખોટા તળાવ ગેટ નં. 1 ખાતેથી તિરંગા યાત્રા યોજાઇ હતી. આ…
Free Ration Update: કરોડો રેશનકાર્ડ લાભાર્થીઓને મોટો ફટકો! સરકારે મફત ઘઉંના વિતરણ પર મૂક્યો પ્રતિબંધ
જો તમારી પાસે પણ રાશન કાર્ડ છે અને તમે સરકારની મફત રાશન યોજનાનો લાભ લઈ રહ્યા છો, તો આ સમાચાર તમારા કામના છે. આ અંગે…
આ છે તિરંગો ફરકાવવાની સાચી રીત,આ વાતોનું રાખો ધ્યાન
'હર ઘર તિરંગા અભિયાન' હેઠળ દેશભરમાં 20 કરોડ તિરંગા ફરકાવવાનું લક્ષ્ય રાખવામાં આવ્યું છે. આ માટે સરકારે તિરંગાને ફરકાવવાના નિયમોમાં ઘણા મહત્વપૂર્ણ ફેરફારો પણ કર્યા…
PM Awas Yojna: PM આવાસ યોજના પર મોદી સરકારે કરી મોટી જાહેરાત, યોજના 2024 સુધી લંબાવી, જાણો વિગત
PMAY-U:પ્રધાનમંત્રી નરેન્દ્ર મોદીની અધ્યક્ષતામાં મંત્રીમંડળે પ્રધાનમંત્રી આવાસ યોજના-શહેરી (PMAY-U) યોજનાને 31 ડિસેમ્બર, 2024 સુધી લંબાવી છે. આમાં 31 માર્ચ, 2022 સુધીમાં મંજૂર કરાયેલા 122.69 લાખ…
હવે બદલાશે કોલ અને ઈન્ટરનેટ ઉપયોગની પદ્ધતિ, જાણો શું હશે હવે આગામી સમયમાં નવીનત્તમ બાબત
દેશમાં લાંબ સમય સુધી રાહ જોયા બાદ હવે 5G નેટવર્ક તેના છેલ્લા તબક્કામાં છે. વાસ્તવમાં, 5G નેટવર્કની હરાજી 26 જુલાઈ 2022 મંગળવારના રોજ સવારે 10…
Azadi Ka Amrit Mahotsav:અર્થવ્યવસ્થાના પાટા પર દોડી રહેલ ભારતનો જીડીપી, જાણો 1947થી અત્યાર સુધીમાં કેટલો વધ્યો છે
દેશે આઝાદીના 75 વર્ષ પૂર્ણ કર્યા છે. આ વખતે દેશભરમાં આઝાદીનું અમૃત ઉજવવામાં આવી રહ્યું છે. આઝાદીની 75મી વર્ષગાંઠની ઉજવણીની ખાસ તૈયારીઓ ચાલી રહી છે.…
લમ્પી વાયરસ પશુઓમાં દૂધ ઉત્પાદનને ઘટાડી શકે છે, તે કયાં લક્ષણો ધરાવે છે તે જાણો
લમ્પી વાયરસ સમગ્ર ભારતમાં ઝડપથી ફેલાઈ રહ્યો છે. દેશના અનેક રાજ્યોમાં તે પશુધન માટે જીવલેણ સાબિત થયો છે. લમ્પી વાયરસ ત્વચા રોગનો પ્રથમ કેસ જુલાઈના…
કેન્દ્રીય ગૃહ અને સહકારિતા મંત્રી શ્રી અમિત શાહ આજે નવી દિલ્હીમાં ગ્રામીણ સહકારી બૅન્કોની રાષ્ટ્રીય પરિષદનું ઉદઘાટન કરશે
શ્રી નરેન્દ્ર મોદીનાં નેતૃત્વમાં સરકાર કૃષિ અને ગ્રામીણ વિસ્તારોની સુધારણા માટે કામ કરી રહી છે અને જેમ જેમ કૃષિ માળખામાં સરકારનું રોકાણ વધે છે, તેમ…
ચોખાનાં ફોર્ટિફિકેશનની જાહેરાતનું એક વર્ષ
24 રાજ્યોના 151 જિલ્લાઓએ ફોર્ટિફાઇડ ચોખા ઉઠાવ્યા હતા; 6.83 એલએમટીનું વિતરણ રાજ્યો/કેન્દ્ર શાસિત પ્રદેશો દ્વારા બીજા તબક્કામાં કરવામાં આવ્યું હતું…
ગાયોને બચાવવા માટે શરૂ કરાયેલ લમ્પી પ્રો વેક્સિન ટૂંક સમયમાં અસરગ્રસ્ત વિસ્તારો અને પશુપાલકો સુધી પહોંચશેઃ કૈલાશ ચૌધરી
લમ્પી પ્રો વેક્સીનનું ઉત્પાદન ICAR સંસ્થાઓ દ્વારા પશુઓમાં ફેલાતા વાયરલ રોગ લમ્પી સ્કીનને નિયંત્રિત કરવા માટે કરવામાં આવ્યું છે, કેન્દ્રીય કૃષિ રાજ્ય મંત્રી કૈલાશ ચૌધરીએ…
Vice President oath: જગદીપ ધનખડ બન્યા દેશના 14મા ઉપરાષ્ટ્રપતિ, રાષ્ટ્રપતિ દ્રૌપદી મુર્મુએ લેવડાવ્યા શપથ
નેશનલ ડેમોક્રેટિક એલાયન્સ (NDA)ના ઉમેદવાર જગદીપ ધનખડે આજે ભારતના 14મા ઉપરાષ્ટ્રપતિ તરીકે શપથ લીધા હતા. રાષ્ટ્રપતિ દ્રૌપદી મુર્મુએ રાષ્ટ્રપતિ ભવનમાં તેમને શપથ લેવડાવ્યા હતા. તમને…
સુરત તિરંગા યાત્રામાં પ્રધાનમંત્રીનાં વક્તવ્યનો મૂળપાઠ
થોડા દિવસો પછી, દેશને તેની આઝાદીનાં 75 વર્ષ પૂરાં થઈ રહ્યાં છે, અને આપણે બધા આ ઐતિહાસિક સ્વતંત્રતા દિવસ માટે પૂરજોશથી તૈયારી પણ કરી રહ્યા…
વનસ્પતિજન્ય જંતુનાશક દવાઓ દ્વારા સંકલિત કીટ નિયંત્રિત કરો
ખેતી પાકોના ઉત્પાદનમા બાધારૂપ પરીબળોમા કીટકો એક અગત્યનું પરીબળ છે. હાલના સંજોગોમા કીટકોના આક્ર્મણથી ખેતીના મોટાભાગના પાકમા નુકશાન થાય છે તેથી કીટકોનો નાશ કરવો ખુબ…
કૃષિ જાગરણ ચૌપાલમાં ધનુકા ગ્રુપ ચેરમેન રામ ગોપાલ અગ્રવાલ
રામ ગોપાલ અગ્રવાલ (આર.જી અગ્રવાલ), ભારતની અગ્રણી એગ્રોકેમિકલ કંપની ધનુકા લિ.ના ગ્રુપ ચેરમેન. કૃષિ જાગરણના ચૌપાલમાં પહોંચ્યા, આર.જી અગ્રવાલ સ્વતંત્રતાના અમૃત પર્વ નિમિત્તે આયોજિત હરઘર…
2020માં સીએમ બનવા ન હતો માંગતો, શપથ ગ્રહણ બાદ બીજુ શુ બોલે નીતિશ
બિહારના સીએમ પદના શપથ લીધા બાદ નીતિશે ભાજપ પર પ્રહારો કર્યા હતા. તેમણે કહ્યું કે તેઓ વર્ષ 2020માં સીએમ બનવા માંગતા ન હતા. તેમનું આ…
આઝાદીના અમૃત મહોત્સવ અંતર્ગત આ 75મા વર્ષે ભારતભરમાં જનજાગૃતિ લાવવા તિરંગા પદયાત્રા રેલીનું કરાયું આયોજનઃ શ્રી દેવુસિંહ ચૌહાણ, કેન્દ્રીય રાજ્ય સંચાર મંત્રી
નડિયાદ શહેરની તમામ શૈક્ષણિક, બિન શૈક્ષણિક, સંસ્થાઓ સ્વૈચ્છિક, સંગઠનો, પ્રબુદ્ધ નાગરિકો સાથે સ્ટેશન રોડ ઉપર આવેલ સરદાર પટેલની પ્રતિમા પાસેથી તિરંગા પદયાત્રા ઉત્સાહભેર પસાર થઈ…
કેન્દ્રએ વર્ષ 2022-23 માટે શેરડીની FRP ક્વિન્ટલ દીઠ રૂપિયા 15 વધારીને રૂપિયા 305 કર્યાં
શેરડીના ખેડૂતો (ગન્ના કિસાન)ના હિતોને ધ્યાનમાં રાખી વડા પ્રધાન નરેન્દ્ર મોદીની અધ્યક્ષતામાં આર્થિક બાબતોની કેબિનેટ સમિતિએ વર્ષ 2022 માટે મિલોએ શેરડીના ખેડૂતોને ચૂકવવાના લઘુત્તમ ભાવમાં…
પશુપાલકોને ચેતવણી! લમ્પી સ્કિન ડિસીઝ રોગ ગુજરાતના 20 જિલ્લાઓમાં ફેલાયો, 1400થી વધુ પશુના મોત
જીવલેણ લમ્પી સ્કિન ડિસીઝ (LSD)ના પરિણામે ગુજરાતમાં ઓછામાં ઓછી 1,431 ગાયના મૃત્યુ થયા છે , આ રોગ હવે રાજ્યના 20 જિલ્લામાં ફેલાઈ ચૂક્યો છે. સરકારે…
કેન્દ્રીય મત્સ્ય, પશુપાલન અને ડેરી ઉદ્યોગ મંત્રી શ્રી પરશોત્તમ રૂપાલાએ ગઈ કાલે ભરૂચના જંબુસર ખાતે બ્રૂડસ્ટોક મલ્ટિપ્લિકેશન સેન્ટરનું ઉદ્ઘાટન કર્યુ
ભારત સરકારનો ઉદ્દેશ મત્સ્યપાલન અને જળચર ઉછેરમાં બ્રૂડ અને બીજમાં આત્મનિર્ભરતા હાંસલ કરવાનો છેઃ કેન્દ્રીય મંત્રી શ્રી રૂપાલા…
ખેડૂતો પણ પત્રકાર બની શકે છે, કૃષિ જાગરણની અનોખી પહેલ
ફાર્મર ધ જર્નાલિસ્ટ (FTJ) દ્વારા કૃષિ જાગરણની પહેલ દ્વારા હવે દરેક ગામનો ખેડૂત પત્રકાર બની શકશે. એટલું જ નહીં ખેડૂતો પોતાના માટે પણ અવાજ ઉઠાવી…
આત્મનિર્ભર ભારત અંતર્ગત MSME માટે યોજનાઓનું અમલીકરણ
દેશમાં સૂક્ષ્મ, લઘુ અને મધ્યમ ઉદ્યોગો (MSME) ક્ષેત્રને પ્રોત્સાહન આપવા માટે સરકારે આત્મનિર્ભર ભારત અભિયાન હેઠળ ઘણી પહેલ કરી છે. બે મુખ્ય યોજનાઓની વિગતો નીચે…
અમિત શાહ ગવર્નમેન્ટ ઇ માર્કેટપ્લેસ (GeM) પોર્ટલ પર સહકારી સંસ્થાઓના ઓનબોર્ડિંગનું ઇ-લોન્ચિંગ કરશે
પ્રધાનમંત્રી શ્રી નરેન્દ્ર મોદીની અધ્યક્ષતામાં કેન્દ્રીય મંત્રીમંડળે 1 જૂનના રોજ સહકારી સંસ્થાઓને GeM દ્વારા વસ્તુઓ અને સેવાઓની ખરીદી કરવાની મંજૂરી આપવા માટે GeM માટેના મેન્ડેટનું…
NITI Aayog Meeting: PM મોદીની અધ્યક્ષતામાં નીતિ આયોગની બેઠક, NEP 2020 અને G20 પર કરવામાં આવી ચર્ચા
બેઠકમાં રાષ્ટ્રીય શિક્ષણ નીતિ, શાળા શિક્ષણ અને ઉચ્ચ શિક્ષણના અમલીકરણની સાથે સાથે તેલીબિયાં અને કઠોળની બાબતમાં દેશને આત્મનિર્ભર બનાવવા અને શહેરી વહીવટની બાબત પર વિચાર…
NITI Aayog Meeting: PM મોદીની અધ્યક્ષતામાં નીતિ આયોગની બેઠક, NEP 2020 અને G20 પર કરવામાં આવી ચર્ચા
બેઠકમાં રાષ્ટ્રીય શિક્ષણ નીતિ, શાળા શિક્ષણ અને ઉચ્ચ શિક્ષણના અમલીકરણની સાથે સાથે તેલીબિયાં અને કઠોળની બાબતમાં દેશને આત્મનિર્ભર બનાવવા અને શહેરી વહીવટની બાબત પર વિચાર…
DoT ગુજરાત LSA દ્વારા ઈન્ટરનેટ સેવા પ્રદાતાઓ સાથે કોન્ફરન્સ
ગુજરાત LSA ડિપાર્ટમેન્ટ ઓફ ટેલિકોમ્યુનિકેશન્સ (DoT) એ 8.08.2022ના રોજ, ગુજરાતના ઈન્ટરનેટ સર્વિસ પ્રોવાઈડર્સ (ISP) સાથે, હોટેલ પ્રગતિ ધ ગ્રાન્ડ, થલતેજ અમદાવાદ ખાતે એક ઇન્ટરેક્ટિવ કોન્ફરન્સનું…
બીજાના જીવનમાં પ્રકાશ ભરીને તમારું પોતાનું જીવન રોશન કરો: IAS રવિકાંત
વરિષ્ઠ વહીવટી અધિકારી (IAS) ડૉ. રવિકાંત મેંધી, વ્યવસાયિક ક્ષેત્રમાં તેમના લાંબા અનુભવ અને કૃષિ જગત સાથે સતત પ્રવાસના અનુભવ અંગે ડૉ. રવિકાંત. IAS રવિકાંત હાઉસિંગ…
પ્રધાનમંત્રીએ રાજ્યસભામાં ઉપરાષ્ટ્રપતિ શ્રી એમ. વેંકૈયા નાયડુને વિદાય આપી
“આપણે આ વર્ષે 15મી ઓગસ્ટની ઉજવણી કરીશું ત્યારે તે રાષ્ટ્રપતિ, ઉપરાષ્ટ્રપતિ, સ્પીકર અને સ્વતંત્રતા પછી જન્મેલા પ્રધાનમંત્રી સાથે સ્વતંત્રતા દિવસ હશે. અને તેમાંથી દરેક ખૂબ…
અમદાવાદના વીવર્સ સર્વિસ સેન્ટરમાં રાષ્ટ્રીય હાથશાળ દિવસની ઉજવણી કરાઈ
દેશના સામાજિક આર્થિક વિકાસ માટે હેન્ડલૂમ ઉદ્યોગના મહત્વ વિશે જાગૃતિ લાવવાના ઉદ્દેશ્યથી કેન્દ્ર સરકારે વર્ષ 2015માં 7મી ઓગસ્ટને રાષ્ટ્રીય હાથશાળ દિવસ તરીકે જાહેર કર્યો હતો.…
ભારત હવે ખાંડનો સૌથી મોટો ઉત્પાદક અને બીજા ક્રમનો સૌથી મોટો નિકાસકાર દેશ
ભારત હવે ખાંડનો સૌથી મોટો ઉત્પાદક અને બીજા ક્રમનો સૌથી મોટો નિકાસકાર દેશ છે. છેલ્લા કેટલાક વર્ષો દરમિયાન દેશમાં ખાંડનું ઘરેલું વપરાશમાં સતત વધારો થવાને…
આર્ટિફિશિયલ ઈન્ટેલિજન્સ (કુત્રિમ બૌધિકતા): ભારતને ગુણવત્તાસભર ખેતી તરફ લઈ જનાર એક સક્ષમ માર્ગ
કુત્રિમ બૌધિકતા એ કોમ્પ્યુટર વિજ્ઞાનની એક શાખા છે જે સામાન્ય રીતે માનવ બુધ્ધિની જરૂર હોય તેવા કાર્યો કરવા સક્ષમ અને કુશળ યંત્રો બનાવવા સાથે સંબંધિત…
સુમિંતર ઈન્ડિયા ઓર્ગેનિક્સ પ્રાઈવેટ લિમિટેડ દ્વારા પૂરી પાડવામાં આવેલ છે વેનોમ ફ્રી ટ્રેપ અને લ્યુર કીટ
નોંધ:- આ ટ્રેપ અને લ્યુર કીટ એક એકર કપાસના પાક માટે છે. (A) યલો ટ્રેપ-15 (B)-ફનલ ટ્રેપ-16 (C) ગુલાબી બોલવોર્મ લ્યુર-8 (D) સ્પોડોપ્ટેરાલુર-4 (E) હેલિઓથિસ…
આધુનિક ખેતી તરફ પ્રયાસ ; ખેતી માં નોન વુવન ક્રોપ કવર નો ઉપયોગ
આજ ની ૨૧મી સદી માં દિવસે દિવસે વધતા જતા બેફામ રાસાયણિક ખાતરો અને દવાઓ ના ઉપયોગ ના લીધે આજે જમીન ની ફળદ્રુપતા માં ઘટાડો અને…
Milk MSP: કેન્દ્ર સરકારે ખેડૂતોને આપ્યો મોટો ઝટકો, MSPના દાયરામાં નહીં આવે દૂધ
કેન્દ્ર સરકારે લોકસભામાં કહ્યું કે દૂધના ભાવ સરકારી નિયંત્રણથી મુક્ત છે. તેની કિંમત સહકારી અને ખાનગી ડેરીઓ દ્વારા ઉત્પાદન ખર્ચ અને બજાર દળોના આધારે નક્કી…
સાવધાન :આ રાજ્યોમાં ભારે વરસાદ, પૂર, ભૂસ્ખલન અને વીજળી પડવાની ચેતવણી
ઘણા રાજ્યોમાં હવામાનમાં મોટો ફેરફાર જોવા મળી રહ્યો છે. ક્યાંક વરસાદના કારણે તો ક્યાંક કાળઝાળ ગરમીના કારણે લોકો પરેશાન છે, તો ચાલો જાણીએ રાજ્ય પ્રમાણે…
ગ્રામીણ વિસ્તારોમાં ડિજિટલ સાક્ષરતા
ડિજિટલ સ્વીકાર માટે, MeitY સમગ્ર દેશમાં ખાસ કરીને ગ્રામીણ વિસ્તારોમાં નાગરિકોને ડિજિટલ સાક્ષરતા પ્રદાન કરવા પર ધ્યાન કેન્દ્રિત કરી રહી છે. આને અનુલક્ષીને, સમગ્ર દેશમાં…
Mushroom Farming: ખેડૂતો માટલામાં પણ મશરૂમ ઉગાડીને કમાઈ શકે છે બમ્પર નફો, આ છે રીતે
Mushroom Cultivation: ઘણા ખેડૂતો મશરૂમની ખેતીથી બમ્પર નફો કમાઈ રહ્યા છે. તેમનાથી પ્રેરાઈને અન્ય ખેડૂતો પણ તેની ખેતી તરફ વળવા લાગ્યા છે. મશરૂમની ખેતીની સૌથી…
તકનીકી કાપડને પ્રોત્સાહન આપવા અને કુશળ માનવબળની ઉપલબ્ધતા સુનિશ્ચિત કરવાના હેતુથી, કેન્દ્રએ નવા ડિગ્રી અભ્યાસક્રમો માટે માર્ગદર્શિકા તૈયાર કરી
તકનીકી કાપડને પ્રોત્સાહન આપવા અને કુશળ માનવબળની ઉપલબ્ધતા સુનિશ્ચિત કરવાના હેતુથી, કેન્દ્રએ એન્જિનિયરિંગ સંસ્થાઓ માટે તકનીકી કાપડના નવા ડિગ્રી અભ્યાસક્રમો માટે માર્ગદર્શિકા તૈયાર કરી છે.…
ઉદ્યોગ સાહસિક બનવાની દિશામાં પગલુઃ અગરબતીનો કારોબાર શરૂ કરવાની પદ્ધતિ અને મશીનની કિંમત જાણો
દેશમાં ધાર્મિકતા એક ઉચ્ચ સ્થાન ધરાવે છે અને પૂજા-પ્રાર્થનામાં ધૂપ અથવા અગરબતીઓનો ન હોય તો જાણે ખાલીપો લાગે છે. અગરબતીનો કારોબારમાં ક્યારેય મંદી આવતી નથી.…
આવતીકાલે AJAIની સત્તાવાર વેબસાઇટ અને લોગો પરથી પડદો હટાવી દેવામાં આવશે
આવતીકાલે AJAI ઓફિશિયલ વેબસાઈટના લોગો પરથી પડદો હટશે…
ITOTY એવોર્ડ 2022: ઈન્ડિયન ટ્રોક્ટર ઓફ ધ યર એવોર્ડના વિજેતા મહિંદ્રા 575 DI XP Plus
ITOTY (ભારતીય ટ્રેક્ટર ઓફ ધ યર)ની શરૂઆત ટ્રેક્ટર જંક્શન દ્વારા દિલ્હીમાં 2019માં કરવામાં આવી હતી. તે ટ્રેક્ટર જંકશનના સ્થાપક (શ્રી રજત ગુપ્તા) દ્વારા એક નવીન…
આરોગ્ય સાથે આર્થિક લાભઃ અશ્વગંધાની ખેતી ખર્ચ કરતા 3 ગણો નફો રળી આપે છે
આયુર્વેદિક સારવારમાં ઉપયોગમાં લેવામાં આવતી અશ્વગંધા ગુણકારી ઔષધિયો પૈકીની એક છે. અશ્વગંધા ભારતની એક એવી ઔષધી છે જે ફક્ત આરોગ્ય માટે જ નહીં પણ આર્થિક…
Paddy Crop Management: પાકને બરબાદ કરશે આ રોગ, જાણો લક્ષણો અને નિવારણનાં પગલાં
ખરીફ સીઝન દરમિયાન, દેશના મોટાભાગના ખેડૂતો તેમના ખેતરોમાં ડાંગરનું વાવેતર કરે છે, કારણ કે ડાંગરનો પાક સંપૂર્ણપણે વરસાદના પાણી પર આધારિત છે. આ સમયે ડાંગરના…
ઔષધિય વનસ્પતિની ખેતીને પ્રોત્સાહન આપવા માટે લેવાયેલા પગલાં
ઇન્ડિયન કાઉન્સિલ ઓફ ફોરેસ્ટ્રી રિસર્ચ એન્ડ એજ્યુકેશન (ICFRE) દ્વારા નેશનલ મેડિસિનલ પ્લાન્ટ્સ બોર્ડ (NMPB) દ્વારા સમર્થિત વાર્ષિક 'મેડિસિનલ પ્લાન્ટ્સ ઇન ઇન્ડિયા: એન એસેસમેન્ટ ઑફ ધ…
ગુજરાતમાં 'હર ઘર નલ સે જલ' યોજનાનો અમલ
સાંસદ શ્રી નરહરી અમીનના અતારાંકિત પ્રશ્ન નં. 106 જેમકે, (a) ગુજરાત રાજ્યમાં 'હર ઘર નલ સે જલ' યોજનાના અમલીકરણની સ્થિતિ; (b) અત્યાર સુધી આ યોજનાનો…
દેશના માત્ર 50 ટકા ખેડૂતોને કૃષિ લોન માફી યોજનાનો લાભ મળ્યોઃ SBI રિપોર્ટ
ખેડૂતોને દેવામાંથી મુક્ત કરવા માટે વિવિધ રાજ્યોમાં ચાલતી કૃષિ લોન માફી યોજનાનો દેશના કેટલા ખેડૂતોને ફાયદો થયો? તેને સમજવા માટે સ્ટેટ બેંક ઓફ ઈન્ડિયા દ્વારા…
Cultivation of lemons :વિટામિન C થી ભરપૂર લીંબુની ખેતી કમાણી પણ ભરપૂર કરાવી આપે છે
જ્યાં એક બાજુ વિટામીન C વિપૂલ પ્રમાણમાં હોવાને લીધે લીંબુ અનેક ઔષધીય ગુણો ધરાવે છે ત્યારે તેનો સ્વાદ અથાણાના સ્વરૂપમાં હોય કે લીંબુપાણી અને શિકંજીના…
ભારતને ગેસ સપ્લાયમાં રશિયાની મોટી ચુક, વિકલ્પોની શોધ શરૂ, જાણો શું છે કારણ
રશિયાએ ભારતને લિક્વિફાઈડ નેચરલ ગેસ (LNG)ના ઓછામાં ઓછા પાંચ કન્સાઈનમેન્ટ મોકલવામાં ચુક કરી છે. માહિતી અનુસાર, મોસ્કો દ્વારા ભારતને ગેસ સપ્લાય કરતી કંપનીઓમાંથી એક પર…
UNSC: વિશ્વ ખાદ્ય સુરક્ષામાં ભારત ભજવી રહ્યું છે તેની ભૂમિકા, અફઘાનિસ્તાનને ઘઉંનું દાન કરી રહ્યું છે ભારત
સંયુક્ત રાષ્ટ્રમાં ભારતે કહ્યું છે કે વૈશ્વિક ખાદ્ય સુરક્ષાને આગળ વધારવામાં ભારત તેની યોગ્ય ભૂમિકા ભજવશે. સુરક્ષા પરિષદમાં ભારતના પ્રથમ સચિવ સ્નેહા દુબેએ કહ્યું કે,…
શું ભાજપ આ ટ્રમ્પ કાર્ડની મદદથી ખેડૂતોના આંદોલનને 'ડેમેજ કંટ્રોલ' કરી શકશે અને બે રાજ્યોમાં વિપક્ષને નબળો પાડી શકશે?
ભાજપે પશ્ચિમ બંગાળના રાજ્યપાલ જગદીપ ધનખડને ઉપરાષ્ટ્રપતિ પદના ઉમેદવાર જાહેર કરીને મોટું ટ્રમ્પ કાર્ડ રમ્યું છે. પાર્ટી આ દ્વારા ખેડૂતોના આંદોલન એટલે કે 'ડેમેજ કંટ્રોલ'માં…
કૃષિ જાગરણ ITOTY 2022 માટે એક્સક્લુઝિવ એગ્રી મીડિયા પાર્ટનર બનશે
ITOTY પાછળનો વિચાર ટ્રેક્ટર કંપનીઓની મહેનતને ઓળખવાનો છે. તેઓ તેમની સખત મહેનત માટે પુરસ્કારથી પ્રેરિત થાય છે, અને તેઓ ખેડૂતોની પરિસ્થિતિ સુધારવા માટે આગળ વધે…
જમીનની સ્વસ્થ્યતા અને પર્યાવરણ સંરક્ષણ માટે અપનાવો જૈવિક ખેતી
દિન પ્રતિદિન વધતી જતી જનસંખ્યાને જરૂરી અનાજનો પુરવઠો પુરો પાડવા માટે તેમજ ઘટતી જતી ખેતીલાયક જમીન વિસ્તારમાં વધુ ઉત્પાદન કઈ રીતે મેળવવું તે માટે ખેડૂતોને…
સારા ઉત્પાદન માટે બિયારણને લગતી આ કાળજી હવે વિશેષ જરૂરી બની છે
કૃષિ ભારતીય અર્થતંત્રમાં અગ્રણી સ્થાન ધરાવે છે. છેલ્લા 70 વર્ષોમાં કૃષિ માટે વપરાતી ખેતીની જમીનનો વિસ્તાર ઘટ્યો છે, પરંતુ કૃષિ ઉત્પાદનમાં પાંચ ગણાથી વધુ વધારો…
ડાંગરમાં નિંદણને નાબૂદ કરો અને ઉપજમાં મેળવો નોંધપાત્ર વધારો
વાવણી માટે પ્રમાણિત અને શુદ્ધ બીજનો ઉપયોગ કરવો જોઈએ. વાવેતર માટે ઉપયોગમાં લેવામાં આવતા બિયારણ ઘણી વખત બીજ અશુદ્ધિઓથી ભરેલા હોઈ શકે છે અને દર…
ચોમાસું પાકોમાં ખાતરની યોગ્ય વ્યવસ્થા કરો
વર્તમાન સમયમાં આધુનિક ખેતી પદ્ધતિમાં ટૂંકાગાળામાં વધુ ઉત્પાદન આપતા પાકોની જાતો તેમજ ઘનિષ્ટ ખેતી પદ્ધતિ દ્વારા એકમ વિસ્તારમાં વર્ષમાં એક કરતાં વધારે વખત પાકોનું વાવેતર…
આધુનિક ટેકનોલોજી અપનાવો અને મેળવો સ્વીટ કોર્નનું વિપુલ ઉત્પાદન
મકાઈ એ વિશ્વના લગભગ તમામ દેશોમાં ઉગાડવામાં આવતો પાક છે. તે વિશ્વના કુલ ખાદ્ય ઉત્પાદનમાં ત્રીજા ભાગ કરતાં વધુ યોગદાન આપે છે. વિશ્વના કુલ મકાઈ…
કુદરતી ખેતીનું સુરત મોડેલ સમગ્ર દેશ માટે રોલ મોડેલરૂપ બનશે: પ્રધાન મંત્રી નરેન્દ્ર મોદી
પ્રધાનમંત્રી શ્રી નરેન્દ્ર મોદીએ વીડિયો કોન્ફરન્સ મારફતે કુદરતી કૃષિ સંમેલનને સંબોધિત કર્યું હતું. ગુજરાતના સુરત શહેરમાં આયોજિત આ કોન્ક્લેવમાં હજારો ખેડૂતો અને અન્ય તમામ હિતધારકોએ…
Top 5 Government Jobs of the Day: નાબાર્ડ, ઇલેક્ટ્રિસિટી ડિપાર્ટમેન્ટ, સેબી, સેના અને MDL માં નીકાળી નોકરીઓ, જલ્દી કરો અરજી
દેશના ટોચના સરકારી વિભાગ નાબાર્ડ, પંજાબ સ્ટેટ પાવર અને અન્ય 5 વિભાગોએ ક્લાર્કથી લઈ અધિકારીઓની જગ્યાઓ માટે ભરતી નીકાળી છે, તો આ માટે સંપૂર્ણ સમાચાર…
બરફ જેવા દેખાતા આ ફળની ખેતી કરીને બમ્પર નફો મેળવી શકે છે ખેડૂતો
Ice Apple Farming: ખેતીમાં વધુ નફો મેળવવા માટે ખેડૂતો વિવિધ પાકની ખેતી તરફ વળ્યા છે. તાડગોલા પણ આમાંથી એક પાક છે. બરફ જેવું લાગતું આ…
Expensive Wood :કરોડોમાં વેચાય છે આ અમૂલ્ય લાકડું, દરેક વ્યક્તિ નથી ઉગાડી શકતા તેનું ઝાડ
સમગ્ર ભારતમાં ચંદનની ખેતીને પ્રોત્સાહન આપવાની સાથે સાથે, આજીવિકાની તકો પર ધ્યાન કેન્દ્રિત કરવામાં આવે છે. આ સાથે ખેડૂતોને ખેતીની આવકનું સ્તર વધારવા માટે વર્તમાન…
MSP માટે મોદી સરકારે કમિટીની કરી રચના, સંયુક્ત કિસાન મોરચાના 3 સભ્યો પણ થશે સામેલ
એક મોટો નિર્ણય લેતા કેન્દ્ર સરકારે MSP પેનલની રચના કરી છે. આ સમિતિમાં સંયુક્ત કિસાન મોરચાના ત્રણ સભ્યોનો પણ સમાવેશ કરવામાં આવશે. વડા પ્રધાન નરેન્દ્ર…
PM Kisan Yojana: સમયમર્યાદા પૂરી થવા જઈ રહી છે, પ્રધાનમંત્રી સન્માન નિધિનો 12મો હપ્તો મેળવવા ખેડૂતોએ તાત્કાલિક કરવું જોઈએ આ કામ
PM Kisan Yojana: ખેડુતોની આવક વધારવા માટે સરકાર સતત પ્રયાસ કરી રહી છે. આ માટે કેન્દ્ર અને રાજ્ય સરકારો અવાર નવાર ખેડુતલક્ષી યોજનાઓ બહાર પાડતી…
Online Shopping of Crops : પાકની ઓનલાઈન હરાજી શરૂ, ખેડૂતો અને વેપારીઓને થશે વધુ ફાયદો
ખેડૂત ભાઈઓની આવક વધારવા માટે સરકાર અને અનેક સંસ્થાઓ તેમને દરેક રીતે મદદ કરવા તૈયાર છે. આ ક્રમમાં હવે ખેડૂતો તેમના પાકની સારી કિંમત મેળવવા…
સસ્તું પેટ્રોલ અને ડીઝલ આપવા માટે મોદી સરકાર લઈ શકે છે આ પગલું
સરકારે ગ્રાહકોને સસ્તું પેટ્રોલ અને ડીઝલ આપવા માટે કવાયત તેજ કરી છે. ક્રૂડ ઓઈલના આંતરરાષ્ટ્રીય ભાવમાં ઘટાડાનો ફાયદો ઓઈલ માર્કેટિંગ કંપનીઓએ દેશના ગ્રાહકો સુધી પહોંચાડ્યો…
નોન વૂવન બેગનો કારોબાર અપનાવો અને પોલિથિનના વૈકલ્પિક કારોબારથી મેળવો લાખોની કમાણી
ભારતમાં 1લી જુલાઈથી સિંગલ યુઝ પ્લાસ્ટિક એટલે કે પોલિથીન બેગ અને પ્લાસ્ટિકની બનેલી અન્ય ઘણી પ્રકારની વસ્તુઓના ઉત્પાદન અને વેચાણ પર સંપૂર્ણપણે પ્રતિબંધ મુકવામાં આવ્યો…
Pusa Foundation Day: ઉજવામાં ઉજવાયો પુસાનો 94મો સ્થાપના દિવસ, વાંચો સંપૂર્ણ સમાચાર
16 જુલાઈ 2022 ના રોજ કૃષિ વિજ્ઞાન કેન્દ્ર ઉજવા દિલ્હી દ્વારા ભારતીય કૃષિ સંશોધન પરિષદ, પુસા, નવી દિલ્હી (કૃષિ અને ખેડૂત કલ્યાણ મંત્રાલય, ભારત સરકાર)…
PM Kusum Yojana: ખેડૂતો માટે સોલર પંપ પર 60% સુધી સબસિડી, આ રીતે કમાઈ શકો છો તમે નફો
Subsidy on Solar Pump: દેશમાં ચાલી રહેલા વીજ સંકટને કારણે પાકની સિંચાઈને પણ અસર થઈ રહી છે. તેની અસર પાકના ઉત્પાદન પર જોવા મળી રહી…
પાલકની આ જાતો વાવવાથી ખેડૂતો મેળવી શકશે બમ્પર ઉપજ
પાંદડાવાળા શાકભાજીની દૃષ્ટિએ આ સિઝન ખૂબ જ ખાસ છે. આ સિઝનમાં પાંદડાવાળા શાકભાજી ખૂબ જ ઝડપથી ખીલે છે અને જો થોડી કાળજી લેવામાં આવે તો…
જાણો ફળો પકવવાની નવી ટેકનિક, ખેડૂતોને થશે ફાયદો
ઝાડ પરથી તોડ્યા બાદ ફળો થોડા સમય માટે જ તાજા રહી શકે છે, ત્યારબાદ તે ધીમે ધીમે બગડવા લાગે છે, જો તેને સુરક્ષિત રાખવામાં ન…
ગાયના છાણ અને ગોળમાંથી બનાવો જીવામૃત, પાકની ગુણવત્તામાં થશે વધારો
સારા પાક માટે છોડને પોષણ મળતું રહે તે જરૂરી છે, જેના માટે સમયાંતરે ખેતરોમાં ખાતરનો છંટકાવ કરવામાં આવે છે, જેનાથી ખેતરોમાં જમીનની ગુણવત્તા સુધરે છે…
હેક્ટર, વિઘા કે એકર શેમાં આવે છે સૌથી વધારે જમીન, અહીં સમજો તેનું સંપૂર્ણ ગણિત
ખેતીની જમીન માપવાની ઘણી જુદી જુદી પદ્ધતિઓ છે. તમને જણાવી દઈએ કે દરેક રાજ્યમાં જમીનની માપણી અલગ અલગ રીતે કરવામાં આવે છે. જો શહેરની વાત…
Top 5 Expensive Tree Wood: 5 એવા વૃક્ષો, જેને વેચીને તમે બની જશો કરોડપતિ, જાણો ખાસિયત અને કિંમત
જો તમે ખેડૂત છો અને તમારી આવક બમણી કરવા માંગો છો, તો આ લેખ તમારા માટે ખૂબ જ ઉપયોગી સાબિત થઈ શકે છે. કારણ કે…
Cow Farming: આ જાતિની ગાયોના ઉછેરથી ખેડૂતો બની શકે છે સમૃદ્ધ
Cow Farming: ભારતના ગામડાઓમાં પશુપાલનનો વ્યવસાય આવકનો એક સારો સ્ત્રોત છે. અહીંના ખેડૂતો ગાય, ભેંસ અને બકરી ઉછેરમાંથી સારો નફો કમાય છે. મોટાભાગના પરિવારો ગાય…
કુદરતી ખેતીથી વાર્ષિક પાંચ લાખની કમાણી કરી રહ્યા છે અનિલ કુમાર, સેનામાંથી નિવૃત્ત થયા બાદ કર્યું આ કામ
ભારતીય સેનામાં 16 વર્ષ સુધી દેશની સેવા કર્યા બાદ હરિયાણાના ઝજ્જર જિલ્લાના ધાના ગામનો રહેવાસી અનિલ જ્યારે પોતાના ગામ પહોંચ્યો તો ખેતીની રીતો જોઈને આશ્ચર્યચકિત…
જાણો શું છે નકલી DAP ઓળખવાની રીત
પાકની વાવણીનો સમય ચાલી રહ્યો છે, તેવામાં ખેડૂતોને પાક માટે ખાતરની જરૂર પડે છે, ઘણીવાર સસ્તા ખાતરની લાલચમાં ખેડૂતો લાયસન્સ વિનાની દુકાનોમાંથી ખાતર ખરીદે છે…
ટામેટાંના ભાવમાં જોરદાર ઘટાડો પણ બટાકામાં હજુ પણ તેજી, જાણો શું છે મુદ્દો
મોંઘવારીથી ત્રસ્ત સામાન્ય માણસ માટે રાહતના સમાચાર છે. જૂનમાં ટામેટાની કિંમત 100 રૂપિયા પ્રતિ કિલો સુધી પહોંચી ગઈ હતી, પરંતુ હવે તેમાં નોંધપાત્ર ઘટાડો થયો…
જાણો સૌથી વધુ આવક કયો પાક આપે છે, ખેતી કરીને કેવી રીતે બની શકાય અમીર
સમગ્ર વિશ્વમાં ભારતને એક કૃષિ પ્રધાન દેશ તરીકે ઓળખવામાં આવે છે. દેશના વિવિધ સ્થળો પર અલગ-અલગ પ્રકારની ખેતી કરવામાં આવે છે. મોટાભાગના ખેડૂતો આજે પણ…
Profitable Farming: માત્ર 5 વર્ષમાં નીલગિરીની ખેતીથી થશે લાખોનું ટર્નઓવર, વધશે આવક
ભારતમાં લોકોની આજીવિકાનું સૌથી મહત્વપૂર્ણ રોજગાર અને સાધન ખેતી છે. આજના સમયમાં પણ ખેડૂતો ગ્રામ્ય વિસ્તારોમાં ખેતી કરે છે. આપણા દેશની જમીનમાં અનેક પ્રકારની ખેતી…
Coffee Cultivation: કોફીની ખેતી કરીને શરૂઆતથી જ કરો મોટી કમાણી, 50-60 વર્ષ સુધી થશે ફાયદો
સમગ્ર વિશ્વમાં કોફીનો વપરાશ દિવસેને દિવસે વધી રહ્યો છે. આલમ એ છે કે હવે ભારતમાં લોકો ચા કરતાં કોફીને વધુ પસંદ કરવા લાગ્યા છે. આવી…
આ ફળની ખેતી કરીને ખેડૂતો બની જશે કરોડપતિ, સરકાર આપી રહી છે 120000 રૂપિયા સુધીની સહાય
ખેડૂતોની આવક વધારવા માટે, કેન્દ્ર અને રાજ્ય સરકારો અવાર નવાર વિવિધ યોજનાઓ શરૂ કરતી રહે છે, આ દરમિયાન હરિયાણા સરકાર ખેડૂતોને ડ્રેગન ફ્રૂટની ખેતી કરવા…
Til Farming: ખેડૂતોની ગરીબી દૂર કરી શકે છે તલનો પાક, આ રીતે કમાવો બમ્પર નફો
Til farming: ભારતમાં તેલીબિયાં મોટા પાયે ઉગાડવામાં આવે છે. ઓછા સમયમાં ખેડુતોને આ સારો નફો આપે છે. મોટાભાગે તલનો ઉપયોગ તેલ બનાવવા માટે થાય છે.…
e-NAM POP: આ પ્લેટફોર્મથી અન્ય રાજ્યોમાં થશે પાકનું વેચાણ, 3 લાખ ખેડૂતોને થશે ફાયદો
e-NAM POP: કેન્દ્ર સરકારે ખેડૂતોને મોટી ભેટ આપી છે. કેન્દ્ર સરકારે નેશનલ એગ્રીકલ્ચરલ માર્કેટ (e-NAM) હેઠળ પ્લેટફોર્મ ઓફ પ્લેટફોર્મ (POP) લોન્ચ કર્યું છે.…
PM Kisan Yojana: પીએમ કિસાન યોજનાની રકમ મૃતકોના ખાતામાં મોકલવામાં આવી, હવે આ રીતે વસૂલ કરવામાં આવશે
પ્રધાનમંત્રી કિસાન સન્માન નિધિ યોજના હેઠળ દર વર્ષે ખેડૂતોને 6 હજાર રૂપિયાની રકમ આપવામાં આવે છે. આ રકમ તેમના ખાતામાં દર ચાર મહિનાના અંતરે બે-બે…
Free Electricity: હવે આ રાજ્યમાં મળશે મફત વીજળી, દર મહિને 1 રૂપિયામાં મળશે 1 કિલો ગ્રામ દાળ
Jharkhand cabinet decesion: સામાન્ય જનતાને રાહત આપવા માટે રાજ્ય સરકાર દ્વારા બજેટમાં આપવામાં આવેલા વચનોને કેબિનેટે મંજૂરી આપી છે.…
ડુંગળી અને લસણની છાલને ડસ્ટબિનમાં ફેંકવાની ન કરો ભૂલ, તેનાથી મળે છે 6 અદ્ભુત ફાયદા
Onion and Garlic Peels: લોકો ઘણીવાર લસણ અને ડુંગળીની છાલના ફાયદાઓથી અજાણ હોય છે. પરંતુ તમારે આ ભૂલ ન કરવી જોઈએ અને સમયસર જાણવું જોઈએ…
કારેલા ખાવાથી થાય છે આ ગંભીર રોગોનુ નિયંત્રણ, આ છે તેનું સેવન કરવાની સાચી રીત
કારેલાના ફાયદા: કારેલાનું નામ સાંભળતા જ લોકો સંકોચવા લાગે છે કારણ કે તેનો સ્વાદ ખૂબ જ કડક અને તીખો હોય છે. પરંતુ તે સ્વાસ્થ્ય માટે…
શું કેન્દ્ર સરકાર સપ્ટેમ્બર પછી મફત રાશનનું વિતરણ બંધ કરશે?
રાજ્યમાં પ્રધાનમંત્રી ગરીબ કલ્યાણ અન્ન યોજના (PMGKAY) હેઠળ મફત રાશનનું વિતરણ ઉત્તર પ્રદેશ વિધાનસભા ચૂંટણીમાં ભાજપની જીતનું મુખ્ય કારણ માનવામાં આવતું હતું.…
7 હેક્ટરમાં ખજૂરની ખેતી કરીને કમાઓ કરોડો રૂપિયા, જાણો આ ટેકનિક વિશે સંપૂર્ણ માહિતી
તમે ઘણીવાર સાંભળ્યું હશે કે ખેતી-કિસાની એ ખોટનો સોદો છે, પરંતુ તમને જણાવી દઈએ કે રાજસ્થાનના કેહરારામ ચૌધરીએ આ કહેવતને ખોટી સાબિત કરી બતાવી છે.…
ખેડૂતોની મહેનત અને વૈજ્ઞાનિકોના યોગદાનથી થયુ રેકોર્ડ ઉત્પાદન - નરેન્દ્રસિંહ તોમર
કૃષિ અને ખેડૂત કલ્યાણ મંત્રાલયે રાજ્યો/કેન્દ્રશાસિત પ્રદેશો અને અન્ય સરકારી સ્ત્રોત એજન્સીઓ પાસેથી મળેલી માહિતીના આધારે સંકલિત 2021-22 માટે વિવિધ બાગાયતી પાકોના વિસ્તાર અને ઉત્પાદનના…
હવે ખેડૂતોને મળશે 90 કૃષિ મશીન પર 40 થી 80 ટકા સબસિડી, જાણો સંપૂર્ણ માહિતી
90 કૃષિ મશીનો પર ગ્રાન્ટની રકમ દેશના ખેડૂતોની સમૃદ્ધિ માટે કેન્દ્ર સરકાર અને રાજ્ય સરકાર અનેક ઉત્તમ યોજનાઓ ચલાવતી રહે છે, જેથી તેઓ તેમની ખેતીમાંથી…
Amla Gardening: કૃષ્ણ, કંચન, નરેન્દ્ર અને ગંગા બનારસી જાતો સાથે કરો આમળાની બાગાયત, તમને બમ્પર ઉપજ મળશે
કોરોના સમયગાળા દરમિયાન, હર્બલ ઉત્પાદનોની માંગ માત્ર ભારતમાં જ નહીં પરંતુ વિદેશમાં પણ ઘણી વધી ગઈ છે. લોકો તેમની રોગપ્રતિકારક શક્તિ વધારવા અને ત્વચાને સ્વસ્થ…
Amla Gardening: કૃષ્ણ, કંચન, નરેન્દ્ર અને ગંગા બનારસી જાતો સાથે કરો આમળાની બાગાયત, તમને બમ્પર ઉપજ મળશે
કોરોના સમયગાળા દરમિયાન, હર્બલ ઉત્પાદનોની માંગ માત્ર ભારતમાં જ નહીં પરંતુ વિદેશમાં પણ ઘણી વધી ગઈ છે. લોકો તેમની રોગપ્રતિકારક શક્તિ વધારવા અને ત્વચાને સ્વસ્થ…
દેશભરમાં ખેડૂતો કરશે મલેરિયા વિરોધી છોડની ખેતી, પ્રતિ હેક્ટર લગભગ 65 હજાર રૂપિયાનો નફો
Artemisia cultivation: દર વર્ષે દેશભરમાં હજારો લોકો મેલેરિયાથી મૃત્યુ પામે છે. આવી સ્થિતિમાં મલેરિયાને જડમૂળથી ખતમ કરવા માટે ઉત્તર પ્રદેશ સરકારે એક યોજના તૈયાર કરીને…
ખેડૂત પિતાની મુશ્કેલી જોઈને 10માની વિદ્યાર્થીનીએ બનાવી એપ, PM મોદીએ પણ કરી પ્રશંસા
ઉત્તર પ્રદેશના લલિતપુર જિલ્લાના મેહરૌની તાલુકામાં રહેતી 10માં ધોરણની વિદ્યાર્થીની નંદિની કુશવાહાએ કંઈક એવું કર્યું છે જેની વડા પ્રધાન નરેન્દ્ર મોદી પણ પ્રશંસા કરી રહ્યા…
IILના મેનેજિંગ ડિરેક્ટર રાજેશ અગ્રવાલે જંતુનાશકોની ઉપયોગિતા અંગે આપી સલાહ
એગ્રો-કેમિકલ કંપની ઈન્સેક્ટીસાઈડ્સ ઈન્ડિયા લિમિટેડ (IIL) ના મેનેજિંગ ડિરેક્ટર રાજેશ અગ્રવાલે આજે કૃષિ જાગરણ ચૌપાલમાં હાજરી આપી હતી. આ દરમિયાન તેમણે ખેડૂતોના કલ્યાણને લગતા ઘણા…
કેવી રીતે 'કેન્ડી લેક' જંગલમાંથી તળાવમાં થયુ પરિવર્તિત
કઝાકિસ્તાનના સાતી ગામમાં કેન્ડી નામનું એક બહુ મોટું તળાવ છે, આ તળાવની સુંદરતા જોઈને લોકો હતપ્રત થઈ જાય છે, હકીકતમાં આ તળાવની અંદર એક આખું…
IMD Rainfall Alert: ઉત્તર ભારતના આ રાજ્યોમાં 4-5 દિવસ સુધી વરસાદની આશંકા, આ પાકને થઈ શકે છે નુકસાન
જૂન મહિનામાં સામાન્ય કરતાં ઓછા વરસાદને કારણે ખેડૂતો ચોમાસાની આતુરતાપૂર્વક રાહ જોઈ રહ્યા હતા. ચોમાસાએ દસ્તક દીધી, પરંતુ તે ઘણા રાજ્યો માટે આફત તરીકે પણ…
Coloured Rice Cultivation: રંગીન ચોખાની ખેતીથી ખેડૂત થયો માલામાલ, જાદુઈ ચોખામાં પણ મોટી કમાણી
Coloured Rice Cultivation: ખેતીમાં રોજ નવા પ્રયોગો થઈ રહ્યા છે. જેનો લાભ પણ ખેડૂતોને થઈ રહ્યો છે. ચંપારણના રામનગર બ્લોકની સોહસા પંચાયતમાં પણ કંઈક આવું…
ખેડૂતોને આત્મનિર્ભર બનાવવા તેમજ કૃષિ ક્ષેત્રના વિકાસ માટે ખાનગી રોકાણ જરૂરી - નરેન્દ્રસિંહ તોમર
કેન્દ્રીય કૃષિ અને ખેડૂત કલ્યાણ મંત્રી નરેન્દ્ર સિંહ તોમરે કહ્યું છે કે કેન્દ્ર સરકાર ખેડૂતોને આત્મનિર્ભર બનાવવા માટે સતત પ્રયાસો કરી રહી છે.આ દિશામાં ઘણી…
બજારમાં ફૂલકોબીની કિંમતમાં થયો ઘટાડો, જાણો તેની હાલની કિંમત
છેલ્લા કેટલાક સમયથી દેશમાં સતત વધી રહેલી મોંઘવારીથી લોકો પરેશાન છે અને આજના મોંઘવારીના યુગમાં 'સખી સન્યા તો બહુ હી કામત હૈ મોંઘવારી ડાયન ખાયે…
અમિત શાહે નવી દિલ્હીમાં છઠ્ઠા રાષ્ટ્રીય ખાણ અને ખનીજ સંમેલનમાં સંબોધન આપ્યું
શ્રી નરેન્દ્ર મોદી 2014માં પ્રધાનમંત્રી બન્યા ત્યારથી આજદિન સુધીમાં મોદી સરકારે હંમેશા ખાણ, ખનીજ અને કોલસા ક્ષેત્રને પ્રાથમિકતાનું ક્ષેત્ર માન્યું છે. દેશનો વિકાસ ખાણકામ ક્ષેત્ર…
Ashoka Stambh : શું નવા સંસદ ભવન પર રાષ્ટ્રીય પ્રતીકના સિંહો સારનાથના સિંહો કરતા અલગ છે? દાવાઓ જુઓ
નવી દિલ્હી, 13 જુલાઇ: નવા સંસદ ભવનમાં સ્થાપિત નવું રાષ્ટ્રીય પ્રતીક (National Emblem) હાલ ચર્ચાનો વિષય બની ગયો છે.…
ACFIના ડાયરેક્ટર કલ્યાણ ગોસ્વામીએ કેજે ચૌપાલમાં આપી હાજરી, અનેક મહત્વપૂર્ણ મુદ્દાઓ પર ચર્ચા કરી
કૃષિ જાગરણની ચૌપાલમાં આજે એગ્રો કેમ ફેડરેશન ઓફ ઈન્ડિયાના ડાયરેક્ટર જનરલ કલ્યાણ ગોસ્વામીએ પોતાના વિચારો વ્યક્ત કરતાં ખેડૂતોને ઘણી મહત્વની બાબતો વિશે જણાવ્યું હતું.…
ખેડૂતોએ ખેતરમાં બંધ કરી દીધું ડાંગર રોપવાનું, કારણ જાણીને હેરાન થઈ જશો
આ સમયે વરસાદના અભાવે મોટાભાગના ખેડૂતોના ખેતરો સુકાઈ જવાના આરે આવી ગયા છે. જેના કારણે ખેડૂત ભાઈઓએ ખરીફની ખેતી બંધ કરવી પડી છે.…
Dragon Fruit Farming: બિહારના ખેડૂતો ડ્રેગન ફ્રૂટની ખેતી કરીને કમાઈ રહ્યા છે મબલખ કમાણી
Dragon Fruit Farming: બિહારના મોતિહારીના કેટલાક યુવા ખેડૂતોએ પરંપરાગત ખેતી છોડીને હવે નવી પદ્ધતિથી ખેતીની શરૂઆત કરી છે. આ યુવાનોને ખેતીના આ નવા સ્ટાર્ટઅપથી ઘણો…
Dragon Fruit Farming: બિહારના ખેડૂતો ડ્રેગન ફ્રૂટની ખેતી કરીને કમાઈ રહ્યા છે મબલખ કમાણી
Dragon Fruit Farming: બિહારના મોતિહારીના કેટલાક યુવા ખેડૂતોએ પરંપરાગત ખેતી છોડીને હવે નવી પદ્ધતિથી ખેતીની શરૂઆત કરી છે. આ યુવાનોને ખેતીના આ નવા સ્ટાર્ટઅપથી ઘણો…
લીમડામાંથી બનાવેલ જંતુનાશક દવાથી ખેડૂતોને બમણો નફો મળશે
Neem made Organic Insecticides and Pesticides: ખેડૂતો સૌથી વધુ પરેશાન થાય છે જ્યારે તેમના પાકમાં જીવાતોનો ચેપ લાગે છે. આવી સ્થિતિમાં ખેડૂતો રાસાયણિક જંતુનાશકો (chemical…
જર્બેરા ફૂલની ખેતીથી તમે લાખો રૂપિયાની કમાણી કરી શકો છો, 1 વાર રોપતા 3 વર્ષ સુધી લાગે છે ફૂલ, જાણો કેવી રીતે
ભારતમાં, ખેડૂતો મોટાભાગે પરંપરાગત પાક જ ઉગાડે છે. પરંતુ આજના સમયમાં પરંપરાગત પાકોમાં ઓછો નફો મળવાથી લોકોનો મોહભંગ થઈ રહ્યો છે અને ખેડૂતો એવા પાકો…
ભારતમાં ઝડપથી વિકસતા ફળોના ઝાડ અને તેના શું ફાયદા મળે છે તે જાણો
મોટાભાગના છોડને ફળ આવવામાં લાંબો સમય લાગે છે, પરંતુ કેટલાક ફળના છોડ ખૂબ જ ઝડપથી વિકસે છે. તે વાવેતરના થોડા મહિનામાં જ ફળ આપવાનું શરૂ…
Subsidy on Agricultural Machinery: ખેતીના કયા મશીનો પર કેટલી સબસિડી મળશે, જાણો આ મોબાઈલ એપથી
આજના સમયમાં કૃષિ યંત્રો વિના ખેતીની કલ્પના કરી શકાતી નથી. કૃષિ યંત્રોના આવવાથી ખેડૂતો માટે ખેતી કરવી પહેલા કરતા ઘણી સરળ બની ગઈ છે.…
બ્રહ્માંડ કેવું દેખાય છે? નાસાના જેમ્સ વેબ સ્પેસ ટેલિસ્કોપમાંથી "બ્રહ્માંડનું પ્રથમ રંગીન ચિત્ર".
જેમ્સ વેબ ટેલિસ્કોપ એ અત્યાર સુધી અવકાશમાં લોન્ચ કરાયેલા સૌથી શક્તિશાળી ટેલિસ્કોપમાંનું એક છે. નાસાના ડેપ્યુટી એડમિનિસ્ટ્રેટર પામ મેલરોયના નિવેદન અનુસાર, મિશનમાં 20 વર્ષ સુધી…
Maharashtra Rain: ભારે વરસાદને કારણે ગઢચિરોલીમાં 5 લોકોના મોત, CM અને ડેપ્યુટી સીએમએ વિદર્ભ વિસ્તારની લીધી મુલાકાત
Maharashtra Rain Deaths: મહારાષ્ટ્રમાં 1 જૂનથી ભારે વરસાદને કારણે 83 લોકોના મોત થયા છે, જ્યારે 64 લોકો ઘાયલ થયા છે. આ ભારે વરસાદમાં અત્યાર સુધીમાં…
ભારત ટકાઉ કૃષિ દેશ બની શકે છે: રાજુ કપૂર, કોર્પોરેટ અફેર્સ ડિરેક્ટર, FMC ઇન્ડિયા
એફએમસી કોર્પોરેશનની ભારતીય પેટાકંપની અને ફિલાડેલ્ફિયા યુએસએ સ્થિત વૈશ્વિક કૃષિ અગ્રણી FMC ઇન્ડિયા સાથેના ઉદ્યોગ અને જાહેર બાબતોના કોર્પોરેટ અફેર્સ ડિરેક્ટર રાજુ કપૂરે ભારતમાં ટકાઉ…
ઘઉંને સ્ટોરેજમાં રાખવા માટે યોગ્ય સ્થિતિ કઈ હોવી જોઈએ જેથી કરીને જંતુઓની ઝપટમાં ન જાય
ઘઉંને સ્ટોરેજમાં રાખવા માટે યોગ્ય સ્થિતિ શું હોવી જોઈએ જેથી જંતુઓનો ઉપદ્રવ ન સર્જાય…
સારા ઉત્પાદન માટે બિયારણને લગતી આ કાળજી હવે વિશેષ જરૂરી બની છે
કૃષિ ભારતીય અર્થતંત્રમાં અગ્રણી સ્થાન ધરાવે છે. છેલ્લા 70 વર્ષોમાં કૃષિ માટે વપરાતી ખેતીની જમીનનો વિસ્તાર ઘટ્યો છે, પરંતુ કૃષિ ઉત્પાદનમાં પાંચ ગણાથી વધુ વધારો…
ઓછી જમીનની સ્થિતિમાં દીવાલો બાંધીને ખેતીની ઇઝરાયેલી ટેક્નોલોજીથી મોટો નફો મેળવી શકાય છે
વધતા જતા શહેરીકરણ અને પ્રદુષણને કારણે ખેતીલાયક જમીન ઘટી રહી છે. આ ઉપરાંત ઉપલબ્ધ ખેતીલાયક જમીન પણ જોખમી રસાયણોથી નુક્શાન પામી રહી છે. વસ્તી સતત…
સંયુક્ત રાષ્ટ્રનો નવો રિપોર્ટ ભારત માટે ચિંતાનું કારણ બન્યો, 2023 સુધીમાં ભારતની વસ્તી ચીન કરતા પણ વધી શકે છે
વધતી જતી જનસંખ્યા ભારત માટે ચિંતાનો વિષય બની રહે છે, વસ્તીને નિયંત્રિત કરવા માટે વિશ્વ વસ્તી દિવસ પર લોકોને કરવામાં આવ્યા હતા જાગૃત, સંયુક્ત રાષ્ટ્રના…
પ્રુથ્વીનુ કલ્પ પાક એટલે કઠોળ, શું છે તેની વિશેષતા તે જાણો
યુનાઈટેડ નેશન્સ (યુએન) એ વર્ષ ૨૦૧૬ ને આંતરરાષ્ટ્રીય કઠોળ વર્ષ તરીકે જાહેર કર્યું હતુ. વર્ષ ૨૦૧૯ થી કઠોળના મહત્વ વિશે જાગૃતિ લાવવા માટે ૧૦ ફેબ્રુઆરીએ…
આગામી 5 દિવસ સુધી ભારે વરસાદ પડશે, હવામાન વિભાગે આ રાજ્યો માટે આ ચેતવણી જારી કરી છે
Rainfall Alert, IMD Prediction: મહારાષ્ટ્ર સહિત દેશના અનેક રાજ્યોમાં સતત પડી રહેલા વરસાદને કારણે સ્થિતિ વણસી રહી છે. હવામાન વિભાગ દ્વારા આપવામાં આવેલી નવીનતમ માહિતી…
બેંગ્લોરના શ્રીનિવાસ ગધેડીના દૂધમાંથી લીટર દીઠ રૂપિયા 5000ની કમાણી કરે છે
કૃષિ ઉદ્યોગ એક એવું ક્ષેત્ર છે કે જ્યાં ઘરે બેસી કામ કરી શકાતું નથી. તેના માટે દરરોજ માનસિક અને શારીરિક પ્રયત્નો સાથે સતત તકેદારી અને…
KCRએ ફરી પીએમ મોદીની કરી ટીકા, કહ્યું- કેન્દ્ર સરકાર લોકશાહીમાં નથી માનતી, તાનાશાહીમાં માને છે
તેલંગાણાના મુખ્યમંત્રી કે.ચંદ્રશેખર રાવે ફરી એકવાર વડાપ્રધાન નરેન્દ્ર મોદી પર આકરા પ્રહારો કર્યા છે.…
KCRએ ફરી પીએમ મોદીની કરી ટીકા, કહ્યું- કેન્દ્ર સરકાર લોકશાહીમાં નથી માનતી, તાનાશાહીમાં માને છે
તેલંગાણાના મુખ્યમંત્રી કે.ચંદ્રશેખર રાવે ફરી એકવાર વડાપ્રધાન નરેન્દ્ર મોદી પર આકરા પ્રહારો કર્યા છે.…
Fish-Rice Farming:માછલી-ભાતની ખેતી તમને બનાવશે ધનવાન, બસ કરવું પડશે આ કામ
ચોખા, એક મહત્વપૂર્ણ અનાજ છે, જે વિશ્વની લગભગ અડધી વસ્તીનુ પેટ ભરે છે. ચોખાનો પાક એક મહત્વપૂર્ણ પાક તરીકે જાણીતો છે, જે ઉપલબ્ધ જળ સંસાધનોના…
નવી સર્વપક્ષીય સરકારની રચના અંગે ચર્ચા કરવા ટૂંક સમયમાં વિપક્ષની બેઠક, રાષ્ટ્રપતિ ગોટબાયાના ઘરે કરોડો રૂપિયા મળ્યા
વિરોધીઓના ઉગ્ર પ્રદર્શનને જોતા, રાષ્ટ્રપતિ ગોટબાયાએ 13 જુલાઈએ તેમના રાજીનામાની જાહેરાત કરી છે. તે જ સમયે, પીએમ રાનિલ વિક્રમસિંઘેએ પણ સર્વપક્ષીય સરકાર બનાવવા માટે રાજીનામું…
શ્રીલંકા સંકટ પર વિદેશ મંત્રી એસ.જયશંકરનું નિવેદન, ત્યાં ફસાયેલા શરણાર્થીઓ વિશે આપી મોટી માહિતી
Sri Lanka Crisis: પાડોશી દેશ શ્રીલંકામાં ચાલી રહેલા વિરોધ પ્રદર્શનને લઈને વિદેશ મંત્રી ડૉ. એસ. જયશંકરનું નિવેદન સામે આવ્યું છે. તેમણે કહ્યું કે અમે શ્રીલંકાની…
Rural Business Idea: ગામડાં અને શહેરના લોકો એક જ વખતના રોકાણમાં શરૂ કરે આ વ્યવસાય, મેળવો 40 વર્ષ સુધી નફો
આજકાલ નોકરી દ્વારા કોઈની જરૂરિયાત પૂરી થતી નથી.આ જ કારણ છે કે લોકો નોકરીની સાથે બિઝનેસ તરફ વળી રહ્યા છે. આવી સ્થિતિમાં, અમે તમારા માટે…
દિલ્હીની જામા મસ્જિદમાં બકરી ઈદ પર નમાજ અદા કરવા માટે એકઠા થયા લોકો, જાણો શા માટે મનાવવામાં આવે છે ઈદ-ઉલ-અઝહા?
ઈદ-ઉલ-અદહા એ સુખ અને શાંતિનો પ્રસંગ છે, જે લોકો તેમના પરિવાર સાથે ઉજવે છે. આ સમય દરમિયાન તેઓ જૂની ફરિયાદોને ભુલીને એકબીજા સાથે વધુ સારા…
માલામાલ કરી દેશે આ વૃક્ષની ખેતી, થોડા વર્ષોમાં બની જશો કરોડપતિ
Sagwan Farming Cost and Profit: ઓછા ખર્ચમાં વધુ નફો મળવાને કારણે સરકાર ખેડૂતોને સાગના ઝાડની ખેતી કરવાની સલાહ આપે છે. તેના લાકડાની ગણતરી સૌથી મજબૂત…
ખેડૂતો માટે ફાયદાકારક છે આ ટેક્નોલોજી, વર્ષ દરમિયાન થશે મોટી કમાણી
નવીન તકનીકોને કારણે, બાગાયત કરતા ખેડૂતોને ઘણો નફો મળી રહ્યો છે, જે સાબિત કરે છે કે ખેડૂતો બાગાયતી પાક ઉગાડીને જ તેમની આવકમાં વધારો કરી…
પીએમ કિસાન યોજનાઃ આ લોકોએ પરત કરવા પડશે પીએમ કિસાન યોજનાના પૈસા, ચેક કરી લો યાદીમાં તમારું નામ તો નથી..
પીએમ કિસાન સન્માન નિધિ યોજના (PM Kisan Samman Nidhi Yojana) હેઠળ, 11મો હપ્તો 31 મે 2022ના રોજ ખેડૂતોના ખાતામાં મોકલવામાં આવ્યો છે. ખેડૂતો હવે 12મા…
નાઇજર ફાર્મિંગ: દૂધાળા પશુઓ માટે ઉત્તમ ખોરાક
ખાસ કરીને દૂધાળા પશુઓ માટે નાઈજર સીડ કેક એ ગાયનો એક સારો ખોરાક છે. ફ્લેક્સસીડ કેકને વાછરડાના ખોરાકમાં નાઇજર ભોજન દ્વારા બદલી શકાય છે, જેમાં…
તમારા ઘરની હવાને શુદ્ધ તથા તાજી રાખે છે આ એર પ્યુરિફાયર પ્લાન્ટ્સ
જો તમે તમારા ઘરમાં ગાર્ડનિંગ કરો છો તો તમારા માટે એ જાણવું ખૂબ જ જરૂરી છે કે તમે ઘરમાં જે છોડ ઉગાડો છો તે હવાને…
અમરનાથ ગુફાથી 2 કિમી દુર વાદળ ફાટ્યુ, 16 લોકોના મોત નિપજ્યા, 40 લોકો હજુ સુધી લાપતા
મહારાષ્ટ્રના રહેવાસી સુમીતે જણાવ્યું કે, "વાદળ ફાટવાના કારણે આવેલા પૂરમાં મોટી સંખ્યામાં પથ્થરો આવ્યા હતા. અમે વાદળ ફાટવાના સ્થળથી બે કિલોમીટર દૂર હતા."…
ઘરે ઓર્ગેનિક શાકભાજી ઉગાડવાની સરળ રીત, જાણો આ લેખમાં આ વિધિ
શાકભાજી એ આપણા જીવનનો ખૂબ જ મહત્વપૂર્ણ ભાગ છે, તેના વિના આપણું જીવન આગળ વધી શકે નહીં. પરંતુ જેમ જેમ વસ્તી વધતી ગઈ તેમ તેમ…
તાજમહેલ પ્રેમીઓ બકરી ઈદ પર કરી શકશે મફતમાં પ્રવેશ, જાણો સંપૂર્ણ સમાચાર
તાજમહેલ જોવાના શોખીન લોકો માટે એક સારા સમાચાર સામે આવ્યા છે. 10 જુલાઈ એટલે કે રવિવારે તાજમહેલમાં પ્રવેશ ફ્રી થવાનો છે, સવારે 7 વાગ્યાથી 10…
ખેતર બળી ગયું, છતાં હાર ન માની, બિહારની આ મહિલાએ મશરૂમની ખેતી કરીને કર્યો બમણો નફો
દેશમાં ખેડૂતોમાં મશરૂમની ખેતીની લોકપ્રિયતા વધી છે. ખેડૂતો મશરૂમની ખેતી કરીને ઓછા સમયમાં સારો નફો કમાઈ રહ્યા છે. અમે તમને એવી જ એક મહિલા ખેડૂતની…
Lotus Cultivation: કમળની ખેતી કરવાની આ પદ્ધતિ અપનાવવાથી તમે પણ બની જશો માલામાલ
આજના સમયમાં ખેતી અમુક પાક પુરતી મર્યાદિત રહી નથી. આજે ખેડુતો વિવિધ પાકો ઉગાડી પોતાનુ નસીબ અજમાવી રહ્યા છે. ત્યારે કમળનુ ફુલ તો તમે જોયુ…
ગંભીર રોગો સામે અસરકારક છે કાઠીયા ઘઉં , ODOP માં સમાવેશ કરવાની ઉઠી માંગ
કાઠીયા ઘઉં : ઉત્તર પ્રદેશના બુંદેલખંડમાં ઉગાડવામાં આવતા કાઠીયા ઘઉં સમગ્ર ભારતમાં પ્રખ્યાત છે. અહીંના ખેડૂતો ઓર્ગેનિક રીતે તેની ખેતી કરે છે. લોકો આ ઘઉંનો…
જાપાન અને વિશ્વએ એક મહાન સ્વપ્નદૃષ્ટા ગુમાવ્યા છે. અને, મેં એક પ્રિય મિત્ર ગુમાવ્યો છે:પીએમ મોદી
શિન્ઝો આબે – જાપાનના એક ઉત્કૃષ્ટ નેતા, મહાન વૈશ્વિક રાજનેતા અને ભારત-જાપાન વચ્ચે મિત્રતાના મહાન ચેમ્પિયન - હવે આપણી વચ્ચે નથી. જાપાન અને વિશ્વએ એક…
પશુ ચિકિત્સામાં આયુર્વેદ દવાઓના ઉપયોગની વિચારણા : કેન્દ્રીય મત્સ્યોદ્યોગ, પશુપાલન અને ડેરી મંત્રી શ્રી પરશોત્તમ રૂપાલા
પશુઓના ડોક્ટર્સને પણ માન-સન્માન આપો તેને ઢોરના ડોક્ટરની ઉપમા ન આપો…
જાપાનના 'દેશી કટ્ટા'થી પૂર્વ PM શિન્ઝો આબેની હત્યા કરવામાં આવી, જાણો કેવી રીતે તૈયાર કરવામાં આવી હતી ગન
જાપાનના પૂર્વ વડાપ્રધાન શિન્ઝો આબેની જે બંદૂકથી હત્યા કરવામાં આવી હતી તે દેશી બનાવટની પિસ્તોલ છે. જેને હત્યારાએ તેના ઘરે જ બનાવી હતી. જાપાનમાં હથિયારોને…
ટીશ્યુ કલ્ચરમાંથી તૈયાર કરેલા છોડમાંથી કેળાની ખેતી કરો, જાણો આ પદ્ધતિ વિશે
અમે તમને કેળાની આધુનિક ખેતી વિશે જણાવી રહ્યા છીએ, જેનાથી તમે ઓછા સમયમાં વધુ નફો મેળવી શકો છો. આપણા દેશમાં કેળાની 500 થી વધુ જાતો…
સરકારી શાળાઓમાં ફળોના બગીચા સ્થાપવાની તૈયારીઓ, બનશે આવકનું સાધન
પંજાબના આમ આદમી પાર્ટીના મુખ્યમંત્રી ભગવંત સિંહ માન (Bhagwant Mann) ની આગેવાની હેઠળની રાજ્ય સરકારે રાજ્યમાં બાગાયતને પ્રોત્સાહન આપવા માટે રાજ્યની સરકારી શાળાઓમાં ફળોના વૃક્ષો…
પરષોત્તમ રૂપાલાએ ગરીબ ખેડૂતોને KCC જારી કરવાની પ્રગતિની સમીક્ષા કરવા કેન્દ્રીય નાણાં મંત્રી નિર્મલા સીતારામનની અધ્યક્ષતામાં બેઠકમાં હાજરી આપી
રૂપાલાએ બેંકો દ્વારા અનુપાલન માટેના પગલાં સૂચવ્યા કેન્દ્રીય મત્સ્યોદ્યોગ, પશુપાલન અને ડેરી મંત્રી શ્રી પરશોત્તમ રૂપાલાએ કેન્દ્રીય નાણા મંત્રી શ્રીમતી શ્રીમતીની અધ્યક્ષતામાં યોજાયેલી બેઠકમાં હાજરી…
હાથ ખર્ચ માટે મળશે આટલા પૈસા, બસ આપવા પડશે માત્ર આ 5 દસ્તાવેજ
બેરોજગારોને દર મહિને બેરોજગારી ભથ્થું આપવામાં આવે છે. કોઈપણ શિક્ષિત બેરોજગાર સરકારની આ યોજનાનો લાભ લઈ શકે છે.…
ખેડુત જરૂરથી કરે કેળાની ખેતી, થશે લાખોનો ફાયદો, જાણો વિસ્તૃતમાં
હાલમાં કેળા સારી આવકના પાક તરીકે ઉભરી આવ્યા છે, ખેડૂતો કેળાના પાકમાંથી લાખોની કમાણી કરી રહ્યા છે.…
પાક વીમા યોજના સપ્તાહમાં તજજ્ઞોએ ખેડૂતોને આપી જરૂરી સલાહ
કૃષિ જાગરણ દ્વારા શુક્રવાર, 7મી જુલાઈના રોજ "પાક વીમો: ખેડૂતોની આવકમાં જોખમ નાબૂદી" શીર્ષકવાળા લાઇવ વેબિનારનું આયોજન કરવામાં આવ્યું હતું.…
નીંદણ વ્યવસ્થાપનની વિવિધ પધતિઓ
ખેતી ની શરૂઆત થઈ ત્યારથી ખેડૂતોને મુઝવતો નીંદણનો પ્રશ્ન માત્ર ખેડૂતોનોજ પ્રશ્ન ન રહેતા માનવ સમાજનો પ્રશ્ન બની ગયેલ છે. જેવા કે માનવ જાતની તંદુરસ્તી…
PM Kisan Yojana: 12મા હપ્તાથી વંચિત ન રહેવું હોય તો ખેડૂતોએ આ કામ જરૂરથી કરી લે
PM Kisan Yojana :પ્રધાનમંત્રી કિસાન સન્માન નિધિ અંતર્ગત ખેડૂતોને દર વર્ષે 6 હજાર રૂપિયા આપવામાં આવે છે. આ રકમ દર ચાર મહિને રૂ. 2-2 હજારના…
ભારત અમૂર્ત સાંસ્કૃતિક વારસાની સુરક્ષા માટે યુનેસ્કોનાં 2003 સંમેલનની આંતરસરકારી સમિતિમાં ચૂંટાયું
ભારતને અમૂર્ત સાંસ્કૃતિક વારસાની સુરક્ષા માટે યુનેસ્કોનાં 2003 સંમેલનની આંતર સરકારી સમિતિના સભ્ય તરીકે 2022-2026 ચક્ર માટે ચૂંટવામાં આવ્યું છે. આંતરસરકારી સમિતિ માટેની ચૂંટણીઓ 5…
આ રીતે મરચાંની ખેતી કરો અને મેળવો વધુ ઉત્પાદન
મરચાની સફળ ખેતી માટે ગરમ અને ભેજવાળી આબોહવા શ્રેષ્ઠ છે. મરચાંની ખેતી માટે 20 થી 25 ડિગ્રી સેલ્સિયસ તાપમાન યોગ્ય માનવામાં આવે છે. 625 થી…
ABDMઅંતર્ગત આરોગ્ય સુવિધા રજિસ્ટ્રીમાં એક લાખ કરતાં વધારે સરકારી અને ખાનગી આરોગ્ય સંભાળ સુવિધાઓનું સફળતાપૂર્વક ઓનબોર્ડિંગ કરવામાં આવ્યું
રાષ્ટ્રીય આરોગ્ય સત્તામંડળ (NHA) દ્વારા તેમની મુખ્ય યોજના આયુષ્માન ભારત ડિજિટલ મિશન (ABDM)ની આરોગ્ય સુવિધા રજિસ્ટ્રીમાં એક લાખ કરતાં વધારે સરકારી અને ખાનગી આરોગ્ય સંભાળ…
પરશોત્તમ રૂપાલાએ ભારતની પ્રથમ એનિમલ હેલ્થ સમિટનું ઉદ્ઘાટન કર્યું
પરશોત્તમ રૂપાલાએ ભારતની પ્રથમ એનિમલ હેલ્થ સમિટનું ઉદ્ઘાટન કર્યું. રૂપાલાએ પશુધન ક્ષેત્રમાં સહકારી ચળવળને મજબૂત કરવાની જરૂરિયાત પર ભાર મૂક્યો…
દરિયાઈ માર્ગે અમેરિકા પહોંચી ભારતીય કેરીઓ, તેને સડવાથી બચાવવા BARCએ કર્યું આ કામ
મેસર્સ સનપ એગ્રોએનિમલ્સ પ્રાઈવેટ લિમિટેડે (Sanap Agroanimals Pvt. Ltd) પસંદગીની કેસર કેરીને દરિયાઈ માર્ગે વિદેશ મોકલવાની પહેલ કરી છે. 5 જૂને MSAMB ના મેનેજિંગ ડિરેક્ટર…
ખેતરના એક-એક ઇંચનો ઉપયોગ કરીને ગરીબ ખેડૂતો પણ બનશે સમૃદ્ધ, આ રીતે કરો સંકલિત ખેતી
જો ખેડૂતો એક જ જગ્યાએ ખેતી કરવા તેમજ બાગાયત, પશુપાલન, મરઘાં, મત્સ્યોદ્યોગ કરવાનું શરૂ કરે તો નફો અનેકગણો વધી શકે છે. એકસાથે એક જ ક્ષેત્રમાં…
ડાંગરની આ જાત એકર દીઠ 27 ક્વિન્ટલ ઉપજ આપશે, 115 દિવસમાં થશે તૈયાર
ખરીફ સિઝનમાં ખેડૂતો માટે ડાંગરની રોપણીનો સમય યોગ્ય છે. આવી સ્થિતિમાં ખેડૂત ભાઈઓ તેમના ખેતરમાં ડાંગરની સારી જાતનું વાવેતર કરીને વધુ ઉત્પાદન મેળવી શકે છે.…
સીધા ખેડૂતોના ખાતામાં જશે 50000 રૂપિયા, વધુ રાહ જોવી નહીં પડે
કેન્દ્ર અને રાજ્ય સરકાર ખેડુતોના ફાયદા માટે અવાર નવાર ઘણી યોજનાઓ લાવતી રહે છે. આવી જ એક યોજના છે પરંપરાગત કૃષિ વિકાસ યોજના, જેમાં ખેડુતોને…
શેરડીની સાથે ઓછા સમયમાં તૈયાર આ 5 પાકનું વાવેતર કરો, સારો ફાયદો થશે
ભારતમાં શેરડીની ખેતી મોટા પાયે થાય છે. શેરડીના ઉત્પાદનમાં ભારત વિશ્વમાં પ્રથમ ક્રમે છે. જોકે, ઉત્તર પ્રદેશ જેવા રાજ્યોમાં શેરડીની ખેતીમાં સતત નુકસાનને કારણે ઉત્પાદનમાં…
તુવેર, બાજરી, તલ સહિતના ઘણા પાકો સંબંધિત સલાહ, સંપૂર્ણ લેખ વાંચો
રાજ્ય કૃષિ-હવામાન કેન્દ્ર ભોપાલે આગામી પાંચ દિવસના હવામાનને ધ્યાનમાં રાખીને પાક ખેડૂતો, માળીઓ અને પશુપાલકો માટે આ માહિતી જાહેર કરી છે.…
સોમાણી સીડ્સ દ્વારા લોન્ચ કરવામાં આવી ગાજરની નવી હાઇબ્રિડ વેરાયટી
ગાજરની ખેતીની સાથે સાથે સમગ્ર ભારતમાં ગાજરનું સેવન પણ કરવામાં આવે છે. તેનો ઉપયોગ સલાડથી લઈને શાકભાજી અને સૌથી વધુ ગાજરના હલવામાં થાય છે. હજુ…
કૃષિ ક્ષેત્રે આશીર્વાદરૂપ: મહિલાસંચાલિત કૃષિ ઉપકરણો
દેશની કુલ કૃષિ મજૂરોની વસ્તીમાં ૩૭ ટકા મહિલાઓ છે. જો કે, ખેતીમાં ઉપયોગમાં લેવાતા મોટાભાગના ઓજારો, સાધનો અને મશીનો માત્ર પુરુષો અનુરુપ બનાવવામાં આવે છે.…
છેલ્લા 70 વર્ષમાં ભારતની જમીનમાં ઓર્ગેનિક કાર્બનનું પ્રમાણ 1% થી 0.3%ના ચિંતાજનક સ્તરે પહોંચ્યું- સંશોધનમાં જાણવા મળ્યુ
જમીનમાં યોગ્ય ખાતર વિના સઘન પાકની ખેતી એ SOC સામગ્રીમાં ઘટાડો થવાનું કારણ છે. ખેડૂતોએ જંતુનાશકો અને ખાતરો પરની તેમની નિર્ભરતા ઘટાડવી જોઈએ. જૈવ ખાતર…
ખેડૂતો, પશુપાલકો અને માછલીના ખેડૂતો માટે ખૂબ જ મહત્વપૂર્ણ માહિતી, આ સિઝનમાં આ બાબતોનું ધ્યાન રાખો
દેશના લગભગ દરેક રાજ્યમાં ચોમાસાની શરૂઆત થઈ ગઈ છે. જેના કારણે હાલમાં મોટાભાગના રાજ્યોમાં વરસાદ પડવાનુ ચાલુ છે. આ જ કારણ છે કે હવામાન વિભાગે…
Pomegranate Farming: વરસાદની મોસમમાં દાડમની ખેતી તમને ધનવાન બનાવશે, 24 વર્ષ સુધી મેળવો બમ્પર નફો
દાડમની ખેતી, દાડમની ખેતી કેવી રીતે કરવી: ભારતમાં, પરંપરાગત ખેતીમાં નફો સતત ઘટી રહ્યો છે. આની પાછળ હવામાન પરિવર્તનને કારણે ખેતી કરવાની રીતને જવાબદાર ઠેરવવામાં…
જમીનની સ્વસ્થ્યતા અને પર્યાવરણ સંરક્ષણ માટે અપનાવો જૈવિક ખેતી
દિન પ્રતિદિન વધતી જતી જનસંખ્યાને જરૂરી અનાજનો પુરવઠો પુરો પાડવા માટે તેમજ ઘટતી જતી ખેતીલાયક જમીન વિસ્તારમાં વધુ ઉત્પાદન કઈ રીતે મેળવવું તે માટે ખેડૂતોને…
ડાંગરમાં કળીઓ વધારવા માટે અપનાવો આ 5 જબરદસ્ત રીતો, તમને ઝડપી ઉપજ મળશે
ડાંગર દેશનો મુખ્ય પાક છે. તેના ઉત્પાદનમાં ચીન પછી ભારતનું નામ આવે છે. આવી સ્થિતિમાં, અમે ડાંગરની સંખ્યા વધારવા માટે પાંચ જબરદસ્ત રીતો લઈને આવ્યા…
સાવધાન! ખેડૂત વરસાદમાં આ બાબતોનું રાખે ધ્યાન, નહીં બગડે પાક
મધ્ય પ્રદેશના ખેડૂતો માટે, ભારતીય હવામાન વિભાગના ભોપાલ કેન્દ્રએ ખરીફ પાકો અંગે એગ્રોમેટ એડવાઈઝરી જારી કરતી વખતે જરૂરી માહિતી આપી છે. આ એડવાઈઝરીની માન્યતા 29…
આ મહિલા બની કૃષિ વ્યવસાયની 'મલિકા', અનોખા ઉત્પાદનોથી બનાવી પોતાની ઓળખ
જ્યારે કેન્દ્ર સરકાર એક તરફ ઓર્ગેનિક ખેતી અને ઉત્પાદનોને પ્રોત્સાહન આપવા પર ભાર આપી રહી છે. તે જ સમયે, કર્ણાટકના હરિહર વિસ્તારની 63 વર્ષીય ઉદ્યોગસાહસિક…
કેન્દ્રીય આરોગ્ય મંત્રાલય અમરનાથ યાત્રાને ભવ્ય રીતે સફળ બનાવવા માટે વિવિધ પગલાં લઈ રહ્યું છે
ભક્તોને મદદ કરવા માટે કેન્દ્ર સરકાર અને રાજ્ય સરકાર બંને તરફથી મેડિકલ પ્રોફેશનલ્સ તૈનાત DRDOની મદદથી બાલતાલ અને ચંદનવારી ખાતે ઇન્ડોર સુવિધા તરીકે બે 50…
શું છે સિંગલ યુઝ પ્લાસ્ટિક જેના પર 01 જુલાઈથી મૂકવામાં આવ્યો છે પ્રતિબંધ
કેન્દ્રીય પર્યાવરણ મંત્રી ભૂપેન્દ્ર યાદવે એક ટીવી ચેનલને આપેલા ઈન્ટરવ્યુમાં જણાવ્યું છે કે 01 જુલાઈથી સમગ્ર ભારતમાં સિંગલ યુઝ પ્લાસ્ટિક પર પ્રતિબંધ લાગશે.…
પોલીહાઉસ અને ખેતરમાં ફેન્સીંગ માટે ઘરે બેસીને અરજી કરી શકશે ખેડૂતો
ખેડૂતો પોલીહાઉસ બનાવવા અને ખેતરમાં ફેન્સીંગ કરવા માટે ઘરે બેઠા આરામથી અરજી કરી શકશે. રાજ્યના કૃષિ નિર્દેશાલયે તેની પ્રક્રિયાને સરળ બનાવી છે. કૃષિ વિભાગને લગતી…
ખાતરની ઊંચી કિંમત વસૂલવામાં આવશે, તો એક ફોન કોલ પર થશે લાઇસન્સ સસ્પેન્ડ
ખેડૂતોને મદદ કરવા માટે સરકાર દરરોજ કંઈક ને કંઈક કરતી રહે છે, જેથી ખેડૂતોને મુશ્કેલીનો સામનો ન કરવો પડે, પરંતુ હજુ પણ ઘણી જગ્યાએ ખેડૂતોને…
પીએમએ વીડિયો સંદેશ દ્વારા બેંગલુરુમાં બોશ સ્માર્ટ કેમ્પસના ઉદ્ઘાટન પ્રસંગે સંબોધન કર્યું
“ડિજીટલ ઈન્ડિયાના અમારા વિઝનમાં સરકારના દરેક પાસાઓ સાથે ટેક્નોલોજીને એકીકૃત કરવાનો સમાવેશ થાય છે. હું વિશ્વને વિનંતી કરીશ કે તકોનો ઉપયોગ કરે અને આપણા રાષ્ટ્રમાં…
તુવેરની આ 2 નવી જાતો આપશે વધુ ઉત્પાદન, જાણો તેમની ખાસિયતો
ભારતમાં કઠોળ પાકોમાં ચણા પછી તુવેરનું આગવું સ્થાન છે. તુવેરની વાવણી વરસાદ પછી એટલે કે જુલાઈ મહિનામાં શરૂ થાય છે. ખેડૂતો ક્યારેક તુવેરના પાકની સાથે…
અડદ, મગફળીની સુધારેલી જાતોનું વાવેતર કરો
અડદ, મગફળી, તલ, સોયાબીન, જુવારની ખેતી મુખ્યત્વે ખરીફ સીઝનમાં થાય છે. છેલ્લા 2-3 વર્ષથી મગફળીનો વાવેતર વિસ્તાર વધી રહ્યો છે અને હવામાન પરિવર્તનને કારણે તલ,…
કાળી હળદરની ખેતી કરવાની સાચી રીત, ખેડૂતો બનશે સમૃદ્ધ
ખેડૂતો હવે પરંપરાગત ખેતીની સાથે આધુનિક ખેતી તરફ વળ્યા છે, કારણ કે તેમને તેમાં વધુ નફો જોવા મળી રહ્યો છે. આમાંથી એક ઔષધીય પાક પણ…
ચોખાના પાકને બચાવવા માટે સ્વાલે વાયોલા લોન્ચ કર્યું
સ્વાલે ચોખાના પાકને સુરક્ષિત રાખવા માટે વાયોલા લોન્ચ કર્યુ - ટકાઉ કૃષિ સોલ્યુશન્સની અગ્રણી પ્રદાતા સ્વાલ કોર્પોરેશન લિ. દ્વારા ચોખાના પાકના રક્ષણ માટે, હરિયાણાના કરનાલમાં…
જિલ્લામાં વાવવામાં આવશે 26.56 લાખ રોપાઓ
રામપુર. જિલ્લામાં 5 જુલાઇથી વૃક્ષારોપણનો કાર્યક્રમ શરૂ થશે. જે અંતર્ગત જિલ્લામાં 26.56 લાખ રોપા વાવવાનો લક્ષ્યાંક રાખવામાં આવ્યો છે. આ લક્ષ્યાંક 15 ઓગસ્ટ સુધીમાં પૂર્ણ…
Uddhav Thackeray Resigns: ઉદ્ધવ ઠાકરેએ સીએમ પદેથી આપ્યું રાજીનામું
ઉદ્ધવ ઠાકરેએ કાલે એટલે કે બુધવારે ફ્લોર ટેસ્ટ પહેલા જ રાજીનામું આપી દીધું હતું. આજે ભાજપની બેઠક, ફડણવીસ 1-2 દિવસમાં CM પદના શપથ લઈ શકે…
અમિત શાહે પ્રાઇમરી એગ્રીકલ્ચર ક્રેડિટ સોસાયટીઓને કોમ્પ્યુટરાઈઝ કરવા કેબિનેટ દ્વારા લેવામાં આવેલા નિર્ણય બદલ પ્રધાનમંત્રીનો આભાર માન્યો
કેન્દ્રીય ગૃહ અને સહકારિતા મંત્રી, શ્રી અમિત શાહે પ્રાઇમરી એગ્રીકલ્ચર ક્રેડિટ સોસાયટીઓ (PACS) ને કોમ્પ્યુટરાઈઝ કરવા કેબિનેટ દ્વારા લેવામાં આવેલા મહત્વના નિર્ણય બદલ પ્રધાનમંત્રી શ્રી…
NITI આયોગ અને TIFAC એ ભારતીય બજારમાં ઇલેક્ટ્રિક ટુ-વ્હીલરના ભાવિ પ્રવેશ અંગેનો અહેવાલ રજૂ કર્યો
FY 26-27 સુધીમાં 100% પ્રવેશ આશાવાદી દૃશ્યમાં અનુમાનિત; 2031 સુધીમાં 72% જ્યાં વર્તમાન પ્રોત્સાહનો 2024 સુધીમાં પાછા ખેંચી લેવામાં આવશે…
4 ઈંચ વરસાદ પછી આ રીતે કરો સોયાબીનની વાવણી
સોયાબીન વાવણી દેશના મોટાભાગના રાજ્યોમાં ચોમાસું ફરી સક્રિય થયું છે, જેની અસર સીધી ખેડૂત ભાઈઓ પર જોવા મળી રહી છે. આવી સ્થિતિમાં કૃષિ વિભાગે સોયાબીન…
કેપ્સીકમની ટોચની જાતો, જે 78-80 દિવસમાં આપશે બમ્પર ઉપજ
ભારતમાં કેપ્સિકમની ખેતી મોટાભાગે ઉત્તરીય રાજ્યો જેવા કે, હિમાચલ પ્રદેશ, હરિયાણા, પંજાબ, ઝારખંડ, ઉત્તર પ્રદેશ અને કર્ણાટકના નજીકના રાજ્યોમાં કરવામાં આવે છે.…
ખેડૂતોના ખાતામાં મોકલવામાં આવશે 7000 રૂપિયા, જલ્દી કરાવો નોંધણી
ખેડૂતોને ડાંગરની ખેતી ન કરવાની સલાહ ખેડૂત ભાઈઓને ડાંગરની ખેતી કરવા માટે વધુ પાણીની જરૂર પડે છે, પરંતુ દેશના ઘણા રાજ્યોમાં પાણીનું સ્તર સતત ઘટી…
નાના ખેડૂતોને તેમની ઉપજનો લાભ મળશેઃ હરિયાણા કૃષિ મંત્રી શ્રી દલાલ
હરિયાણા સરકાર ખેડૂતોના ઉત્થાન અને હિતોને ધ્યાનમાં રાખીને વિવિધ યોજનાઓ લાગુ કરી રહી છે.હરિયાણાના કૃષિ અને ખેડૂત કલ્યાણ મંત્રી, શ્રી જે.પી. દલાલે જણાવ્યું હતું કે,…
પ્રખ્યાત મશરૂમની ખેતી કરે છે રાજસ્થાનનો આ ખેડૂત, અહી કર્યો ટેકનિકનો ખુલાસો
મશરૂમ કિસાન મોટારામ શર્મા (Mushroom Farmer Motaram Sharma) મશરૂમની ખેતી એક આકર્ષક અને નવા ઉદ્યોગ તરીકે ઝડપથી ઉભરી રહી છે. આ સંદર્ભમાં, આપણે બધાએ રાજસ્થાનના…
“આવિષ્કારનો જીન તેના ચિરાગમાંથી બહાર આવી ગયો છે”: રાજીવ ચંદ્રશેખર
“આજના સમયમાં સખત પરિશ્રમ, ધીરજ અને ધગશ જ તમારી સફળતા નક્કી કરે છે. તમારી અટકનો પ્રભાવ હોવો જરૂરી નથી”: રાજીવ ચંદ્રશેખર…
હરિયાણા પશુધન વિકાસ બોર્ડને મળ્યું શ્રેષ્ઠ સન્માન
હરિયાણા પશુધન વિકાસ બોર્ડને મળ્યું શ્રેષ્ઠ સન્માન તેમજ પશુપાલકોની યોજનાઓ માટે મુખ્યમંત્રીનો આભાર વ્યક્ત કર્યો…
જુલાઈ મહિનામાં આ પાકની વાવણી કરીને બમ્પર નફો કમાઈ શકે છે ખેડૂતો
ખરીફ પાકની વાવણી શરૂ થઈ ગઈ છે. આ દરમિયાન, કૃષિ નિષ્ણાતો ખેડૂતોને પરંપરાગત પાકો ઉપરાંત અન્ય ઘણા પાકોની ખેતી કરવાની સલાહ આપી રહ્યા છે, જેથી…
ઉન્નત ખેતીનો અભિગમઃ પપૈયાની ઉન્નત ખેતી કેવી રીતે કરશો તે જાણીએ
પપૈયા સ્વાદિષ્ટ અને પોષક તત્વોથી ભરપૂર તથા દેશનું પાંચમુ લોકપ્રિય ફળ છે. તેમા વિટામીન A અને C વિપુલ પ્રમાણમાં જોવા મળે છે. આપણા દેશમાં તે…
કુદરતી ખેતી દ્વારા કૃષિ સમૃદ્ધિ વિષય પર સેમિનારનું આયોજન
ગુજરાતના રાજ્યપાલ આચાર્ય દેવવ્રત આજે મેરઠની કૃષિ યુનિવર્સિટી ખાતે કુદરતી ખેતી દ્વારા કૃષિ સમૃદ્ધિ વિષય પર યોજાયેલા સેમિનારમાં મુખ્ય અતિથિ તરીકે હાજરી આપવા પહોંચ્યા હતા.…
તેંદુના પાનનો વ્યવસાય કરીને કમાવો લાખો રૂપિયા
તમે ગ્રામીણ વિસ્તારોમાં તમારો પોતાનો વ્યવસાય શરૂ કરીને લાખો રૂપિયા કમાઈ શકો છો, જેના માટે તમારે તેંદુના પાંદડાના છોડની ખેતી શરૂ કરવી પડશે.…
1 જુલાઈ, 2022થી અધિસૂચિત સિંગલ યુઝ પ્લાસ્ટિકની ચીજવસ્તુઓ પર પ્રતિબંધ
પ્રતિબંધિત સિંગલ યુઝ પ્લાસ્ટિકની ચીજવસ્તુઓના ગેરકાયદેસર ઉત્પાદન, આયાત, સ્ટોકિંગ, વિતરણ, વેચાણ અને ઉપયોગ પર નજર રાખવા રાષ્ટ્રીય અને પ્રાદેશિક સ્તરે નિયંત્રણ કક્ષો સ્થાપિત થશે…
ઉદયપુર કૃષિ વિજ્ઞાન કેન્દ્રોની પ્રાદેશિક વર્કશોપ પૂર્ણ થઈ
ઉદયપુર કૃષિ વિજ્ઞાન કેન્દ્રોની પ્રાદેશિક કાર્યશાળા પૂર્ણ - હરિયાણા અને દિલ્હીના કૃષિ વિજ્ઞાન કેન્દ્રો (જ્હોન II) ની ત્રણ દિવસીય વર્કશોપ 27મી જૂન, 2022ના રોજ વિસ્તરણ…
કરોડપતિ બનવાની ચાવી છે છાણ, શરૂ કરો વર્મી કમ્પોસ્ટનો બિઝનેસ
દેશનો ખેડૂત વારંવાર રાહ જોઈને બેઠો હોય છે કે આખરે તે ખેતી, પશુપાલન સિવાય વધારાની કમાણી કેવી રીતે કરી શકશે. આજે અમે તમને જણાવીશું કે…
"'સ્ટાર્ટઅપ' એ આજકાલ ફેશન નથી, પરંતુ ન્યૂ નોર્મલ છે " : રાજીવ ચંદ્રશેખર
કેન્દ્રીય રાજ્યમંત્રીએ રાજીવ ચંદ્રશેખરે નિરમા યુનિવર્સિટીમાં ઇન્ક્યુબેશન સેન્ટરનું ઉદ્ઘાટન કર્યું, સ્ટાર્ટઅપ્સ અને ઇનોવેટર્સ સાથે વાતચીત કરી…
ડાંગરની સીધી વાવણી પર ખેડૂતોને પ્રતિ એકર 4 હજાર રૂપિયા, અરજી માટે આટલા દિવસો બાકી
ખરીફ વાવણી લગભગ શરૂ થઈ ગઈ છે. જો કે આ વખતે ખેડૂતો સામે સિંચાઈનું મોટું સંકટ ઊભું થવાનું છે. વાસ્તવમાં હરિયાણા સહિત ઉત્તર ભારતના તમામ…
જર્મનીમાં G7 શિખર સંમેલનમાં ‘બહેતર ભવિષ્યમાં રોકાણ: આબોહવા, ઊર્જા, આરોગ્ય’ પર યોજાયેલા સત્રમાં પ્રધાનમંત્રીના સંબોધનનો મૂળપાઠ
દુર્ભાગ્યવશ, એવું માનવામાં આવે છે કે દુનિયાના વિકાસલક્ષી ધ્યેયો અને પર્યાવરણીય સંરક્ષણ વચ્ચે જડમૂળમાંથી ટકરાવ છે. બીજી એક ગેરસમજ એવી પણ છે, કે ગરીબ દેશો…
જો આ કામ નહીં કરવામાં આવે તો તમે પીએમ કિસાન યોજનાના 12મા હપ્તાથી રહી જશો વંચિત
પીએમ કિસાન સન્માન નિધિનો 11મો હપ્તો ખેડૂતોના ખાતામાં પહોંચી ગયો છે. સરકારના જણાવ્યા અનુસાર 2 હજાર રૂપિયાની આ રકમ 10 કરોડથી વધુ ખેડૂતોના ખાતામાં મોકલવામાં…
અફઘાનિસ્તાનમાં ભૂકંપથી 950ના મોત, 600થી વધુ ઘાયલ
અફઘાનિસ્તાનમાં આવેલા ભયાનક ભૂકંપના કારણે 950થી વધુ લોકોના મોત થયા છે અને 100થી વધુ મકાનો કાટમાળમાં ફેરવાઈ ગયા છે.આ ભૂકંપની તીવ્રતા 6.1 જણાવવામાં આવી રહી…
સોયાબીનમાં સંતુલિત ખાતર વ્યવસ્થાપન અંગે ખેડૂત સેમિનારનું આયોજન
ઈન્ડિયન ઈન્સ્ટિટ્યૂટ ઓફ સોયાબીન રિસર્ચ, ઈન્દોર દ્વારા 'બેલેન્સ્ડ ફર્ટિલાઈઝર મેનેજમેન્ટ ઇન સોયાબીન ફોર ન્યુટ્રીશન મેનેજમેન્ટ' વિષય પર ઓનલાઈન ખેડૂત સેમિનારનું આયોજન કરવામાં આવ્યું હતું.…
તરત થઈ જાવ સાવધાન, આવા લોકોએ પીએમ કિસાન યોજનાના પૈસા પરત ન કર્યા તો...
પ્રધાનમંત્રી કિસાન સન્માન નિધિ અંતર્ગત ખેડૂતોને દર વર્ષે 6 હજાર રૂપિયા આપવામાં આવે છે. આ રકમ દર ચાર મહિને રૂ. 2-2 હજારના અંતરાલ સાથે ત્રણ…
પ્રધાનમંત્રી શ્રી નરેન્દ્ર મોદીના “સહકાર સે સમૃદ્ધિ” ના વિઝનને વધુ મજબૂત કરશે અમિત શાહ
કેન્દ્રીય ગૃહ અને સહકારિતા મંત્રી, શ્રી અમિત શાહ આવતીકાલે નવી દિલ્હીમાં "શહેરી સહકારી ધિરાણ ક્ષેત્રની ભાવિ ભૂમિકા" વિષય પર અનુસૂચિત અને બહુ-રાજ્ય શહેરી સહકારી બેંકો…
કુલ્લુમાં દુષ્કાળની અસર, 35% ટામેટાંનો પાક બરબાદ
કુલ્લુ જિલ્લામાં દુષ્કાળના કારણે 35 ટકા પાકને નુકસાન થયું છે. ટામેટાં પર જીવાત, સ્કેમ બ્લાઈટ અને ઘણા રોગોએ પણ હુમલો કરી દીધો છે.…
૮ વર્ષના શાસનકાળમાં કેન્દ્ર સરકારે ગરીબ કલ્યાણ, સેવા અને સુશાસન સાથે તમામ વર્ગ માટે સુખાકારીનું કામ કર્યું છે: કૈલાશ ચૌધરી
ભુજમાં ૮ વર્ષના શાસનકાળની ઉપલબ્ધિના સંવાદમાં વિવિધ યોજનાઓના ગ્રામીણ અને શહેરી વિસ્તારના લાભાર્થીઓ પ્રધાનમંત્રી નરેન્દ્ર મોદી ઉપર ઓળઘોળ…
બેસ્ટ એગ્રો લાઈફ ડીલર્સ બેઠક માં 5 પ્રોડક્ટ લોન્ચ
બેસ્ટ એગ્રો લાઈફની ડીલર્સ મીટીંગમાં 5 પ્રોડક્ટ લોન્ચ - તાજેતરમાં ઈન્દોરમાં દેશની પ્રતિષ્ઠિત કંપની બેસ્ટ એગ્રો લાઈફ લિમિટેડ દ્વારા ડીલર્સ મીટીંગનું આયોજન કરવામાં આવ્યું હતું,…
સરકારી કર્મચારીઓને જલ્દી મળી શકે છે મોટી ભેટ, નિવૃત્તિની ઉંમર અને પેન્શનની રકમ વધશે, સરકારને મોકલ્યો પ્રસ્તાવ
કેન્દ્રની મોદી સરકાર ટૂંક સમયમાં સરકારી કર્મચારીઓને મોટી ભેટ આપી શકે છે. વાસ્તવમાં મોદી સરકાર કર્મચારીઓની પેન્શનની રકમ અને નિવૃત્તિની ઉંમર વધારવાના પ્રસ્તાવ પર વિચાર…
વૈશ્વિક પ્રવાસન સ્થળ ધોળાવીરાના વિકાસ માટે કેન્દ્ર સરકાર વચનબદ્ધ, પોસ્ટલ બેંક અને મોબાઈલ ટાવરની સુવિધા શરૂ કરાશે: દેવુસિંહ ચૌહાણ
કેન્દ્રીય સંદેશાવ્યવહાર રાજ્ય મંત્રીશ્રી દેવુસિંહ ચૌહાણે યુનેસ્કો દ્વારા વર્લ્ડ હેરિટેજ ઘોષિત કરાયેલ ધોળાવીરા સાઈટ નિહાળી કહ્યું, “આ ભારતની સંસ્કૃતિ અને સમૃદ્ધિનો ધરબાયેલો જીવંત વારસો”…
ઘઉં, ડાંગરની કાપણીના સમયગાળા વચ્ચે બટાટા ઉગાડી શકશે ખેડૂતો, સીપીઆરઆઈ શિમલાએ ત્રણ જાતોની શોધ કરી
ગંગા નદીને અડીને આવેલા દેશના મેદાની વિસ્તારોના ખેડૂતો હવે ઘઉં અને ડાંગરની કાપણી વચ્ચેના સમયગાળા દરમિયાન બટાટાની લણણી કરી શકશે.…
રિવરફ્રન્ટ ખાતે આઠમો આંતરરાષ્ટ્રીય યોગ દિવસ ઉજવાયો
યોગ આપણા દેશની સંસ્કૃતિ, વિશ્વભરમાં યોગની શરૂઆત પ્રધાનમંત્રી શ્રી નરેન્દ્ર મોદીએ કરાવી છે : કેન્દ્રીય રાજ્ય નાણાં મંત્રી ડૉક્ટર ભાગવત કિશનરાવ કરાડ…
ઉંમર માત્ર એક નંબર જ નંબર છે... આ 105 વર્ષની વૃધ્ધ મહિલાએ બધાને ચોંકાવી દીધા
કહેવાય છે કે ઉંમર માત્ર એક આંકડો જ છે અને સપના પૂરા કરવા માટેની કોઈ ઉંમર નથી હોતી.…
કર્ણાટકના મૈસુર પેલેસ ગ્રાઉન્ડ ખાતે 8મા આંતરરાષ્ટ્રીય યોગ દિવસ પર પ્રધાનમંત્રીના સંબોધનનો મૂળપાઠ
રાજ્યના રાજ્યપાલ શ્રી થાવરચંદ ગેહલોતજી, મુખ્યમંત્રી શ્રી બસવરાજ બોમાઈજી, શ્રી યદુવીર કૃષ્ણ દાતા ચામરાજા વાડિયારજી, રાજમાતા પ્રમોદા દેવી, મંત્રી શ્રી સર્બાનંદ સોનોવાલજી, 8મા આંતરરાષ્ટ્રીય યોગ…
ખરીફ સિઝનમાં આ પાકની વાવણી કરવાથી સારી કમાણી થશે
દેશના મોટાભાગના રાજ્યોમાં ચોમાસાની શરૂઆત થઈ ગઈ છે, આ સાથે ખેડૂતોએ ખરીફ પાકની વાવણીની તૈયારી શરૂ કરી દીધી છે. ચોમાસાના આગમન સાથે ખરીફ પાકની વાવણીની…
પ્રધાનમંત્રીએ શ્રી સુત્તુર મઠ ખાતે એક કાર્યક્રમમાં ભાગ લીધો
"જ્યારે ભારતની ચેતના ઓછી થઈ, ત્યારે દેશભરના સંતો અને ઋષિઓએ દેશના આત્માને જીવંત કર્યો"…
પીએમએ પ્રગતિ મેદાન સંકલિત ટ્રાન્ઝિટ કોરિડોર પ્રોજેક્ટ સમર્પિત કર્યો
"આ એક નવું ભારત છે જે સમસ્યાઓનું નિરાકરણ કરે છે, નવા સંકલ્પો લે છે અને તે પ્રતિજ્ઞાઓને સાકાર કરવા માટે અથાક મહેનત કરે છે" આ…
શ્રી વહાણવટીકૃપા એજ્યુકેશન ટ્રસ્ટ દ્વારા ગરીબ બાળકોને મફતમાં શિક્ષણ આપાવતા વિપુલભાઈ
વહાણવટી એજ્યુકેશન ટ્રસ્ટના ટ્રસ્ટી વિપુલભાઈ છેલ્લા ઘણા સમયથી ગરીબ બાળકોને પુરતુ શિક્ષણ મળી રહે અને ગરીબ બાળક તેનુ ભવિષ્ય ઉજવળ બનાવી શકે તે હેતુથી ટ્રસ્ટ…
બજારમાં બમણા ભાવે વેચાશે રીંગણ, ચોમાસામાં આ સાવધાની સાથે કરો વાવણી અને રોપણી
ખરીફ પાક ચક્ર દરમિયાન મોટાભાગના ખેડૂતો બાગાયતી પાકની ખેતી માટે તૈયારી કરી રહ્યા છે. નિષ્ણાતોના મતે બાગાયતી પાકો નર્સરીમાં ઉગાડવા જોઈએ અને ખેતરોમાં રોપવા જોઈએ.…
જો તમે UPSC પરીક્ષાની તૈયારી કરવા માંગતા હોવ તો, જાણો માહિતી વિસ્તારથી
UPSC શું છે? તેની તૈયારી કઈ રીતે કરવી ? UPSCની એક્ઝામ કોણ આપી શકે? UPSC ની ભરતી કેટલા વર્ષે થાય? UPSCનો સિલેબસ શું છે? UPSCની…
કેન્દ્રીય આરોગ્ય મંત્રી ગુજરાતના કેવડિયામાં સ્ટેચ્યૂ ઓફ યુનિટી ખાતે 21 જૂન 2022ના રોજ IDY ઉજવણીનું નેતૃત્વ સંભાળશે
સમગ્ર દેશમાં IDYની ઉજવણી માટે પસંદ કરવામાં આવેલા 75 સુપ્રસિદ્ધ સ્થળોમાં સ્ટેચ્યૂ ઓફ યુનિટીની પણ પસંદગી કરવામાં આવી…
રાજસ્થાનમાં 1000 નવી ગ્રામ સેવા સહકારી મંડળીઓની થઈ રચના
રાજસ્થાનમાં 1000 નવી ગ્રામ સેવા સહકારી મંડળીઓની રચના - રજીસ્ટ્રાર સહકારી શ્રી મુક્તાનંદ અગ્રવાલે જણાવ્યું હતું કે રાજ્યની તમામ ગ્રામ પંચાયતોના મુખ્યાલયમાં નવી ગ્રામ સેવા…
ભારતમાં બીજ ક્ષેત્રની મુખ્ય પડકારો અને તકો
બિયારણ એ કૃષિ માટે સૌથી મૂળભૂત અને મહત્વપૂર્ણ સામગ્રી છે, જેને વર્તમાન અને ભવિષ્ય વચ્ચેની કડી તરીકે તેને ગણવામાં આવે છે. ભારત વિશ્વ મંચ પર…
પરભક્ષી કીટક –લેડીબર્ડ બીટલની અગત્યની જાતિઓ
લેડીબર્ડ બીટલ એ ચૂસિયાં પ્રકારની જીવાતોનું અગત્યનું પરભક્ષી કીટક છે. તેનો સમાવેશ ઢાલપક્ષ શ્રેણીના કોકસીને લીડી કૂળમાં કરવામાં આવેલ છે.…
કેક્ટસના છોડમાંથી બનેલું લેધર, ચામડા ઉદ્યોગમાં આવશે ક્રાંતિ
વધતી જતી ફેશન સાથે ચામડાની બનાવટોની માંગ અનેક ગણી વધી ગઈ છે. ડેકોરેશનથી લઈને દૈનિક જરૂરિયાતની વસ્તુઓમાં ચામડાનો ઉપયોગ ઝડપથી વધી રહ્યો છે. પરંતુ ચામડાના…
દેશમાં મલ્ટિલેયર ફાર્મિંગના પ્રણેતા છે આકાશ ચૌરસિયા, આપી રહ્યા છે ખેડૂતોને તાલીમ
આકાશ ચૌરસિયા આજે દેશમાં ખૂબ જ લોકપ્રિય બની ગયા છે. તેઓ મલ્ટી લેયર ફાર્મિંગની બ્રાન્ડ બની ગયા છે. તેમના દ્વારા બતાવેલ તકનીકોને અપનાવીને, ખેડૂતો મર્યાદિત…
મજૂરો માટે વૃદ્ધાવસ્થાની લાકડી બનશે મોદી સરકારની આ યોજના, મળશે 36 હજાર રૂપિયા પેન્શન, આ રીતે કરો નોંધણી
કેન્દ્રની મોદી સરકાર દેશના નાગરિકો માટે અનેક યોજનાઓ ચલાવી રહી છે. ખેડૂતોની સાથે સાથે મજૂર વર્ગ માટે પણ ઘણી યોજનાઓ ચલાવવામાં આવે છે. તેમાંથી પીએમ…
પુરવઠામાં વધારાને કારણે બ્રાન્ડેડ ખાદ્યતેલોના ભાવમાં રૂપિયા 15નો ઘટાડો થયો, આગામી સમયમાં વધુ સસ્તા થશે
બ્રાન્ડેડ ખાદ્ય તેલ કંપનીઓએ સોયા, પામ અને સૂર્યમુખી તેલના ભાવમાં પ્રતિ લિટર રૂપિયા 15 સુધીનો ઘટાડો કર્યો છે. મે મહિનાના અંતથી તેલના પુરવઠામાં થયેલા સુધારાને…
અગ્નિપથ યોજનામાં કેન્દ્રનો મોટો નિર્ણય, ગૃહ મંત્રાલયે બે ફોર્સમાં આપ્યુ અનામત
ગૃહ મંત્રાલય દ્વારા કરવામાં જાહેરાત અનુસાર, CAPF અને આસામ રાઇફલ્સમાં ભરતીમાં અગ્નિપથ યોજના હેઠળ 4 વર્ષ પૂર્ણ કરનારા અગ્નિવીર માટે 10% ખાલી જગ્યાઓ અનામત રાખવાનો…
બાગાયતના વ્યવસાયે ખેડૂતને બનાવ્યો લાખોપતિ, રચી દીધી સફળતાની ગાથા
સફળ લોકો ક્યારેય આરામ કરતા નથી, પરંતુ તેમનું કામ તેમના માટે આરામ છે. આ વાક્યને ઝારખંડના એક પ્રગતિશીલ ખેડૂતે સાચું સાબિત કરી બતાવ્યુ છે જેમનું…
સ્ટીલ મંત્રીનો 2030 સુધીમાં 300 મિલિયન ટન સ્ટીલ ક્ષમતા હાંસલ કરવાનો લક્ષ્યાંક
સ્ટીલ મંત્રી શ્રી રામ ચંદ્ર પ્રસાદ સિંહે ગૌણ સ્ટીલ ક્ષેત્ર માટે યોગ્ય ઇકોસિસ્ટમને સમર્થન અને પ્રદાન કરવા પર ભાર મૂક્યો હતો; વર્ષ 2030 સુધીમાં 300…
જિલ્લામાં 48 હજાર મેટ્રિક ટનનો લક્ષ્યાંક હતો, માત્ર 400 ક્વિન્ટલ ઘઉંની થઈ ખરીદી
આ વખતે આગ્રા જિલ્લામાં ઘઉંની ખરીદીની ખરાબ સ્થિતિ રહી. માત્ર 400 ક્વિન્ટલ ઘઉંની ખરીદી થઈ શકી હતી. 10 કેન્દ્રોમાં તો બોણી પણ થઈ નથી.…
દુખ:દ સમાચાર: કૃષિ જાગરણના મુખ્ય સંપાદક એમ.સી ડોમિનિકના આદરણીય પિતા શ્રી એમ.વી. ચેરિયનનું નિધન થયું.
સારા લોકો હૃદયમાં એવી રીતે ઉતરી જાય છે, કે મૃત્યુ પછી પણ અમર બની જાય છે.…
APEDA એ કેરીની નિકાસને વેગ આપવા માટે બહેરીનમાં મેંગો ફેસ્ટિવલનું આયોજન કર્યુ
APEDAએ કેરીની નિકાસને પ્રોત્સાહન આપવા માટે બહેરીનમાં મેંગો ફેસ્ટિવલનું આયોજન કર્યુ છે - કૃષિ અને પ્રોસેસ્ડ ફૂડ પ્રોડક્ટ્સ એક્સપોર્ટ ડેવલપમેન્ટ ઓથોરિટી (APEDA) એ બહેરીનમાં ભારતીય…
સમૃદ્ધ ખેતીનો મંત્ર: એક ખેતર, અનેક પાકો
રાસાયણિક ખાતરો-દવાઓ-જંતુનાશકોનું વિપુલ ઉત્પાદન કરનારી 'હરિયાળી ક્રાંતિ' હવે તેના દ્વારા સર્જાયેલા જોખમોને પ્રકાશિત કરવાનું શરૂ કરી દીધું છે. એક સમયે કેન્સર જેવો દુર્લભ રોગ હવે…
ખેતીમાં બમણો નફો મેળવવાની સરસ રીત, જાણો કેવી રીતે આ ખેડૂત કરે છે સ્માર્ટ વર્ક
પંજાબ એક એવું રાજ્ય છે જેને "બાઉલ ઓફ ઈન્ડિયા" (Bowl of India )નો દરજ્જો આપવામાં આવ્યો છે. આ માત્ર તેની ખાદ્ય જરૂરિયાતોને જ પૂર્ણ નથી…
ખેડૂતો માટે સારા સમાચાર, કિસાન સમૃદ્ધિ યોજનાની મુદત 5 વર્ષ સુધી લંબાવાઈ
ઉત્તર પ્રદેશના ખેડૂતો માટે એક સારા સમાચાર આવ્યા છે. બંજર અને પાણી ભરાયેલી જમીનને ખેતીલાયક બનાવવા રાજ્ય સરકારે કિસાન સમૃદ્ધિ યોજનાને પાંચ વર્ષ માટે લંબાવી…
ખરીફ મગફળી પાકની ઉન્નત ખેતી પધ્ધતી
મગફળી એ ગુજરાતમાં વવાતો અગત્યનો તેલીબિયાં પાક છે. આ પાકનું વાવેતર અંદાજીત ૧પ થી ર૦ લાખ હેકટર અને રપ થી ૩૦ લાખ ટન ચોમાસુ ઋતુ…
વિકાસ યોજનાઓના આયોજન અને સંચાલનમાં સહભાગી ગ્રામીણ મૂલ્યાંકનનો અભિગમ
સહભાગી ગ્રામીણ મૂલ્યાંકન (Participatory Rural Appraisal -PRA) એ બિન-સરકારી સંસ્થાઓ અને આંતરરાષ્ટ્રીય વિકાસ સાથે સંકળાયેલી અન્ય એજન્સીઓ દ્વારા વિકાસ યોજનાઓ અને કાર્યક્રમોના આયોજન અને સંચાલનમાં…
ખેડૂતોને 2 લાખ રૂપિયાનું ઈનામ આપશે રાજ્ય સરકાર, જાણો શરતો અને અરજીની પ્રક્રિયા
સરકાર કૃષિને પ્રોત્સાહન આપવા માટે ઘણી યોજનાઓ લાવે છે. આવી જ એક યોજનામાં, છત્તીસગઢ સરકાર ખેડૂતોને પ્રોત્સાહિત કરવા માટે ડૉ. ખૂબચંદ બઘેલ પુરસ્કારથી સન્માનિત કરવા…
સુરેન્દ્રનગર-રાજકોટ સેક્શનમાં ડબલ ટ્રેકના કામને કારણે 21 જૂન સુધી રેલ વ્યવહાર ને અસર
રાજકોટ ડિવિઝનમાં ચાલી રહેલા ડબલ ટ્રેકના કામ હેઠળ સુરેન્દ્રનગર-રાજકોટ સેક્શનમાં આવેલા સ્ટેશનો પર ઈન્ટરલોકિંગ ના કામ માટે અને રામપરડા યાર્ડના રિમોડલિંગના કામ માટે બ્લોક લેવામાં…
20 વર્ષના સમયગાળા માટે 72 ગીગાહર્ટ્ઝથી વધુ સ્પેક્ટ્રમની હરાજી કરવામાં આવશે
પ્રધાનમંત્રી શ્રી નરેન્દ્ર મોદીની અધ્યક્ષતામાં કેન્દ્રીય મંત્રીમંડળે સ્પેક્ટ્રમની હરાજી કરવા માટે ટેલિકોમ્યુનિકેશન વિભાગના પ્રસ્તાવને મંજૂરી આપી છે જેના દ્વારા જાહેર અને ખાનગી સાહસોને 5G સેવાઓ…
હરિયાણા સરકારે જળ સંરક્ષણના સૌથી મોટા પ્રોજેક્ટનો પાયો નાખ્યો
હરિયાણા સરકારે જળ સંરક્ષણને લઈને એક મોટો પ્રોજેક્ટ શરૂ કર્યો છે. જેનો પાયો ખુદ મુખ્યમંત્રી મનોહર લાલ ખટ્ટરે નાખ્યો હતો. સુજલના નામે આ પ્રોજેક્ટ હરિયાણા…
ડ્રોનના ઉપયોગથી આધુનિક ખેતીમાં એક નવો અધ્યાય લખાશે.ખેડુત ઉત્પાદન સંગઠનોને ડ્રોન ખરીદવા માટે 75 ટકા સુધીની આર્થીક સહાય
21 મી સદી એટલે આધુનિક સદી દરેક ક્ષેત્રમાં આધુનિકતા આવી રહી છે. તો ક્રુષિ ક્ષેત્ર પણ બાકી ના રહી જાય તે માટે કેન્દ્ર સરકારના ક્રુષિ…
કૃષિ જાગરણ ચૌપાલની મુલાકાતે આવ્યા કૈલાશ સિંહ, ટીમ સાથે કરી વાત, તો આવો જાણીએ શું કહ્યુ...
કંઈક કરી બતાવાની ઈચ્છા તમને સફળતાના માર્ગે લઈ આવે છે. આ સંદર્ભમાં, કૃષિ જાગરણ તેના ચૌપાલ સત્રમાં એવી મહાન હસ્તીઓને આમંત્રિત કરતું રહે છે, જેમના…
પ્રધાનમંત્રીએ નવસારીમાં 'ગુજરાત ગૌરવ અભિયાન' દરમિયાન બહુવિધ વિકાસ પરિયોજનાઓનું લોકાર્પણ કર્યું
પ્રધાનમંત્રીએ 3050 કરોડ રૂપિયાના બહુવિધ વિકાસ પ્રોજેક્ટ્સના ઉદ્ઘાટન અને શિલાન્યાસ કર્યા…
PM Kisan Yojana: 11 દિવસ પછી પણ ખેડૂતોના ખાતામાં નથી પહોંચ્યા 2 હજાર રૂપિયા? આમ કરવાથી તરત જ આવશે પૈસા
PM Kisan Yojana: પ્રધાનમંત્રી કિસાન સન્માન નિધિ યોજનાના 11મા હપ્તાના પૈસા ખેડૂતોના ખાતામાં ટ્રાન્સફર કરી દેવામાં આવ્યા છે. આ સાથે ખેડૂતોની લાંબી રાહનો પણ અંત…
Biopesticides પર એક લાખ ખેડૂતોને મળશે 90% સબસિડી, વાંચો કેવી રીતે થશે ફાયદા
ભારત એક કૃષિપ્રધાન દેશ છે અને તેમાં સ્થિત રાજ્યોની ભૌગોલિક સ્થિતિ અલગ-અલગ છે. રાજ્ય અને કેન્દ્ર સરકારો ખેડુતોના હિત માટે સમય સમય પર અનેક કલ્યાણકારી…
ખેડૂતે ઓર્ગેનિક ડ્રેગન ફ્રુટની ખેતીને બનાવ્યો ફાયદાનો સોદો, ઘણી થઈ આવક, મળ્યું સન્માન
ખેડૂત ઋતુરાજ અને રાજેન્દ્ર સિંહ ડ્રેગન ફ્રુટનું ઉત્પાદન કરે છે. તેમણે એક એકરમાં ઓર્ગેનિક ડ્રેગન ફ્રુટની ખેતી કરી છે. ખેડૂત ઋતુરાજે જણાવ્યું કે તેણે ઓર્ગેનિક…
અમિત શાહે સહકારી બેંકો દ્વારા ધિરાણ પ્રવાહ વધારવા માટે આરબીઆઈ દ્વારા જાહેર કરાયેલા મહત્વપૂર્ણ પગલાંને આવકાર્યું
શ્રી અમિત શાહે કહ્યું કે, એક વર્ષથી ઓછા સમયગાળામાં પ્રધાનમંત્રી નરેન્દ્ર મોદીએ સહકારી ક્ષેત્ર માટે ઘણા ઐતિહાસિક નિર્ણયો લીધા છે, જેની લાંબા સમયથી જરૂર હતી…
સોયાબીનના 4300, ડાંગરના 2040 રૂપિયા પ્રતિ ક્વિન્ટલ MSP નક્કી
કેન્દ્ર સરકારે ખરીફ માર્કેટિંગ વર્ષ 2022-23 માટે પાકના લઘુત્તમ ટેકાના ભાવ (MSP) જાહેર કર્યા છે. આ વર્ષે એમએસપીમાં 92 થી 523 રૂપિયા પ્રતિ ક્વિન્ટલ સુધીનો…
કોરોમંડલ કંપનીના સતીશ તિવારી કૃષિ જાગરણ ચૌપાલમાં જોડાયા, કૃષિ ઉત્પાદનો પર કરી ચર્ચા
કૃષિ જાગરણ તેના કૃષિ જાગરણ ચૌપાલમાં સતત એવા મહાનુભાવોને આમંત્રિત કરે છે, જેમનું કૃષિ ક્ષેત્રમાં ખુબ જ મહત્વપૂર્ણ યોગદાન હોય છે. આજના આ એપિસોડમાં કોરોમંડલ…
પ્રધાનમંત્રી ₹ 3050 કરોડની બહુવિધ વિકાસ પરિયોજનાઓનું ઉદ્ઘાટન અને શિલાન્યાસ કરશે
આ પરિયોજનાઓ પ્રદેશમાં પાણી પુરવઠામાં સુધારો કરવા અને જીવનની સરળતા વધારવા પર કેન્દ્રિત છે. પ્રધાનમંત્રી નવસારીમાં એ.એમ. નાયક હૅલ્થકેર કોમ્પ્લેક્ષ અને નિરાલી મલ્ટી સ્પેશિયાલિટી હૉસ્પિટલનું…
પ્રધાનમંત્રી મત્સ્ય સંપદા યોજના (PMSSY) ડેશબોર્ડની શરૂઆત
ડિજિટલ ઈન્ડિયા એ દેશને ડિજિટલી સશક્ત સમાજ અને જ્ઞાન અર્થતંત્રમાં પરિવર્તિત કરવાના વિઝન સાથે ભારત સરકારનો મુખ્ય કાર્યક્રમ છે. આ કાર્યક્રમમાં ‘ગુડ ગવર્નન્સ’ની સંસ્કૃતિનું નિર્માણ…
છેલ્લા 70 વર્ષમાં ભારતની જમીનમાં ઓર્ગેનિક કાર્બનનું પ્રમાણ 1% થી 0.3%ના ચિંતાજનક સ્તરે પહોંચ્યું- સંશોધનમાં જાણવા મળ્યુ
જમીનમાં યોગ્ય ખાતર વિના સઘન પાકની ખેતી એ SOC સામગ્રીમાં ઘટાડો થવાનું કારણ છે. ખેડૂતોએ જંતુનાશકો અને ખાતરો પરની તેમની નિર્ભરતા ઘટાડવી જોઈએ. જૈવ ખાતર…
આ વર્ષે અત્યાર સુધીમાં ખાંડનું ઉત્પાદન 15% વધીને કુલ 35.24 મિલિયન ટન થયું
સહકારી સંસ્થા NFCSFL દ્વારા મંગળવારે જાહેર કરાયેલા ડેટા પ્રમાણે વિશ્વના સૌથી મોટા ઉત્પાદક અને બીજા ક્રમના સૌથી મોટા નિકાસકાર ભારતમાં ખાંડનું ઉત્પાદન મહારાષ્ટ્રમાં ઊંચા ઉત્પાદનને…
36 લાખ ઘરેલું ગ્રાહકો અને 7 લાખ ખેડૂતોના વીજળીના બિલ થયા શૂન્ય – મુખ્યમંત્રી
મુખ્યમંત્રી અશોક ગેહલોતે જણાવ્યું હતું કે રાજ્ય સરકાર દ્વારા ચલાવવામાં આવતી યોજનાઓમાંથી આશરે 1.25 કરોડ ખેડૂતો અને ઘરેલું ગ્રાહકોના વીજ બિલોમાં 1044 કરોડની ગ્રાન્ટ આપીને…
સીતાફળ તમારા બગીચાની શોભા વધારવા સાથે મબલખ કમાણી કરી આપે છે
સીતાફળ જેને શરીફા તરીકે પણ ઓળખવામાં આવે છે. તેનું બોટનિકલ નામ એનોના સ્ક્વોમોસા અને ફેમિલી એન્નોનાસીમાં આવે છે. તે અમીર અને ગરીબ દરેકનું પ્રિય ફળ…
સાત દિવસ વીતી ગયા તો પણ ખાતામાં નથી આવ્યા 11માં હપ્તાના પૈસા, જાણો શુ હોઈ શકે છે કારણ
દેશમાં અનેક પ્રકારની કલ્યાણકારી અને લાભકારી યોજનાઓ ચાલે છે, જેમાંથી એક છે, પ્રધાનમંત્રી કિસાન સન્માન નિધિ યોજના. આ યોજના કેન્દ્ર સરકાર દ્વારા ચલાવવામાં આવે છે,…
આયુષ સંસ્થાને NABL માન્યતા મળી
નેશનલ આયુર્વેદ રિસર્ચ ઇન્સ્ટિટ્યૂટ ફોર પંચકર્મ (NARIP), ચેરુથુરુથી, થ્રિસુર, કેરળના બાયોકેમિસ્ટ્રી અને પેથોલોજી વિભાગને તેની ક્લિનિકલ લેબોરેટરી સેવાઓ માટે NABL M(EL)T માન્યતા મળી છે.…
RBIએ રેપો રેટમાં 50 બેસિસ પોઈન્ટનો વધારો કર્યો
6 થી 8 જુન 2022 દરમિયાન મળેલી રિઝર્વ બેંક ઓફ ઈન્ડિયાની નાણાકીય નીતી સમિતિએ સર્વસંમતિથી રેપો રેટમાં 50 બેસિસ પોઈન્ટનો વધારો કરીને 4.90% કરવાનો નિર્ણય…
વનસ્પતિજન્ય જંતુનાશક દવાઓ દ્વારા સંકલિત કીટ નિયંત્રણ
ખેતી પાકોના ઉત્પાદનમા બાધારૂપ પરીબળોમા કીટકો એક અગત્યનું પરીબળ છે. હાલના સંજોગોમા કીટકોના આક્ર્મણથી ખેતીના મોટાભાગના પાકમા નુકશાન થાય છે તેથી કીટકોનો નાશ કરવો ખુબ…
રામાયણના અંગદની જેમ મક્કમ બની ઉભા રહ્યા આ ખેડુત, રચી દીધી સફળતાની ગાથા, હવે છે માલામાલ
ઈરાદાઓમાં જાન અને પોતાની ઓળખ બનાવવા માટે બસ થોડા જ પગલાંની દૂરી હોય છે, જે તમારી સફળતાની કહાની રચી દે છે. વાસ્તવમાં, રવિ ઉમરાવ ઉત્તર…
IFFCO-MC દ્વારા નેનો યુરિયા તાલીમ
IFFCO-MC દ્વારા નેનો યુરિયાની તાલીમ - IFFCO-MC તેમજ કૃષિ વિજ્ઞાન કેન્દ્ર રાયસેનના સંયુક્ત નેજા હેઠળ ગામ બાનખેડી જિલ્લા રાયસેન ખાતે પ્રધાનમંત્રી શ્રી નરેન્દ્ર મોદીના દ્વારા…
ટામેટાની કમાણીથી ખુશ થઈને ખેડૂતે કાઢ્યું સરઘસ... એક લાખ ખર્ચ કરી કમાયા સાત લાખ
મહારાષ્ટ્રના વિદર્ભમાં ખેડૂતો ડુંગળીના ઘટતા ભાવથી ઘણા નારાજ છે, જ્યારે વાશિમ જિલ્લામાં ટામેટાના ઉત્પાદનથી ખુશ થયેલા એક ખેડૂતે ટામેટાના વેલાઓનું સરઘસ કાઢ્યું હતું. દેપુલ ગામના…
કેરળમાં ચોમાસાની એન્ટ્રી થઈ, કયા રાજ્યમાં ક્યારે આવી પહોંચશે તે જાણો
દક્ષિણ પશ્ચિમ ચોમાસાએ 29મી મેના રોજ કેરળમાં દસ્તક આપી છે. સામાન્ય રીતે તે 1લી જૂને અહીં પહોંચે છે. તે 15 દિવસમાં અડધા ભારતમાં પહોંચી જશે.…
5 જુનના રોજ અમુલ ડેરી ઉજવે છે “વિશ્વ પર્યાવરણ દિવસ”
અમુલ ઓર્ગેનીક ફર્ટીલાઈઝરનો ઉપયોગ કરી જમીન બચાવો અને તેની ફળદ્રુપતા વધારો. વધુ માહીતી માટે સંપર્ક કરો 9727795749…
ડ્રોન ખરીદવા માટે સરકાર આપી રહી છે 40 થી 75% સબસિડી, જાણો શરતો
ખેડૂતોના લાભ માટે સરકાર દ્વારા ડ્રોન યોજના ચલાવવામાં આવી રહી છે, જેના દ્વારા માત્ર સાતથી નવ મિનિટમાં એક એકર (0.40 હેક્ટર) ખેતરમાં દવાનો છંટકાવ કરી…
ખેતીની આ ટેકનિકથી ખેડૂત બન્યો અમીર! ઓછા સમયમાં પાકી જાય છે પાક, થાય છે બમણો નફો
એક કહેવત છે "ઉત્તમ કરે ખેતી, મધ્યમ કરે ધંધો અને નાનો કરે નોકરી" આ એટલા માટે કહેવાયું છે કારણ કે જે લોકો ખેતી કરે છે…
ખર્ચ કરતાં અનેક ગણો વધુ નફો, માત્ર 5 વર્ષમાં નીલગિરીની ખેતી કરીને ખેડૂતો બની શકે છે કરોડપતિ
ભારતમાં મોટા પાયે નીલગિરી એટલે કે યુકેલિપ્ટસના વૃક્ષોની ખેતી કરવામાં આવે છે. આ વૃક્ષની સૌથી મહત્વની બાબત એ છે કે અન્ય પાકોની સરખામણીમાં આમાં મહેનતની…
ઘરમાં જ લેબ બનાવીને ઉગાડી દીધી 5 લાખ રૂપિયે કિલો વેચાતી મશરૂમ
ભુંતરના ગૌરવ શર્મા ધોક્કોએ 45 દિવસમાં કોર્ડીસેપ્સ મિલિટેયર્સ મશરૂમ તૈયાર કરી છે. સ્ટેમિના અને રોગપ્રતિકારક શક્તિને મજબૂત રાખવા સાથે મશરૂમનો ઉપયોગ દવા તરીકે કરવામાં આવે…
શરીરમાં પોષણની ઉણપ પૂરી કરતો ઉત્તમ આહાર એટલે-રાગી
ગુજરાતમાં વવાતા તૃણ ધાન્ય પાકોમાં મોખરાનું સ્થાન ધરાવે છે.રાગી એ ડુંગરાઉ પ્રદેશમાં વસતા આદિવાસીઓનો મુખ્ય ખોરાક છે.ગુજરાત તેમજ સમગ્ર ભારતમાં વવાતા તૃણ ધાન્ય પાકોમાં રાગીની…
જીલ્લામાં નિયંત્રણ રેખા પર શાંતિના કારણે ઢોલના તાલે ડાંગરની રોપણી કરી રહ્યા ખેડૂતો
પુંછ: દોઢ વર્ષોથી નિયંત્રણ રેખા પર પાકિસ્તાની ગોળીબારી બંધ થવાના કારણે ચાલી રહેલી શાંતિના કારણે નિયંત્રણ રેખા(LOC)ની આસપાસના વિસ્તારોના ખેડુતો ખુબ જ ખુશ છે. આ…
5 જુનના રોજ અમુલ ડેરી ઉજવે છે “વિશ્વ પર્યાવરણ દિવસ”
દર વર્ષે 5 જુનના દિવસે સમગ્ર વિશ્વ પર્યાવરણ દિવસ ઉજવે છે. આ વખતે અમુલ ડેરી દ્વારા એક નવી પહેલ શરૂ કરવામાં આવી છે અને વિશ્વ…
મશરૂમનું વ્યાપારી બીજ ઉત્પાદનની પધ્ધતિ
૧૬૫૨મા કલ્પેપરે સ્પાનને મશરૂમનું માયસેલિયમ છે એવુ વર્ણવેલ. ત્યાર પછી ૧૬૫૨ થી ૧૮૯૪ સુધી સ્પાનને બનાવવાને બદલે જંગલીમાંથી એકત્રિત કરવામાં આવતા હતા. અનાજના દાણ ઉપર…
ડ્રોન ટેકનોલોજી હવે ખેડૂતોને સશક્ત બનાવશેઃ વડાપ્રધાન નરેન્દ્ર મોદી
વડાપ્રધાન શ્રી નરેન્દ્ર મોદીએ ભારતના સૌથી મોટા ડ્રોન ફેસ્ટિવલ - ઈન્ડિયા ડ્રોન ફેસ્ટિવલ 2022નું ઉદ્ઘાટન કર્યું હતુ. તેમણે ખેડૂત ડ્રોન પાઇલોટ્સ સાથે પણ વાતચીત કરી…
બલ્હ અને નાચનમાં ટામેટાંનો બમ્પર પાક, એક ક્રેટ રૂ. 800માં વેચાય છે
બલ્હ ટામેટાંની માંગ વધુ રહે છે અને ખેડૂતોને ભાવ પણ સારા મળે છે. અન્ય રાજ્યોના વેપારીઓ ખેતરમાંથી જ ખેડૂતોનો પાક ખરીદી લે છે. આ વર્ષે…
આ યુવા ખેડૂત કરે છે આશ્ચર્યજનક ખેતી, નથી માનતા હાર તેથી નસીબ પણ આપે છે સાથ!
મધ્યપ્રદેશના બેતુલ જિલ્લાના આમલા તાલુકાનો રાહુલ કુમાર 'સાહુ સબજી ફાર્મ'ના માલિક છે. તે પોતાને 29 વર્ષનો એક નાનો જમીનદાર ગણાવે છે, પરંતુ તેનું કામ જાણીને…
વૈજ્ઞાનિક ઢબે પશુપાલનનો વ્યવસાય કરી ચોખ્ખી આવકમાં વધારો કરો
આધુનિક વૈજ્ઞાનિક પધ્ધતિથી પશુપાલનના પૂરક ઉધોગને વિકસાવી રાષ્ટ્રમાં શ્વેતક્રાંતિ લાવવા હજુ ઘણું બધું કરવાનું બાકી છે. જેનાથી ગ્રામ્ય બેકારીનો પ્રશ્ન પણ હળવો બને તેમ છે.…
સૂર્ય શક્તિનો ઊપયોગ કરો અને સોલાર વોટર પંપ વસાવો.
આપણો દેશ કૃષિપ્રધાન દેશ છે. આપણા દેશમાં સૂર્યશક્તિ પૂરતા પ્રમાણમાં ઉપલબ્ધ છે, તો આપણે તેનો લાભ લેવો જોઈએ, સોલાર શક્તિમાંથી પુનઃપ્રાપ્ય ઉર્જા ઉત્પન્ન કરી શકાય…
ખેડુતોને નવી ટેકનોલોજી સાથે જરૂરી સંસાધનો આપી રહી છે કેન્દ્ર સરકાર: કૈલાશ ચૌધરી
કેન્દ્રીય કૃષિ અને ખેડૂત કલ્યાણ રાજ્ય મંત્રી કૈલાશ ચૌધરી બુધવારે (1 જૂન) હિમાચલ પ્રદેશની મુલાકાતે હતા. જ્યાં કેન્દ્રીય મંત્રી કૈલાશ ચૌધરીએ રાજ્યમાં વિવિધ સ્થળોએ કૃષિ…
મજૂર અભણ માતા-પિતાનો હોનહાર પુત્ર, પહેલા IIT અને હવે IAS ઓફિસર, કોચિંગ પણ નહોતું કર્યું... જણાવ્યુ સફળતાનું રહસ્ય
જયપુર, રાજસ્થાન: ઘણીવાર લોકો કહે છે કે ભણેલા કે પૈસાદાર લોકોના બાળકોને જ મોટી સરકારી નોકરીઓ મળે છે. પરંતુ આ કહેવતને એક ગરીબ મજુર મા-બાપના…
લેમન ગ્રાસની સુગંધથી દૂર થશે તણાવ, તેલ લગાવવાથી નહીં કરડે મચ્છર
લેમન ગ્રાસમાંથી તેલ પણ કાઢવામાં આવે છે. આનો પ્રયોગ દવાઓની સાથે સેન્ટ અને સાબુ બનાવવામાં થાય છે. તેના પાંદડામાંથી લેમન-ટી પણ બનાવવામાં આવે છે. એક…
ગીરમાં વરસાદ પહેલા જ મગફળીનું મબલખ આગોતરું વાવેતર શરૂ
ગીર વિસ્તારનાં મોટાભાગોમાં પાણીનું સુખ હોવાને કારણે ખેડૂતો ચોમાસાના 15 દિવસ પહેલા જ મગફળીનું વાવેતર કરી દે છે. સાથે શેરડીનું પણ વાવેતર હોય છે.…
વધુ એક ખાનગી એજન્સી ઘન કચરામાંથી પ્લાસ્ટિક અલગ કરી સિમેન્ટ બેગ બનાવશે
અમદાવાદ શહેરમાંથી એકત્રીત થયેલો ચારથી પાંચ હજાર મેટ્રીક ટન ઘન કચરો અમદાવાદ મહાનગર પાલિકા (AMC) માટે માથાનો દુખાવો બની ગયો છે.…
32 વર્ષ બાદ 129 કૃષિ પદાધિકારીઓને મળ્યા નિમણૂક પત્ર, ખેડૂતોને થશે ફાયદો
રાંચી. ઝારખંડમાં, કૃષિ સેવા કેડરના ક્ષેત્રમાં 32 વર્ષ પછી ભરતી પ્રક્રિયા શરૂ થઈ છે. ઝારખંડ પબ્લિક સર્વિસ કમિશન દ્વારા ભલામણ કરાયેલા 129 પદાધિકારીઓમાં નિમણૂક પત્રોનું…
ઘરમાં તુલસીના આ સંકેતોને ન કરો નજરઅંદાજ, તરત જ કરો આ ઉપાય
હિંદુ ધર્મમાં તુલસીના છોડનું ઘણું મહત્વ છે. હિંદુ ધર્મ અને હિંદુ શાસ્ત્રોમાં તુલસીને ભગવાનનો દરજ્જો આપવામાં આવ્યો છે અને તેને ખૂબ જ પવિત્ર પણ માનવામાં…
યોગી સરકારે લીધો મોટો નિર્ણય, દૂધ ન આપવાવાળી ગાયોને રસ્તે છોડશો તો થશે કેસ, જાણો સંપૂર્ણ સમાચાર
રખડતા પ્રાણીઓ પર પ્રતિબંધ લગાવવા માટે યોગી સરકારે મોટું પગલું ભર્યું છે. સરકારે કહ્યું છે કે જે લોકો દૂધ ન આપવાવાળી ગાયોને નિરાધાર છોડી દે…
ખેડુત ઘેટાં-બકરાંને ડુંગળીનો પાક ખવડાવવા મજબુર, કારણ જાણીને ચોંકી જશો
ખેડૂત ભાઈઓ માટે ખેતી એ જીવન જીવવાનું સાધન છે.જેના માટે સરકાર પણ અનેક યોજનાઓ બનાવતી હોય છે અને સમયાંતરે તેમાં ફેરફાર પણ કરતી રહે છે.…
આજથી હોમ લોન અને ઈન્શ્યોરન્સ લેવા થયા મોંઘા, આ 6 મોટા ફેરફારની સીધી અસર પડશે તમારા જીવન પર
1 જૂનથી સમગ્ર દેશમાં ઘણા ફેરફાર થયા છે. તેની સીધી અસર તમારા ખિસ્સા અને જીવન પર પડશે. તેથી જરૂરી છે કે નિયમોની જાણકારી પહેલાથી જ…
ICICI પ્રુડેન્શિયલ: બોટમ-અપ સ્ટોક પીકીંગ ઇન્વેસ્ટમેન્ટ શું છે? આ રીતે રોકાણ કરો, તમને વધુ ફાયદો થશે
આ સંજોગો જ એક ફંડ મેનેજર માટે રોકાણની શ્રેષ્ઠ તક રજૂ કરે છે, જે તે તકમાં સામેલ દરેક બાબતને યોગ્ય રીતે સમજાવી શકે છે.…
આજથી 4 જૂન સુધી ભારતના ઘણા રાજ્યોમાં પડશે ભારે વરસાદ, જાણો અહીં તમારા શહેરની સ્થિતિ
તમે જાણો છો, કે ભારતમાં ચોમાસાનુ આગમન પહેલા જ થઈ ચુક્યુ છે, પરંતુ હવે તે ધીમે ધીમે આગળ વધી રહ્યું છે. આગામી થોડા દિવસોમાં ભારતના…
જાણો UPSC ટોપર શ્રુતિ શર્માની સફળતાનું રહસ્ય
યુનિયન પબ્લિક સર્વિસ કમિશન (UPSC) સિવિલ સર્વિસીસ 2021માં ટોપ રેન્ક મેળવનાર શ્રુતિ શર્મા ઉત્તર પ્રદેશની રહેવાસી છે. તો, ચાલો જાણીએ તેમની સફળતાનું રહસ્ય.…
આજે જાહેર થશે પીએમ કિસાન યોજનાનો હપ્તો, જાણો કેવી રીતે કરશો ઘરે બેઠા ચેક
આજે, 31 મે 2022ના રોજ, પ્રધાનમંત્રી કિસાન સન્માન નિધિ યોજનાનો 11મો હપ્તો બહાર પાડવામાં આવશે. તેનું વિમોચન ખુદ પીએમ નરેન્દ્ર મોદી કરશે. વાસ્તવમાં, કેન્દ્ર સરકારના…
પીએમ મોદીએ શરૂ કરી ખેડૂતો માટે આ લાભકારી યોજનાઓ
વડાપ્રધાન નરેન્દ્ર મોદીના કાર્યકાળના 8 વર્ષ સફળતાપૂર્વક પૂર્ણ થવા પર કૃષિ અને ખેડૂત કલ્યાણ મંત્રી નરેન્દ્ર સિંહ તોમરે દેશવાસીઓને અભિનંદન પાઠવ્યા છે. કૃષિ પ્રધાન તોમરે…
આજે વિશ્વ તમાકુ નિષેધ દિવસ: વિશ્વનું 3% તમાકુ વાવેતર અને સમગ્ર ગુજરાતમાં નોંધાતાં કેન્સરના કુલ દર્દીઓમાંથી 25% કેસ એકલા ચરોતરમાં!
સમગ્ર વિશ્વમાં તમાકુનું ઉત્પાદન મોટા પાયે કરવામાં આવે છે, તેમાંથી 3 ટકા ઉત્પાદન તો માત્ર આણંદ-ખેડા સહિત મધ્યગુજરાતમાં જ થાય છે. વિશ્વમાં દર વર્ષે કેન્સરના…
કૃષિ વિજ્ઞાન કેન્દ્રે ખેડૂતોને 5-5 કિલો ડાંગરનું બિયારણ આપ્યું બિલકુલ મફત, જાણો શું છે સંપૂર્ણ સમાચાર
કૃષિ વિજ્ઞાન કેન્દ્રો દ્વારા ખેડૂતોને ખેતી વિશે પણ જાગૃત કરવામાં આવી રહ્યા છે ભારતને એક કૃષિ પ્રધાન દેશ કહેવામાં આવે છે, કારણ કે અહીંની અડધાથી…
કેન્દ્રીય ગૃહ મંત્રી શ્રી અમિત શાહે તેમની ગુજરાત મુલાકાતના બીજા દિવસે ગોધરામાં અનેક વિકાસ કાર્યોનું ઉદ્ઘાટન અને લોકાર્પણ કર્યું
કેન્દ્રીય ગૃહ અને સહકારિતા મંત્રી શ્રી અમિત શાહે તેમની ગુજરાત મુલાકાતના બીજા દિવસે પંચામૃત ડેરી, ગોધરામાં અનેક વિકાસ કાર્યોનું ઉદ્ઘાટન અને લોકાર્પણ કર્યું.…
પોલી હાઉસના નિર્માણ પર સરકાર આપશે 75 ટકા સુધી સબસિડી, જલ્દી કરો આવેદન
રાજસ્થાન આપણા દેશનું ગૌરવ છે, ત્યાંથી હંમેશા આપણને અવારનવાર ખાવા સાથે જોડાયેલા અજીબોગરીબ સમાચાર મળતા રહે છે. પરંતુ વિશ્વના તમામ લોકોને આકર્ષિત કરનાર આ રાજસ્થાની…
પોલી હાઉસના નિર્માણ પર સરકાર આપશે 75 ટકા સુધી સબસિડી, જલ્દી કરો આવેદન
રાજસ્થાન આપણા દેશનું ગૌરવ છે, ત્યાંથી હંમેશા આપણને અવારનવાર ખાવા સાથે જોડાયેલા અજીબોગરીબ સમાચાર મળતા રહે છે. પરંતુ વિશ્વના તમામ લોકોને આકર્ષિત કરનાર આ રાજસ્થાની…
બુંદેલખંડના સફળ ખેડૂત પ્રેમ સિંહ ખેતી કરીને લાખોની કમાણી કરી રહ્યા છે, પૈસા બચાવવા માટે તૈયાર કર્યુ મોડલ
ઉત્તર પ્રદેશના બુદેલખંડનો વિસ્તાર દુષ્કાળના કારણે હંમેશા ચર્ચામાં રહે છે. તેની હાલત કોઈનાથી છુપી નથી. પરંતુ અહીં એક એવા પણ ખેડૂત છે જેઓ આ દુષ્કાળગ્રસ્ત…
Khet talab yojna :ખેતરમાં તળાવ ખોદવા માટે ખેડૂતોને મળી રહી છે સબસિડી, જલ્દી કરો આવેદન
દેશના અનેક ભાગોમાં ખરીફ પાકની વાવણીની મોસમ ચાલી રહી છે પરંતુ પાણીના અભાવના કારણે ખેડૂતોને વાવણી માટે ભારે જહેમત ઉઠાવવી પડી રહી છે. તેનું મુખ્ય…
પાક બચાવવા માટે રખડતા પશુઓને પંચાયત ભવનમાં કર્યા બંધ
ગ્રંટ નંબર 18ના ગ્રામજનોએ DM પાસે પશુઓને ગૌશાળામાં મોકલવાની માંગ કરી, ગ્રામજનોએ કહ્યું, તેઓ પોતે જ પશુઓ માટે બે દિવસના ચારા અને પાણીની વ્યવસ્થા કરી…
ખેડૂતોની રાહ પૂરી થઈ! આ દિવસે આવશે ખાતામાં સન્માન નિધિ યોજનાના 2 હજાર રૂપિયા
11th Installment of PM Kisan Samman Nidhi: પીએમ કિસાન સન્માન નિધિ (PM Kisan Samman Nidhi) ના 11મા હપ્તાની રાહ જોઈ રહેલા ખેડુત ભાઈઓ માટે સારા…
હિમાચલ પ્રદેશમાં પહેલીવાર તૈયાર કરવામાં આવ્યુ લાલ જરદાળુ, કેન્સર સામે લડવામાં થશે મદદરૂપ
હિમાચલ પ્રદેશના શિમલા જિલ્લાના એક માળીએ તેના બગીચામાં લાલ રંગના જરદાળુ (રેડ બોલેરો જરદાળુ) ઉગાડ્યું છે, જોકે આ જરદાળુ એક સ્પેનિશ જાત છે. લાલ જરદાળુને…
બકરી ઉછેર પર 60% સુધીની સબસિડી આપી રહી છે સરકાર, અહીં કરો અરજી
ભારતના ગામડાઓમાં ખેતીવાડી એ આવકનો સૌથી મોટો સ્ત્રોત છે, જ્યારે પશુપાલન એ આવકનો બીજો સૌથી મોટો સ્ત્રોત છે. ખેડૂતો ગાય અને ભેંસનું દૂધ વેચીને સારો…
સરકારી બજારમાં મગની ખરીદી શરૂ ન થવાના કારણે મંદીનો માહોલ છે, ખેડૂતોને ભારે નુકસાન વેઠવું પડી રહ્યું છે.
ઉનાળાની ઋતુ ચાલી રહી છે અને દેશના ઘણા ભાગોમાં મગનો પાક પાકીને તૈયાર થઈ ગયો છે. તો દેશના ઘણા ભાગોમાં મગ વેચાણ માટે બજારમાં પણ…
PM કિસાન યોજના: માત્ર 4 દિવસ બાકી... બેંક ખાતામાં આવશે પૈસા, પણ આ લોકોને નહીં મળે!
સરકાર ખેડુતો માટે અવાર નવાર નવી નવી યોજનાઓ બહાર પાડતી હોય છે, તેવી જ એક યોજના પ્રધાનમંત્રી કિસાન સન્માન નિધિ યોજના છે. જેમા ખેડુતોને સરકાર…
પાક સંરક્ષણ માટે ખેડૂતો જલ્દી કરો આ કામ નહીંતર ભારે નુકશાન થશે, હવામાન વિભાગની ચેતવણી
બિહારના ખેડુતોને અમે જરૂરી અને મહત્વપૂર્ણ માહિતી આપવા જઈ રહ્યા છે. ભારતીય હવામાન વિભાગે રાજ્યના ખેડૂતો માટે એગ્રો મેટ એડવાઈઝરી જાહેર કરી છે, આ એડવાઈઝરી…
પીએમ મોદી પોતે આ દિવસે રિલીઝ કરશે કિસાન યોજનાના લાભાર્થીઓને 11મા હપ્તાના પૈસા, અહીં જાણો તારીખ
કેન્દ્ર સરકાર દ્વારા ચલાવવામાં આવી રહેલી પ્રધાનમંત્રી કિસાન સન્માન નિધિ યોજનાનો લાભ દેશના જરૂરિયાતમંદ ખેડૂતો લઈ રહ્યા છે. આ યોજના સાથે મોટી સંખ્યામાં ખેડૂતો જોડાયેલા…
ખેડૂતોને સારી ગુણવત્તાનું બિયારણ સમયસર મળે : શ્રી તોમર
"બીજ શ્રુંખલા વિકાસ" પર રાષ્ટ્રીય વેબિનાર કેન્દ્રીય કૃષિ પ્રધાન શ્રી નરેન્દ્ર સિંહ તોમરે, નવી દિલ્હીમાં "બીજ શ્રુંખલા વિકાસ" પર એક રાષ્ટ્રીય વેબિનારની અધ્યક્ષતા કરી, જેનું…
ઓઈલ કંપનીઓએ જાહેર કર્યા પેટ્રોલ અને ડીઝલના ભાવ, જાણો આજે તમારા શહેરમાં કેટલા છે ભાવ
આજ દિલ્હીમાં એક લિટર પેટ્રોલ 96.72રૂ. પ્રતિ લિટર, જ્યારે ડીઝલ 89.62 રૂ. પ્રતિ લિટર મળી રહ્યુ છે.મુંબઈમાં પેટ્રોલની કિંમત111.35 રૂ. અને ડિઝલની કિંમત 97.28રૂ. પ્રતિ…
નુકસાન નહી, ખાંડથી થાય છે અનેક સ્વાસ્થ્ય લાભો, જાણો કેવી રીતે
કેટલાક લોકોને મીઠુ ખાવાનું ખૂબ જ પસંદ હોય છે, જ્યારે કેટલાક લોકો તેમના આહારમાં ખૂબ ઓછી માત્રામાં ખાંડનો સમાવેશ કરે છે. ઘણા લોકોને એવુ લાગે…
ઓનલાઈન શરૂ થયુ ઓર્ગેનિક શાકભાજીનું માર્કેટ, સોશિયલ મીડિયા પર થઈ રહ્યો છે પ્રચાર - પ્રસાર
નમામિ ગંગે અભિયાન હેઠળ, ઉત્તર પ્રદેશના બિજનૌર જિલ્લામાં ગંગા કિનારે 46 પંચાયતોના વિસ્તારમાં ઓર્ગેનિક પાક ઉગાડવામાં આવી રહ્યા છે. કૃષિ વિભાગ અને ખેડૂતોએ શાકભાજી, કઠોળ,…
1 હેક્ટરમાં આ ઝાડની ખેતી કરીને કરો 5 લાખથી વધુની કમાણી, ખર્ચ ઘણો ઓછો
આ દિવસોમાં લોકોનુ વલણ ખેતી તરફ ઝડપથી વધી રહ્યુ છે. આ જ કારણ છે કે લોકો તેમની સારી એવી નોકરીઓ છોડીને ખેતીમાં પોતાનું નસીબ અજમાવી…
પોલીસ કોન્સ્ટેબલ, પ્રોફેસર સહિતની વિવિધ જગ્યાઓ પર મળી રહી છે સરકારી નોકરી, લાખોમાં મળશે પગાર
સરકારી નોકરી મેળવવા માંગતા યુવાનો માટે સારા સમાચાર છે. દેશમાં 10, 12 પાસ અને ગ્રેજ્યુએટ યુવાનો માટે હજારો નોકરીઓ બહાર પડી છે. આ નોકરીઓ માટે…
ખેડૂતો માટે સારા સમાચાર! મુર્રાહ ભેંસ ખરીદવા પર 50% સુધીની સબસિડી આપશે સરકાર
મુર્રાહ ભેંસની ખેતી: ભારતના ગ્રામીણ વિસ્તારોમાં કૃષિ પછી પશુપાલનને આવકનો બીજો સૌથી મોટો સ્ત્રોત માનવામાં આવે છે. સરકાર પણ ખેડૂતોને લગતી આવી તમામ યોજનાઓ શરૂ…
ઓછુ પીવો કે વધારે ..... સ્વાસ્થ્ય માટે હાનિકારક છે આલ્કોહોલ – અભ્યાસ
જો કે દારૂ પીવો સ્વાસ્થ્ય માટે હાનિકારક છે, પરંતુ ઘણા દેશો ઓછી માત્રામાં દારૂ પીવાને સલામત માને છે. વાસ્તવિકતા એ છે કે દારૂ આપણા હૃદય…
સફળ ખેડૂતે આર્થિક સ્થિતિ સુધારવાનો રામબાણ ઉપાય જણાવ્યો
શોભારામ અયોધ્યાના એક પ્રગતિશીલ ખેડુત કહેવાય છે કે માણસ જો મહેનત કરે તો દરેક વસ્તુ સરળતાથી મેળવી શકે છે. આજે અમે તમને એક એવા જ…
બટાકાના પાકને રોગો અને જીવાતોથી બચાવશે લસણ
બટાકાના પાકને નષ્ટ કરનાર લેટ બ્લાઈટ રોગનો સામનો કરવા માટે લસણના પાકને મધ્યમાં ઉગાડવો અસરકારક માનવામાં આવે છે. હવે બટાકાના પાકને રોગો અને જીવાતોથી લસણ…
યુવાનીમાં અનિદ્રાની સમસ્યા વૃદ્ધાવસ્થામાં આપી શકે છે મુશ્કેલી, સાવધાન રહો
આજકાલની જીવનશૈલીમાં અનિદ્રા એટલે કે ઉંઘ ન આવવી એ ઘણા લોકો માટે સામાન્ય સમસ્યા હોય શકે છે. પરંતુ નિષ્ણાતો હંમેશા આ બાબતે બેદરકાર ન રહેવાની…
મલ્ટીનેશનલ કંપનીની નોકરી છોડીને કરી રહ્યા છે કુદરતી ખેતી
આરોગ્ય માટે ઓર્ગેનિક ખેતી ગુરુગ્રામની પ્રદુષિત હવાથી કંટાળીને કેટલાક યુવાનોએ પોતાના ગામે પરત ફરી કુદરતી ખેતીને જ તેમની આજીવિકાનુ સાધન બનાવ્યુ અને સાથે સાથે ગામના…
કેલ્શિયમની ગોળી હાર્ટ એટેકથી મૃત્યુનું જોખમ વધારી શકે છે – અભ્યાસ
આજકાલની જીવનશૈલીમાં અનિયમીત ખાન-પાનને કારણે સામાન્ય રીતે 30ની ઉંમર પછી હાડકા નબળા પડવા લાગે છે. તેવામાં ઘણી વાર એવુ જોવામાં આવ્યુ છે કે હાડકામાં દુખાવો…
ડાયાબિટીસ અને પ્રી-ડાયાબિટીસ વચ્ચે શું તફાવત છે? જાણો આ બંનેના લક્ષણો
ડાયાબિટીસ અને પ્રી-ડાબિટીસ બન્ને શબ્દોને તમે ખુબ સારી રીતે જાણતા હશો. ડાયાબિટીસ હાલના સમયમાં એક સામાન્ય રોગ બની ગયો છે. ઘણા લોકો આ રોગથી પીડાતા…
હિમાચલ પ્રદેશ: પ્રદેશના લસણની બહારના રાજ્યોમાં માંગ, 100 રૂપિયા પ્રતિ કિલોના ભાવે વેચાઈ રહ્યુ છે.
હિમાચલ પ્રદેશનુ લસણ ઔષધીય ગુણોથી ભરપુર હિમાચલ પ્રદેશનુ લસણ ઔષધીય ગુણોથી ભરપુર છે. હિમાચલ પ્રદેશના લસણની માંગ સમગ્ર દેશ અને વિદેશમાં પણ રહે છે. લસણનું…
કાસગંજના ખેડૂતે ઉગાડ્યું પીળું તરબૂચ, લોકોને પસંદ આવ્યો તેનો સ્વાદ
તરબૂચ ઉનાળાની ઋતુમાં ઠંડક આપવાનું કામ કરે છે, જેથી બજારોમાં ઘણા પ્રકારના તરબુચનુ વેચાણ થઈ રહ્યુ છે. કાસગંજના એક ખેડૂતે પીળા તરબૂચના પાકનું વાવેતર કર્યું…
પીએમ કિસાન યોજનામાં E-KYC નહીં હોય તો અગિયારમાં હપ્તાની રકમ નહીં મળે, જાણો E-KYC કરવાની સંપુર્ણ પ્રોસેસ
કિસાને પોતાના મોબાઈલ નંબરને આધાર કાર્ડ સાથે લિંક કરવો ફરજીયાત સરકાર દ્વારા કિસાનો માટે અવાર નવાર નવી નવી યોજનાઓ બહાર પાડવામાં આવતી હોય છે, આવી…
દૂધ સ્ટોર કરવામાં થાય છે તકલીફ તો આ વાસણોનો કરો ઉપયોગ, જલદી નહીં થાય ખરાબ
દૂધ એવી વસ્તુ છે જે લગભગ દરેક ઘરમાં આસાનીથી મળી જાય છે. કોઈને ચા પીવાનુ પસંદ છે તો કોઈ કોફી માટે દૂધ રાખે છે. તેની…
ગરમીના કારણે ઘઉંનું ઉત્પાદન 30 ટકા ઘટ્યું, ખરીદીમાં પણ તેજી, ખેડૂતોને ભારે નુકસાન
માર્ચ અને એપ્રિલ મહિનામાં સરેરાશથી વધારે તાપમાને ઘઉંના ઉત્પાદનને અસર કરી છે. મેરઠ જીલ્લામાં ઘઉંનુ પ્રતિ હેક્ટર ઉત્પાદન 30% સુધી ઘટી ગયુ છે. ખેડૂતોને આના…
ખેડૂતોએ ધ્યાન આપવું જોઈએ, હવામાન વિભાગે પાક અંગે જરૂરી એડવાઈઝરી જાહેર કરી છે
ઉનાળાની ઋતુમાં ગરમ વાતાવરણને કારણે હવામાન વિભાગના નિષ્ણાંતોએ રવિ અને જાયદ પાક સહિત અનેક પાકો માટે એડવાઈઝરી જાહેર કરી છે. ઘઉં, સરસવ, મકાઈ, ચણા વિશે…
ભારતમાં ઘઉંની નિકાસ પરના પ્રતિબંધનો અમેરિકાએ કર્યો વિરોધ, કેન્દ્રએ આપી થોડી છૂટ
સ્થાનિક બજારમાં ભાવ વધવાને કારણે ઘઉંની નિકાસ પર ભારત દ્વારા લાદવામાં આવેલા પ્રતિબંધનો અમેરિકાએ વિરોધ કર્યો છે. સંયુક્ત રાષ્ટ્રમાં અમેરિકી રાજદૂત લિન્ડા થોમસ ગ્રીનફિલ્ડે આશંકા…
હિમાચલ પ્રદેશના 30,366 અન્નદાતાઓએ kccમાં દેવાળુ ફુંક્યુ, ખાતા NPA જાહેર કરી દેવાયા
30,366 ખેડુતો કિસાન ક્રેડિટ કાર્ડનુ દેવુ ન ભરી શક્યા તેથી તેમના બેંક ખાતાને એનપીએ ઘોષિત કરી દેવામાં આવ્યા છે. ડિફોલ્ડર થયેલા આ ખેડુતો પાસે બેંકોના…
દિલ્હીથી મુંબઈ સુધી પેટ્રોલ અને ડીઝલના ભાવ સ્થિર, જાણો આજના ભાવ
દેશની આર્થિક રાજધાની મુંબઈમાં પેટ્રોલ 120.51 રૂ. લીટર અને ડીઝલ 104.77 રૂ. લીટર વેચાઈ રહ્યુ છે. દિલ્હીથી લઈ મુંબઈ સુધી રાષ્ટીય બજારોમાં આજ પણ પેટ્રોલ…
દુનિયાનુ એવુ પહેલુ કુલર જે એસીની જેમ લગાવી શકાય છે દિવાલ પર, જે ઓછી વિજળીમાં ઘરને બનાવી દેશે શિમલા
ભારતમાં મોટા ભાગની જગ્યાઓ પર ગરમી દિવસે ને દિવસે ખુબ જ વધી રહી છે. દેશની રાજધાની દિલ્હીમાં 15 મે ના રોજ 47 ડિગ્રી તાપમાન રહ્યુ…
મૃત્યુ બાદ તમારા સોશિયલ મીડિયાનો વારસદાર કોણ ? આ વિશે જાણીએ રસપ્રદ માહિતી
શું તમે જાણો છો તમારા મૃત્યુ બાદ તમારા સોશિયલ મીડિયા એકાઉન્ટને કોણ સંભાળશે? તો આવો આજે જાણીએ કે તમારા મૃત્યુ બાદ તમારા ફેસબુક અને ટ્વિટર…